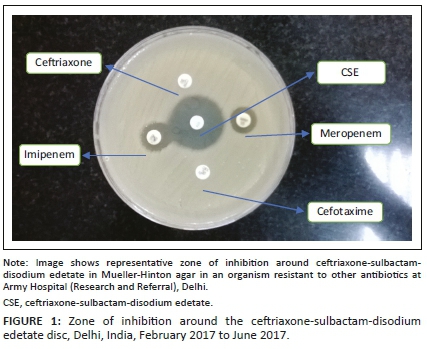

Services on Demand
Journal
Article
Indicators
Related links
-
Cited by Google -
Similars in Google
Share
African Journal of Laboratory Medicine
On-line version ISSN 2225-2010Print version ISSN 2225-2002
Afr. J. Lab. Med. vol.9 n.1 Addis Ababa 2020
https://doi.org/10.4102/ajlm.v9i1.1038
Data analysis
All data were recorded on a datasheet and entered into an Excel (Microsoft, Redmond, Washington, United States) spreadsheet for statistical analysis. Where data were missing, no value was entered. There was no patient follow-up or clinical record review. StatisticaTM version 13.0 (Dell, Round Rock, Texas, United States) and STATA version 15 (Statacorp, College Station, Texas, United States) were used in the statistical analysis. Categorical data (macroscopic tissue quantity, diagnostic category, diagnosis) were reported as frequencies. Numerical data (age and endometrial thickness) were reported as medians with interquartile ranges, as these data were non-normally distributed. Only endometrial thicknesses reported in postmenopausal patients were used. The chi-square and Fisher's exact tests were used to assess associations between the amount of tissue at grossing and diagnostic category, and the presence of endometrial tissue on histological examination. The Kruskall-Wallis test was used to assess differences in endometrial thicknesses recorded for macroscopic quantity of tissue and diagnostic category. Pairwise comparison (Dunn's test) was used to assess associations between median endometrial thickness and diagnostic category, and macroscopic tissue quantity in the postmenopausal group. Statistical significance was set at p < 0.05.
Results
Entire cohort
A total of 1926 outpatient endometrial aspiration biopsies were received and reported in the laboratory from 01 July 2013 to 31 May 2017. The median age of the patients was 53 (interquartile range 48-62) years (Table 1). Most biopsies (n = 1625, 90.58%) were submitted for abnormal or postmenopausal bleeding. In 196 (10.18%) cases, the presence of risk factors for endometrial carcinoma was indicated (data not shown in table). Scanty and moderate samples comprised the majority of samples received, with only 135 (6.82%) bulky specimens noted. For the entire group, 485 (25.18%) cases had no endometrium and 245 (12.72%) cases had limited amounts in the form of superficial strips of mucosa or stroma (Figure 1). The majority of diagnoses were benign (n = 1725, 86.42%). Of the 110 malignancies diagnosed, there were 32 cases of serous carcinoma of the endometrium, 24 endometrioid carcinomas and 13 malignant mixed Müllerian tumours. Cervical pathology was noted in 107 (5.56%) of the total biopsies, 70 cases of which were diagnosed with cervical squamous intraepithelial lesions, eight with squamous cell carcinoma and three with cervical adenocarcinoma.

The distribution of samples with histologically determined endometrium present, absent or limited in amount and the diagnostic categories across macroscopic quantities was assessed. Associations between the macroscopic quantity of tissue received and the presence of endometrial tissue (p ≤ 0.001) and diagnostic category (p ≤ 0.001) are shown in Table 2.
Cases of interest
Two cases of interest were noted. An endometrial sample from a 39-year-old woman with abnormal uterine bleeding revealed cytomegalovirus endometritis (Figure 2). No clinical follow-up was available for this patient. A B-cell non-Hodgkin lymphoma (Figure 3) was noted in a 22-year-old woman with bilateral ovarian masses, hepatosplenomegaly and lymphadenopathy. In addition to endometrial involvement, previous histology also showed nodal and marrow infiltration by lymphoma.


Actinomyces
Six biopsies from five patients, ranging in age from 54 to 78 years, showed infection with Actinomyces bacteria (Figure 4). All patients with Actinomyces infection presented with abnormal bleeding, with one patient additionally complaining of per vaginal discharge. An intrauterine contraceptive device in situ was noted in only one patient and none of patients with Actinomyces infection had microbiological confirmation.

Tamoxifen use
Of the total biopsies studied, 11 were from patients on tamoxifen. Three presented with postmenopausal bleeding, and the endometrial thickness reported in three women ranged from 4 mm to 18 mm (data not shown). Two biopsies from patients on tamoxifen showed endometrial polyps (both patients presented with bleeding), two showed endometritis and one, atypical squamous cells (data not shown).
Postmenopausal subgroup
A total of 994 patients (see Table 1) of the entire cohort were postmenopausal, as indicated in the clinical history sections of the laboratory records. The median age in the postmenopausal group was 60 years (interquartile range 54-68). The majority of biopsies (n = 964, 98.27%), where an indication for biopsy was provided, were for postmenopausal bleeding. Risk factors for malignancy were noted in 126 (12.7%) patients (data not shown). In the postmenopausal group, 267 (26.86%) had no endometrium and 152 (15.29%) had limited amounts (data not shown). Malignant diagnoses accounted for 82 (8.27%) of postmenopausal cases (data not shown). Other significant pathological findings included hyperplasia (n = 16), hyperplasia with atypia (n = 15), endometrial polyps (n = 115), inactive endometrium (n = 125) and endometritis (n = 71) (data not shown). Endometrial thicknesses were specified in only 94 of postmenopausal patients, with an overall median of thickness of 11.0 mm (interquartile range 7-17) (data not shown).
Significant differences were noted in the median endometrial thicknesses recorded among the diagnostic categories and macroscopic quantities of tissue for postmenopausal women (Table 3). On subsequent analysis, it was shown that the greater the endometrial thickness, the greater the likelihood of obtaining more tissue (bulky vs moderate p = 0.021 and bulky vs scanty p < 0.001) (data not shown). In addition, the thicker the endometrium measured on ultrasound, the more likely a diagnosis of malignant versus atypical (p = 0.048) and malignant versus benign (p = 0.005) (data not shown) was made.

Discussion
Outpatient endometrial samples are regularly encountered in general pathology practice. One-quarter of samples in this study contained no endometrial tissue on histological examination. Furthermore, in the postmenopausal group, endometrial thickness on ultrasound correlated with the amount of tissue obtained at sampling and the histologically confirmed diagnostic category.
As per other studies from Canada and Turkey, abnormal bleeding was the most common presenting feature in our study.8,9 The importance of adhering to guidelines or indications for biopsy has been stressed, as endometrial sampling is not without risk. A tendency to over-investigate patients younger than 40 with abnormal bleeding has been shown.10 Furthermore, sampling of the endometrium without a clear indication may contribute to higher failure rates.
Although larger samples show better agreement rates with final excisional diagnoses,4,11 bulky specimens formed the minority of samples submitted in our cohort. Failure rates reported in the literature include cases where insufficient tissue was noted on histological examination or where the endometrium could not be accessed due to technical or patient-related factors.5 Higher failure rates have been noted in postmenopausal, obese patients, those with advanced age or previous failed pipelle and when sampling was performed by a non-physician.9 The failure rate for this cohort is higher than some reported failure rates (6.33% - 18.4%)8,9,12 and lower than the overall failure rate of 42% reported in a meta-analysis where 11% of cases failed due to technical reasons and 31% had insufficient tissue.5 These figures need to be interpreted with caution, as the criteria for labelling biopsies as 'insufficient' may vary across institutions. In one study, complete agreement on classification as insufficient or diagnostic was shown in only 57% of cases.7 The terms 'insufficient' or 'inadequate' were proposed for cases with no endometrial tissue present and 'unassessable' if there was too little tissue.6 Recently published Canadian guidelines may facilitate standardising reporting. Categories of 'non diagnostic sample, no endometrial tissue present' and 'scant fragments of inactive endometrial surface epithelium and/or stroma (suboptimal for histopathological assessment)' have been suggested.13 An endometrial surface area of at least 35 mm,2,11 or a minimum of 10 endometrial strips14 have also been proposed as cut-offs for a conclusive sample. Limited endometrial tissue was noted in 245 (12.72%) of our biopsies. The histological finding of limited endometrial tissue should be correlated clinically with the endometrial thickness as this microscopic finding could be compatible with atrophy, requiring no further clinical intervention. Adequacy is related to endometrial thickness. One study showed that 27% of samples were adequate among postmenopausal patients with an endometrial thickness of less than 5 mm, leading to the suggestion that sampling should not be done in this group.3 This study corroborates the findings of others in that the thicker the endometrium in postmenopausal women, the greater the likelihood of obtaining more sample and a malignant diagnosis.3,8 Specificity of endometrial sampling is high, but its sensitivity is low.5 One study has shown that, following an inadequate or scant biopsy, 10% of patients had hyperplasia, 5% had malignancy on repeat sampling and 15% had malignancy on hysterectomy.7 Worrisome histological findings such as atypia or necrosis on initial biopsy should be communicated as 43% of such patients in one study had malignancy on follow-up biopsy.15
The frequency of histological diagnoses noted in the entire cohort is similar to findings by Inal et al.,8 with the exception that hyperplasia was diagnosed in fewer patients (2.02% vs their 9.7%). Cervical pathology was noted in some of this cohort's endometrial biopsies. Histopathologists should be alert to the presence of, and pathological changes in, cervical tissue present in an endometrial sample, as this may direct clinicians to re-examine and rebiopsy the cervix. In the current study, hyperplasia or malignancy were diagnosed in 113 (11.37%) of postmenopausal women, which is in keeping with other studies.10,16
Cytomegalovirus endometritis and endometrial involvement by non-Hodgkin lymphoma were two interesting cases encountered. Isolated case reports of cytomegalovirus endometritis from the 1990s have been noted, but the most recent report was in a postpartum uterus specimen.17 Polymerase chain reaction for cytomegalovirus was negative and the diagnosis was based on immunohistochemistry.17 A caveat to bear in mind is that biotin present in postpartum endometrial epithelium interacts with the avidin-biotin-complex, resulting in false-positive staining on immunohistochemistry.18 In women, non-Hodgkin lymphoma most commonly affects the ovaries, as it is postulated that the ovarian microenvironment is conducive to the growth of tumour cells. It is important to categorise lymphomas as either primary genital tract disease or secondary involvement, as this may have treatment implications.19 The prevalence of actinomycotic endometritis was 0.31% in this study, which is higher than the 0.0002% previously recorded.20 The association with prolonged use of an intrauterine contraceptive device is well known, but this history is not always forthcoming. Although forming only a very small subset in this study, patients on tamoxifen with postmenopausal bleeding and with adequate endometrial tissue most commonly had endometrial polyps on biopsy, which is similar to another study.21
Limitations
This study included a review of laboratory-record histology reports from a large number of endometrial biopsies. Clinical information submitted in some instances was minimal, with no information about the menopausal status or endometrial thickness. The postmenopausal group was determined using clinical history only and all cases with no comment on menopausal state were excluded from this subgroup. A large number of cases could therefore have been left out, but assumptions about the menopausal state based purely on age could not be justified. Furthermore, there was no clinical record review to assess outcomes and final diagnosis for cases where there was no endometrium or limited endometrium. As this hospital is a tertiary public hospital in a metropolitan area, the cases are biased and therefore may not be a true reflection of the South African community. Further areas of study could include a follow-up of cases with no or limited endometrium and to assess local reasons for the failure rates in this study.
Conclusion
This study provides information about the indications, diagnoses and representation of endometrium in endometrial samples seen at a large tertiary hospital in Soweto. There should be an awareness among pathologists and clinicians regarding terms such as 'insufficient', 'inadequate', 'scant' and 'unassessable' in an endometrial sample pathology report. If these terms are used, they should be accompanied by a clear description of the type and amount of tissue that is present as there is no consensus among pathologists regarding adequacy criteria.6,7 In the appropriate setting, repeat biopsy can be suggested by the pathologist when no or little endometrial tissue is present as there is a possibility of finding hyperplasia or malignancy on subsequent biopsy.7 Ultimately, management following an 'insufficient' tissue biopsy will depend on clinical factors such as the persistence of bleeding and ultrasound findings.7,12,13 Endometrial sampling is a useful investigation if done under the appropriate clinical circumstances, submitted with adequate history and reported mindfully by the histopathologist.
Acknowledgements
The author wishes to thank Dr Innocent Maposa (Faculty of Health Sciences Research Office) for biostatistical support, Mr Eric Liebenberg for assistance with photography, Mr Deon Mahlathi for slide retrieval, and colleagues and staff at Chris Hani Baragwanath Academic Hospital Histopathology Laboratory.
Competing interests
The author declares that she has no financial or personal relationships that may have inappropriately influenced her in writing this article.
Author's contributions
I declare that I am the sole author of this research article.
Sources of support
This research did not receive any specific grant from funding agencies in the public, commercial or not-for-profit sectors.
Data availability statement
Data is available upon request from the author.
Disclaimer
The views expressed in the submitted article are the author's own and not an official position of the institution or funder.
References
1.Demirkiran F, Yavuz E, Erenel H, Bese T, Arvas M, Sanioglu C. Which is the best technique for endometrial sampling? Aspiration (pipelle) versus dilatation and curettage (D&C). Arch Gynecol Obstet. 2012;286(5):1277-1282. https://doi.org/10.1007/s00404-012-2438-8 [ Links ]
2.Visser N, Reijnen C, Massuger L, Nagtegaal I, Bulten J, Pijnenborg J. Accuracy of endometrial sampling in endometrial carcinoma: A systemic review and meta-analysis. Obstet Gynecol. 2017;130(4):803-813. https://doi.org/10.1097/AOG.0000000000002261 [ Links ]
3.Elsandabesee D, Greenwood P. The performance of pipelle endometrial sampling in a dedicated postmenopausal bleeding clinic. J Obstet Gynaecol. 2005;25(1):32-34. https://doi.org/10.1080/01443610400025390 [ Links ]
4.Garcia T, Appel M, Rivero R, Kliemann L, Wender M. Agreement between preoperative endometrial sampling and surgical specimen findings in endometrial carcinoma. Int J Gynecol Cancer. 2017;27(3):473-478. https://doi.org/10.1097/IGC.0000000000000922 [ Links ]
5.Van Hanegem N, Prinns M, Bongers M, et al. The accuracy of endometrial sampling in women with postmenopausal bleeding: A systematic review and meta-analysis. Eur J Obstet Gynecol Reprod Biol. 2016;197:147-155. https://doi.org/10.1016/j.ejogrb.2015.12.008 [ Links ]
6.Phillips V, McCluggage W. Results of a questionnaire regarding criteria for adequacy of endometrial biopsies. J Clin Pathol. 2005;58(4):417-419. https://doi.org/10.1136/jcp.2004.023564 [ Links ]
7.Goebel E, McLachlin M, Ettler H, Weir M. Insufficient and scant endometrial samples: Determining outcomes and consistency in reporting. Int J Gynecol Pathol. 2019;38(3):216-223. https://doi.org/10.1097/PGP.0000000000000514 [ Links ]
8.Inal Z, Inal H, Kuckukosmanoglu I, Kucukkendirci H. Assessment of endometrial sampling and histopathological results: Analysis of 4247 cases. Eurasian J Med. 2017;49(1):44-47. https://doi.org/10.5152/eurasianjmed.2017.16269 [ Links ]
9.Nicholls-Dempsey L, Kamga-Ngande C, Belisle S, et al. Endometrial biopsy in an outpatient gynaecological setting: Overinvestigation. J Obstet Gynaecol Can. 2018;40(10):1309-1314. https://doi.org/10.1016/j.jogc.2018.01.020 [ Links ]
10.Reijnen C, Visser N, Bulten J, Massuger L, Van der Putten L, Pijnenborg J. Diagnostic accuracy of endometrial biopsy in relation to the amount of tissue. J Clin Pathol. 2017;70(11):941-946. https://doi.org/10.1136/jclinpath-2017-204338 [ Links ]
11.Adambekov S, Goughnour S, Mansuria S, et al. Patient and provider factors associated with endometrial pipelle sampling failure. Gynecol Oncol. 2017;144(2):324-328. https://doi.org/10.1016/j.ygyno.2016.11.041 [ Links ]
12.Clark T, Mann C, Shah N, Khan K, Song F, Gupta J. Accuracy of outpatient endometrial biopsy in the diagnosis of endometrial cancer: A systematic quantitative review. BJOG. 2002;109(3):313-321. https://doi.org/10.1111/j.1471-0528.2002.01088.x [ Links ]
13.Parra-Herran C, Cesari M, Djordjevic B, et al. Canadian consensus-based and evidence-based guidelines for benign endometrial pathology reporting in biopsy material. Int J Gynecol Pathol. 2019;38(2):119-127. https://doi.org/10.1097/PGP.0000000000000481 [ Links ]
14.Sakhdari A, Moghaddam P, Liu Y. Endometrial samples from postmenopausal women: A proposal for adequacy criteria. Int J Gynecol Pathol. 2016;35(6):525-530. https://doi.org/10.1097/PGP.0000000000000279 [ Links ]
15.Kandil D, Yang X, Stockl T, Liu Y. Clinical outcomes of patients with insufficient sample from endometrial biopsy or curettage. Int J Gynecol Pathol. 2014;33(5):500-506. https://doi.org/10.1097/PGP.0000000000000085 [ Links ]
16.Patel V, Wilkinson E, Chamala S, Lu X, Castagno J, Rush D. Endometrial thickness as measured by transvaginal ultrasound and the corresponding histopathologic diagnosis in women with postmenopasual bleeding. Int J Gynecol Pathol. 2016;36(4):348-355. https://doi.org/10.1097/PGP.0000000000000344 [ Links ]
17.Giraldo-Isaza M, Jaspan D, Cohen A. Postpartum endometritis caused by herpes and cytomegaloviruses. Obstet Gynecol. 2011;117(2):466-467. https://doi.org/10.1097/AOG.0b013e3181f73805 [ Links ]
18.Bakkar R, Moore G, Martin A, Alatassi H. Biotin-rich intranuclear inclusions: Have you checked your immunohistochemical controls?. Int J Surg Path. 2008;16(4):424-425. https://doi.org/10.1177/1066896908319674 [ Links ]
19.Lagoo A, Robboy S. Lymphoma of the female genital tract: Current status. Int J Gynecol Pathol. 2005;25(1):1-21. https://doi.org/10.1097/01.pgp.0000183049.30212.f9 [ Links ]
20.Chiesa-Vottero A. Actinomycotic endometritis. Int J Gynecol Pathol. 2019;38(2):138-142. https://doi.org/10.1097/PGP.0000000000000476 [ Links ]
21.Jung H, Jung J, Kim S, Cho E, Um M. Comparative study on hysteroscopic and histologic examinations of the endometrium in postmenopausal women taking tamoxifen. J Menopausal Med. 2018;24(2):81-86. https://doi.org/10.6118/jmm.2018.24.2.81 [ Links ]
Correspondence:
Reena Mohanlal
reena.mohanlal@nhls.ac.za
Received: 26 Apr. 2019
Accepted: 15 May 2020
Published: 29 Sept. 2020
ORIGINAL RESEARCH
Serological detection of brucellosis among febrile, malaria-negative children and domesticated dogs in an urban African setting
John B. Kalule; Joseph Tomusange; Teddy Namatovu
Department of Biotechnical and Diagnostic Sciences, College of Veterinary Medicine, Animal Resources Animal and Biosecurity, Kampala, Uganda
ABSTRACT
BACKGROUND: Childhood brucellosis and malaria are co-endemic febrile illnesses in some sub-Saharan African countries. Malaria and brucellosis co-infection or brucellosis sole infections are often missed due to an over emphasis on malaria and the lack of appropriate diagnostic infrastructure. Brucellosis in dogs is usually overlooked and yet there is extensive contact between humans and their pets.
OBJECTIVE: This study investigated brucellosis in children and dogs using a confirmatory serological testing series that screens for three Brucella sp.
METHODS: Residual blood samples from malaria smear-negative febrile children were collected and tested for Brucella sp and malaria parasite. During the same period, residual blood samples presented to a veterinary microbiology laboratory in the same area were tested for brucellosis using the same approach.
RESULTS: A total of 105 human and 80 canine blood samples were tested for brucellosis antibodies. The seroprevalence of brucellosis was 22.86% (25/105) in children and 1.3% (1/80) in dogs using the Card, buffered acidified plate antigen, and standard plate agglutination tests but was 0% using the rivanol precipitation plate agglutination test.
CONCLUSION: Given that brucellosis can be caused by both smooth and rough colony strains, there is a need to modify the current serological surveillance strategy (targeted at only Brucella abortus and other smooth colony Brucella strains) to figure out the relative contribution of rough colony Brucella strains (B. ovis and B. canis). Since Uganda is endemic for brucellosis there is a need to modify the brucellosis surveillance strategy.
Keywords: brucellosis; serology; malaria; febrile illness; diagnostics.
Introduction
Globally, human brucellosis remains the most common zoonotic disease with more than 500 000 new cases annually, most of which are in sub-Saharan Africa.1 Generally, brucellosis has no age predilection; its transmission is linked to use of or contact with known sources of infection, such as consumption of poorly made dairy products,2,3 or contact with carcasses or aborted material of infected livestock. Childhood brucellosis has previously been reported among children presenting with pyrexia of unknown origin.4 Childhood brucellosis accounts for up to one-third of all cases of human brucellosis in endemic regions.5
Uganda is one of the sub-Saharan Africa countries that are endemic for brucellosis and have, according to World Organisation for Animal Health (OIE) data, reported cases of human brucellosis.6 As per a 2006 study which estimated brucellosis globally, Uganda had an estimated incidence of 1.8 new cases per 100 000 population.7
Both the vaccine strain (Brucella abortus S19) and the wild strains (B. abortus, B. melitensis, B. canis and B. suis) have been shown to be excreted in substantial amounts in livestock milk,8,9,10 a wholesome nutritious option for weaned children,11 thus milk is a vehicle of brucellosis transmission to humans.12 Milk and/or milk products should be subjected to various physical sterilisation to kill potential pathogens such as Brucella spp.13 However, due to various socio-economic factors, consumption of milk and milk products remains a risk factor for brucellosis in many regions in sub-Saharan Africa.10,14,15,16,17 Nevertheless, other risk factors, such as environmental contamination with aborted foetal material, or contact with infected domesticated dogs or their body fluids, could potentially be associated with brucellosis,18 even among children. Dogs have been proven to be reservoirs of highly pathogenic canine B. suis strains that can cause severe disease in humans19 and/or re-emergence of brucellosis on livestock farms.20
The clinical presentation of brucellosis is largely similar to that of malaria (high fever, joint pain, malaise, headache and chills)21; thus, there is a need to deploy sensitive, specific, rapid, and cost-effective laboratory diagnostic tools to differentiate them and avoid misdiagnosis.3 The situation is aggravated by the presence of the weak laboratory infrastructure in sub-Saharan Africa.22 Moreover, the morbidity and mortality rates associated with malaria are high, yet co-infections with brucellosis in this setting are not uncommon.3 Children presenting with high fevers, headaches, and joint pains are more likely to be treated empirically for malaria.23
The diagnosis of brucellosis requires the use of several clinical investigative techniques across haematology, biochemistry, radiology, bacteriology, serology and molecular biology.24 Isolation of Brucella spp. from the blood, bone marrow or other tissue fluids is the gold standard.5 Unlike most high-income countries where brucellosis affects mostly animals, in sub-Saharan Africa it is arguably endemic in both humans and animals.25 In North America, where brucellosis affects both domestic (such as cattle and goats) and wild animals (such as elk and bison), highly efficient serological tests have been developed as part of surveillance diagnostic test schemes for both.26 Seven such serological tests, the Card (Rose Bengal) test, the complement fixation test, the rivanol precipitation plate agglutination (RPPA) test, the standard plate agglutination (SP) test (SPT), the buffered acidified plate antigen (BAPA) test, the rapid automated presumptive test, and the fluorescence polarisation assay have been approved by the United States Department of Agriculture for the detection of B. abortus antibodies. Brucella abortus is the most prevalent species in North America. The rapid slide agglutination test is often used to test for B. canis in dogs which can also be infected with B. suis.27 The B. abortus serological tests that are commonly used cannot detect antibodies to the rough colony variants B. canis and B. ovis. The North American serological tests have rarely been used in the endemic African regions; in fact, only the Card test has been used frequently for serodiagnosis of brucellosis at the point of care for both humans and animals.28 The Card test is highly efficient for diagnosis of human brucellosis, often outperforming tests that take longer to perform such as Coombs, competitive enzyme-linked immunosorption assay, BrucellaCapt (immunocapture agglutination test; Vircell, Granada, Spain),29 immunochromatography, and immunoprecipitation with Brucella proteins.30 With the exception of the RPPA and the fluorescence polarisation tests, the SPT, Card, rapid automated presumptive and BAPA tests all have the limitation that immunoglobulin M antibodies against Brucella spp. cross-react with those of other Gram-negative bacteria such as Salmonella spp. On the other hand, the immunoglobulin G antibodies that are detected using the RPPA test do not cross-react and thus give fewer false positives. Unlike seropositivity by Rose Bengal test or BAPA, which in addition to indicating infection may also mean recovery from brucellosis, RPPA test seropositivity can be used to differentiate between active infection or past infection.12
Most studies of Brucella spp. seroprevalence in Uganda have used the Rose Bengal test (Card test) without using a confirmatory serological test as categorised by the OIE.31,32,33 The RPPA test is commonly used as a confirmatory test, because the non-specific reactivity is reduced by precipitation of high molecular weight serum glycoproteins.12 The increased specificity means a reduction in the number of false positives. This study aimed to establish the seroprevalence of brucellosis due to B. abortus and B. suis in humans presenting with acute febrile illness and domesticated dogs in the same urban African setting. We hypothesised that the use of a confirmatory serological test (RPPA) in addition to routinely used screening serological tests (BAPA, Card and SPT) would enable us to rule out positive reactions due to vaccination of tested animals, previous infection history, or cross reactions34 and thus figure out the true seroprevalence of brucellosis due to B. abortus and B. suis in this setting.
Methods
Ethical considerations
Ethical clearance was obtained from the Makerere University, College of Veterinary Medicine, Animal Resources and Biosecurity (CoVAB), School of Biomedical and Biotechnical Laboratory Sciences, Research and Ethics Committee (SBLS/REC/13/019). The ethical clearance was for use of residual blood samples from the paediatric ward at the clinical microbiology laboratory at Mulago National Referral Hospital. The same clearance also permitted the use of residual blood samples from dogs at a small animal veterinary clinic at Makerere University College of Veterinary Medicine Animal resources and Biosecurity. This study did not directly recruit or collect samples from either the febrile children or the febrile dogs.
Data on the ages and sex of the patients from whom the samples were collected were recorded. The samples were re-assigned a study number and all patient-identifying data were not accessed. The same was done for the residual blood samples from febrile dogs.
Study design and residual sample selection
We opted to test residual blood samples from febrile children that were malaria smear-negative and residual blood samples from febrile dogs. The dogs, though owned by individual homes, closely interacted with the community in the study region; for instance, the pig abattoir in the community is potentially a common source of infection to both humans (via meat purchases) and dogs (either the abattoir waste was purchased by the dog owner as dog feed or the dogs accessed poorly disposed abattoir waste).
All samples used were collected between January and June 2014 (Figure 1). The malaria-negative residual paediatric blood samples were collected from the clinical microbiology laboratory of a regional referral hospital, while residual canine blood samples were from a local veterinary clinic which serves the central region. The residual blood samples were tested for brucellosis using three screening tests and one confirmatory test.

Re-testing human blood samples for malaria
The included malaria-negative paediatric residual blood samples were re-tested for malaria to confirm that they were malaria-negative. The Field's stains A and B (Himedia Laboratories Limited, Mumbai, India) were used to stain malaria parasites and were viewed using light microscopy. Briefly, a drop of blood was placed on a clean 25 mm x 75 mm glass slide (Merck, Darmstadt, Germany) and a thick smear was made at the centre of the glass slide using the edge of another glass slide to spread to an area of 1 cm2. The smear was allowed to dry at room temperature for 1 min. It was then sequentially dipped into Field's stain A (Himedia Laboratories Limited, Mumbai, India) for 3 seconds and washed in de-ionised water for 3 s with gentle agitation, then it was dipped in Field's stain B for 3 s and washed in tap water for 5 s. The stained smear was then air dried and examined under a light microscope at X100 magnification under oil immersion for malaria parasites, as previously described.35
Testing of human and canine sera samples for Brucella abortus/suis antibodies
Human blood samples that were negative for malaria were processed by centrifugation and the serum obtained was tested for brucellosis using: the Becton Dickinson Brucellosis Card Test Kit 306® (National Veterinary Services Laboratory [NVSL], Ames, Iowa, United States) - a screening test for antibodies against B. abortus/B. suis in serum and plasma; SPT (NVSL, Ames, Iowa, United States); BAPA (SL, Ames, Iowa, United States) and RPPA (NVSL, Ames, Iowa, United States) - a precipitation and agglutination test.
The BAPA, RPPA, Card and SP kits screened for B. abortus/ B. suis antibodies in serum and plasma; tests were carried out according to the manufacturers' instructions on all human and canine sera included in the study. Except otherwise stated, the control sera used were the B. abortus complement fixation medium positive control serum (NVSL reagent 12-M) and the B. abortus complement fixation negative control serum (NVSL reagent 12-N).
Buffered acidified plate antigen test
Aseptically, 80 μL of each sample or control serum was pipetted onto separate squares (1.25 inch - 1.5 inch) etched on a 12.5-inch x 12.5-inch white ceramic bioassay glass plate. Then 30 μL of buffered Brucella plate antigen (NVSL, Ames, Iowa, United States) was added to each sample or control serum square. The serum-antigen suspension was then mixed using a glass stirrer to a diameter of approximately 27 mm and incubated for 4 minutes (±30 s) at room temperature (20 °C - 26 °C) in an enclosed space. After this incubation, it was stirred again and incubated a second time at room temperature for 4 min. The slides were then read in a Minnesota box - an illuminator with an indirect source of light, a black background, and a cover to prevent evaporation of test reagents.
Rivanol precipitation plate agglutination test
Aseptically, 200 μL of each sample or control (positive or negative) was transferred into respective (well-labelled) tubes. Thereafter, 200 μL of Brucella rinavol solution was transferred into each tube and mixed by shaking for 1 min. The mixture was incubated at room temperature for 5 min for precipitation. The tubes were centrifuged at 3000 revolutions per minute to pellet the precipitates. Aseptically, 80 μL, 40 μL, 20 μL and 10 μL of each sample or control supernatant were dispensed onto separate squares (1.25 inch - 1.5 inch) etched on a 12.5 inch x 12.5 inch white ceramic bioassay glass plate. Then, 30 μL of B. abortus rivanol antigen was added. The serum-antigen mixture was stirred in circles (at least 8 circles) beginning from the 1:200 serum dilutions, then proceeding to the 1:25 dilutions of sample or control sera. The bioassay plate was then incubated at room temperature (25±2 °C) in an enclosed space for 6 min (±30 s) with rotation. The incubation with rotation was repeated for a further 6 min (±30 s). The reading was taken at the end of the second incubation under an illuminator according to the manufacturer's instructions.
Card test
Aseptically, 30 µL of sample or control (positive or negative) were dispensed onto the reaction area on the card. Subsequently, two drops of the B. abortus Card test antigen (NVSL, Ames, Iowa, United States) were then dispensed onto the card adjacent to the sample. The antigen and serum were mixed using a clean wooden stirrer for approximately 15 s, followed by rocking movements for 4 min.
Standard plate agglutination tests
Aseptically, 80 µL, 40 µL, 20 µL and 10 µL of sample or control serum were dispensed onto separate squares on a white ceramic bioassay glass plate. Following gentle mixing, 30 µL of antigen was dispensed to each square containing sample or control serum. The serum and antigen were mixed with a stirrer in circles. Mixing was done beginning with the 1:200 dilution. Twice, consecutively, the glass plate was rocked through four rotations, followed by incubation at 25±2 °C in an enclosed space for 4 min (±30 s). The white ceramic bioassay glass plate was rotated again and incubated for another 4 min (±30 s). The reaction was then read using a Minnesota box (NVSL, Ames, Iowa, United States).
Statistical analysis
Data on the serological reactions were entered in Microsoft Office Excel 2010 (Microsoft Corp., Redmond, Washington, United States) and then exported to EPIINFOTM 7.1.5.2 (Centers for Disease Control and Prevention, Atlanta, Georgia, United States) for analysis to determine proportions. The OpenEpi diagnostic test evaluation calculator36 was used to estimate parameters for the performance of the different screening tests compared to the RPPA test.
Results
A total of 349 human residual blood samples were received at the clinical microbiology laboratory from the paediatric ward during the study period; 80 canine residual blood samples were received at the small animal veterinary clinic during the same time period. Of the 349 human samples, 105 were smear-negative for malaria; 244 were smear-positive and excluded from further analysis. Of the 105 malaria smear-negative samples, 44.8% (47/105) were from male patients and 55.2% (58/105) were from female patients. Seroprevalence of brucellosis among the malaria smear-negative residual blood samples was 23.8% (25/105) by Card, 23.8% (25/105) by BAPA and 23.8% (25/105) by SPT, but was 0% (0/105) using the RPPA test (Table 1). All the samples that tested positive using the Card test were also positive using the BAPA and the SP tests; therefore, there was a 100% agreement between Card, BAPA and SP tests. Of the 25 samples that tested positive using the three screening tests, none (0%, 0/25) were confirmed as positive using the RPPA test. Of the 25 human samples that were positive, 40% (10/25) were from male patients, and 60% (15/25) were from female patients. There was no significant difference between sero-reactions for male and female children (p = 0.131). The mean age of the seropositive children was 12 (±0.8) years.

Eighty blood samples from dogs (one sample from each dog), all from households in the central region, were tested for B. suis antibodies, and only one was positive using the three screening serological screening tests - Card, BAPA and SPT. Thus, the seroprevalence of canine B. suis was 1.28% (1/80) using the screening tests. This sample was, however, negative using the RPPA test (seroprevalence using the RPPA test = 0%). There was no significant difference between the seropositivity for humans and dogs (p = 0.052).
Of the canine (1/80) and human (25/105) samples that tested positive by the SP test, all were positive at the two lowest dilutions (1:25 and 1:50). However, 60% (15/25) of the human samples tested positive at the third dilution (1:100) and 28% (7/25) tested positive at the fourth dilution (1:200).
For the human samples, the specificity of the screening tests (Card, BAPA and SPT) was 76.2% (67.2-83.3), sensitivity 0%, positive predictive value 0%, and the negative predictive value 100%. The Cohen's Kappa statistic was 0.
For the canine samples, the specificity of the screening tests (Card, BAPA and SPT) was 76.2% (67.2-83.3), sensitivity 0%, positive predictive value 0%, and the negative predictive value 100%. The Cohen's Kappa statistic was 0.
Discussion
This study used three screening tests (Card, BAPA and SP) and an OIE confirmatory test (RPPA) to evaluate brucellosis as a possible aetiology of pyrexia of unknown origin among malaria smear-negative febrile children in a malaria-endemic African region. Using routine serological screening tests, the seroprevalence of brucellosis in dogs was 1.3%, and 23.8% in humans. There was 100% agreement between Card, BAPA and SP tests, but all were negative using the confirmatory RPPA test. The seroprevalence of brucellosis in both species using the OIE-recommended confirmatory serological test - RPPA test - was 0%.
Many serological studies conducted on brucellosis in endemic regions have reported a high prevalence of brucellosis.37,38,39,40 Unlike earlier studies, this study deployed an OIE confirmatory test in parallel with routinely used screening tests. The brucellosis prevalence reported without the use of a confirmatory test might be misleading, particularly when Brucella culture, the gold standard for Brucella spp. detection, is not carried out. Brucella culture is difficult to execute and suitable laboratory facilities are often lacking in resource-limited brucellosis-endemic regions. The discrepancy between the screening and confirmatory tests found in the current study is similar to that reported in a study conducted in Kenya.41
In this study, all the blood samples tested using the Card and other screening tests were negative when tested using the RPPA test. The difference in results can be explained by the fact that the most commonly used screening test in Uganda, the Card (Rose Bengal) test, deploys a B. abortus/suis antigen that would miss the detection of rough Brucella spp. such as B. canis and B. ovis.42 Also, cross-reaction is not uncommon when using Card (Rose Bengal), leading to false positives. The smooth lipopolysaccharide O-chain of smooth B. abortus, B. melitensis and B. suis and other Gram-negative bacteria expressing the lipopolysaccharide O-chain (such as Escherichia coli O157:H7 and Yersinia enterocolitica O:9) have been shown to cross-react with the Card (Rose Bengal) test (B. abortus/suis antigen).43 Also, the Card test does not differentiate between vaccinated and infected animals, or of the recovered individuals (as would be expected in a brucellosis-endemic setting) from those with active infection.34 On the other hand, the RPPA test is a quantitative and specific test which is able to rule out false-positive serological reactions.34 These factors could account for the difference in results between the Card and the RPPA test.
Additionally, even though there was agreement between the three serological screening tests (Card, BAPA and SP) the different screening serological tests target a different cluster of antibodies, some of which are not recognised by the OIE. For instance, the SP test lacks OIE recognition and detects immunoglobulin M, immunoglobulin G2, and immunoglobulin A (unpublished data, NVSL protocols, Ames Iowa, United States). While the BAPA test has OIE recognition, it detects mainly immunoglobulin G1 and immunoglobulin G2 and has a sensitivity ranging from 70% - 99%.44 Therefore, the use of any one of the screening tests in isolation could infer non-detection of some of the antibody types. In this study, the screening tests were in total agreement, meaning that at least one of the antibody types they target was present, pointing to possible prior exposure or other cross-reactions, but not infection (as this would be confirmed using the RPPA).
The RPPA test showed that all the test samples from humans and dogs were negative for brucellosis caused by the smooth Brucella strains. Specifically, the canine blood samples were negative for the highly pathogenic canine B. suis. The findings of this study contrasted with those of a similar study that showed a seroprevalence of 7.5% for human brucellosis in humans using the Card test alone.3 The difference could be attributable to the fact that they did not use a quantitative confirmatory serological test (RPPA) alongside the Card test.
Since a positive brucellosis test would necessitate long-term use of antibiotics,45 an incorrect brucellosis diagnosis (false-positive serological reaction) means that patients are placed on unnecessary antibiotics, this in turn aids the development of antibiotic resistance.41 Misdiagnosis of the causes of febrile illness in Uganda is a common cause of the misuse of antibiotics.46
Limitations
The serological tests that were used in this study deployed antigens that could not aid the detection of rough colony Brucella spp. such as B. canis and B. ovis. Brucella canis is a species specific to dogs. Therefore, even though the residual samples were negative for B. abortus and B. suis they may not be negative for B. canis.
The Flourescent Polarisation assay is the recommended serological confirmatory test for brucellosis, but it was not used in this study; instead we used a supplemental confirmatory serological test. In this study we did not confirm infection by carrying out a culture for brucellosis.
To the best of our knowledge, the findings of this study can be used as per the scope of the study and in light of its limitations as clearly pointed out.
Conclusion
This study used the traditional brucellosis screening tests (BAPA, Card and SP) in addition to a quantitative serological confirmatory test (RPPA). The additional use of RPPA confirmed as negative the positive results obtained using the BAPA, SP and Card tests. This implies that the improved specificity on using RPPA might help improve diagnostic accuracy by ruling out false-positive serological reactions. Since this study did not set out to detect B. canis in dogs, but rather canine B. suis, other serological tests specific to B. canis would help to complete the brucellosis picture in dogs.
Acknowledgements
We acknowledge the Norman. E. Borlaug International Fellowship and the National Veterinary Services Laboratory for providing the serological reagents.
Competing interests
The authors declare that there are no financial or personal relationships that may have had an influence in the writing of this article.
Authors' contributions
J.B.K. participated in the conception of the idea, data analysis, and writing of the manuscript. T.N. and J.T. participated in the processing of the samples, and writing of the manuscript.
Sources of support
Funds for this study were provided by the Norman. E. Borlaug International Fellowship in the East African region.
Data availability statement
Data is available from the corresponding author upon reasonable request.
Disclaimer
The views and opinions expressed in this article are those of the authors and do not necessarily reflect the official policy or position of any affiliated agency of the authors.
References
1.Godfroid J. Brucellosis in livestock and wildlife: Zoonotic diseases without pandemic potential in need of innovative one health approaches. Arch Public Health. 2017;75:34. https://doi.org/10.1186/s13690-017-0207-7 [ Links ]
2.Nguna J, Dione M, Apamaku M, et al. Seroprevalence of brucellosis and risk factors associated with its seropositivity in cattle, goats and humans in Iganga District, Uganda. Pan Afr Med J. 2019;33:99. https://doi.org/10.11604/pamj.2019.33.99.16960 [ Links ]
3.Majalija S, Luyombo P, Tumwine G. Sero-prevalence and associated risk factors of Brucellosis among Malaria negative febrile out-patients in Wakiso district, Central Uganda. BMC Res Notes. 2018;11(1):803. https://doi.org/10.1186/s13104-018-3907-3 [ Links ]
4.Dutta D, Sen A, Gupta D, et al. Childhood Brucellosis in Eastern India. Indian J Pediatr. 2018; 85, 266-271. https://doi.org/10.1007/s12098-017-2513-z [ Links ]
5.Roushan MR, Amiri MJ. Update on childhood brucellosis. Recent Pat Antiinfect Drug Discov. 2013;8(1):42-46. https://doi.org/10.2174/1574891X11308010008 [ Links ]
6.OIE. Handistatus II: Zoonoses (human cases): Global cases of brucellosis in 2004. Paris, France: OIE; 2004. [ Links ]
7.Pappas G, Papadimitriou P, Akritidis N, et al. The new global map of human brucellosis. Lancet Infect Dis. 2006;6(2):91-99. https://doi.org/10.1016/S1473-3099(06)70382-6 [ Links ]
8.Pacheco WA, Genovez ME, Pozzi CR, et al. Excretion of Brucella abortus vaccine B19 strain during a reproductive cycle in dairy cows. Braz J Microbiol. 2012;43(2):594-601. https://doi.org/10.1590/S1517-83822012000200022 [ Links ]
9.Sabrina R, Mossadak HT, Bakir M, et al. Detection of Brucella spp. in milk from seronegative cows by real-time polymerase chain reaction in the region of Batna, Algeria. Vet World. 2018;11(3):363-367. https://doi.org/10.14202/vetworld.2018.363-367 [ Links ]
10.Islam MS, Islam MA, Khatun MM, et al. Molecular detection of Brucella spp. from milk of seronegative cows from some selected area in Bangladesh. J Pathog. 2018;2018:9378976. https://doi.org/10.1155/2018/9378976 [ Links ]
11.Thorsdottir I, Thorisdottir AV. Whole cow's milk in early life. Nestle Nutr Workshop Ser Paediatr Program. 2011;67:29-40. https://doi.org/10.1159/000325573 [ Links ]
12.Huber JD, Nicoletti P. Comparison of the results of card, rivanol, complement-fixation, and milk ring tests with the isolation rate of Brucella abortus from cattle. Am J Vet Res. 1986;47(7):1529-1531. [ Links ]
13.Alirezalu K, Munekata PES, Parniakov O, et al. Pulsed electric field and mild heating for milk processing: A review on recent advances. J Sci Food Agric. 2019;100(1):16-24. https://doi.org/10.1002/jsfa.9942 [ Links ]
14.Sfeir MM. Raw milk intake: Beware of emerging brucellosis. J Med Microbiol. 2018;67(5):681-682. https://doi.org/10.1002/jsfa.9942 [ Links ]
15.Cossaboom CM, Kharod GA, Salzer JS, et al. Notes from the Field: Brucella abortus vaccine strain RB51 infection and exposures associated with raw milk consumption - Wise County, Texas, 2017. MMWR Morb Mortal Wkly Rep. 2018;67(9):286. https://doi.org/10.15585/mmwr.mm6709a4 [ Links ]
16.Tumwine G, Matovu E, Kabasa JD, et al. Human brucellosis: Sero-prevalence and associated risk factors in agro-pastoral communities of Kiboga District, Central Uganda. BMC Public Health. 2015;15:900. https://doi.org/10.1186/s12889-015-2242-z [ Links ]
17.Abd El-Wahab EW, Hegazy YM, El-Tras WF, et al. A multifaceted risk model of brucellosis at the human-animal interface in Egypt. Transboundary and Emerging Diseases. 2019;66(6):2383-2401. https://doi.org/10.1111/tbed.13295 [ Links ]
18.Ekpanyaskul C, Santiwattanakul S, Tantisiriwat W, et al. Factors associated with seropositive antibodies to Brucella melitensis in the Nakhon Nayok, Thailand. J Med Assoc Thai. 2012;95 Suppl 12:S40-S46. [ Links ]
19.Mor SM, Wiethoelter AK, Lee A, et al. Emergence of Brucella suis in dogs in New South Wales, Australia: Clinical findings and implications for zoonotic transmission. BMC Vet Res. 2016;12(1):199. https://doi.org/10.1186/s12917-016-0835-0 [ Links ]
20.Wareth G, Melzer F, El-Diasty M, et al. Isolation of Brucella abortus from a dog and a cat confirms their biological role in re-emergence and dissemination of Bovine Brucellosis on dairy farms. Transbound Emerg Dis. 2017;64(5):e27-e30. https://doi.org/10.1111/tbed.12535 [ Links ]
21.Trampuz A, Jereb M, Muzlovic I, et al. Clinical review: Severe malaria. Crit Care. 2003;7(4):315-323. https://doi.org/10.1186/cc2183 [ Links ]
22.Alemnji GA, Zeh C, Yao K, et al. Strengthening national health laboratories in sub-Saharan Africa: A decade of remarkable progress. Trop Med Int Health. 2014;19(4):450-458. https://doi.org/10.1111/tmi.12269 [ Links ]
23.Migisha R, Dan N, Boum Y, et al. Prevalence and risk factors of brucellosis among febrile patients attending a community hospital in south western Uganda. Sci Rep. 2018;8(1):15465. https://doi.org/10.1038/s41598-018-33915-9 [ Links ]
24.Bozdemir SE, Altintop YA, Uytun S, et al. Diagnostic role of mean platelet volume and neutrophil to lymphocyte ratio in childhood brucellosis. Korean J Intern Med. 2017;32(6):1075-1081. https://doi.org/10.3904/kjim.2016.092 [ Links ]
25.Ducrotoy MJ, Ammary K, Ait Lbacha H, et al. Narrative overview of animal and human brucellosis in Morocco: Intensification of livestock production as a driver for emergence? Infect Dis Poverty. 2015;4:57. https://doi.org/10.1186/s40249-015-0086-5 [ Links ]
26.Brennan A, Cross PC, Portacci K, et al. Shifting brucellosis risk in livestock coincides with spreading seroprevalence in elk. PLoS One. 2017;12(6):e0178780. https://doi.org/10.1371/journal.pone.0178780 [ Links ]
27.Hubbard K, Wang M, Smith DR. Seroprevalence of brucellosis in Mississippi shelter dogs. Prev Vet Med. 2018;159:82-86. https://doi.org/10.1016/j.prevetmed.2018.09.002 [ Links ]
28.Ducrotoy MJ, Bardosh KL. How do you get the Rose Bengal Test at the point-of-care to diagnose brucellosis in Africa? The importance of a systems approach. Acta Trop. 2017;165:33-39. https://doi.org/10.1016/j.actatropica.2016.10.004 [ Links ]
29.Orduña A, Almaraz A, Prado A, et al. Evaluation of an immunocapture-agglutination test (Brucellacapt) for serodiagnosis of human brucellosis. J Clin Microbiol. 2000;38(11):4000-4005. https://doi.org/10.1128/JCM.38.11.4000-4005.2000 [ Links ]
30.Diaz R, Casanova A, Ariza J, Moriyon I. The Rose Bengal test in human brucellosis: A neglected test for the diagnosis of a neglected disease. PLoS Negl Trop Dis. 2011;5(4):e950. https://doi.org/10.1371/journal.pntd.0000950 [ Links ]
31.Muloki HN, Erume J, Owiny DO, et al. Prevalence and risk factors for brucellosis in prolonged fever patients in post-conflict Northern Uganda. Afr Health Sci. 2018;18(1):22-28. https://doi.org/10.4314/ahs.v18i1.4 [ Links ]
32.Tumwine G, Matovu E, Kabasa JD, et al. Human brucellosis: Sero-prevalence and associated risk factors in agro-pastoral communities of Kiboga District, Central Uganda. BMC Publ Health. 2015;15:900. [ Links ]
33.Erume J, Roesel K, Dione MM, et al. Serological and molecular investigation for brucellosis in swine in selected districts of Uganda. Trop Anim Health Prod. 2016;48(6):1147-1155. [ Links ]
34.Hall SM, Confer AW, Tabatabai LB, et al. Detection of serum antibody to Brucella abortus in cattle by use of a quantitative fluorometric immunoassay. J Clin Microbiol. 1984;20(6):1023-1027. [ Links ]
35.Bejon P, Andrews L, Hunt-Cooke A, et al. Thick blood film examination for Plasmodium falciparum malaria has reduced sensitivity and underestimates parasite density. Malar J. 2006;5:104. [ Links ]
36.Dean AG SK, Soe MM. OpenEpi: Open source epidemiologic statistics for public health, Version 3 [homepage on the Internet]. n.d. [updated 2013 June 04; cited 2019 Aug 15]. Available from: www.OpenEpi.com [ Links ]
37.Assenga JA, Matemba LE, Muller SK, et al. Epidemiology of Brucella infection in the human, livestock and wildlife interface in the Katavi-Rukwa ecosystem, Tanzania. BMC Vet Res. 2015;11:189. [ Links ]
38.Acosta-González RI, González-Reyes I, Flores-Gutiérrez GH. Prevalence of Brucella abortus antibodies in equines of a tropical region of Mexico. Can J Vet Res. 2006;70(4):302-304. [ Links ]
39.Ducrotoy MJ, Bertu WJ, Ocholi RA, et al. Brucellosis as an emerging threat in developing economies: Lessons from Nigeria. PLoS Negl Trop Dis. 2014;8(7):e3008. [ Links ]
40.Njeru J, Wareth G, Melzer F, et al. Systematic review of brucellosis in Kenya: Disease frequency in humans and animals and risk factors for human infection. BMC Publ Health. 2016;16(1):853. [ Links ]
41.De Glanville WA, Conde-Álvarez R, Moriyón I, et al. Poor performance of the rapid test for human brucellosis in health facilities in Kenya. PLoS Negl Trop Dis. 2017;11(4):e0005508. [ Links ]
42.Ebani VV, Cerri D, Fratini F, Bey RF, Andreani E. Serological diagnosis of brucellosis caused by Brucella canis. New Microbiol. 2003;26(1):65-73. [ Links ]
43.Bonfini B, Chiarenza G, Paci V, et al. Cross-reactivity in serological tests for brucellosis: A comparison of immune response of Escherichia coli O157:H7 and Yersinia enterocolitica O:9 vs Brucella spp. Vet Ital. 2018;54(2):107-114. [ Links ]
44.OIE. Manual of diagnostic tests and vaccines for terrestrial animals [homepage on the Internet]. 2018 [cited 2019 Oct 15]. Available from: https://www.oie.int/international-standard-setting/terrestrial-manual [ Links ]
45.Yuan MJ, Li SH, Huang Y, et al. Diagnosis and treatment of seven patients with brucellosis in non-pastoral areas. Zhonghua Nei Ke Za Zhi. 2019;58(8):596-598. [ Links ]
46.Batwala V, Magnussen P, Nuwaha F. Antibiotic use among patients with febrile illness in a low malaria endemicity setting in Uganda. Malar J. 2011;10:377. [ Links ]
Correspondence:
John Kalule
kaluleb@gmail.com
Received: 12 July 2018
Accepted: 06 July 2020
Published: 30 Sept. 2020
ORIGINAL RESEARCH
Review of the Stepwise Laboratory Quality Improvement Process Towards Accreditation (SLIPTA) version 2:2015
Tjeerd A.M. DatemaI; Linda OskamI; Jacqueline E.W. BroerseII; Paul R. KlatserIII
IDATOS B.V., Leiden, the Netherlands
IIDepartment of Science Communication, Faculty of Science, Vrije Universiteit Amsterdam, Amsterdam, the Netherlands
IIIAthena Institute, Faculty of Science, Vrije Universiteit Amsterdam, Amsterdam, the Netherlands
ABSTRACT
BACKGROUND: In 2011 the Stepwise Laboratory Quality Improvement Process Towards Accreditation (SLIPTA) was launched, aimed at strengthening the quality and competence of African clinical, public health and reference laboratories. We reviewed the first version of the SLIPTA checklist in 2011. The continued development and publication of a new version of the International Organization for Standardization (ISO) 15189 standard demands a renewed review
OBJECTIVE: This study aimed to determine the suitability of SLIPTA in guiding laboratories towards ISO 15189:2012 compliance and accreditation and provide recommendations for further SLIPTA improvement
METHODS: The study was conducted between September 2018 and April 2019. Coverage of ISO 15189:2012 by SLIPTA checklist version 2:2015 was determined and the point distribution of the scoring system over the different sections of the SLIPTA checklist was re-investigated. These findings were compared with the review of the first version of the SLIPTA checklist (based on ISO 15189:2007) and with findings published on SLIPTA implementation and roll-out
RESULTS: The coverage of ISO 15189 by the SLIPTA checklist has increased, even though ISO 15189:012 is more extensive than ISO 15189:2007. The point distribution is still skewed towards sections related to quality planning rather than quality control and improvement. Although to date 314 laboratories have been assessed, barriers for laboratories to participate in SLIPTA are high. Sustainability of SLIPTA results is insufficiently studied
CONCLUSION: SLIPTA checklist version 2:2015 has improved compared to earlier versions. We recommend increasing accessibility for laboratories to participate and increasing guidance for ISO-based quality management system implementation
Keywords: accreditation; ISO 15189; laboratory; SLIPTA; SLMTA; quality assurance; total quality management.
Introduction
In 2011 the Stepwise Laboratory Quality Improvement Process Towards Accreditation (SLIPTA) was launched, aimed at strengthening quality and competence of clinical, public health and reference laboratories in the African region.1,2,3,4 The launch of SLIPTA was the result of a series of events. In 2008 the World Health Organization (WHO) and the United States Centers for Disease Control and Prevention (CDC) organised a conference on laboratory quality systems. One of the recommendations stated that laboratories in resource-limited settings should consider taking a staged approach towards implementation of a quality management system (QMS).5,6 In the following years, several resolutions on laboratory strengthening were drafted for the African region.7,8 In 2009, the WHO Regional Office for Africa (WHO-AFRO), in collaboration with CDC and other partners, launched the WHO-AFRO laboratory accreditation process and the Strengthening Laboratory Management Towards Accreditation (SLMTA) training and mentoring programme.9,10,11,12 In 2011, the WHO-AFRO accreditation process was renamed SLIPTA.4,10,13
In 2012, WHO-AFRO designated the African Society for Laboratory Medicine (ASLM) as the SLIPTA secretariat.4,12,14 The ASLM established SLIPTA's implementation structure consisting of4,14:
•WHO-AFRO SLIPTA Focal Point, responsible for mobilisation of resources, providing guidance on content and implementation, and reviewing and updating SLIPTA.
•Ministry of Health SLIPTA Focal Point, responsible for -in-country promotion of laboratory improvement through SLIPTA. The ministry of health develops an implementation plan and prioritises SLIPTA applicant laboratories and allocates financial and human resources for SLIPTA implementation.
•ASLM-certified SLIPTA auditors, responsible for conducting audits and providing advice to auditees.
•SLIPTA independent advisory group, enrolling laboratories into the SLIPTA programme, organising audits and making a final decision on laboratory recognition through awarding a star rating based on audit reports (varying from zero to five stars) (Table 1). Star ratings are valid for a two-year period.12,14

The ASLM aims to enrol 2500 laboratories in SLIPTA and have 250 public laboratories accredited to international standards by 2020.12
Not all laboratories can voluntarily participate in SLIPTA because ministries of health are encouraged to select laboratories in phases, considering tiered laboratory networks and giving precedence to laboratories that have already completed laboratory quality improvement training. Eligibility criteria include a SLIPTA self-audit score of 55% or higher, participation in proficiency testing schemes or alternative methods in the past 6 months and having conducted internal audits and a management review in the past 12 months. The laboratory should also have documented its QMS.14
Upon enrolment a laboratory is audited to determine its initial star rating. Laboratories are expected to work towards the next star. Laboratories that achieve a five-star rating are encouraged to apply for ISO 15189 accreditation.14
Key in the SLIPTA programme is the SLIPTA checklist, which is primarily based on ISO 15189 and, to a lesser extent, Clinical and Laboratory Standards Institute (CLSI) guideline QMS01-A4.3,15 Because laboratories with a five-star rating are encouraged to apply for accreditation, it is important to obtain insight into the coverage of ISO 15189 requirements by the SLIPTA checklist. This determines how much of the ISO 15189 requirements still must be addressed before full compliance with ISO 15189 is achieved. In 2011, the authors reviewed the first version of the SLIPTA checklist (published in 2009), referred to as the alpha version,16 and determined coverage of ISO 15189:2007.1 In that same year SLIPTA was revised and the SLIPTA alpha version became SLIPTA checklist v1.0.11,12 Because a new version of the ISO 15189 standard was published in 2012, SLIPTA checklist v2, based on ISO 15189:2012, was published in 2015.3,12 The current study determines coverage of ISO 15189:2012 by SLIPTA checklist v2:2015 and re-investigates the point division over the different sections of the SLIPTA checklist to determine the relative weight of QMS elements in SLIPTA. We also reviewed published SLIPTA implementation data.
This article informs potential users about SLIPTA's suitability to guide laboratories towards ISO 15189:2012 compliance and accreditation and provides recommendations for further improvement of SLIPTA.
Methods
Ethical considerations
Ethical clearance was not required for this study.
Study design
The study was conducted between September 2018 and April 2019. The methodology used in this study was adapted from Datema et al. 2011.1 The first analysis determined the SLIPTA checklist's coverage of ISO 15189:2012 by linking each question of SLIPTA checklist v2:2015 to ISO 15189:2012 clauses. The second analysis provides insight into the point distribution of the scoring system over the different SLIPTA checklist sections. The SLIPTA checklist is divided into 12 sections corresponding with 12 QMS elements. For each section, points can be scored, the total of which determines the number of stars awarded. Excel 2016 (Microsoft, Redmond, Washington, United States) was used to analyse and compare the number of points that can be scored per section. Results were compared with results of the review of the SLIPTA checklist alpha version.1 In Datema et al. 2011, the 12 sections of the SLIPTA checklist were divided over the categories 'Resource Management', 'Process Management' and 'Improvement Management'. In this article we renamed these categories to 'quality planning', 'quality control' and 'quality improvement', in line with the Juran Trilogy (Table 2).17 The overall intention of each SLIPTA checklist section led the categorisation process, which was identical to the review of the alpha version of the SLIPTA checklist.1 Hence, the overall aim of the sections assigned to the Juran category quality planning is to ensure quality of work before it is started, that is, before work can be conducted in a quality-assured way, proper organisation and functioning of equipment, purchasing and inventory management processes, good facilities and competent personnel are needed. As such, with the implementation of these elements the laboratory is 'planning for quality', justifying the decision for assigning these sections to the Juran category quality planning. Similarly, the primary, shared objective of the sections on process control, information management, documents and records, and client management is to control quality of work while it is being conducted. Therefore, these sections were assigned to the Juran category quality control. The sections on management reviews, evaluation and audits, occurrence or incident management and process improvement, and identification of non-conformities, corrective and preventive actions all share the common goal of continuously improving the quality of laboratory work. Therefore, these sections were assigned to the Juran category quality improvement.

A PubMed search was conducted on 06 March 2019 to gather literature on outcomes of SLIPTA implementation and roll-out. The search terms were 'SLIPTA' OR 'Stepwise Laboratory Improvement Process Towards Accreditation' and the search yielded 29 hits. After primary and secondary selection based on title and abstract, and identification of additional reports through snowballing, a total of 23 articles were identified. Upon further scrutiny 12 papers were excluded because they did not report findings on SLIPTA implementation, roll-out, effectiveness or sustainability per se. Finally, 11 papers were included.
Results
Changes to Stepwise Laboratory Quality Improvement Process Towards Accreditation checklist v2:2015 compared with the alpha version
Structurally, SLIPTA checklist v2:2015 is very similar to the alpha version. The checklist is still divided over 12 sections based on the Quality System Essential structure developed by the CLSI.15 A notable change is the addition of one very detailed question on the presence and content of 36 specific standard operating procedures (SOPs).
ISO 15189:2012 coverage
The SLIPTA checklist v2:2015 addresses 82% of ISO 15189:2012 clauses, of which 35% are fully addressed, 47% addressed partially and 18% are not addressed at all. This is an improvement compared to the alpha version, which wholly or partially covered 52% of ISO 15189:2007 clauses. In some areas SLIPTA checklist v2:2015 is more detailed and prescriptive compared to ISO 15189 requirements, whereas in other areas ISO 15189 requirements are more extensive than the SLIPTA checklist.
Point distribution and relative weight (importance) of quality management system elements
The total number of points in the SLIPTA checklist v2:2015 has increased from 250 to 275. In most sections a higher number of points can be scored compared to the alpha version. However, the relative weight of each section has remained similar due to the increase in the total number of points (see Figure 1).

When the point distribution of the SLIPTA checklist v2:2015 scoring system was analysed using the Juran Trilogy model, points were still heavily skewed towards quality planning (45% of the weight) and quality control (33%). Quality improvement received the lowest number of points (22%) (Figure 2).

Outcomes of Stepwise Laboratory Quality Improvement Process Towards Accreditation roll-out
Up to 24 April 2019, 314 laboratories had been audited in 20 countries, which is still far below the ambition to enrol 2500 laboratories by 2020 (Table 3).18 The percentage of laboratories per star rating is shown in Figure 3. The distribution is still in line with data published by Ndihokubwayo et al. in 2016, and Andiric et al. in 2018.12,19

Although many papers have been published on the SLMTA training and mentoring programme, in which the SLIPTA checklist was used to measure progress, papers evaluating the SLIPTA initiative per se are scarce. The paper by Ndihokubwayo et al. (2016) is the only paper summarising SLIPTA implementation and lessons learned.12 Two additional papers were found that present SLIPTA implementation findings, but these also combined SLIPTA with additional assistance.20,21 Both studies indicated that combining SLIPTA with mentoring has a positive effect on QMS implementation, although neither control laboratories nor findings on sustainability of this model were included.20,21
Ndihokubwayo et al. found that SLIPTA laboratories performed most poorly on the internal audit and corrective action sections.12 This finding is corroborated by other studies.22,23,24,25,26,27,28 They further state that advocacy for laboratory strengthening is key to the SLIPTA process (as it is owned by the ministry of health) and that particularly Francophone and Lusophone countries are not well covered. An explanation for the latter finding might be that SLIPTA was initially implemented through the United States President's Emergency Plan for AIDS Relief, which is oriented towards Anglophone countries.12
Discussion
SLIPTA checklist v2:2015 has improved compared to the alpha version. Even though ISO 15189:2012 is more extensive than ISO 15189:2007, ISO 15189 coverage has increased, decreasing the gap that still needs to be bridged by 5-star laboratories aiming for ISO 15189 accreditation. However, the gap is still considerable: only 35% of ISO 15189 clauses are fully covered, leaving 47% partially covered and 18% not covered at all. Compliance with some of these requirements may be reached as part of the continuous improvement process which 5-star laboratories may have already partially implemented.
The main point for SLIPTA improvement remains the absence of prioritisation of QMS implementation activities. There are no conditions for the different star ratings (other than the star rating thresholds) that encourage laboratories to implement the QMS in a specific, rational manner, indicating that QMS implementation guidance remains limited. Most SLIPTA checklist v2:2015 questions are supplemented with short notes including examples, but neither a stepwise plan nor a detailed explanation of implementation of requirements is provided, showing that SLIPTA remains primarily an assessment checklist. SLIPTA auditors may provide advice on implementation during assessments4,12 but this might come late, for laboratories may first try to implement a QMS before being assessed as laboratories must score at least 55% in self-assessment to meet eligibility criteria for enrolment.14
Currently, most points can be scored in SLIPTA checklist sections related to quality planning, followed by quality control. The least number of points can be scored on quality improvement. This creates an imbalance. Implementing a QMS is a 'systems approach': all QMS elements work together to create a sustainable system that can deliver quality-assured laboratory services and continuously improve itself. When one QMS element is not (correctly) functioning, quality assurance of overall laboratory services and continuous quality improvement may be compromised. Therefore, one could argue that SLIPTA should award an equal number of points for each section. On the other hand, the skewed point distribution may point laboratories in the right direction by encouraging them to address sections related to quality planning first because of the high number of points that can be scored in this category, as was also argued by Datema et al. in 2011 (although no evidence was found in literature supporting this hypothesis).1 However, this is counterbalanced by the higher amount of work required for implementing the sections related to quality planning.
Another improvement opportunity for the SLIPTA checklist is the imbalance in the effort required to earn points per question. For example, for question 1.5 one needs to develop 36 SOPs to earn five points, whereas by developing a list of documents used in the laboratory (question 1.4), making sure that SOPs are accessible to staff (question 1.6), and indicating date of authorisation, location and date of discontinuation on each SOP (question 1.8) one can score a total of six points. Writing 36 SOPs obviously requires considerably more effort.
Stepwise Laboratory Quality Improvement Process Towards Accreditation implementation and roll-out
A strong point is that SLIPTA requires the ministry of health to play an active role; government commitment has been shown to be key to success in both SLIPTA21 and SLMTA.11,12,20,24,25,27,29,30,31,32,33,34,35 Also, SLIPTA can be well combined with other guidance methods for laboratory accreditation as is evident from many studies on SLMTA implementation.20,22,27,29,30,33,34,35,36
A major downside is the indirect accessibility of the SLIPTA programme: laboratories are selected by the ministry of health for participation. Only 27 of the 47 WHO-AFRO member states have established a SLIPTA focal point within their ministry of health. Moreover, the programme has a language bias towards Anglophone countries.12,18,28 Also, up to April 2019, 314 laboratories had been assessed, which is low considering that Kampala, the capital of Uganda, alone counts 954 laboratories18,37 and that ASLM aimed to include 2500 laboratories by 2020.12
Recommendations for improvement
The level of guidance provided by SLIPTA for QMS implementation could be increased by making better use of the star rating system. Currently, stars are simply awarded based on the number of points scored, regardless of the section these points are scored in. Setting certain benchmarks and conditions for the different star ratings may improve guidance. An example could be the definition of key questions that have to be implemented for each star rating. This may help laboratories in using a rational approach towards QMS implementation. It may also assist laboratories in lower tiers of laboratory networks, for which ISO 15189:2012 is not (yet) feasible, to implement a basic yet functional QMS. The phased approach incorporated in the WHO Laboratory Quality Stepwise Implementation (LQSI) tool as well as the tiered approach of the Laboratory Quality Management System Stepwise Improvement Process (LQMS-SIP) used in the Caribbean region could serve as models in assigning key questions to the different star ratings, which would also contribute to harmonisation of SLIPTA with these laboratory strengthening tools and initiatives.38,39,40
Sustainability is a challenge for laboratory strengthening efforts. Literature on SLIPTA implementation does not provide sufficient clarity on sustainability. SLIPTA assessments, like accreditation assessments in general, are snapshot measurements of laboratory compliance, creating the risk that the efforts may weaken after an assessment, as was also witnessed in SLMTA evaluations.11,24,32 A possible measure to decrease this risk is announcing assessment visits only shortly before they are scheduled, leaving just enough time for a laboratory to prepare logistics but not for correction of elements that would otherwise not have been corrected, yielding a more representative view of the daily practice. Another measure is the adoption of a point scoring system that awards negative points for questions that are not in place anymore compared to the previous assessment. This emphasises the importance of quality assurance and may be an extra driver for the laboratory to ensure continued compliance. In the case of SLIPTA, both measures could be adopted without requiring major revisions as it would primarily require amendment of the audit scoring section of the SLIPTA checklist. It should be noted that SLIPTA checklist v2:2015 already indicates that audit scores should be based on laboratory performance during the 12 months preceding the SLIPTA audit, which is an encouragement for laboratories to maintain compliance.3
The last recommendations relate to implementation and roll-out of SLIPTA: increasing the accessibility of SLIPTA by increasing the capacity, among others through ensuring the presence of SLIPTA focal points at each ministry of health and training of more SLIPTA auditors. This should include training of more SLIPTA auditors fluent in Portuguese and French to increase accessibility for laboratories in Lusophone and Francophone countries.
Limitations
The analysis using the Juran Trilogy model was limited to categorisation of overall SLIPTA sections. Although the authors are aware that the same analysis can be conducted at the individual question level, the decision was made to categorise based on the overall intention of each SLIPTA section and, therefore, categorise each SLIPTA checklist section as a whole as described in the methods section. This was also required to enable comparison with the review of the alpha version of the checklist. This study is a desk-based review. Ideally, the findings of this study should be triangulated through an observational study monitoring SLIPTA implementation with a sufficiently large sample size. This would enable substantiation of the findings and may reveal additional opportunities for improvement of the SLIPTA checklist and programme.
Conclusion
SLIPTA checklist v2:2015 has improved compared to the alpha version. Suggestions for improvement are mainly related to the point scoring system, including the designation of key questions to specific star ratings to improve the level of guidance for implementation of a QMS. The LQSI tool and LQMS-SIP could serve as examples, leading to harmonisation of SLIPTA with these tools. Recommendations for enhanced SLIPTA roll-out include increasing accessibility by translation into French and Portuguese, training more auditors, and increasing capacity for participation.
Acknowledgements
Competing interests
The authors have declared that no competing interests exist.
Authors' contributions
T.A.M.D. designed and performed the review and wrote the manuscript. L.O., J.E.W.B. and P.R.K. critically reviewed the analysis and the manuscript. All authors approved the present version of the manuscript.
Sources of support
This research received no specific grant from any funding agency in the public, commercial, or not-for-profit sectors.
Data availability statement
Data are available upon request.
Disclaimer
The views and opinions expressed in this article are those of the authors and do not necessarily reflect the official policy or position of any affiliated agency of the authors.
References
1.Datema TAM, Oskam L, van Beers SM, Klatser PR. Critical review of the Stepwise Laboratory Improvement Process Towards Accreditation (SLIPTA): Suggestions for harmonization, implementation and improvement. Trop Med Int Health. 2012;17(3):361-367. https://doi.org/10.1111/j.1365-3156.2011.02917.x [ Links ]
2.World Health Organization Regional Office for Africa. Laboratory accreditation checklist. Brazzaville: WHO-AFRO; 2009. [ Links ]
3.World Health Organization Regional Office for Africa. Stepwise laboratory quailty improvement process towards accreditation (SLIPTA) checklist. Brazzaville: WHO-AFRO; 2015. [cited 2019 March 06]. Available from: https://apps.who.int/iris/bitstream/handle/10665/204423/slipta-checkist0711.pdf?sequence=1&isAllowed=y [ Links ]
4.World Health Organization Regional Office for Africa. WHO guide for the stepwise laboratory improvement process towards accreditation in the African Region (SLIPTA). Brazzaville: WHO-AFRO; 2015 [cited 2019 March 06]. Available from: http://www.afro.who.int/en/who-guide-for-the-stepwise-laboratory-improvement-process-towards-accreditation-in-the-african-region-with-checklist.html [ Links ]
5.World Health Organisation. Joint WHO - CDC conference on health laboratory quality systems. Lyon: WHO; 2008. Available from: https://www.who.int/csr/ihr/lyon/report20080409.pdf?ua=1 [ Links ]
6.World Health Organization. Joint WHO-CDC conference on laboratory quality systems, Lyon, April 2008 - Joint statement and recommendations. Wkly Epidemiol Rec. 2008;83(32):285-292. [cited 2019 March 06]. Available from: http://www.who.int/wer/2008/wer8332/en/ [ Links ]
7.World Health Organization Regional Office for Africa. The Maputo declaration on strengthening of laboratory systems. Maputo: WHO-AFRO; 2008. Available from: http://www.who.int/diagnostics_laboratory/Maputo-Declaration_2008.pdf [ Links ]
8.Regional Committee for Africa. Strengthening public health laboratories in the WHO African Region: A critical need for disease control (resolution AFR/RC58/6). Maputo: WHO-AFRO; 2008. [cited 2019 March 06]. Available from: https://www.afro.who.int/sites/default/files/2017-06/AFR-RC58-6.pdf [ Links ]
9.World Health Organization. Press release: Kigali host the launch of a program to accelerate national laboratory service capcity building towards accreditation in the African Region. Kigali: WHO; 2009 [cited 2019 March 06]. Available from: https://www.who.int/hiv/amds/diagnostics/amds_kigali_pr_lab.pdf [ Links ]
10.Nordling L. African disease labs to get health check. Nature. 2009. https://doi.org/10.1038/news.2009.735 [ Links ]
11.Andiric LR, Massambu CG. Laboratory quality improvement in Tanzania. Am J Clin Pathol. 2015;143(4):566-572. https://doi.org/10.1309/AJCPAB4A6WWPYIEN [ Links ]
12.Ndihokubwayo JB, Maruta T, Ndlovu N, et al. Implementation of the World Health Organization regional office for Africa stepwise laboratory quality improvement process towards accreditation. Afr J Lab Med. 2016;5(1):a280. https://doi.org/10.4102/ajlm.v5i1.280 [ Links ]
13.Gershy-Damet G-M, Rotz P, Cross D, et al. The World Health Organization African Region laboratory accreditation process. Am J Clin Pathol. 2010;134(3):393-400. https://doi.org/10.1309/AJCPTUUC2V1WJQBM [ Links ]
14.World Health Organization Regional Office for Africa. WHO/AFRO guide for the stepwise laboratory quality improvement process towards accreditation (SLIPTA) in the African Region - Revision 2 (draft). Brazzaville: WHO-AFRO; 2019. [ Links ]
15.Clinical and Laboratory Standards Institute. Quality management system : A model for laboratory services; Approved guideline - 4th ed. Wayne, PA: CLSI; 2011. [ Links ]
16.Yao K, McKinney B, Murphy A, et al. Improving quality management systems of laboratories in developing countries: An innovative training approach to accelerate laboratory accreditation. Am J Clin Pathol. 2010;134(3):401-409. https://doi.org/10.1309/AJCPNBBL53FWUIQJ [ Links ]
17.Juran JM. Juran on leadership for quality - An executive handbook. New York, NY: Collier Macmillan; 1989. [ Links ]
18.ASLM Laboratory Accreditation/SLIPTA - ASLM [homepage on the Internet]. [cited 2019 Apr 24]. Available from: http://www.aslm.org/slipta-map/ [ Links ]
19.Andiric LR, Chavez LA, Johnson M, Landgraf K, Milner Jr DA. Strengthening laboratory management toward accreditation, a model program for pathology laboratory improvement. Clin Lab Med. 2018;38(1):131-140. https://doi.org/10.1016/j.cll.2017.10.010 [ Links ]
20.Viegas SO, Azam K, Madeira C, et al. Mozambique's journey toward accreditation of the National Tuberculosis Reference Laboratory. Afr J Lab Med. 2017;6(2):a491. https://doi.org/10.4102/ajlm.v6i2.491 [ Links ]
21.Maruta T, Motebang D, Mathabo L, Rotz PJ, Wanyoike J, Peter T. Impact of mentorship on WHO-AFRO strengthening laboratory quality improvement process towards accreditation (SLIPTA). Afr J Lab Med. 2012;1(1):6. https://doi.org/10.4102/ajlm.v1i1.6 [ Links ]
22.Taremwa IM, Ampaire L, Iramiot J, et al. Assessment of three medical and research laboratories using WHO AFRO_SLIPTA quality standards in Southwestern Uganda: Long way to go. Pan Afr Med J. 2017;28(1):129. https://doi.org/10.11604/pamj.2017.28.129.10995 [ Links ]
23.Mokobela KO, Moatshe MT, Modukanele M. Accelerating the spread of laboratory quality improvement efforts in Botswana. Afr J Lab Med. 2014;3(2):207. https://doi.org/10.4102/ajlm.v3i2.207 [ Links ]
24.Mbah H, Ojo E, Ameh J, et al. Piloting laboratory quality system management in six health facilities in Nigeria. PLoS One. 2014;9(12):e116185. https://doi.org/10.1371/journal.pone.0116185 [ Links ]
25.Guevara G, Gordon F, Irving Y, et al. The impact of SLMTA in improving laboratory quality systems in the Caribbean Region. Afr J Lab Med. 2014;3(2):199. https://doi.org/10.4102/ajlm.v3i2.199 [ Links ]
26.Maina RN, Mengo DM, Mohamud AD, et al. Progressing beyond SLMTA: Are internal audits and corrective action the key drivers of quality improvement? Afr J Lab Med. 2014;3(2):222. https://doi.org/10.4102/ajlm.v3i2.222 [ Links ]
27.Mothabeng D, Maruta T, Lebina M, Lewis K, Wanyoike J, Mengstu Y. Strengthening laboratory management towards accreditation: The lesotho experience. Afr J Lab Med. 2012;1(1):9. https://doi.org/10.4102/ajlm.v1i1.9 [ Links ]
28.World Health Organization Regional Office for Africa. WHO/AFRO SLIPTA update [homepage on the Internet]. SLIPTA/SLMTA Symposium 2016; 2016 [cited 2019 Jul 17]. Available from: https://slmta.org/uploads/category_file/29/1.4-SLIPTAUpdates.pdf [ Links ]
29.Nzabahimana I, Sebasirimu S, Gatabazi JB, et al. Innovative strategies for a successful SLMTA country programme: The Rwanda story. Afr J Lab Med. 2014;3(2):a217. https://doi.org/10.4102/ajlm.v3i2.217 [ Links ]
30.Skaggs B, Pinto I, Masamha J, Turgeon D, Gudo ES. Implementing laboratory quality management systems in Mozambique: The becton dickinson-US President's emergency plan for AIDS relief public-private partnership initiative. J Infect Dis. 2016;213(Suppl 2):S47-S52. https://doi.org/10.1093/infdis/jiv544 [ Links ]
31.Yao K, Maruta T, Luman ET, Nkengasong JN. The SLMTA programme: Transforming the laboratory landscape in developing countries. Afr J Lab Med. 2014;3(3):a194. https://doi.org/10.4102/ajlm.v3i2.194 [ Links ]
32.Andiric LR, Massambu CG. One laboratory's progress toward accreditation in Tanzania. Afr J Lab Med. 2014;3(2):202. https://doi.org/10.4102/ajlm.v3i2.202 [ Links ]
33.Nkrumah B, Van der Puije B, Bekoe V, et al. Building local human resources to implement SLMTA with limited donor funding: The Ghana experience. Afr J Lab Med. 2014;3(2):a214. https://doi.org/10.4102/ajlm.v3i2.214 [ Links ]
34.Nkwawir SC, Batumani NN, Maruta T, Awasom CN. From grass to grace: How SLMTA revolutionised the Bamenda Regional hospital laboratory in Cameroon. Afr J Lab Med. 2014;3(2):a203. https://doi.org/10.4102/ajlm.v3i2.203 [ Links ]
35.Ntshambiwa K, Ntabe-Jagwer W, Kefilwe C, Samuel F, Moyo S. Translating a National Laboratory Strategic Plan into action through SLMTA in a district hospital laboratory in Botswana. Afr J Lab Med. 2014;3(2):a209. https://doi.org/10.4102/ajlm.v3i2.209 [ Links ]
36.Masamha J, Skaggs B, Pinto I, et al. Working toward a sustainable laboratory quality improvement programme through country ownership: Mozambique's SLMTA story. Afr J Lab Med. 2014;3(2):a253. https://doi.org/10.4102/ajlm.v3i2.253 [ Links ]
37.Elbireer AM, Jackson JB, Sendagire H, Opio A, Bagenda D, Amukele TK. The good, the bad, and the unknown: Quality of clinical laboratories in Kampala, Uganda. PLoS One. 2013;8(5):e64661. https://doi.org/10.1371/journal.pone.0064661 [ Links ]
38.Caricom Regional Organization for Standards and Quality [homepage on the Internet]. LQMS-SIP. [cited 2019 Jul 17]. Available from: https://www.crosq.org/index.php/projects/lqms-sip [ Links ]
39.Alemnji G, Edghill L, Guevara G, et al. Development and implementation of the Caribbean Laboratory Quality Management Systems Stepwise improvement process (LQMS-SIP) towards accreditation. Afr J Lab Med. 2017;6(1):a496. https://doi.org/10.4102/ajlm.v6i1.496 [ Links ]
40.World Health Organization. Laboratory quality stepwise implementation tool [homepage on the Internet]. 2014. [cited 2019 Jul 17]. Available from: https://extranet.who.int/lqsi [ Links ]
Correspondence:
Tjeerd Datema
t.datema@datos-advice.nl
Received: 18 July 2019
Accepted: 19 Aug. 2020
Published: 28 Oct. 2020
ORIGINAL RESEARCH
Postmortem diagnosis of COVID-19: Antemortem challenges of three cases at the 37 Military Hospital, Accra, Ghana
Seth A. AttohI; Frederick HobenuI; Lawrence EduseiII; Kwasi Agyeman-BediakoI; Clement T. LaryeaIII; Edward O. NyarkoIV; Michael K. AmediV; Richard H. AsmahVI; Edward AsumanuVII; Mary McAddyI; Anthony MaisonI; Godwin NyarkoI; Raymond D. FatchuVIII; Kafui AkakpoIX
IJ.M. Wadhwani Department of Anatomical Pathology, 37 Military Hospital, Accra, Ghana
IIDepartment of Pathology, Korle-bu Teaching Hospital, Accra, Ghana
IIIDepartment of Medicine, 37 Military Hospital, Accra, Ghana
IVPublic Health Division, 37 Military Hospital, Accra, Ghana
VDepartment of Radiology, 37 Military Hospital, Accra, Ghana
VIDepartment of Molecular Biology, University of Health and Allied Sciences, Ho, Ghana
VIIDepartment of Surgery, 37 Military Hospital, Accra, Ghana
VIIIDepartment of Pathology, 37 Military Hospital, Accra, Ghana
IXDepartment of Pathology, University of Cape Coast, Cape Coast, Ghana
ABSTRACT
BACKGROUND: Consistency among clinical symptoms, laboratory results and autopsy findings can be a quality measure in the diagnosis of coronavirus disease 2019 (COVID-19). There have been classic clinical cases that have met the case definition of COVID-19 but real-time reverse-transcription polymerase chain reaction (rRT-PCR) tests of nasopharyngeal swabs were negative
OBJECTIVES: This study aimed to share pathological observations of autopsies performed at the 37 Military Hospital's Department of Anatomical Pathology on three presumed COVID-19 cases in Accra, Ghana
METHOD: Complete autopsies with detailed gross and histopathological analysis were conducted between April 2020 and May 2020 on three suspected COVID-19 cases, of which two had initial negative (rRT-PCR) nasopharyngeal tests. Postmortem bronchopulmonary samples of two cases were collected and tested by rRT-PCR for severe acute respiratory syndrome coronavirus 2 (SARS-CoV-2
RESULTS: The two postmortem bronchopulmonary samples tested for SARS-CoV-2 by rRT-PCR were positive. Though no postmortem bronchopulmonary sample was taken from the third case, a close contact tested positive for SARS-CoV-2 in later contact tracing. For all three cases, lung histopathological findings were consistent with Acute Respiratory Distress Syndrome
CONCLUSION: The outcome of COVID-19 testing is dependent on the sample type and accuracy of sampling amongst other factors. Histopathological findings vary and may be dependent on a patient's modifying factors, as well as the duration of infection. More autopsies are required to fully understand the pathogenesis of this disease in Ghanaians
Keywords: COVID-19; autopsy; postmortem diagnosis; false-negative; Ghana.
Introduction
The global estimate of confirmed cases of coronavirus disease 2019 (COVID-19) as of 27 May 2020 stood at over 5.5 million in approximately 213 countries and territories with over 349 190 deaths, giving a mortality rate of 15.7%.1 In Ghana, the first confirmed COVID-19 case was reported on 12 March 2020. As at the end of May 2020, over 7303 cases, 34 deaths and 2412 recoveries had been recorded.2 COVID-19 emerged from Wuhan, Hubei Province, China in December 2019, and is clinically associated with viral pneumonia.3,4 Clinical, laboratory and radiological features for COVID-19 are non-specific; features are similar to other respiratory tract infections.5 Thus, mild symptoms of COVID-19 such as fever, cough, dyspnoea, myalgia and fatigue were initially treated and managed as pneumonia symptoms by healthcare workers.
The World Health Orginization (WHO) Situation Report 94 defines a suspected COVID-19 case as:
[A] person presenting with acute respiratory illness (fever and at least one sign/symptom of respiratory disease, e.g. cough, shortness of breath) AND no aetiology that fully explains the clinical presentation; OR A patient with an acute respiratory illness AND has been in contact with a confirmed or probable case of COVID-19 in the last 14 days before the onset of symptoms; OR A patient with severe acute respiratory illness (fever and at least one sign/symptom of respiratory disease, e.g. cough shortness of breath; AND requiring hospitalization) AND in the absence of an alternative diagnosis that fully explains the clinical presentation. (pp. 11, 12)
The clinical presentation of COVID-19 infection varies from mild to moderate to severe. The severe presentation is reportedly characterized by Acute Respiratory Distress Syndrome. In line with this, diffuse alveolar damage (DAD) is a reported postmortem pathological feature of COVID-19; DAD is the histological correlate of Acute Respiratory Distress Syndrome. In the acute stage, DAD is characterized by hyaline membrane formation in the alveoli and the organizing stage by interstitial widening due to oedema and fibroblast proliferation.7 However, there is an instance where DAD was not reported.8 Other pathological features that have been reported in the lung include: oedema, fibrinous exudates, reactive hyperplasia limited to some type II pneumocytes and patchy inflammatory changes with scattered multinucleated giant cells.7 Others report pathological similarities between these coronavirus infections: COVID-19, Severe Acute Respiratory Syndrome (SARS) and Middle Eastern respiratory syndrome.3
Though other pathological features have been reported in other organs, including the liver and heart, the changes in these organs have been less significant than those reported in the lung. The prominent role of endotheliitis in COVID-19 infection was highlighted in one such publication that reported the presence of viral inclusion in endothelial cells.9 The authors suggested that infection with SARS coronavirus 2 (SARS-CoV-2) results in endotheliitis in several organs from the involvement of the virus and as part of the host inflammatory response. The authors hypothesized that a strategy that targets endotheliitis in susceptible patients (people with diabetes, hypertension, obesity) is likely to improve survival in such patients.9
Among nucleic acid tests, the polymerase chain reaction (PCR) method is considered the 'gold standard' for the detection of COVID-19, and it is characterized by rapid detection, high sensitivity and high specificity.10 The specificity of most real-time reverse-transcription (rRT) PCR tests is estimated at 100%, because the design of the primers is specific for the genome sequence of SARS-CoV-2. However, false-negative reports may occur and have been associated with intended and non-intended activities during case detection, patient preparation, sample collection, packaging, storage, transport and reporting.11
The nasopharyngeal swabs or other upper respiratory tract specimens, including throat swabs or, more recently, saliva are the commonly used specimens for rRT-PCR diagnosis of COVID-19.11 Howbeit, the positivity rates of these samples vary; bronchoalveolar lavage has the highest positivity rate. In one study of 205 confirmed COVID-19 infections, the rRT-PCR positivity rate of bronchoalveolar lavage, sputum, nasal and oropharyngeal specimens were 93%, 72%, 63% and 32%, respectively.3
Although confirmed deaths due to COVID-19 are being recorded, autopsy findings of COVID-19 reported deaths in Africa, including Ghana, are largely unavailable. This report shares pathological observations of autopsies performed at the 37 Military Hospital's J.M. Wadhwani Department of Anatomical Pathology on three presumed COVID-19 cases. It also highlights the challenges associated with managing presumed cases.
Methods
Ethical considerations
Due to the emergency nature of the pandemic, ethical review and approval was not conducted. However, all identifiers were removed from the report and verbal consent was also sought from the relations of the deceased, where required.
Study site
The 37 Military Hospital, a 600-bed tertiary facility, is one of the largest hospitals in Ghana. Annually, the J.M. Wadhwani Department of Anatomical Pathology of the hospital conducts approximately 1500 hospital, medico-legal or coroner's autopsies in its standard morgue facility.
The notices of death were received by the Department of Anatomical Pathology for two presumed COVID-19 cases who were being managed within the 37 Military Hospital. Also received at the department was a case referred from a peripheral hospital for a medico-legal or coroner's autopsy to determine the cause of death. All cases were received between April 2020 and May 2020 and met the clinical case definition of COVID-19; antemortem SARS-CoV-2 tests of the two tested cases were negative. All cases were transported to the morgue under COVID-19 recommended protocols as published by the WHO.12
A complete autopsy was conducted on all cases with detailed gross and histopathological analysis. Examinations were performed in the department's state-of-the-art morgue following guidelines for performing autopsies on presumed COVID-19 cases. Except in the coroner's autopsy case, postmortem bronchopulmonary samples were collected, immediately placed in viral transport media and sent to the Noguchi Memorial Institute for Medical Research where rRT-PCR was performed.
Selected organs (lungs, heart, brain, kidneys, liver, spleen) were sampled and fixed in 10% buffered formalin for histopathological studies. Organ slides were made, stained with haematoxylin and eosin and examined by certified histopathologists. Tissue sections were retained in formalin and blocks appropriately stored. Findings from the autopsy were corroborated by both clinical presentations and laboratory outcomes.
Results
Case 1
The first case was a man with hypertension and diabetes who was in his late thirties. He had a non-productive cough, fever (39.5 °C) and had experienced breathlessness for six days before hospital admission. He alleged that he had no contact with a confirmed or probable COVID-19 case. A provisional diagnosis of COVID-19 was made, the patient was isolated, and a nasopharyngeal swab was taken for SARS-CoV-2 testing. The SARS-CoV-2 test result came in after his demise and was negative. Therefore, a coroner's autopsy was requested and was performed to find out the cause of death (Table 1). No postmortem bronchopulmonary specimen was taken. However, following contact tracing, it was discovered that he had prior contact with a confirmed COVID-19 patient and that one of his caregivers tested positive for SARS-CoV-2.
Microscopic sections of the lungs show autolytic changes with bacterial colonization of the bronchioles (Figure 1). The prominent pathological findings in fairly preserved areas of the lungs were severe oedema and DAD with prominent hyaline membrane formation, infiltration of the interstitium by macrophages and scattered multinucleated giant cells. Also, there was evidence of pneumonic changes in the lungs: moderate dense inflammatory cell exudate. In the final autopsy report, the cause of death was listed as bronchopneumonia most likely due to or as a consequence of COVID-19; diabetes and hypertension were contributory causes.
Case 2
The second case was a 60-year-old woman with hypertension who was morbidly obese and had in the past week been diagnosed with diabetes mellitus. She had a three-week history of worsening breathing difficulty, one day of unproductive cough and no history of asthma. She allegedly had no contact with a confirmed or probable case of COVID-19. She was being managed for bronchitis or asthma with no improvement. An initial diagnosis of pulmonary thromboembolism was made. Differential diagnoses were congestive cardiac failure due to hypertension or COVID-19 infection. She was therefore transferred from the emergency centre to the isolation unit. She was managed with intravenous fluids, anticoagulants, antibiotics, insulin and anti-hypertensive medications. A nasopharyngeal swab was taken for a COVID-19 test three days after admission.
She experienced palpitation and dyspnoea but no orthopnoea, paroxysmal nocturnal dyspnoea, pedal oedema, calf tenderness or fever. She had an oxygen saturation of 85% at room air and 95% at non-rebreather oxygen, a normal pulse and a blood pressure of less than or equal to 140/90 mmHg throughout admission.
She had a marginally increased neutrophil-white blood cell count and a high D-dimer of 1.26 ug/mL (fibrinogen equivalent unit; normal limit 0.0-0.5). Her liver function test showed deranged liver enzymes. However, renal function tests, C-reactive protein (3.6) and troponin were normal. A computerised tomogram scan was done, the pulmonary vessels were reported as normal (Figure 2).

The PCR results for COVID-19 were returned as negative three days after sample collection. She was therefore transferred from the isolation unit to a general medical ward. She later suddenly developed severe respiratory distress, started desaturating and later died. An academic autopsy was ordered by the attending clinical team who queried the PCR COVID-19 result (Table 1).
A postmortem bilateral lung parenchymal swab was taken for SARS-CoV-2 testing. Microscopic examination of the lungs showed severe congestion with foci of haemorrhage. There was a proliferation of fibroblasts and infiltration of macrophages within the interstitium and in the alveolar space; DAD with characteristic hyaline membranes in the alveoli; and interstitial fibrosis and oedema. Fibrin thrombi, mostly located in the subpleural region were noted. The liver and spleen were poorly preserved. Microthrombi were also noted in some of the glomeruli (Figure 3). In the final autopsy report, the cause of death was listed as acute pulmonary embolism due to or as a consequence of COVID-19 pneumonia; diabetes mellitus and hypertensive heart disease were contributing causes.
Case 3
The third case was a 55 year old man with hypertension and diabetes who had a seven-day history of non-productive cough and dyspnoea. He had a fever, general weakness and headache but no chest pains, sore throat, leg swelling, paroxysmal nocturnal dyspnoea or orthopnoea. He had a recent travel history that suggested a COVID-19 exposure.
The man was in respiratory distress; oxygen saturation- 56% on room air, 82% on non-rebreather oxygen and his temperature was 37.6 °C. His blood pressure was 175/94 mmHg, and his pulse rate was 112 beats per minute regular. He had no pallor of mucous membranes, not jaundiced and hydration was fair. Examinations of the chest revealed reduced air entry in lung bases with crepitations. There were bronchial breath sounds over lower zones. Heart sounds I and II were present, normal and no murmurs were heard. No bi-pedal oedema was also noticed. The abdomen was soft, non-tender and there was no organomegaly. A diagnosis of bilateral pneumonia to rule out COVID-19 in a patient with diabetes and hypertension was made. Pulmonary embolism was a differential diagnosis. He was managed on intravenous fluids, anticoagulants, antibiotics, insulin and anti-hypertensive medications. He had a low haemoglobin (11.5g/dL) and a high white blood cell count (15.58 × 1010/L) with platelets at 185 × 1010/L. Liver and renal function tests were normal.
A plain chest X-ray and a computerised tomography scan were requested (Figure 4). Later that day, his breathing became laboured and uneven. His temperature was 36.6 °C, pulse rate 100 beats per minute; respiratory rate was 29 per minute; oxygen saturation was 96% on intranasal oxygen. His blood pressure shot up to 220/140 mmHg but was controlled by intravenous labetalol.
A nasopharyngeal swab for SARS-CoV-2 testing was to be collected the following day but the patient passed before the sample could be taken. An academic autopsy was therefore ordered by the attending clinical team (Table 1).
Postmortem bilateral lung parenchymal swabs were positive for SARS-CoV-2. Microscopic examination of the lungs showed severe congestion with haemorrhages. There were severe pulmonary oedema and moderately dense macrophage exudate. Diffuse alveolar damage with hyaline membrane formation was striking, and large pneumocytes showing enlarged nuclei and granular amphophilic cytoplasm were present. Microthrombi were also noted in some smaller pulmonary capillaries (Figure 5). In the final autopsy report, the cause of death was listed as COVID-19 pneumonia with diabetes mellitus and hypertension as contributory.
Discussion
Though thousands of COVID-19 cases have been reported in Ghana with more than 30 deaths, no autopsies performed on such cases have been published in the medical literature. Postmortem samples were taken for COVID-19 testing in two of the cases that were autopsied. Both lung parenchymal samples were positive for SARS-CoV-2. In two cases, an earlier test using a nasopharyngeal swab sample was negative. This suggests that there is the possibility of false-negative results and that there is a proportion of COVID-19 patients who, because of their false-negative test results, will be managed in health facilities without protective protocols. Similarly, for those that die without being tested or have false-negative test results, their remains will be handled without the necessary safety precautions. To ensure the safety of workers and prevent unconscious exposure, health facilities and funeral homes should ensure that adequate safety measures are put in place during this pandemic.
In one case, the antemortem nasopharyngeal sample was negative for SARS-CoV-2, whereas the postmortem bronchopulmonary sample was positive for SARS-CoV-2. Such false-negative errors for COVID-19 may be the result of pre-analytical activities, such as a poorly collected sample, wrong sample labelling, mislabeling, interference from medications and improper storage or transport.11,13 It is therefore essential that great emphasis is made in ensuring adherence to proper sample collection and processing protocols across the entire cascade of activities in the diagnosis and reporting of COVID-19.
Considering the inevitable occurrence of deaths within the global COVID-19 pandemic, it is crucial for anatomical pathologists, while following due safety protocols, to look out for evidence of COVID-19 in all autopsy cases. The most significant pathological findings in our patients were in the lungs. This finding is similar to previous findings in other COVID-19 autopsies. In our patients, significant pathological findings that were present in all three patients included severe oedema, congestion, haemorrhages, the proliferation of pneumocytes, scattered multinucleated giant cells and DAD with hyaline membrane formation.3,8,14 Other pathological features including the proliferation of fibroblasts with interstitial fibrosis and microthrombi in the kidneys were seen in one patient.
Again, in a previous report, one patient had patchy inflammatory infiltrates that suggested a pneumonic process.4 Though all our patients had diabetes, we did not find the reported endotheliitis that has been reported to be present in some diabetic individuals.
Although molecular testing for Case 1 was not done, DAD was observed. This combined with the anecdotal evidence - contact with a COVID-19 patient and a later positive COVID-19 test of his caretaker - is suggestive of COVID-19. The death was thus ascribed to COVID-19 infection, in line with WHO6 Situation Report 94 for certifying deaths due to COVID-19 which states that:
[W]here a definite diagnosis of COVID-19 cannot be made but it is suspected or likely (e.g. the circumstances are compelling within a reasonable degree of certainty), it is acceptable to report COVID-19 on a death certificate as 'probable' or 'presumed'. (p. 12)
The pathological presentation observed in the lungs were consistent with similar cases reported in Beijing and Oklahoma by Barton et al.,7 and Xu et al.14
Limitations
Bronchopulmonary sampling was not done for SARS-CoV-2 testing for Case 1 as a result of the psychological unpreparedness of the autopsy team for COVID-19 autopsies. Additionally, no immunohistochemical staining was done for histopathological samples collected to show the presence and distribution of immune cells in the lungs. Also, the quality of photomicrographs could have been better if the bodies were better preserved after death.
Conclusion
Findings from this study indicate that autopsies are capable of reporting evidence of COVID-19 and provides insights for proper sample management for purposes of diagnosis. More so, the diagnosis of COVID-19 at autopsy is relevant in situations where molecular testing such as rRT-PCR is not available to inform relevant public health action. Bronchopulmonary samples for SARS-CoV-2 testing during postmortem should be taken for presumed COVID-19 cases. More autopsies are required to fully understand the pathogenesis of this disease in Ghanaians.
Acknowledgements
Competing interests
The authors have declared that no competing interest exist.
Authors' contributions
S.A.A. conceived the idea and performed autopsies; K.A. and R.D.F. developed the initial manuscript; F.H., L.E. and K.A.-B. reviewed slides; K.A.-B. assisted in autopsies; C.T.L. managed clinical cases; M.K.A. reported X-Rays and computerised tomography scans; A.M. and G.N. processed tissues and prepared slides. E.O.N., R.H.A., E.A. and M.M. did the literature review and discussed the findings of the study. All authors reviewed the manuscript and provided feedback.
Sources of support
This research received no specific grant from any funding agency in the public, commercial or not-for-profit sectors.
Data availability statement
Data sharing is not applicable to this article as no new data were created or analysed in this study.
Disclaimer
The views and opinions expressed in this article are those of the authors and do not necessarily reflect the official policy or position of any affiliated agency of the authors.
References
1.WHO. WHO Covid-19 dashboard WHO Covid-19 dashboard [homepage on the Internet]. WHO; 2020 [updated 27 May 2020; cited 2020 May 27]. Available from: https://covid19.who.int/?gclid=Cj0KCQjwn7j2BRDrARIsAHJkxmyChap3BruKNNXLtl7keokLhmv1V91uTTjfrBy-HrUu5_zpj4FOPcUaAidAEALw_wcB [ Links ]
2.GHS. Ghana Covid-19 updates [homepage on the Internet]. Ghana Health Service (GHS); 2020 [updated 26 May 2020; cited 2020 May 27]. Available from: https://www.ghanahealthservice.org/covid19/latest.php [ Links ]
3.Huang C, Wang Y, Li XL, Ren L, Zhao J, Hu Y. Clinical features of patients infected with 2019 coronavirus in Wuhan, China. Lancet. 2020;395(10223):497-506. https://doi.org/10.1016/S0140-6736(20)30183-5 [ Links ]
4.Singhal T. A review of coronavirus disease-2019 (COVID-19). Indian J Pediatr. 2020;87(4):286. https://doi.org/10.1007/s12098-020-03263-6 [ Links ]
5.Samsami M, Bagherpour Z, Nematihonar B, Tahmasbi H. COVID-19 pneumonia in asymptomatic trauma patients; report of 8 cases. Arch Acad Emerg Med. 2020;8(1):e46. [ Links ]
6.WHO Coronavirus disease. (COVID-19) Situation Report - 94. Data as received by WHO from national authorities by 10:00 CEST. 23 April 2020 [document on the internet]. 2019. [cited 2020 Sept 27] Available from: https://reliefweb.int/sites/reliefweb.int/files/resources/20200423-sitrep-94-covid-19. [ Links ]
7.Barton LM, Duval EJ, Stroberg E, Ghosh S, Mukhopadhyay S. COVID-19 autopsies, Oklahoma, USA. Am J Clin Pathol. 2020;153(6):725-733. https://doi.org/10.1093/ajcp/aqaa062 [ Links ]
8.Ng W-F, To K-F, Lam WWL, Ng T-K, Lee KC. The comparative pathology of severe acute respiratory syndrome and avian influenza A subtype H5N1 - A review. Hum Pathol. 2006;37(4):390. https://doi.org/10.1016/j.humpath.2006.01.015 [ Links ]
9.Varga Z, Flammer A, Steiger P, Haberecker M, Andermatt R, Zinkernagel AS. Endothelial cell infection and endotheliitis in COVID-19. Lancet; 2020;395(10234):1417-1418. https://doi.org/10.1016/S0140-6736(20)30937-5 [ Links ]
10.Tahamtan A, Ardebili A. Real-time RT-PCR in COVID-19 detection: Issues affecting the results. Expert Rev Mol Diagn. 2020;20(5):453-454. https://doi.org/10.1080/14737159.2020.1757437 [ Links ]
11.Sethuraman N, Jeremiah SS, Ryo A. Interpreting diagnostic tests for SARS-CoV-2. JAMA. 2020;323(22):2049-2051. https://doi.org/10.1001/jama.2020.8259 [ Links ]
12.WHO. Infection prevention and control for the safe management of a dead body in the context of COVID-19: Interim guidance. WHO; March 24, 2020 p. 6. https://www.who.int/publications/i/item/infection-prevention-and-control-for-the-safe-management-of-a-dead-body-in-the-context-of-covid-19-interim-guidance [ Links ]
13.Lippi G, Simundic AM, Plebani M. Potential preanalytical and analytical vulnerabilities in the laboratory diagnosis of coronavirus disease 2019 (COVID-19). Clin Chem Lab Med. 2020;58(7):1070-1076. https://doi.org/10.1515/cclm-2020-0285 [ Links ]
14.Xu Z, Shi L, Wang Y, et al. Pathological findings of COVID-19 associated with acute respiratory distress syndrome. Lancet Respir Med. 2020;8(4):422. https://doi.org/10.1016/S2213-2600(20)30076-X [ Links ]
Correspondence:
Seth Attoh
sethattoh@yahoo.com
Received: 03 June 2020
Accepted: 21 Aug. 2020
Published: 03 Nov. 2020
ORIGINAL RESEARCH
Adult and paediatric haematology and clinical chemistry laboratory reference limits for Liberia
Mark W. KiehI; Sarah M. BrowneI; Greg A. GranditsII; Julie BlieI; Jestina W. Doe-AndersonIII; Marie L. HooverIV; Bionca DavisII; Cavan S. ReillyII; James D. NeatonII; H. Clifford LaneV; Stephen B. KennedyI, VI
IPartnership for Research on Ebola Virus in Liberia (PREVAIL), New Kru Town, Monrovia, Liberia
IIDivision of Biostatistics, University of Minnesota, Minneapolis, Minnesota, United States
IIILeidos Biochemical Research, Fredrick, Maryland, United States
IVAdvanced BioMedical Laboratories, Cinnaminson, New Jersey, United States
VDivision of Clinical Research, National Institute of Allergy and Infectious Diseases, National Institute of Health, Bethesda, Maryland, United States
VILiberian College of Physicians and Surgeons, Monrovia, Liberia
ABSTRACT
BACKGROUND: As more research is conducted in Liberia, there is a need for laboratory reference limits for common chemistry and haematology values based on a healthy population. Reference limits from the United States may not be applicable.
OBJECTIVE: The aim of this study was to present laboratory reference ranges from a Liberian population and compare them to United States ranges.
METHODS: Serum chemistry and haematology values from 2529 adults and 694 children and adolescents obtained from two studies conducted in Liberia between 2015 to 2017 were used to determine reference limits. After removing outliers, the reference limits defined by the 2.5th and 97.5th percentiles were determined by sex in three age groups (6-11, 12-17, and 18+ years.
RESULTS: The median (interquartile range) of adults was 29 (23, 37) years; 44% were female. The median (interquartile range) for children and adolescents was 12 (9, 15) years; 53% were female. Several reference ranges determined using Liberian participants differed from those in the US. For chemistries, a high percentage of both adults and children/adolescents had high serum chloride levels based on United States ranges. For haematology, a high percentage of Liberian participants had haemoglobin and related assays below the lower limit of United States ranges.
CONCLUSION: Chemistry and haematology reference intervals determined for a Liberian population of healthy individuals should be considered for establishing eligibility criteria and monitoring of laboratory adverse events for clinical trials as well as for use in clinical settings in Liberia and perhaps for other countries in Western Africa.
Keywords: reference ranges; Liberia; chemistries; haematology; paediatric.
Introduction
Reference limits for clinical laboratory tests for healthy adults and children in Liberia are not available based on a Liberian population. In a clinical setting, reference limits determined from a healthy population can provide useful information for making decisions based on laboratory reports. In addition, in a research setting, reference limits are often used for inclusion and exclusion criteria, for assessing possible adverse effects of treatment, and for the diagnosis of outcomes. Differences in reference limits for haematology and chemistry measurements have been reported between United States (US) reference intervals and reference intervals determined for healthy individuals in other African countries.1,2,3,4,5,6,7,8,9,10,11,12,13,14 These differences have been attributed to differences in socioeconomic status, diet, physical exercise, environmental pathogens and altitude.
The Partnership for Research on Ebola Virus in Liberia (PREVAIL) initiated several studies beginning in 2015. Our experience carrying out this research motivated the determination of reference limits based on healthy people living in Liberia who enrolled in two of the studies. For example, in one of these studies, a vaccine trial for the prevention of Ebola virus disease (EVD), a large percentage of apparently healthy participants had initial laboratory test result values outside the limits considered 'normal'.
The purpose of this paper is three-fold: (1) to describe chemistry and haematology test results for a large number of apparently healthy adults and children in Liberia; (2) to use that data to define reference limits for use in future research projects in Liberia; and (3) to compare the reference limits determined based on Liberian participants with those based on US participants.
Methods
Ethical considerations
We used data from two studies. PREVAIL I and PREVAIL III, to determine the reference limits. All participants aged 18 years and older provided written informed consent. A parent or guardian signed a written informed consent for all participants under age 18 years, and children aged 9 years and older also signed a written assent. Both study protocols were approved by the National Research Ethics Board of Liberia and the Institutional Review Board of the United States National Institutes of Health; Protocol identification number 15-I-N071 (PREVAIL I) and 15-I-0122 (PREVAIL III).
Study design and sample selection
The PREVAIL I study was a Phase 2 placebo-controlled randomised trial that evaluated the efficacy and safety of two vaccines to prevent EVD. The PREVAIL III study was a cohort study of EVD survivors and their close contacts. Close contacts were identified by survivors and either lived with the survivor at the time of diagnosis or after discharge from the Ebola treatment unit, or were sexual partners after discharge. The study design, methods and results of PREVAIL I and PREVAIL III have been described elsewhere.15,16,17
Study participants used to determine reference limits
In PREVAIL I, volunteers aged 18 years or older were enrolled over a three-month period beginning in February 2015 at Redemption Hospital in Monrovia, Liberia. The trial excluded participants with a history of EVD, those with a temperature of more than 38 ºC, and women who were pregnant or breast-feeding. The following additional exclusions were made for these analyses: (1) participants with a history of high blood pressure, diabetes or cancer; (2) participants with HIV or syphilis infection based on blood testing; and (3) participants with antibody levels against the Ebola virus surface glycoprotein greater than or equal to 548 enzyme-linked immunosorbent assay units (EU)/mL which was considered indicative of past Ebola infection. These additional exclusions were made to remove potentially unhealthy participants that could have abnormal laboratory values as a result of medical conditions.
In PREVAIL III, close contacts of EVD survivors of any age, identified by EVD survivors, were enrolled between 2015 and 2017. Close contacts were enrolled at three sites: John F. Kennedy (JFK) Medical Centre and Duport Road Clinic (both in Monrovia), and C.H. Rennie Hospital (a more rural site about 70 km north of Monrovia).
For participants in PREVAIL III, the following additional exclusions were made for these analyses: (1) participants with a history of high blood pressure, diabetes, cancer, stroke or ischemic heart disease; (2) participants with HIV or syphilis based on blood testing; and (3) participants with antibody levels against the Ebola virus surface glycoprotein greater than or equal to 548 EU/mL.
A map showing the locations of the sites where participants were enrolled in PREVAIL I and III is provided in Figure 1. Monrovia is a coastal city located on the Atlantic Coast, with elevation just above sea level.
Laboratory measurements
Laboratories were established at Redemption Hospital, JFK Medical Centre, and C.H. Rennie Hospital. For participants enrolled in PREVAIL I, all laboratory testing was done at Redemption Hospital. For participants enrolled in PREVAIL III, the testing was done at JFK Hospital (JFK participants) or C.H. Rennie Hospital (C.H. Rennie and Duport Road participants), with occasional backup testing at Redemption Hospital. The same laboratory equipment and methods for blood drawing, specimen labelling and testing were used by all three laboratories, with written documentation of all procedures provided in Standard Operating Procedures. All samples were typically analysed within 4 h. Calibrators and controls (vender and third-party) were run daily at each site to maintain quality assurance. The vendors provided precision data for each analyte. Calibrators and control samples were run before the study samples, and results needed to be within the accepted range in order for the study samples to be analysed.
In both studies, the participants were seen in the morning for their baseline clinic visits, during which non-fasting venous blood specimens were obtained. Blood was collected in serum separator tubes for chemistry analyses and Ethylenediaminetetraacetic acid tubes for haematology. Specimens were then transferred to the respective laboratory. All samples were accessioned, centrifuged (if required) and then analysed on benchtop instrumentation: haematology using Cell Dyn Ruby (Abbott Diagnostics, Abbott Park, Illinois, United States), and chemistries using Trademark name for Alfa Wassermann's first chemistry analyzer (ACE) Alera or ACE Axcel (Alfa Wassermann, West Caldwell, New Jersey, United States), with Alera or Axcel used interchangeably. In addition to assessing HIV and syphilis serostatus, a complete blood count was obtained with differential and platelet count, aspirate aminotransferase, alanine aminotransferase, creatinine, potassium, chloride and sodium. Alcohol intake was not ascertained in either study.
Each day reports were generated giving chemistry and haematology results for each participant and indicating values that were outside 'normal' limits based on US values.
Data analysis
Laboratory data for PREVAIL I and III were combined for these analyses. As a first step, outliers for each test were removed after Box-Cox transformation (restricting transformation to the identity, square root or log) using a method proposed by Tukey:18 values 1.5 × interquartile range above the 75th percentile or 1.5 × interquartile range below the 25th percentile were removed. This was done because the information collected to exclude participants with chronic conditions was minimal and the goal was to identify a 'healthy' population. Following this step, for each laboratory test, the reference limits defined by the 2.5th and 97.5th percentiles were determined based on a commonly used non-parametric approach.19,20 Percentile values were back-transformed to the original scale. Because it is important that reference ranges consider age and sex, this process was performed separately for each sex and age group (6-11, 12-17, and 18 years and over). The median and reference ranges are cited for male and female individuals in each of the three age groups. The percentage of participants both below and above published US reference ranges21 are cited for each laboratory value. The results found in this study and for other countries in West Africa are given for reader reference. No formal statistical tests were made for these comparisons. Non-parametric tests were conducted for differences in medians between male and female participants and among the three age groups by sex. All analyses were performed using SAS version 9.4 (SAS Institute, Cary, North Carolina, United States). P-values < 0.001 were regarded as statistically significant.
Results
Of the 3986 participants enrolled in PREVAIL I and III, 3223 met the eligibility criteria for these analyses (Figure 2). The adults enrolled in PREVAIL I that are included in these analyses had a median age of 29 years, 33% were female, and the median body mass index was 21.6 kg/m2 (Table 1). The adults in PREVAIL III that are included in these analyses had similar age distributions as those of the PREVAIL I adults, but included a higher percentage of women and had a slightly higher median body mass index. The median age for the children/adolescents was 12 years, 53% were female, and the median body mass index was 17.4 kg/m2.

Laboratory median levels and reference limits by age and gender
Many laboratory median levels and corresponding reference ranges differed significantly by sex and age (Table 2). For example, the median and reference ranges for white blood cell (WBC) count in male participants aged 6-11 years was 7.18 (4.61-11.92) x 103/μL compared to 5.77 (3.63-9.72) x 103/μL in adult female participants.
For chemistry, adult men had higher liver enzymes, creatinine, and potassium levels, with lower serum chloride and sodium levels than adult women (p < 0.001). In general, the differences between sexes were less pronounced in children/adolescents. For example, the median serum creatinine levels were nearly identical for male and female individuals aged 6-11 years and only slightly higher for male than female individuals aged 12-17 years. For haematology values, adult men had lower WBC counts but higher red blood cell counts and haemoglobin levels than adult women (p < 0.001). Platelet counts were higher in adult women than men. The differences in haematology values between sexes were much smaller in the youngest age group (ages 6-11 years) and were not statistically significant.
For serum chemistry, the median aminotransferase was inversely related to age for both male and female participants, whereas serum creatinine was strongly positively related to age for both sexes (p < 0.001). The median serum sodium increased with age for both sexes. For haematology, the WBC counts were highest for ages 6-11 years for both sexes and the red blood cell counts increased with age for male but not female participants. The median haemoglobin levels increased with age in both sexes but the relationship was stronger in male participants. Platelets decreased with age for both male and female participants.
Comparison with United States reference ranges
For chemistries, a high percentage of both adults and children/adolescents would be classified as having high serum chloride levels based on the US reference standard (Table 3). Similarly, several haematology factors would be classified as out of range for both adults and children/adolescents using the US standard. A high percentage of both children/adolescent and adult participants had haemoglobin, mean corpuscular volume, mean corpuscular haemoglobin, mean corpuscular haemoglobin concentration, and haematocrit levels below the lower limit. In addition, 20% - 25% of Liberian adults had WBC counts and neutrophils below the US reference standard.
Reference ranges for other West African countries
Medians and reference limits for our Liberian study showed some differences compared to reference limits reported for Ghana, Mali, and Gambia (Table 4);4,10,13,14 chemistry values were only available from Ghana. Liver enzymes were lower in Liberia than in Ghana. Potassium, sodium, and chloride levels were also lower in the Liberian population than in the Ghanaian population. The median and reference limits for WBC counts were similar for men in Liberia and Mali. The median WBC counts for women in Liberia were higher than in the other West African countries. The red blood cell counts for men in Liberia were similar to both Ghana and Mali, while the red blood cell counts for women in Liberia were higher than those in Ghana. The haemoglobin levels were similar in the Liberian population as compared to the other West African countries. Platelet counts differed among countries but were always higher in women than men in each country. Comparison of medians among countries were not always consistent with the reference ranges, suggesting differences in variability between populations.
Discussion
To determine reference limits for common clinical laboratory test results for people in Liberia by age and sex, we used baseline data collected at the time of enrolment in two research studies conducted during the West African Ebola epidemic. One study enrolled healthy adults in a vaccine trial16 and the other enrolled adults and children who were close contacts of individuals who survived Ebola.17 'Unhealthy' participants were excluded based on medical history and for positive HIV or syphilis tests. Our goal was to select individuals for determining reference intervals and to use recommended statistical methods for determining these intervals as outlined by the Clinical and Laboratory Standards Institute22 that could be used to interpret an individual's laboratory test results and could be used in the design of future clinical research studies. We found that for several laboratory tests, the reference limits based on the data from this Liberian population differed greatly from the US-based reference limits. For example, the haemoglobin reference ranges were much lower in this study than the US-based reference values. Based on the US reference limits, one could imply that a high proportion of Liberians have 'abnormal' low haemoglobin levels. Other reference limits that differed considerably were chloride, for which the Liberian population had higher reference limits, and mean corpuscular volume, mean corpuscular haemoglobin, haematocrit and mean platelet volume, for which the Liberian population had lower reference limits. Differences between values found in this study compared to US levels could be due to several reasons, including genetics, environmental factors, subclinical disease, and laboratory equipment and/or methods. The observed differences are unlikely to be because of laboratory differences, as the laboratories set up in Liberia used standard equipment that is also used in the US for chemistries and haematology.
The reference limits from our study also confirm that separate values for many laboratory parameters should be considered for men and women and for adults and children/adolescents. The adult women in our study had significantly higher WBC counts than men. The children/adolescents also had higher WBC counts, lower creatinine levels, and lower haemoglobin levels than adults.
Many clinical trials use reference limits and tables for grading laboratory toxicities, such as the Division of AIDS Table for Grading the Severity of Adult and Paediatric Adverse Events,23 to define eligibility criteria and to grade adverse events during follow-up. The difference in reference limits between those estimated for Liberia and US limits could impact the number of participants found to be eligible for a trial, as well as the percentage developing adverse events based on laboratory test results. For trials conducted in other parts of Africa this has been the case. Eller et al.9 studied the impact of using US reference limits in Uganda to screen participants for an HIV vaccine trial. They found that US reference limits led to more exclusions during screening for a Phase 1 vaccine trial than the use of their reference limits derived from people living in Uganda. They also noted that the Division of AIDS toxicity table did not reflect locally established reference limits, and the lower limit for neutrophils they had estimated would qualify as a grade 2 adverse event. Segolodi et al.7 reported that many healthy volunteers for an HIV pre-exposure prophylaxis trial conducted in Botswana had abnormal amylase results according to US-derived reference values. Zeh et al.24 reported that over 58% of participants would have been excluded from a trial in Kenya using US reference limits as compared to reference limits determined for the local population. In addition, 40% of otherwise healthy study participants would have been considered to have a grade 1-4 laboratory-based adverse event based on the Division of AIDS toxicity table.
There may be pros and cons to using Liberian versus US reference limits for reporting adverse events. The burden associated with reporting lower-severity grade events,25 particularly those based solely on laboratory results and not associated with symptoms, would suggest using reference limits from local populations. On the other hand, in early phase research of novel treatments such as the Ebola studies on which this research is based, it may be more prudent to use more conservative limits such as the US reference limits until safety is established.
A strength of this study is the large number of participants (> 2500 adults and nearly 700 children/adolescents) studied with common laboratory methods in two research studies, allowing for more precise estimates of laboratory percentiles on which the reference limits are based. To our knowledge, this is the first report of laboratory reference limits from a Liberian population. We recommend that additional laboratory-based studies be conducted to establish suitable laboratory reference limits for Liberia.
Limitations
A limitation to this study is that we based our definition of 'healthy' participants largely on a self-reported medical history. While we used statistical methods that attempted to remove outliers to establish a 'healthy' population, and that typically removed about 1% - 3% of participants from the group where normal ranges were calculated using 2.5% and 97.5% percentiles, our cohort is likely to include some participants with undiagnosed illnesses.
Conclusion
In conclusion, we present the chemistry and haematology reference intervals from a Liberian population of healthy individuals for men and women and for children/adolescents and adults. These levels should be considered for screening and monitoring participants in clinical trials in Liberia and perhaps other countries in West Africa.
Acknowledgements
The authors would like to thank the many participants in the PREVAIL I and PREVAIL III studies whose data were used for this manuscript.
Competing interests
The authors have declared that no competing interests exist.
Authors' contributions
H.C.L. and S.B.K. conceived and designed the studies; M.W.K., J.D.N. and G.A.G. wrote the article; G.A.G. and C.S.R. analysed the data; M.L.H. set up and conducted the laboratory testing in Liberia. Clinical support and data collection were provided by M.W.K., S.M.B. and J.B; J.W.D.-A. and B.D. contributed to the editing of the manuscript. J.W.D.-A. and B.D. were also involved in the collection of data and monitoring of the study.
Source of support
United States National Institute of Allergy and Infectious Diseases. P1 Principal Investigators: Stephen Kennedy, Fotorma Bolay, and H. Clifford Lane, P3 Principal Investigators: Mosoka Fallah and Michael Sneller.
Data availability statement
The data used for this manuscript is available upon request.
Disclaimer
The views and opinions expressed in this article are those of the authors and do not necessarily reflect the official policy or position of any affiliated agency of the authors.
References
1.Mekonnen Z, Amuamuta A, Mulu W, et al. Clinical chemistry reference intervals of healthy adult populations in Gojjam Zones of Amhara National Regional State, Northwest Ethiopia. PLoS One. 2017;12(9):e0184665. https://doi.org/10.1371/journal.pone.0184665 [ Links ]
2.Karita E, Ketter N, Price MA, et al. CLSI-derived hematology and biochemistry reference intervals for healthy adults in eastern and southern Africa. PLoS One. 2009;4(2):e4401. https://doi.org/10.1371/journal.pone.0004401 [ Links ]
3.Odhiambo C, Oyaro B, Odipo R, et al. Evaluation of locally established reference intervals for hematology and biochemistry parameters in Western Kenya. PLoS One. 2015;10(4):e0123140. https://doi.org/10.1371/journal.pone.0123140 [ Links ]
4.Kone B, Maiga M, Baya B, et al. Establishing reference ranges of hematological parameters from Malian healthy adults. J Blood Lymph. 2017;7(1):pii 154. [ Links ]
5.Samaneka WP, Mandozana G, Tinago W, et al. Adult hematology and clinical chemistry laboratory reference ranges in a Zimbabwean population. PLoS One. 2016;11(11):e0165821. https://doi.org/10.1371/journal.pone.0165821 [ Links ]
6.Tembe N, Joaquim O, Alfai E, et al. Reference values for clinical laboratory parameters in young adults in Maputo, Mozambique. PLoS One. 2014;9(5):e97391. https://doi.org/10.1371/journal.pone.0097391 [ Links ]
7.Segolodi TM, Henderson FL, Rose CE, et al. Normal laboratory reference intervals among healthy adults screened for a HIV pre-exposure prophylaxis clinical trial in Botswana. PLoS One. 2014;9(4):e93034. https://doi.org/10.1371/journal.pone.0093034 [ Links ]
8.Miri-Dashe T, Osawe S, Tokdung M, et al. Comprehensive reference ranges for hematology and clinical chemistry laboratory parameters derived from normal Nigerian adults. PLoS One. 2014;9(5):e93919. https://doi.org/10.1371/journal.pone.0093919 [ Links ]
9.Eller LA, Eller MA, Ouma B, et al. Reference intervals in healthy adult Ugandan blood donors and their impact on conducting international vaccine trials. PLoS One. 2008;3(12):e3919. https://doi.org/10.1371/journal.pone.0003919 [ Links ]
10.Adetifa IMO, Hill PC, Jeffries DJ, Jackson DJ, Ibanga HB, Bah G, et al. Haematological values from a Gambian cohort - Possible reference range for a West African population. Int J Lab Hematol. 2009;31(6):615-622. https://doi.org/10.1111/j.1751-553X.2008.01087.x [ Links ]
11.Mine M, Moyo S, Stevens P, et al. Immunohaetological reference values for HIV-negative healthy adults in Botswana. Afr J Lab Med. 2011;1(1): Art. #5, 7 pages. https://doi.org/10.4102/ajlm.v1i1.5 [ Links ]
12.Saathof E, Schneider P, Kleinfeldt V, et al. Laboratory reference values for healthy adults from southern Tanzania. Trop Med Int Health. 2008;13(5):612-625. https://doi.org/10.1111/j.1365-3156.2008.02047.x [ Links ]
13.Dosoo DK, Kayan K, Adu-Gyasi D, et al. Haematologial and biochemical reference values for healthy adults in the middle belt of Ghana. PLoS One. 2012;7(4):e36308. https://doi.org/10.1371/journal.pone.0036308 [ Links ]
14.Addai-Mensah O, Gyamfi D, Duneeh RV, et al. Determination of haematological reference ranges in heathy adults in three regions in Ghana. BioMed Res Int. 2019; Feb 5 2019:ID7467512. https://doi.org/10.1155/2019/7467512 [ Links ]
15.Kennedy SB, Neaton JD, Lane HC, et al. Implementation of an Ebola virus disease vaccine clinical trial during the Ebola epidemic in Liberia: Design, procedures and challenges. Clin Trials. 2016;13(1):49-56. https://doi.org/10.1177/1740774515621037 [ Links ]
16.Kennedy SB, Bolay F, Kieh M, et al. Phase 2 placebo-controlled trial of two vaccines to prevent Ebola in Liberia. N Engl J Med. 2017;377(15):1438-1447. https://doi.org/10.1056/NEJMoa1614067 [ Links ]
17.The PREVAIL III Study Group. A longitudinal study of Ebola sequelae in Liberia. N Engl J Med. 2019;380(10):924-934. https://doi.org/10.1056/NEJMoa1805435 [ Links ]
18.Tukey JW. Exploratory data analysis. Reading, MA: Addison-Wesley; 1977. [ Links ]
19.National Committee on Clinical Laboratory Standards (NCCLS). How to define and determine reference intervals in the clinical laboratory; approved guideline. Vol. 20(13). 2nd ed. Wayne, PA: NCCLS C28-A2; 2000. [ Links ]
20.Reed AH, Henry RJ, Mason WB. Influence of statistical method on the resulting estimate of normal range. Clin Chem. 1971;17:275-284. https://doi.org/10.1093/clinchem/17.4.275 [ Links ]
21.Kratz A, Ferraro M, Sluss PM, Lewandrowski KB. Laboratory reference values. N Engl J Med. 2004;351;1548-1563. https://doi.org/10.1056/NEJMcpc049016 [ Links ]
22.Clinical and Laboratory Institute (CLSI). Defining, establishing, and verifying reference intervals in the clinical laboratory; Approved guideline - Third edition. CLSI document EP28-A3C (ISBN 1-56238-683-4). Wayne, PA: Clinical and Laboratory Standards Institute; 2008. [ Links ]
23.U.S. Department of Health and Human Services, National Institutes of Health, National Institute of Allergy and Infectious Diseases, Division of AIDS (DAIDS). Table for grading the severity of adult and pediatric adverse events, version 2.0 [homepage on the Internet]. c2014 [cited 2019 Aug 15]. Available from: https://rsc.niaid.nih.gov/sites/default/files/daids-aegrading-table-V2-nov2014.pdf [ Links ]
24.Zeh CE, Odhiambo CO, Mills LA. Laboratory reference intervals in Africa. London, UK: Intech Open; 2012. https://doi.org/10.5772/48250 [ Links ]
25.Chou VB, Omer SB, Hussian H, et al. The costs associated with adverse event procedures for an international HIV clinical trial determined by activity-based costing. J Acquir Immune Defic Syndr. 2007;46(4):426-432. https://doi.org/10.1097/QAI.0b013e318156ee37 [ Links ]
Correspondence:
Mark Kieh
mark.kieh@prevailcr.org
Received: 20 Aug. 2019
Accepted: 12 Aug. 2020
Published: 25 Nov. 2020
ORIGINAL RESEARCH
Infant HIV diagnosis and turn-around time for testing in Malawi, 2015
Hammad AliI; Peter MinchellaI; Geoffrey ChipunguII; Evelyn KimII; James KanduluIII; Dalitso MidianiIII; Andrea KimI; Mahesh SwaminathanI; Steve GutreuterI; John NkengasongI; Daniel SingerII
IDivision of Global HIV and Tuberculosis, Centers for Disease Control and Prevention, Atlanta, Georgia, United States
IIDivision of Global HIV and Tuberculosis, Centers for Disease Control and Prevention, Lilongwe, Malawi
IIIMinistry of Health, Lilongwe, Malawi
ABSTRACT
BACKGROUND: For HIV-exposed infants in Malawi, there are missed opportunities at each step of the testing and treatment cascade.
OBJECTIVE: This study assessed factors associated with HIV positivity among infants in Malawi and turn-around times for infant HIV testing.
METHODS: HIV testing data for infants aged 0-18 months from 2012 to 2015 were extracted from the Malawi HIV laboratory information management system and analysed using logistic regression. Turn-around time was defined as time between collection of samples to results dispatch from the laboratory.
RESULTS: A total of 106 997 tests were included in the analyses. A subset of 76 006 observations with complete dates were included in the turn-around time analysis. Overall positivity was 4.2%. Factors associated with positivity were increasing age (infants aged 3-6 months: adjusted odds ratio [aOR] = 2.24; infants aged 6-9 months: aOR = 3.42; infants aged > 9 months: aOR = 4.24), female sex (aOR = 1.08) and whether the mother was alive and not on antiretroviral therapy at time of the infant's test (aOR = 1.57). Provision of HIV prophylaxis to the infant after birth (aOR = 0.38) was found to be protective against HIV positivity. The median turn-around time was 24 days (increased from 19 to 34 days between 2012 and 2015.
CONCLUSION: Infant HIV positivity has decreased in Malawi, whereas turn-around time has increased. Factors associated with positivity include increasing age, female sex, and whether the mother was alive and not on antiretroviral therapy at the time of the infant's test.
Keywords: HIV; Malawi; infant HIV testing; turn-around time.
Introduction
Malawi has a high prevalence of HIV; in 2016, 9.2% of persons aged 15-49 years, 920 000 people (550 000 women, 60%) aged 15 years and older, and 110 000 children (0-14 years of age) were living with HIV.1 Among all people living with HIV, 680 000 were on antiretroviral therapy (ART) as of 2016.1 Currently, there are 717 sites that offer ART to HIV-positive patients in Malawi and there are nine laboratories nationwide that provide infant HIV virologic testing.2 Like many countries in sub-Saharan Africa, Malawi is striving towards achieving the Joint United Nations Programme on HIV/AIDS 90-90-90 targets. These targets include 90% of people living with HIV diagnosed, 90% of the people living with HIV with known status accessing treatment, and 90% of those who are on treatment virally suppressed.3 In Malawi, an estimated (antiretroviral adjusted) 76.8% of 15-64-year-old people living with HIV know their HIV status, 91.4% who know their status self-report current use of ART and 91.3% of those who self-report ART use were virally suppressed.4 The second 90 requires 'Test and Start', which is defined as provision of ART for all people living with HIV irrespective of their cluster of differentiation 4 counts.5
National guidelines recommend that HIV DNA should be detected using polymerase chain reaction (PCR) in infants who are exposed to HIV. When resources and facilities are available, this should happen at the first opportunity after the infant is older than 6 weeks.6 Blood is collected by facility nurses and dried blood spot specimens are created and sent to one of the nine laboratories nationwide that provide infant HIV virologic testing. If the PCR test is negative, a rapid antibody test is done from age 12 months onwards. If the rapid antibody test done at age 12 months returns negative, another rapid antibody test is done at age 24 months, if breastfeeding stopped at least 6 weeks before. If still breastfeeding, then the test is done six weeks after stopping breastfeeding.
In spite of these clear guidelines, HIV diagnosis in HIV-exposed infants has remained a challenge in the country. The Malawi Population-Based HIV Impact Assessment 2015-2016 showed that around half (49.4%) of infants born to HIV-positive women received a virologic HIV test within 2 months of birth, and 29.3% received a test between 2 and 12 months.4 These Malawi Population-Based HIV Impact Assessment estimates are based on a self-report of the mother and are higher than the estimates from a 2014 cohort study, which showed that only 39% - 41% of HIV-exposed infants older than age 24 months had documented evidence of an HIV test result, with 3% of those tested being positive.2 About 82% - 89% of those who had a positive result or who were diagnosed with severe HIV disease were initiated on ART.2 These data highlight the potential opportunities missed at each step of the testing and treatment cascade for HIV-exposed infants, that is, more infants need to be tested and 10% - 20% of those tested positive were not started on ART.
Malawi started universal treatment (i.e., 'Test and Start') for HIV-positive children younger than age 12 months in 2011.7 In 2014, this was scaled up to cover all children younger than age 5 years,6 and in 2016 Malawi implemented 'Test and Start' to cover all people living with HIV nationally.8 One component of 'Test and Start' implementation is scaling up of HIV virologic testing among infants born to HIV-positive mothers, and this requires a rapid expansion of laboratory services in Malawi.
There is a paucity of adequate paediatric HIV data generally in Malawi and specifically on factors associated with infant HIV positivity. In addition to difficulties in testing all infants born to HIV-positive mothers, there have been significant challenges in turn-around times for infant HIV test results, thus affecting early diagnosis in Malawi. Turn-around time is a metric used to assess the length of time between steps in the laboratory testing process. Longer turn-around times lead to delays in getting test results, which lead to delayed diagnoses. Any delay in diagnosis invariably leads to delays in the initiation of treatment, leading to poorer health outcomes that can result in higher mortality rates among untreated infants. The objectives of this study were to look at HIV positivity in infants in Malawi over time, and assess factors associated with positivity. In addition, we looked at the turn-around time for infant HIV testing to understand the timeliness of diagnoses.
Methods
Ethical considerations
This study was approved as exempt 45 CFR 46.101(b)(4) by the Centers for Disease Control and Prevention institutional review board (#6890) and the National Health Science Research Committee, Ministry of Health, Malawi (#1675).
No extra data were collected for the purpose of these analyses. The Malawi HIV laboratory information management system (LIMS) database does not include patient names but does include unique patient identification numbers, which were scrambled prior to analysis, so that they may be used to clean or de-duplicate the data set but cannot be linked back to a patient.
Study design
A cross-sectional analysis was conducted on data from the LIMS. The United States President's Emergency Plan for AIDS Relief supported the development of a LIMS in Malawi, which captures basic information on each infant HIV and viral load sample sent for testing. Although originally developed to project reagent needs for laboratories conducting virologic testing and thus keep track of laboratory functions, the database offers important information both on the utilisation of laboratory services as well as on the effectiveness of HIV services. Data included in the LIMS are routinely collected as part of regular provision of HIV services. These data include patient demographics, records of sample transportation and laboratory test outcomes. All data are entered into encrypted databases that are centrally stored and are password protected.
Data analysis
Data between 2012 and 2015 were extracted from the infant HIV testing database of the Malawi LIMS. Records for infants aged 0 to 18 months at the time of specimen collection were included in the analysis. Tests were excluded from the analysis if the test result was missing. There were two patient identification numbers available in the system that were used. Data were excluded if both patient identification numbers were missing to avoid duplication. Based on the patient identification numbers, if there was more than one record found in the database for a patient identification number, the record with the latest test date was kept and the others dropped before analysis. Infant HIV positivity was defined as detection of HIV DNA using a PCR test. In Malawi, specimens with positive or indeterminate results are re-tested for confirmation. Table 1 shows the variables from the LIMS database that were included in the analysis. Overall turn-around time was defined as the time between collection of the sample at the healthcare facility to the dispatch of the results from the laboratory back to the facility. Data were dropped from the turn-around time analysis if the date values were implausible (e.g., if the date of the test was before the date of the collection or date of birth). Mean and median turn-around times were calculated between all major steps of the process.

Since the Malawi LIMS includes routinely collected data, a number of variables had missing values. Observations were missing from the records for infant feeding option (60%), reason for PCR testing (37%), infant sex (26%), ART and life status of the mother (alive and on ART, alive but not on ART, deceased; 12%), multiple-birth indicator (8%), region (1.2%) and age (0.2%). We presumed that observations in all these variables were missing at random and used fully conditional chained equations9 to impute 50 completed data sets for analysis.
Bivariate and multivariable logistic regression analyses were undertaken on each of the multiply imputed data sets, and combined using Rubin's rules,10 to identify factors associated with infant HIV positivity. The initial multivariable model included all variables approaching significance (p < 0.25) in the bivariate model, plus all plausible two-way interactions provisionally detected by changes in odds ratios between the bivariate analysis and a full main-effects model. We eliminated covariates one at a time - beginning with the interactions - based on p-values from Wald tests to identify the simplest plausible multivariable model, retaining only covariates and interactions for which p ≤ 0.05. Our inferences were based upon the adjusted odds ratios (aOR) from the final multivariable model and their 95% confidence intervals (CI). STATA version 15 (StataCorp LP, College Station, Texas, United States) was used to conduct analyses.
Results
The 2012-2015 data set included 125 713 tests, and 106 997 tests (85.1%) from unique infants aged 0-18 months which were included in the analysis of associations with HIV positivity. Of those, only 76 006 tests had complete date recordings and those were used for the analysis of turn-around times. A total of 23 954 tests were conducted in 2012, 27 437 in 2013, 29 880 in 2014 and 25 726 in 2015. Most infants tested were younger than 3 months old (66.6%); there were almost equal numbers of male (39 628) and female (39 525) infants and most infants were from southern Malawi (69.1%; Table 2).
HIV positivity
The overall infant HIV positivity between 2012 and 2015 was 4.2% (n = 4448), which reduced from 5.7% in 2012 to 3.1% in 2015. Positivity was 4.3% in male infants (n = 1701) and 4.7% in female infants (n = 1840) and increased by age (2.3% in infants aged < 3 months old, 5.8% in infants aged 3-6 months old, 9.6% in infants aged 6-9 months old, and 12.4% in infants aged > 9 months old; Table 2). Positivity was higher if the mother was not on ART during pregnancy or labour (22.6%) or if the mother's ART status was unknown (4.4%), compared to women who were on ART during pregnancy or labour (2.5%). Positivity was highest for infants of deceased mothers (5.6%), compared to those whose mothers were alive and on ART (2.3%). Positivity was higher if the infant was not given HIV prophylaxis at birth (18.1%) compared to those who were given prophylaxis at birth (2.5%).
On multivariable analyses, the odds of testing positive for HIV decreased by 18% per year (aOR 0.82, 95% CI: 0.70-0.84). Other factors significantly associated with testing positive for HIV were increasing age of the infant (3-6 months: aOR 2.24, 95% CI: 2.07-2.42; 6-9 months: aOR 3.42, 95% CI: 3.13-3.74; > 9 months: aOR 4.24, 95% CI: 3.84-4.67), female sex (aOR 1.08, 95% CI 1.01-1.16), whether the mother was alive but not on ART at the time of the infant HIV test (aOR 1.57, 95% CI: 1.36-1.82), and if PCR was conducted because the infant was presumed to have severe HIV disease (aOR 2.37, 95% CI: 1.65-3.39) (Table 2). Immediate postpartum provision of HIV prophylaxis to infants was protective against testing positive for HIV (aOR 0.38, 95% CI: 0.33-0.44). The effects of ART during pregnancy or labour varied among regions, as manifested by an interaction between region and ART provision during pregnancy or labour. Infants born to mothers who received ART during pregnancy or labour were equally likely to test positive regardless of region. Conversely, the aORs for infants born to mothers who did not receive ART during either pregnancy or labour varied among regions, and infants born in the central region had the lowest aOR (2.80, 95% CI 2.06-3.81) relative to baseline (infants born in the northern region to mothers who received ART during pregnancy or labour) (Table 3).

Turn-around time
The overall median turn-around time between HIV-related sample collection at the healthcare facility to the dispatch of results from the laboratory back to the facility was 24 days (interquartile range: 15-36 days), whereas the mean turn-around time was 29.1 days (standard deviation: 22.5 days) (Table 4). The median turn-around time was 19 days in 2012 but increased by 79% to 34 days in 2015. Median turn-around time was longest in the northern region (28 days, interquartile range: 20-40 days), followed by central (27 days, interquartile range: 17-40 days) and southern region (23 days, interquartile range: 15-35 days). Median times increased for all steps from 2012 to 2015: median turn-around time between sample drawn at the health facility and being received at the laboratory increased from 11 days in 2012 to 16 days in 2015; the median turn-around time between the sample being received and the sample testing increased from 4 to 6 days; median turn-around time between sample testing and the dispatch of the result from the laboratory back to the facility increased from 0 to 3 days.
Discussion
This study used data from Malawi LIMS, a routinely collected HIV data source, and showed that the overall HIV positivity in HIV-exposed infants reduced from 5.7% in 2012 to 3.1% in 2015; however, the overall median turn-around time between collection of the sample at the healthcare facility to the dispatch of the results from the laboratory back to the facility increased from 19 days in 2012 to 34 days in 2015. In addition, LIMS data were analysed to identify factors associated with HIV positivity in infants, including infant age and maternal ART uptake. These results highlight the point that routine testing data from LIMS can be used not only to inform service delivery but to conduct epidemiological analyses to fill gaps in knowledge about HIV infection.
The positivity results from this study (3.1% in 2015) are similar to the results reported by the Ministry of Health (3% in 2014).2 Infant HIV positivity reduced between 2012 and 2015 and prevention of mother-to-child-transmission (PMTCT) initiatives are likely the main reason for this. Specifically, implementation of option B+ (where all pregnant women living with HIV are started on lifelong ART irrespective of their cluster of differentiation 4 count)11 - as opposed to option A (in which pregnant women receive ART prophylaxis antenatal and intrapartum, along with a postpartum 'tail' regimen) and option B (in which all women receive ART starting in the antenatal period with continued treatment throughout the breastfeeding duration) - has reduced the mother-to-child-transmission (MTCT) of HIV. The Malawi Population-Based HIV Impact Assessment found that 97.9% of self-reported HIV-positive women aged 15-49 years who gave birth in the last 12 months before the survey reported having received ART.4 It is important to note that Malawi introduced option B+ in 2011, before it became a recommendation by the World Health Organization.12 Since then, the coverage of pregnant women who received ART to prevent MTCT increased from 62% in 2012 to 79% in 2015 (and further increased to > 95% in 2018).13 Owing to the increase in the number of women who received ART to prevent MTCT, the number of new HIV infections averted have increased, from 8100 in 2012 to 8600 in 2015 (and further increased to 9600 in 2018), and the number of new infections among children aged 0-14 years has decreased from 9300 in 2012 to 6400 in 2015 (and further decreased to 3500 in 2018).13 In addition to the increase in PMTCT, the proportion of infants born to HIV-positive women who received an HIV virological test within the first 2 months after birth increased from 5% in 2012 to 22% in 2015 (and further increased to > 95% in 2018).13 Thus, the reduction in positivity rates is probably led by the reducing MTCT rates due to option B+. Another possible factor contributing to decreased positivity is the increase in testing in healthy infants due to the expansion of early infant diagnosis testing.
This study identified a number of factors found to be associated with HIV positivity in infants. Increasing age was associated with the risk of testing positive. This could be due to a delay in infant testing, duration of breastfeeding, or lack of access or adherence to care and treatment. Most mothers breastfeed in Malawi and the longer a mother who is not on ART breastfeeds, the greater the risk of transmission of HIV to the infant.14 Current Malawi guidelines dictate that HIV-exposed infants should be tested between age 6 and 8 weeks. However, this finding shows that at least some of the infants are not getting tested by 6-8 weeks which may be because mothers are not accessing care and treatment for their HIV. This could be due to non-disclosure issues which can pose a risk for sexual transmission of HIV to the partner, and impact the implementation of PMTCT.15 Also, since the latest test result was selected from the LIMS for this study, some results may reflect a repeat or confirmatory test and thus could have contributed to the observed late testing.
Infants born to mothers who received ART during pregnancy or labour experienced indistinguishable risks of HIV infection across all regions. However, infants born to mothers who did not receive ART during either pregnancy or labour were more likely to have been infected, and their odds ratio varied among regions. Infants born in the central region to mothers who did not receive ART had a slightly lower aOR relative to baseline than their counterparts born in the northern and southern regions; however, the confidence intervals overlapped for all three regions. Infants were at higher risk of being tested positive if mothers were alive and not on ART at the time of the test compared to those whose mothers were alive and on ART. This shows the importance of providing ART during pregnancy to women living with HIV14,16,17,18,19 and during labour,18 which is well established as a PMTCT measure.
Human immunodeficiency virus-exposed infants not provided with HIV prophylaxis at the time of birth were at an increased risk of being HIV-positive as opposed to those who were provided with prophylaxis at birth. In addition, HIV-exposed infants with presumed severe HIV disease at The time of the test were at a higher risk of being HIV-positive. Various studies have reported that suboptimal use of ART and inadequate skilled care during the delivery are factors that increase MTCT.14,16 Human immunodeficiency virus prophylaxis reduces the concentration of HIV virus in the infants' blood.20,21 Thus, HIV prophylaxis should be provided to all exposed infants to reduce perinatal transmission of HIV and those who test positive should be started on ART immediately. Lastly, female infants were at a higher risk of testing HIV-positive compared to male infants. There is some evidence that female infants, compared to male infants, have higher susceptibility to HIV infection before birth. One study reported a significant association between sex and HIV infection, with female infants being at a much higher risk for HIV acquisition than male infants at birth, suggesting in utero acquisition.22
Currently, infant HIV virologic testing in Malawi depends on the availability of equipment, laboratory space and trained technicians.23,24 Out of the 28 districts in Malawi, only 7 have molecular laboratories that can perform infant HIV virologic testing. Therefore, samples need to be transported to these laboratories for testing from the districts with no molecular laboratories. This can increase the turn-around time for testing, resulting in delays in the return of the result back to the patient and start of treatment if the result is HIV-positive. Multiple factors can prolong turn-around time, including delays with sample transport due to inclement weather, shortage of fuel and holidays.25 Laboratory factors can also delay turn-around time, including staff shortages, work overload, stock-out of reagents, issues with equipment and other administrative delays.26 The increase in turn-around time documented in this study occurred during a period of rapid expansion of option B+ for PMTCT. The PMTCT programme uses the same mechanisms for transport of samples and ART and the same laboratory facilities for HIV viral load testing. The increased turn-around time likely represents stresses on the system across all levels as scale-up occurred. A sample tracking and online result reporting system - so samples can be tracked during delivery and results can arrive at the facility as soon as tested - can help with improving turn-around time and providing results as soon as possible to clinicians. Another option could be the use of HIV point-of-care testing which can deliver results at the test site. Although point-of-care testing is currently not available on a routine basis in Malawi, a point-of-care early infant diagnosis implementation pilot conducted in Malawi reduced the turn-around time from collection of sample to ART initiation and increased the proportion of patients initiating ART.27
The findings in this study are strengthened by the fact that the data set used in this study is the national laboratory data set which includes data from all tests conducted at the national laboratories in the country. This includes tests conducted at the public health facilities and the externally managed facilities and there is a minimal chance of testing happening at a laboratory outside the national laboratories. Additionally, the data are available from 2012 onwards which allows for interpretation of the trends over time. The availability of turn-around time data provides a rare opportunity to monitor the delivery of laboratory services on a national scale. Findings from this study may be applicable throughout sub-Saharan Africa, especially in countries that are scaling up virologic testing.
Limitations
Like all studies, this study has limitations. Firstly, as the data set only included routinely collected variables, only a limited set of variables could be included in the logistic regression. Some other important variables that could provide insight into other demographic, behavioural and clinical factors associated with HIV positivity in infants could not be included, as they are not collected routinely. Secondly, multiple patient identification numbers were available in the data set. However, none of the identification numbers were completely available for the majority of the patients. Therefore, the data had to be de-duplicated using various patient identification numbers, which, in spite of all efforts, may have led to some duplication in the data set. Thirdly, a number of variables had missing data. This was due to incomplete data recording and changes in the HIV test requisition form over time. We attempted to address this by doing multiple imputations and using the imputed data to conduct the regression analyses. For the turn-around time analysis, nearly 40% of tests had to be excluded from analysis, if the dates were missing or if the dates were implausible. Better data management and quality control is required to resolve issues of missing data, which will improve the measurement of indicators. Fourthly, the variable 'mother's life and ART status' at the time of the infant's HIV test may not have been correctly entered. It seems that when the mother's life and ART status were missing, it was recorded as mother not on ART. This is important to note, because in the option B+ era in Malawi, it is unlikely that so many women were HIV-positive and not on ART. Lastly, LIMS is not connected to the clinical systems; thus, we were unable to ascertain outcomes of positive tests, that is, what proportion of infants were put on treatment and how quickly.
As LIMS is a routinely collected data source, it can potentially be used for surveillance purposes. However, as described, currently there are a number of data quality and completeness issues that may limit the ability of LIMS to be used as a surveillance system. Attention to detail is required to improve the quality and completeness of LIMS data, and routine data cleaning and validation procedures should be implemented before LIMS can be considered as a surveillance system. In addition, a formal comparison of data generated by LIMS and those generated by other data systems (e.g., electronic medical records) is required to validate the use of LIMS as a surveillance system in Malawi.
Conclusion
Although infant HIV positivity has decreased over time in Malawi, the turn-around time has increased over the same period of time. Active engagement from all stakeholders is required to reduce the turn-around time to assist with implementation of 'Test and Start' among infants in the country. The earlier HIV is detected in infants, and treatment started by the clinician, the better the outcomes among these infants. Therefore, it is imperative to test early and provide the results to clinicians as soon as possible so that appropriate care and treatment are provided to infants. Although this study shows that LIMS can provide important information about infant HIV virologic testing, we do not know what proportion of patients actually received these results and what proportion of results were actually acted upon by clinicians. Although LIMS in Malawi was designed to provide information for the laboratories, it can provide other important epidemiological pieces of information. This evidence-based information can guide development and restructuring of policy and programmes in the country.
Acknowledgements
The authors would like to acknowledge all the implementing partners in Malawi for their support of this study and the mapping exercise. Thanks to Ermias Amene, statistician at the Centers for Disease Control and Prevention, for his assistance.
Competing interests
No conflicts of interest are declared by authors.
Authors' contributions
H.A., A.K. and D.S. conceptualised the study; H.A. and S.G. conducted the analysis; H.A. wrote the first draft; P.M., G.C. and A.K. provided technical input; all authors provided input on the initial and final drafts.
Sources of support
This analysis was supported by the President's Emergency Plan for AIDS Relief through the Centers for Disease Control and Prevention.
Data availability statement
Data sharing is not applicable to this article as no new data were collected in this study.
Disclaimer
The findings and conclusions in this report are those of the authors and do not necessarily represent the official position of the funding agencies.
References
1.Joint United Nations Programme on HIV/AIDS. Malawi HIV and AIDS estimates [homepage on the Internet]. 2017 [cited 2020 Nov 2]. Available from: http://www.unaids.org/en/regionscountries/countries/malawi/ [ Links ]
2.Government of Malawi. Malawi AIDS response progress report 2015. Lilongwe: Government of Malawi; 2015. [ Links ]
3.Joint United Nations Programme on HIV/AIDS. 90-90-90 An ambitious treatment target to help end the AIDS epidemic [homepage on the Internet]. 2014 [cited 2020 Nov 2]. Available from: http://www.unaids.org/en/resources/documents/2017/90-90-90 [ Links ]
4.Ministry of Health Malawi. Malawi population-based HIV impact assessment (MPHIA) 2015-16: Final report. Lilongwe: Ministry of Health Malawi; 2018. [ Links ]
5.World Health Organization. Guideline on when to start antiretroviral therapy and on pre-exposure prophylaxis for HIV. Geneva: World Health Organization; 2015. [ Links ]
6.Ministry of Health Malawi. Clinical management of HIV in children and adults. Lilongwe: Ministry of Health Malawi; 2014. [ Links ]
7.Ministry of Health Malawi. Clinical management of HIV in children and adults. Lilongwe: Ministry of Health Malawi; 2011. [ Links ]
8.Chinele J. Malawi government says determined on new ART regime. The Times Malawi. 2016 Feb 13 [cited 2020 Nov 2]. Available from: https://times.mw/malawi-government-says-determined-on-new-art-regime [ Links ]
9.Van Buuren S. Multiple imputation of discrete and continuous data by fully conditional specification. Stat Methods Med Res. 2007;16(3):219-242. https://doi.org/10.1177/0962280206074463 [ Links ]
10.Rubin D. Multiple imputation for nonresponse in surveys. New York, NY: Wiley; 1987. [ Links ]
11.United Nations Children's Fund. Options B and B+: Key considerations for countries to implement an equity-focused approach. New York, NY: UNICEF; 2012. [ Links ]
12.Kieffer MP, Mattingly M, Giphart A, et al. Lessons learned from early implementation of option B+: The Elizabeth Glaser Pediatric AIDS Foundation experience in 11 African countries. J Acqui Immune Defic Syndr. 2014;67(Suppl 4):S188. https://doi.org/10.1097/QAI.0000000000000372 [ Links ]
13.Joint United Nations Programme on HIV/AIDS [homepage on the Internet]. AIDSinfo. 2019 [cited 2020 Nov 2]. Available from: http://aidsinfo.unaids.org/ [ Links ]
14.Berhan Z, Abebe F, Gedefaw M, Tesfa M, Assefa M, Tafere Y. Risk of HIV and associated factors among infants born to HIV positive women in Amhara region, Ethiopia: A facility based retrospective study. BMC Res Notes. 2014;7(1):876. https://doi.org/10.1186/1756-0500-7-876 [ Links ]
15.Hatcher AM, Woollett N, Pallitto CC, et al. Bidirectional links between HIV and intimate partner violence in pregnancy: Implications for prevention of mother-to-child transmission. J Int AIDS Soc. 2014;17(1):19233. https://doi.org/10.7448/IAS.17.1.19233 [ Links ]
16.Anígilájé E, Dabit O, Ageda B, Hwande S, Bitto T. The prevalence and predictors of HIV infection among children of mothers who missed prevention of mother to child transmission of HIV interventions in Makurdi, Nigeria. J AIDS Clin Res. 2013;4(11):249. https://doi.org/10.4172/2155-6113.1000249 [ Links ]
17.Magder LS, Mofenson L, Paul ME, et al. Risk factors for in utero and intrapartum transmission of HIV. JAIDS. 2005;38(1):87-95. https://doi.org/10.1097/00126334-200501010-00016 [ Links ]
18.De Lemos LM, Lippi J, Rutherford GW, et al. Maternal risk factors for HIV infection in infants in northeastern Brazil. Int J Inf Dis. 2013;17(10):e913-e918. https://doi.org/10.1016/j.ijid.2013.04.015 [ Links ]
19.Okoko NA, Owuor KO, Kulzer JL, et al. Factors associated with mother to child transmission of HIV despite overall low transmission rates in HIV-exposed infants in rural Kenya. Int J STD AIDS. 2017;28(12): 1215-1223. https://doi.org/10.1177/0956462417693735 [ Links ]
20.De Cock KM, Fowler MG, Mercier E, et al. Prevention of mother-to-child HIV transmission in resource-poor countries: Translating research into policy and practice. JAMA. 2000;283(9):1175-1182. https://doi.org/10.1001/jama.283.9.1175 [ Links ]
21.Volmink J, Siegfried N, van der Merwe L, Brocklehurst P. Antiretrovirals for reducing the risk of mother-to-child transmission of HIV infection. Cochrane Database Syst Rev. 2007;1:CD003510. https://doi.org/10.1002/14651858.CD003510.pub2 [ Links ]
22.Taha TE, Nour S, Kumwenda NI, et al. Gender differences in perinatal HIV acquisition among African infants. Pediatrics. 2005;115(2):e167-e172. https://doi.org/10.1542/peds.2004-1590 [ Links ]
23.Fiscus SA, Cheng B, Crowe SM, et al. HIV-1 viral load assays for resource-limited settings. PLoS Med. 2006;3(10):e417. https://doi.org/10.1371/journal.pmed.0030417 [ Links ]
24.Roberts T, Bygrave H, Fajardo E, Ford N. Challenges and opportunities for the implementation of virological testing in resource-limited settings. J Int AIDS Soc. 2012;15(2):17324. https://doi.org/10.7448/IAS.15.2.17324 [ Links ]
25.Minchella PA, Chipungu G, Kim AA, et al. Specimen origin, type and testing laboratory are linked to longer turnaround times for HIV viral load testing in Malawi. PLoS One. 2017;12(2):e0173009. https://doi.org/10.1371/journal.pone.0173009 [ Links ]
26.Thiha S, Shewade HD, Philip S, et al. Factors associated with long turnaround time for early infant diagnosis of HIV in Myanmar. Glob Health Action. 2017;10(1):1395657. https://doi.org/10.1080/16549716.2017.1395657 [ Links ]
27.Mwenda R, Vojnov L, Saka E, et al. Significantly improved antiretroviral therapy initiation rates after the implementation of point of care early infant diagnosis. African Society for Laboratory Medicine Conference Cape Town, South Africa. 3-8 December 2016. [ Links ]
Correspondence:
Hammad Ali
hali@cdc.gov
Received: 30 Aug. 2018
Accepted: 27 Aug. 2020
Published: 26 Nov. 2020
ORIGINAL RESEARCH
A global proficiency testing programme for Xpert® MTB/RIF using dried tube specimens, 2013-2015
Katherine KleinI; Kyle DeGruyII; Zilma ReyII; Patricia HallII; Andrea KimIII; Steve GutreuterIV; Heather AlexanderII
ICenters for Disease Control and Prevention, National Center for HIV/AIDS, Viral Hepatitis, STD and TB Prevention, Division of TB Elimination, Atlanta, Georgia, United States
IICenters for Disease Control and Prevention, Division of Global HIV and TB, International Laboratory Branch, Atlanta, Georgia, United States
IIICenters for Disease Control and Prevention, Division of Global HIV and TB, Epidemiology and Surveillance Branch, Atlanta, Georgia, United States
IVCenters for Disease Control and Prevention, Division of Global HIV and TB, Health Informatics, Data Management and Statistics Branch, Atlanta, Georgia, United States
ABSTRACT
BACKGROUND: Proficiency testing (PT) is an important quality assurance measure toward ensuring accurate and reliable diagnostic test results from clinical and public health laboratories. Despite the rapid expansion of the Xpert® MTB/RIF assay for the detection of tuberculosis in resource-limited settings (RLS), low-cost PT materials for Xpert MTB/RIF external quality assessment (EQA) are not widely available.
OBJECTIVE: We sought to determine whether a dried tube specimen (DTS)-based PT programme would be a feasible option to support Xpert MTB/RIF EQA in RLS.
METHODS: Between 2013 and 2015, the United States Centers for Disease Control and Prevention developed and conducted a voluntary EQA programme using DTS-based PT material. Eight rounds of PT, each comprising five DTS samples, were provided to enrolled testing sites. After each round, participant results were compared to expected results, scored as satisfactory or unsatisfactory, and sites were provided with performance reports.
RESULTS: Programme enrolment increased from 102 testing sites in seven countries to 441 testing sites in 14 countries over the course of three years. In each PT round, approximately 90% of participating sites demonstrated satisfactory performance. In seven of the 14 enrolled countries, the proportion of sites with a satisfactory score increased between the first round of participation and the most recent round of participation.
CONCLUSION: This programme demonstrated that it is possible to implement an Xpert MTB/RIF PT programme for RLS using DTS, that substantial demand for Xpert MTB/RIF PT material exists in RLS, and that country performance can improve in a DTS-based PT programme
Keywords: external quality assessment; Xpert® MTB/RIF; proficiency testing; dried tube specimens; resource-limited settings.
Introduction
The World Health Organization recommends the Xpert® MTB/RIF (Mycobacterium tuberculosis/rifampicin) assay (Cepheid, Sunnyvale, California, United States) as one of the initial diagnostic tests for all individuals evaluated for tuberculosis.1,2 The Xpert MTB/RIF assay is an integrated sputum processing and real-time polymerase chain reaction system that rapidly and simultaneously detects M. tuberculosis and the presence of mutations conferring resistance to rifampicin.3 The roll-out of the Xpert MTB/RIF assay to resource-limited settings (RLS) with a high tuberculosis burden has been remarkable. By the end of 2016, 6659 GeneXpert instruments had been purchased at concessional prices for use at multiple levels of the tiered laboratory network.4
External quality assessment is a critical component of a laboratory quality management system. Proficiency testing (PT) is one means of conducting external quality assessment for tests in clinical laboratories. Proficiency testing provides objective evidence of accurate testing and may identify areas in the diagnostic process, including pre-analytic, analytic, and post-analytic phases, where quality improvement is needed.5,6 The rapid scale-up of Xpert MTB/RIF testing in RLS has not coincided with the same investment in quality assurance activities for the assay. Few PT providers for the Xpert MTB/RIF assay offer materials to sites in RLS, leaving a substantial gap in external quality assessment implementation that could otherwise help to confirm site competency in assay administration and accuracy of test results for limited-resource countries.7,8,9
The United States Centers for Disease Control and Prevention (CDC) developed a PT panel for Xpert MTB/RIF, using a dried tube specimen (DTS)-based method.10 The DTS technique has successfully been used to develop PT panels for HIV, malaria and syphilis diagnostic assays in RLS.11,12,13 Our goal in this evaluation was to assess the performance and utility of CDC-prepared DTS panels in an Xpert MTB/RIF PT programme.
Methods
Ethical considerations
No patient specimen collection was required and no patient identifiers were recorded on quality assurance tools. Participation in the Xpert MTB/RIF quality assurance and PT programme was voluntary and free of charge. No incentives were provided. This study was approved by the CDC Center for Global Health Division of Human Research Protection (CGH HSR tracking number 2014-082).
Dried tube specimen production
The method for producing DTS was described previously by DeGruy et al.10 Briefly, DTS were produced by chemically inactivating liquid cultures of well-characterised mycobacterial strains using equipment and supplies commonly found in laboratories conducting tuberculosis liquid culture.14 Mycobacteria were grown in BACTEC® MGIT 7 mL tubes (Becton, Dickinson and Company, Sparks, Maryland, United States) and inactivated using a 2:1 ratio of Xpert MTB/RIF sample reagent (Cepheid, Sunnyvale, California, United States) to MGIT culture incubated for 2 hours with intermittent vortexing. Inactivated cultures were washed, concentrated, resuspended, homogenised and diluted, before being dispensed into cryovials and air-dried in a Class II biological safety cabinet within a Biosafety Level III tuberculosis containment laboratory. Inactivation verification was performed by inoculating 0.5 mL of undiluted stock solution into MGIT tubes supplemented with polymyxin B, amphotericin B, nalidixic acid, trimethoprim, and azlocillin (PANTA) (Becton, Dickinson and Company, Sparks, Maryland, United States) and incubating for a total of 84 days over two incubation cycles in the BACTEC® MGIT 960® instrument (Becton, Dickinson and Company, Sparks, Maryland, United States) to confirm a lack of growth. Dried tube specimens were validated prior to distribution by testing 10% of DTS produced with the Xpert MTB/RIF assay (Cepheid, Sunnyvale, California, United States), as described previously.10 To test DTS, the DTS were rehydrated with 2.5 mL of sample reagent, shaken vigorously 20 times and incubated at room temperature for 15 minutes with additional shaking repeated after 10 min. The Xpert MTB/RIF cartridges were inoculated with approximately 2.0 mL of rehydrated samples using the transfer pipette provided with the kit, and tested immediately on a GeneXpert IV or GeneXpert VIII using GeneXpert DX software version 4.0 (Cepheid, Sunnyvale, California, United States) according to manufacturer instructions.15
Proficiency testing programme
In 2013, select countries in sub-Saharan Africa, Southeast Asia, and the Caribbean, supported by the United States President's Emergency Plan for AIDS Relief were invited to participate in CDC-Atlanta's pilot DTS Xpert MTB/RIF PT programme at no cost. Seven countries elected to participate in the pilot, designated a PT country coordinator, and enrolled testing sites that routinely conducted Xpert MTB/RIF testing on patient specimens. These countries continued to enrol additional sites throughout 2013, and four additional countries enrolled in subsequent 2013 PT rounds. All countries remained enrolled throughout 2014. In 2015, enrolment was extended to additional sites in all participating countries plus three new countries in Africa.
The PT kits included a panel of five DTS samples, five transfer pipettes, testing instructions, and a paper form for recording results. Four PT rounds were distributed quarterly in 2013 (2013-A, 2013-B, 2013-C and 2013-D). Only one PT round was distributed at the end of 2014 (2014-A) to allow for evaluation of 2013 data. Three PT rounds were distributed in 2015 (2015-A, 2015-B and 2015-C). Country coordinators were responsible for distributing the panels to enrolled testing sites, collating results (including transferring data from paper forms to a template Microsoft Excel file (Microsoft Corp, Redmond, Washington, United States) and submitting data to CDC-Atlanta via email within nine weeks of panel receipt. A sufficient number of PT kits were sent to enrolled countries to allow for distribution of one PT kit to each enrolled site; enrolled sites that did not submit results were categorised as enrolled but not participating in a given PT round.
Participant data were analysed by CDC-Atlanta using Microsoft Excel. A report was generated for each participating site; this compared the site's reported results to expected results (CDC-Atlanta validation results) and included the consensus results from all the participating testing sites in all the ountries. Consensus results detailed the number of testing sites detecting and not detecting M. tuberculosis complex, detecting and not detecting rifampicin resistance, reporting indeterminate rifampicin resistance, reporting uninterpretable tests (error, invalid, or no result), and not reporting M. tuberculosis complex and/or rifampicin results for each sample in the panel. To establish a consensus result for each PT sample in the round, we required at least 80% of participant results for that sample to match the expected result. In the 2013 pilot phase, participating sites were provided with qualitative reports indicating overall concordance of submitted results with the expected results. Beginning in 2014, participating sites were assigned a quantitative score for each PT round. Scores were calculated by assigning a value of 20 points to each of the five DTS, for a total of 100 possible points. If the site's qualitative M. tuberculosis complex and rifampicin resistance detection results matched the expected results for a given sample, 20 points were awarded. If either the M. tuberculosis complex detection result or the rifampicin resistance detection result did not match the expected results, zero points were awarded. If the M. tuberculosis complex detection result matched the expected result but the site's rifampicin resistance detection result was indeterminate, 10 points were awarded. If a site reported an uninterpretable test, five points were awarded. If a site did not report a result, zero points were awarded. A total score of greater than, or equal to, 80 points was considered satisfactory for the PT round. For this evaluation, 2013 results were retrospectively scored to compare performance across all years of the programme.
To further investigate concordance and discordance of site results with expected results, additional analyses were conducted in SAS version 9.3 (SAS Institute, Cary, North Carolina, United States). Results were categorised as concordant if both the qualitative M. tuberculosis complex and rifampicin results matched the expected results. If discordant, results were categorised according to the type of discordance (false-positive M. tuberculosis complex detection, unsuccessful run, etc.). Tests were considered unsuccessful when the test was started, but a definitive result was not obtained due to an error, invalid result, power failure during testing, or similar problem. Tests were also considered unsuccessful if the site chose not to test the sample, was unable to test the sample due to unavailability of Xpert MTB/RIF kits, or failed to report either the M. tuberculosis complex or rifampicin detection result. Frequencies for results in each category were calculated by PT sample and in aggregate for all samples. The mycobacterial strain used to produce the PT sample and the mean cycle threshold (Ct) of probe A during validation of the PT sample were included in the analysis to look for trends between these variables and the amount and type of discordance observed. In line with previous studies, probe A was selected for most analyses as it was the first probe to reach the detection threshold.7
We conducted additional statistical analyses to test for an association between the mean Ct of probe A during validation and several types of discordance including false-negative M. tuberculosis complex detection, false-positive rifampicin resistance, and indeterminate rifampicin resistance. Logistic regression of the type of discordance on mean Ct of probe A was conducted using R glm (R Foundation for Statistical Computing, Vienna, Austria).16
Results
Enrolment in the DTS-based Xpert MTB/RIF PT programme increased steadily from round 2013-A to round 2015-C, with 102 sites in seven countries enrolled in round 2013-A and 441 sites in 14 countries enrolled in round 2015-C (Figure 1). Participation by enrolled sites increased from 68 sites in six countries in round 2013-A to 342 sites in 13 countries in round 2015-C. The participation among sites ranged from a minimum of 66.7% in round 2013-A to a maximum of 83.8% in round 2015-B.

The proportion of participating sites with a satisfactory score ranged from a minimum of 88.1% in round 2015-B to a maximum of 93.1% in round 2014-A (Table 1). Individual countries had as few as 50% and as many as 100% of their participating sites achieve satisfactory scores. In seven of the 14 enrolled countries, the proportion of sites with a satisfactory score increased between the first round of participation and the most recent round of participation. Of the remaining seven countries, the proportion of sites with a satisfactory score remained constant in three countries but decreased in four countries (Table 1).
All 40 PT samples met the criteria for establishing a consensus result except 2015-B-1. 2015-B-1 was below 80% concordance with expected results, primarily due to a high rate of false-negative M. tuberculosis complex detection results (19.9%) (Table 2). This sample is further discussed in the Limitations section. For 29 of the 39 PT samples with a consensus result, over 90% of DTS results received were concordant with the expected result. Five of the 10 PT samples with < 90% concordance had false-negative M. tuberculosis complex detection as the most frequently observed cause for discordance, four of the 10 samples had unsuccessful tests (errors, invalids, and other causes) as the most frequently observed cause for discordance, while one sample had an equal number of unsuccessful tests and indeterminate rifampicin results. Error rates ranged from 0% to 5.9% across PT samples.
There were 765 (9.4%) discordant results out of 8150 DTS results received throughout the eight PT rounds. Of those, 350 (46%) discordant results were unsuccessful tests (Figure 2). False-negative M. tuberculosis complex results were the second-largest contributor to discordant results 224 (29%), followed by indeterminate rifampicin results 79 (10%). The remaining discordant results consisted of: false-negative rifampicin results 45 (6%), false-positive rifampicin results 34 (4%), and false-positive M. tuberculosis complex results 33 (5%).

Logistic regression of the proportion of false-negative M. tuberculosis complex detection results on the mean Ct of probe A during validation yielded an odds ratio of 1.42 (95% confidence interval [CI] 1.32-1.52). However, sample 2015-B-1's unusually high mean probe A Ct, combined with its unusually high proportion of false-negative M. tuberculosis complex detection results, may have unduly influenced this estimate. When this sample was removed from the calculation, the odds ratio decreased to 1.14 (95% CI 1.04-1.26). Logistic regression of the proportion of indeterminate rifampicin results and the proportion of false-positive rifampicin resistance results on the mean Ct of probe A during validation yielded odds ratios of 1.14 (95% CI 1.02-1.25) for indeterminates and 0.96 (95% CI 0.79-1.16) for false positives.
Discussion
We have shown that it is feasible to implement an Xpert MTB/RIF PT programme for RLS using DTS. Over the eight rounds of PT panels provided across a period of three years, the number of countries participating in the programme doubled and the number of participating sites increased five-fold. In each PT round, at least two-thirds of enrolled sites participated in PT panel testing and reported test results. Lower participation rates were seen in rounds during which certain countries or their enrolled sites were subsequently unable to participate due to logistical challenges, such as a lack of funding for in-country panel distribution, lack of staff, PT kits being lost in the mail between the country coordinator and the enrolled testing site, non-functioning Xpert instruments or computers, and stockouts (inability to procure test cartridges). Further work is needed to investigate and address the reasons for non-participation in proficiency testing as part of a comprehensive continuous quality improvement package.
Most participating sites performed well in the DTS-based Xpert MTB/RIF PT programme. Approximately 90% of participating sites in each PT round demonstrated satisfactory performance, and over 90% of returned results during the study period were concordant with expected results. The most common reason for a result that was not concordant with the expected result was an unsuccessful test. Some of the reported causes of unsuccessful tests, such as power failures and stockouts of testing kits, are recurring challenges in RLS.17
The use of a similar sample type, dried culture spots, for Xpert MTB/RIF external quality assessment in South Africa has been described.7,8 We observed similar error rates to those reported by Scott et al. and Gous et al.; however, we observed a greater proportion of discordant results.7,8 The average Ct of probe A obtained from dried culture spots was lower than that of many DTS PT samples. Lower Cts correlate with greater amounts of M. tuberculosis complex DNA present in the sample, indicating that a higher concentration of M. tuberculosis complex DNA was present in the dried culture spots. This may account for the smaller proportion of false-negative M. tuberculosis complex detection results from dried culture spots. We observed that false-negative M. tuberculosis complex detection results were often more common among DTS samples with higher probe A Cts during validation. Our analyses using logistic regression confirmed a statistically significant positive association between higher probe A Cts and false-negative M. tuberculosis complex detection. For DTS samples produced at CDC during the study period, an increase of 1 cycle in the mean probe A Ct resulted in an estimated 42% increase in the proportion of false-negative M. tuberculosis complex detection results (the estimate decreased to 14% when sample 2015-B-1 was excluded). Similarly, we found a statistically significant positive association between higher probe A Cts and indeterminate rifampicin resistance results, with an estimated 14% increase in the proportion of indeterminate rifampicin resistance results for every 1 cycle increase in a sample's mean probe A Ct. No association was found between mean probe A Ct and false-positive rifampicin resistance, and we did not observe any trends between the strain used to produce DTS and the proportion and types of discordance during the study period. Based on these results, we are investigating modifications to the DTS preparation method that will increase the concentration of M. tuberculosis complex DNA present in DTS. However, it is not possible to rule out the presence of or determine the frequency of other site-specific factors, such as adherence to standard operating procedures, transcription errors, instrument maintenance and calibration, and DTS and test cartridge storage and shipping conditions that may influence the accuracy and reliability of Xpert MTB/RIF test results.
The large increase in enrolment we observed over the course of three years may have been influenced by several factors. As the World Health Organization endorsed Xpert MTB/RIF in 2010 and funds became available for the purchase of instruments, the number of laboratories in RLS utilising Xpert MTB/RIF increased dramatically.4 The World Health Organization's expanded recommendations for use of Xpert MTB/RIF in 2013 also encouraged rapid adoption of the technology.1 Over the same time period, the number of laboratories in RLS electing to pursue external accreditation also increased, facilitated by such programmes as Strengthening Laboratory Management Toward Accreditation, and Stepwise Laboratory Improvement Program Towards Accreditation.18,19 Thus, an increasing number of laboratories in RLS are in need of Xpert MTB/RIF PT material to demonstrate proficiency in line with recommendations and requirements for continuous quality improvement and accreditation programmes.
Limitations
Several challenges arose during operation of the DTS-based Xpert MTB/RIF PT programme. The participant consensus for sample 2015-B-1 was below 80% concordance with expected results, mainly due to false-negative M. tuberculosis complex results (failure to detect M. tuberculosis complex when the expected result was 'MTB detected'). Although this sample was produced using the same method as other DTS samples, the probe A Cts during validation were on average higher than those of other M. tuberculosis complex samples produced. This indicates 2015-B-1 contained fewer inactivated organisms and thus less DNA than other samples, potentially contributing to the higher proportion of false-negative M. tuberculosis complex results received.20 To investigate the low concordance of 2015-B-1, three remaining aliquots were tested and confirmed the lower than average semi-quantitative result. Due to the low participant consensus, the decision was made to award all sites that submitted results for 2015-B-1 full credit (20 points). Based on this experience, we have implemented additional DTS validation criteria to ensure DTS contain enough inactivated organism to perform reliably. Beginning in 2016, only DTS samples with an average Ct value of less than 23 for the first probe detected are included in the distributed PT panels. The mean Ct value of 23 was selected based on the findings of previous investigators, who observed good concordance with mean Ct values up to 23.7 In addition, recording and reporting of results was also a recurring challenge. At times, no explanation was provided for missing or incomplete results, and it was not possible to determine whether a site attempted to test the sample or if the test was unsuccessful and the result not reported. More clearly defined reporting language and procedures were added to report forms in future PT rounds to reduce the reliance of free text data entry and improve our ability to provide assistance on determining the root causes of discordant results and unsuccessful tests.
Recommendations and next steps
The steady increase in enrolment and number of sites participating in this DTS-based Xpert MTB/RIF PT programme demonstrates that there is a substantial demand for routine PT material for the Xpert MTB/RIF assay. The ease of large-scale batch preparation of DTS using readily available supplies and equipment, and the successful establishment of country coordinator roles for in-country management of PT programme operations, indicate that a DTS-based Xpert MTB/RIF PT programme could be a feasible option for countries wanting to manage their own Xpert MTB/RIF PT programme. Future work will focus on piloting the transfer of the DTS-based PT package to national and regional programmes as part of a comprehensive continuous quality improvement package, as well as developing a web-based PT data entry and reporting system.
Conclusion
A continuous quality improvement package for Xpert MTB/RIF in RLS that includes routine PT material is an important contributor to ensuring provision of accurate results. A DTS-based PT programme for Xpert MTB/RIF is a useful tool for monitoring and improving Xpert MTB/RIF performance. The simplicity of producing DTS and use of common mycobacteriology laboratory supplies make DTS a feasible way for countries to provide Xpert MTB/RIF PT material to their testing sites.
Acknowledgements
We thank Bharat Parekh for his inspiration and guidance, and all testing sites for their willingness to participate in the proficiency testing program.
Competing interests
The authors declare that they have no financial or personal relationships that may have inappropriately influenced them in writing this article.
Authors' contributions
K.D. and H.A. conceived and designed the experiments, which were performed by K.D. and K.K. Also, K.K., K.D. and S.G. analysed the data. K.K., K.D., Z.R., P.H. and A.K. wrote the article and all authors reviewed and approved the manuscript.
Sources of support
This research has been supported by the President's Emergency Plan for AIDS Relief through the United States Centers for Disease Control and Prevention, Atlanta Georgia.
Data availability statement
Data access level is public without identifying information of proficiency testers, testing sites and country.
Disclaimer
The findings and conclusions in this article are those of the authors and do not necessarily represent the official position of the United States Centers for Disease Control and Prevention. References in this manuscript to any specific commercial products, process, service, manufacturer, or company do not constitute its endorsement or recommendation by the United States government.
References
1.World Health Organization. Rapid communication: Molecular assays as initial tests for the diagnosis of tuberculosis and rifampicin [homepage on the Internet]. Geneva: WHO Press; c2020 [cited 2020 Sep 1]. Available from: https://www.who.int/publications-detail/rapid-communication-molecular-assays-as-initial-tests-for-the-diagnosis-of-tuberculosis-and-rifampicin-resistance [ Links ]
2.World Health Organization. Global tuberculosis report [homepage on the Internet]. Geneva: WHO Press; c2019 [cited 1 September 2020]. Available from: https://www.who.int/tb/publications/global_report/en/ [ Links ]
3.Helb D, Jones M, Story E, et al. Rapid detection of Mycobacterium tuberculosis and rifampin resistance by use of on-demand, near-patient technology. J Clin Microbiol. 2010;48(1):229-237. https://doi.org/10.1128/JCM.01463-09 [ Links ]
4.World Health Organization. Cumulative number of GeneXpert instrument modules and Xpert MTB/RIF cartridges procured under concessional pricing [homepage on the Internet]. Geneva: WHO Press; c2016 [cited 2020 Sep 1]. Available from: https://www.who.int/tb/areas-of-work/laboratory/status_xpert_rollout_dec_2016.pdf?ua=1 [ Links ]
5.World Health Organization. Laboratory quality management system: Handbook [homepage on the Internet]. Geneva: WHO Press; c2011 [cited 2020 Sep 1]. Available from: http://apps.who.int/iris/bitstream/10665/44665/1/9789241548274_eng.pdf [ Links ]
6.Global Laboratory Initiative. Guide for providing technical support to TB laboratories in low- and middle-income countries [homepage on the Internet]. n.d. [cited 2020 May 20]. Available from: http://stoptb.org/wg/gli/assets/documents/guideforprovidingtechnicalsupport_gb_web.pdf [ Links ]
7.Scott LE, Gous N, Cunningham BE, et al. Dried culture spots for Xpert MTB/RIF external quality assessment: Results of a Phase 1 pilot study in South Africa. J Clin Microbiol. 2011;49(12):4356-4360. https://doi.org/10.1128/JCM.05167-11 [ Links ]
8.Gous N, Cunningham B, Kana B, Stevens W, Scott LE. Performance monitoring of Mycobacterium tuberculosis dried culture spots for use with the GeneXpert system within a national program in South Africa. J Clin Microbiol. 2013;51(12):4018-4021. https://doi.org/10.1128/JCM.01715-13 [ Links ]
9.Scott L, Albert H, Gilpin C, Alexander H, DeGruy K, Stevens W. Multicenter feasibility study to assess external quality assessment panels for Xpert MTB/RIF assay in South Africa. J Clin Microbiol. 2014;52(7):2493-2499. https://doi.org/10.1128/JCM.03533-13 [ Links ]
10.DeGruy K, Rey Z, Alexander H. Dried tube specimens (DTS) for Xpert MTB/RIF proficiency panels [poster]. Presented at: African Society for Laboratory Medicine. 1st International Conference; 2012 December 1-7; Cape Town. [ Links ]
11.Benzaken AS, Bazzo ML, Galban E, et al. External quality assurance with dried tube specimens (DTS) for point-of-care syphilis and HIV tests: Experience in an indigenous populations screening programme in the Brazilian Amazon. Sexually Trans Inf. 2014;90(1):14-18. http://doi.org/10.1136/sextrans-2013-051181 [ Links ]
12.Nguyen S, Ramos A, Chang J, et al. Monitoring the quality of HIV-1 viral load testing through a proficiency testing program using dried tube specimens in resource-limited settings. J Clin Microbiol. 2015;53(4):1129-1136. https://doi.org/10.1128/JCM.02780-14 [ Links ]
13.Parekh B, Anyanwu J, Patel H, et al. Dried tube specimens: A simple and cost-effective method for preparation of HIV proficiency testing panels and quality control materials for use in resource-limited settings. J Virol Methods. 2010;163(2):295-300. https://doi.org/10.1016/j.jviromet.2009.10.013 [ Links ]
14.Morlock GP, Plikaytis BB, Crawford JT. Characterization of spontaneous, in vitro-selected, rifampin-resistant mutants of Mycobacterium tuberculosis strain H37Rv. Antimicrob Agents Chemother. 2000;44(12):3298-3301. https://doi.org/10.1128/aac.44.12.3298-3301.2000 [ Links ]
15.Xpert MTB/RIF assay product insert [homepage on the Internet]. Sunnyvale, CA: Cepheid; version 301-1404, Rev. F August 2019 [cited 2020 Sep 1]. Available from: https://www.cepheid.com/Package%20Insert%20Files/Xpert-MTB-RIF-ENGLISH-Package-Insert-301-1404-Rev-F.pdf [ Links ]
16.R Core Team. R: A language and environment for statistical computing [homepage on the Internet]. Vienna: R Foundation for Statistical Computing; c2019 [cited 2020 Sep 1]. Available from: http://www.R-project.org/ [ Links ]
17.Ondoa P, Datema T, Keita-Sow MS, et al. A new matrix for scoring the functionality of national laboratory networks in Africa: Introducing the LABNET scorecard. Afr J Lab Med. 2016;5(3):a498. https://doi.org/10.4102/ajlm.v5i3.498 [ Links ]
18.Yao K, Maruta T, Luman E, Nkengasong J. The SLMTA programme: Transforming the laboratory landscape in developing countries. Afr J Lab Med. 2014;3(2):a194. https://doi.org/10.4102/ajlm.v3i2.194 [ Links ]
19.Datema TAM, Oskam L, van Beers SM, Klatser PR. Critical review of the Stepwise Laboratory Improvement Process Towards Accreditation (SLIPTA): Suggestions for harmonization, implementation and improvement. Trop Med Int Health. 2012;17(3):361-367. https://doi.org/10.1111/j.1365-3156.2011.02917.x [ Links ]
20.Blakemore R, Story E, Helb D, et al. Evaluation of the analytical performance of the Xpert MTB/RIF assay. J Clin Microbiol. 2010;48(7):2495-2501. https://doi.org/10.1128/JCM.00128-10 [ Links ]
Correspondence:
Katherine Klein
xim0@cdc.gov
Received: 14 Jan. 2020
Accepted: 12 Aug. 2020
Published: 27 Nov. 2020
REVIEW ARTICLE
COVID-19 rapid diagnostic test could contain transmission in low- and middle-income countries
Adesola OlalekanI, II; Bamidele IwalokunII, III; Oluwabukola M. AkinloyeIV; Olayiwola PopoolaI, II; Titilola A. SamuelII, V; Oluyemi AkinloyeI, II, III
IDepartment of Medical Laboratory Science, University of Lagos, Idiaraba, Lagos, Nigeria
IICentre for Genomics of Non-Communicable Diseases and Personalized Healthcare (CGNPH), University of Lagos, Akoka, Lagos, Nigeria
IIIDepartment of Molecular Biology and Biotechnology, Nigerian Institute of Medical Research, Yaba, Lagos, Nigeria
IVDepartment of Medical Laboratory Science, Oulton College, Moncton, New Brunswick, Canada
VDepartment of Biochemistry, University of Lagos, Idiaraba, Lagos, Nigeria
ABSTRACT
BACKGROUND: Coronavirus disease 2019 (COVID-19) caused by severe acute respiratory syndrome coronavirus-2 (SARS-CoV-2) has impacted heavily on global health. Although real-time polymerase chain reaction (RT-PCR) is the current diagnostic method, challenges for low- and middle-income countries (LMICs) necessitate cheaper, higher-throughput, reliable rapid diagnostic tests (RDTs).
OBJECTIVE: We reviewed the documented performance characteristics of available COVID-19 RDTs to understand their public health utility in the ongoing pandemic, especially in resource-scarce LMIC settings.
METHODS: Using a scoping review methodology framework, common literature databases and documentary reports were searched up to 22 April 2020, irrespective of geographical location. The search terms included 'SARS-CoV-2 AND serological testing' and 'COVID-19 AND serological testing'.
RESULTS: A total of 18 RDTs produced in eight countries, namely China (6; 33.33%), the United States (4; 22.22%), Germany (2; 11.11%), Singapore (2; 11.11%), Canada, Kenya, Korea and Belgium (1 each; 5.56%), were evaluated. Reported sensitivity ranged from 18.4% to 100% (average = 84.7%), whereas specificity ranged from 90.6% to 100% (average = 95.6%). The testing time ranged from 2 min to 30 min. Of the 12 validated RDTs, the IgM/IgG duo kit with non-colloidal gold labelling system was reported to elicit the highest sensitivity (98% - 100%) and specificity (98% - 99% for IgG and 96% - 99% for IgM.
CONCLUSION: We found reports of high sensitivity and specificity among the developed RDTs that could complement RT-PCR for the detection of SARS-CoV-2 antibodies, especially for screening in LMICs. However, it is necessary to validate these kits locally.
Keywords: Coronavirus disease; COVID-19; SARS-CoV-2; rapid diagnostic test; low- and middle-income countries.
Introduction
Coronavirus disease 2019 (COVID-19) is an emerging respiratory disease that was first reported to the World Health Organization (WHO) as a cluster of pneumonia of unknown origin from Wuhan, China, in December 2019.1 The unknown causative agent was found through deep sequencing to be severe acute respiratory syndrome coronavirus-2 (SARS-CoV-2) on 7 January 2020 and the disease COVID-19 was named on 11 February 2020. In response, WHO declared COVID-19 as a Public Health Emergency of International Concern on 30 January 2020 and a pandemic on 11 March 2020.1 As of 22 April 2020, an estimated 2 572 805 confirmed cases and 178 551 confirmed deaths from COVID-19 had been reported.2 The first 10 cases in Africa were reported in five countries (Nigeria, Algeria, Morocco, Egypt and Senegal).3 Although earlier cases of COVID-19 in many low- and middle-income countries (LMICs) were described as imported by travelers from China, Italy, the United Kingdom and Germany, community transmission has now become the major cause of new COVID-19 infections.3,4 Early, rapid, large-scale diagnosis and accurate diagnosis of COVID-19 is one of the key interventions for COVID-19 containment in both high-income and LMIC settings.3 The availability of the SARS-CoV-2 genome has led to the development and validation of various reverse transcriptase real-time polymerase chain reaction (RT-PCR) in vitro diagnostic test kits by different manufacturers for COVID-19 diagnosis.5,6 This diagnostic test is based on the detection of genes encoding the envelope (E), spike (S), nucleoplasid (N), RNA-dependent RNA polymerase and open reading frame 1a/b (e.g. orf1ab, orf1a, orf1b) polyproteins within the genomic RNA of SARS-CoV-2.5,6,7 Due to lack of culture facilities, the RT-PCR method is currently the reference standard method of confirming COVID-19 diagnosis in suspected cases globally. For epidemiological investigation, public health and clinical actions, RT-PCR has been shown to be very reliable at screening and confirming the diagnosis of COVID-19 using upper respiratory (e.g. nasopharyngeal swab, oropharyngeal swab, throat swab and nasal swab) and lower respiratory (e.g. sputum and bronchioalveolar lavage) samples.7,8 Real-time PCR has also been useful for monitoring viral RNA shedding dynamics during the acute phase of the disease and viral RNA decay and disappearance during the convalescence stage of the disease among survivors.9,10 However, in spite of its high analytical sensitivity its detection range is limited to 3.2 - < 10.0 RNA copies per reaction.6,7,8 The RT-PCR method has been reported from studies done inside and outside China to also be prone to giving false negative results under certain conditions, thereby missing some COVID-19 cases. These missed cases are therefore not isolated increasing community transmission.8,9,10 These conditions include insufficient or inappropriate sample for viral RNA isolation, poor sample transportation to the laboratory, poor storage of the isolated RNA samples, poor quality of the RT-PCR assay and poor timing for sample collection. The asymptomatic phase of SARS-CoV-2 infection - the first few days post infection onset and the convalescence phase ≥ 14 days post infection onset, especially in a missed infection, have been indicated as times when cases can be missed.7,8,9,10 Poor quality RT-PCR assay is characterised by an inconsistent cycle threshold value and/or lack of amplification signal for one or two targeted genes. These missed cases are therefore not isolated increasing for SAR-CoV-2 detection.6,7,8 Also, due to limited financial resources, the limited number of accredited molecular laboratories of biosafety level 2/3 and limited number of technical experts, the scaling up of RT-PCR for COVID-19 diagnosis is limited in LMICs.7,8,9,10
Taken together, the above challenges of RT-PCR have necessitated the deployment of serological rapid diagnostic tests (RDTs) for COVID-19 diagnosis, which could identify asymptomatic and convalescent COVID-19 cases undiagnosed by RT-PCR. COVID-19 serological RDTs are antigen-antibody based tests that detects SARS-CoV-2 IgM and/or IgG in human blood samples or SARS-CoV-2 viral antigen from respiratory samples within 15 min.8,11,12 Unlike the RT-PCR protocols, serological tests require less expensive equipment, no technical expertise or electricity to run and very minimal biosafety requirements. Also, unlike RDTs that use small amounts of biological sample (10 uL - 20 uL) and have an average run time of 15 minutes, the RT-PCR protocols use large amounts of samples (150 ul - 200 ul) and have an average run time of about 90 minutes.6,7,8 These advantages of serological RDTs have attracted serious attention for their use in large-scale COVID-19 serological RDTs are antigen-antibody based tests that detects SARS-CoV-2 IgM and/or IgG in human blood samples or SARS-CoV-2 viral antigen from respiratory samples within 15 min testing especially at the peripheral level of the health system and outside hospital settings in LMICs. Data from worldmeters show that African countries compared to other countries conducted fewer tests per population (Figure 1). This lower testing power means relatively fewer cases can be detected. Thus, the rollout of various RDT kits by different manufacturers could be a favourable development particularly for LMICs as RDTs can be easily scaled up for rapid COVID-19 diagnosis.11,12 Besides, RDTs can provide additional sero-epidemiological data that will be used to determine the magnitude of COVID-19 spread within a population. RDTs achieve this by identifying active and previous symptomatic or asymptomatic cases; these data are then used to calculate case-fatality rate and determine the anti-SARS-CoV-2 immunity level of a community.11,12 However, to harness the various epidemiological and clinical usefulness of currently available COVID-19 serological RDTs, it is important to determine and/or validate their performance levels. In the present scoping review, the following research questions will be answered: (1) what are the currently available serological RDTs for testing, (2) to what extent have these serological RDTs been validated by their manufacturers and (3) what is the level of performance characteristics of these serological RDTs? Presently, the level of accuracy of many serological RDTs available for use in LMICs remains unclear, coupled with insufficient information about their strengths and limitations. This review will provide insight into the performance characteristics of these kits and enable evidenced-based decisions for their possible use in large-scale COVID-19 testing and containment strategies in LMICs.

Methodology and data analysis
A scoping review was conducted using a methodology framework by Arksey13 with modification as described by Adhikari et al.14 This includes: (1) identifying a clear research objective and search strategies, (2) identifying relevant research articles, (3) selecting research articles, (4) extracting and charting of data, and (5) summarising, discussing, analysing and reporting the results. The online databases searched included Google Scholar, medRxiv, bioRxiv and PubMed, as well as documentary reports and white paper publications from relevant online websites including WHO, the United States Centers for Disease Control and Prevention (CDC) and the Nigeria Centre for Disease Control (NCDC) for information on new RDTs for COVID-19 published up to 22 April 2020. The search terms used include 'SARS-CoV-2 AND testing', 'COVID-19 AND rapid test' and 'COVID-19 AND diagnostic kits'. Diagnostic kits published for the confirmation of other coronaviruses, such as the coronavirus associated with the 2003 SARS outbreak in Asia and Middle East respiratory syndrome-coronavirus, were excluded. All the members of the review teams were involved in paper search and selection and a consensus was reached through peer review. Duplicated publications and those with insufficient information were removed. The extracted data included the name of the diagnostic kit, manufacturer, test performance based on sensitivity, specificity, predictive positive and negative values, test principles and special characteristics and testing time. The data were entered into Excel (Microsoft, Redmond, Washington, United States) and exported to Statistical Product and Service Solution version 23 (IBM SPSS Inc., Chicago, Illinois, United States) for cleaning and analysis.
Review findings
Overall, 28 publications on coronavirus-based diagnostic kits that matched the goal of this publication were included in this study (Figure 2). Articles were excluded based on duplication and lack of information on detection principle, type of kit, performance characteristics and manufacturers' details. All eligible publications on COVID-19 diagnostic kits by country and performance as of 22 April 2020 were summarised in numbers and percentages using descriptive analysis. On the whole, a total of 18 serological RDT kits were included for analysis. Of these, four were antigen RDTs (22.2%), nine were total immunoglobulin RDTs (50%) and five were IgM/IgG serological RDTs (27.8%) (Figure 3). These kits were produced in eight countries, namely China (6; 33.33%), the United States (4; 22.22%), Germany (2; 11.11%), Singapore (2; 11.11%) and Kenya, Canada, Korea and Belgium (1 each; 6.56%) (Table 1). Fourteen of the RDT kits are antibody-detection kits for use with blood, plasma or serum (77.8%), and four were antigen-detection kits for use with swab, sputum or blood (22.2%). The majority of these kits (13; 72.22%) use lateral flow membrane technology, whereas the remaining five (27.78%) use colloidal gold (Figure 4).



In general, the sensitivity of the test kits irrespective of sample specification ranged from 18.4% to 100% and their specificity ranged from 90.6% to 100%. The pooled analysis revealed an average (range) sensitivity of 81.6% (72.9% - 88%) and specificity of 94.4% (88.2% - 97.5%). The sensitivity and specificity of lateral flow immunoassay membrane type RDT kits were in the range (average) of 84.4% - 100% (92.7%) and 90.6% - 100% (96%), respectively, and that of lateral flow immunoassay colloidal gold type were 18.4 - 99.1% (67.7%) and 91.7% - 100% (98.3%), respectively (Figure 4). Three of these kits, namely Bodysphere Rapid Test (Los Angeles, California, United States), Thermogenesis Rapid COVID-19 Test kit (Rancho Cordova, California, United States) and NADAL® COVID-19 Test kit (Regensburg, Germany), had a sensitivity of 99% - 100%. These three kits also had a specificity range of 91% - 100%. Asides their better sensitivity and specificity compared to other RDTs, these kits are for use with blood samples only, detect both IgG and IgM, and have shorter testing time of 2 - 10 min. The testing time for all the identified kits ranged from 2 to 30 min with an average testing time of 13.5 min (95% confidence interval = 10.8 min - 16.1 min). Only two of the kits provided information on positive predicted value and negative predictive value (range = 87.5% - 100.0% to 26.2% - 96.2%).
Out of the 18 RDTs identified, 6 (33%) were not subjected to performance validation by the manufacturers of the kits. Two of four antigen detection kits, seven of nine total immunoglobulin and three of five IgM + IgG serological kits were validated for sensitivity and specificity using RT-PCR assay as the reference method (Table 1).15 On the whole, eight of the 13 lateral flow immunoassay membrane type and four of the five lateral flow immunoassay colloidal gold type kits were validated. Of the 12 serological RDTs validated by RT-PCR, the IgM/IgG duo kit with non-colloidal gold labelling system was found to elicit the highest and acceptable sensitivity (98% - 100%) and specificity (98% - 99%) values for IgG and specificity of 96% - 99% for IgM compared to other RDT types and the counterpart colloidal gold system-based IgM/IgG duo kit (Figure 5).

Implications and recommendations
The need to expand diagnostic testing in order to cope with the current spread of COVID-19 infection in many settings in LMICs where resources for RT-PCR are limited and difficult to sustain has made RDT kits for SARS-CoV-2 an important tool in the global fight against the COVID-19 pandemic. For patients with suspected infection, RT-PCR is used to detect SARS-CoV-2 in sputum, throat and nasopharyngeal swab, and secretions of the lower respiratory tract samples such as bronchoalveolar lavage and bronchial washings.16,17,18 However, limited facilities and human resources for molecular testing using RT-PCR tends to slow down testing for COVID-19 in resource-limited countries. It has been argued that RDTs do not have sufficient evidence to support their use in the COVID-19 pandemic and hence should be used only in a research setting.19 Cassaniti et al. have earlier reported low sensitivity and specificity of serological assay which led to misdiagnosis of COVID-19 in the vast majority of the patients in their study population.20 The WHO has emphasised that tests with inadequate quality may miss patients with active infection or falsely categorise patients as having the disease, further hampering disease control efforts, hence the need for questioning the performance of SARS-CoV-2 RDT kits.19,21 Most manufacturers of the RDTs have performance characteristics of the kits validated using the RT-PCR technique as the reference method. However, several publications have reported the possibility of false-negative results using RT-PCR.22 Thus, the sensitivity and specificity data of reviewed kits should be understood in light of this bias.
The declaration of COVID-19 as a global pandemic and the huge concern of its transmission in LMICs where HIV, tuberculosis and malaria are currently endemic have necessitated the need to scale up diagnostic testing to mitigate further spread and the rising number of COVID-19 deaths outside China.23,24 In many settings in LMICs, such as small communities, riverine areas, health posts and primary health centres, resources for RT-PCR are absent.23,24 This has made the development of serological RDTs for the detection of specific SARS-CoV-2 antigens, anti-SARS-CoV-2 IgM and anti-SARS-CoV-2 IgG an attractive and very important tool in the global fight against the COVID-19 pandemic in LMICs. Findings from the 18 serological RDT kits analysed in this review imply that three different types of serological RDTs, antigen, total immunoglobulin, and combined IgM and IgG-based RDT with the ability to provide results between 2 min and 30 min are currently available for potential large-scale testing in LMICs using five types of biological samples (nasopharyngeal swab, throat swab, whole blood, plasma and serum). Due to challenges associated with more sensitive biological samples such as bronchoalveolar lavage and sputum, both nasopharyngeal and throat swabs are used for COVID-19 testing by RT-PCR in many settings.7,8,9 Also, whole blood, plasma or serum is often used as biological sample for RT-PCR for monitoring viremia to predict COVID-19 severity during the acute stage of infection and viral clearance during the convalescent stage.7,8 The latter is currently used to inform hospital discharge decisions in many countries; use of different samples for diagnosis and viral clearance determination can negatively impact on discharge decision-making.8,9,10,12 A potential way of circumventing discharge decision errors is to employ a diagnostic tool that uses the same type of sample for both diagnosis and viraemia monitoring such as the SARS-CoV-2 antigen and specific anti-SARS-CoV-2 IgM/IgG duo detection kit identified in this review. This can be integrated into the local COVID-19 management guidelines in LMICs. This guideline is currently being used in Malaysia and Europe.25,26 The primary weakness of RT-PCR for COVID-19 diagnosis lies in its inability to detect infection using nasopharyngeal samples collected outside the viral RNA shedding period. The shedding period is characterised by presence of low viral RNA, such as seen in asymptomatic, pre-symptom days (~2 days prior to symptom onset) and post-infection days (~14 post infection onset).26,27 Also, the RT-PCR, may also miss infections due to poor sample collection and preparation as well as poor storage of isolated RNA. These weaknesses can be addressed by serological RDTs, which detect the more stable viral immunogenic proteins such as the S and N proteins, which persist more than RNA or anti-SARS-CoV-2 IgM and IgG which have been reported to peak between 2 and 3 weeks and 17 days post infection onset.26,27 Guo et al.28 reported an improvement of COVID-19 identification by RT-PCR from 51.9% to 98.6% with the integration of an IgM-based immunoassay. However, the results of sensitivity (18.4% - 100%) and specificity (90.6% - 100.0%) reported for 12 of the 18 reviewed serological RDT kits by their manufacturers imply that the currently available COVID-19 RDTs are not equally accurate and only a few of them pass the sensitivity and specificity benchmark of 95%. Zainol et al.29 recently reported a sensitivity range of 72.7% - 100.0% and specificity range of 98.7% - 100.0% for IgM/IgG duo-based serological RDT kits for COVID-19 in their review in which nine serological kits were analysed. The authors also reported a sensitivity range of 86.4% - 90.6% and a specificity of 99% for total immunoglobulin-based RDTs. In Brazil, Castro et al.30 reported a mean (range) anti-SARS-CoV-2 IgM sensitivity of 82% (76% - 87%) and specificity of 97% (96% - 98%) and anti-SARS-CoV-2 IgG sensitivity of 97% (90% - 99%) and specificity of 98% (97% - 99%). Although in this review, only 5 of the 18 serological RDT kits offered combined IgM and IgG detection, we also found a better performance characteristic for this type of RDT kit compared to the antigen and total immunoglobulin kits using non-colloidal gold labelling system with acceptable sensitivity (98% - 100%) and a specificity (98% - 99%) values for IgG and specificity of 96% - 99% for IgM, suggesting the ability of these kits to detect past infections, confirm true negative results and rule out false positive COVID-19 testing results by RT-PCR. However, the performance of these kits to confirm recent infections seems to be below the benchmark of 95%, since they had a sensitivity range of 85% - 94%, which was even lower for colloidal gold labelling systems at 57.1%. Meanwhile, the improvement offered by the antigen-based RDT kits in this review can be said to be none or marginal at 84.4% - 96%. Another implication of these findings is that more than one serological RDT kit may be needed for a SARS-CoV-2 detection algorithm to improve confirmation and diagnosis of COVID-19 by RT-PCR, if deployed in LMICs. It is also important to note that 6 of the 18 reviewed serological RDT kits lacked reports on sensitivity and specificity, thus the accuracy in diagnosising COVID-19 is unknown as at the time of this review. This finding further reiterates the difficulty associated with SARS-CoV-2 serological RDT kit validation by manufacturers, since RT-PCR the reference method targets viral RNA instead of specific SARS-CoV-2 antibodies or antigens. A similar opinion has been shared by Castrol et al.,30 given the well-documented differences in the kinetics of the viral RNA (even between samples) and anti-SARS-CoV-2 antibodies in infected individuals.
As of 01 April 2020, the death toll for COVID-19 was over a million globally and the need for accurate intervention to stop transmission and re-infection of COVID-19 is now extremely necessary. The WHO advises countries to improve the rate of testing to identify an infected individual for appropriate isolation and treatment. The availability of efficient and rapid diagnostics for COVID-19 has been indicated as one of the mitigation strategies to control the pandemic. Rapid diagnostic tests are cheaper and more readily available; thus, they might be more useful stopping transmission by rapidly identifying positive and previous cases particularly in LMICs. These data will in turn be useful for both disease diagnosis and surveillance. The RDT will either detect the presence of viral proteins (antigens) expressed by the COVID-19 virus or the presence of antibodies in the blood of COVID-19-infected people.31,32 The performance of the kits has been shown to depend on several factors such as the onset of illness, the viral load in the specimen, the integrity of the specimen collected from suspected cases, processing, age, nutritional status, the severity of the disease, and certain medications or underlying disease condition, especially immune suppression diseases and the precise formulation of the reagents in the test kits.19
The LMICs reported the lowest rate of testing per population with corresponding lower numbers of cases compared with developed countries. This may be an indication of limited testing resources and facilities due to the challenges associated with RT-PCR. Therefore, there may be several cases in this population that are not detected with antecedent clinical implications. The use of RDTs will not only help to detect currently infected or previously exposed individuals who have developed immunity as well as identify asymptomatic carriers. These will inform decisions for public health measures, for example, cases among a more IgM-positive population may be an indication of a subclinical outbreak. The economic impact of movement restrictions and lockdowns in many of these countries is not well managed, adding unimaginable suffering in an already impoverished population. The use of RDTs for the screening of COVID-19 may help to determine individuals who are at lower risk and may be permitted to go back to work. When coupled with clinical symptoms and molecular testing, RDTs may serve as a first-line tool for diagnosis and help to better understand the spread of diseases.
Although the COVID-19 test kit market is in its infancy, the global COVID-19 outbreak and up-surging cases are driving the demand for RDTs, hence researchers throughout the world are striving to develop RDTs to track infected people. To date, very few countries have succeeded in developing SARS-CoV-2 testing kits, while some are still working on improving the performance of their products. With the dedicated global efforts on preventing the spread of COVID-19 and flattening the curve, significant improvement must have occurred in improving the performance of COVID-19 test kits. Increasing accessibility to testing among other interventions has improved the containment and transmission of the infection. While algorithms have been developed to limit testing to individuals that fulfil certain criteria, such as contact with the infected patients, clinical symptoms of COVID-19, travelling history to epidemic countries, etc., testing the entire population has been recommended.33 Resource limitations means most LMICs can not cope with the up-surge of infection and transmission. While testing per population is high in developed countries with over 3 million tested in the United States, testing per population is still very low in developing countries with less than 10 000 tested in Nigeria as of 22 April 2020. Therefore, the addition of validated serological-based RDT even with lower performance characteristics compared to RT-PCR may serve as complementary tools to increase the rate of testing per population, especially in LMICs where community transmission is now on the rise. Therefore, the use of RDTs operated as lateral flow immunochromatographic assays to detect both IgM and IgG on separate test lines using whole blood, plasma or serum samples is desirable for LMICs. Wang et al. reported that the combination of RT-PCR testing and clinical features for diagnosis of COVID-19 facilitated the management of the SARS-CoV-2 outbreak in China,22 and COVID-19 mass testing facilities have been strongly advocated to end the epidemic rapidly.34 The use of RDT will not only allow mass testing facilities in LMICs but coupled with clinical features in symptomatic patients and molecular testing (RT-PCR) in asymptomatic populations may help to contain transmission in LMICs.
Conclusion
Considering the peculiarity of LMICs, especially their economic situation, the standard RT-PCR may not be able to cope with the testing needs of these countries because of limited infrastructure and human resources. Generally, it is agreed that rapid testing techniques are useful for screening for early detection of symptomatic cases, which is crucial for averting community or hospital transmission and strengthening contact tracing and active surveillance. This review revealed considerable good performance of the RDT with manufacturer sensitivity and specificity using varieties of samples including blood samples. Hence, the use of RDT kits in LMICs may increase access to testing and better triaging of COVID-19 patients. We, however, identified that most of the proposed rapid kits have not been optimised and validated. It is important that the kits undergo further validation with samples from countries of proposed use in reference to RT-PCR before use.
Acknowledgements
Competing interests
The authors have declared that no competing interest exists.
Authors' contributions
O.A. conceived the idea for the study. O.A., B.I., and A.O. designed the study. A.O., T.A.S., O.M.A. and O.P. searched for published work. O.A. and B.I. reviewed and made the selection of eligible studies. A.O., T.A.S., O.M.A. and O.P. extracted and compiled the data. O.A., B.I. and A.O. analysed the data while B.I. and A.O. prepared the first draft of the article. O.A. did the final editing of the article. All authors contributed to the writing of the article and have seen and approved the final version.
Ethical considerations
Ethical clearance was not required for this study.
Funding information
This research received no specific grant from any funding agency in the public, commercial or not-for-profit sectors.
Data availability statement
Data sharing is not applicable to this article as no new data were created or analysed in this study.
Disclaimer
The views and opinions expressed in this article are those of the authors and do not necessarily reflect the official policy or position of any affiliated agency of the authors.
References
1.Zhu N, Zhang D, Wang W, et al. A novel coronavirus from patients with pneumonia in China, 2019. N Engl J Med. 2020;382(8):727-733. https://doi.org/10.1056/NEJMoa2001017 [ Links ]
2.Dong E, Du H, Gardner L. An interactive web-based dashboard to track COVID-19 in real time. Lancet Infect Dis. 2020;20(5):533-534. https://doi.org/10.1016/S1473-3099(20)30120-1 [ Links ]
3.Nkengasong JN, Mankoula W. Looming threat of COVID-19 infection in Africa: Act collectively, and fast. Lancet (London, England). 2020;395(10227):841-842. https://doi.org/10.1016/S0140-6736(20)30464-5 [ Links ]
4.Khadka S, Hashmi FK, Usman M. Preventing COVID-19 in low- and middle-income countries. Drugs Ther Perspect. 2020:1-3. https://doi.org/10.1007/s40267-020-00728-8 [ Links ]
5.Wang X, Yao H, Xu X, et al. Limits of detection of six approved RT-PCR kits for the novel SARS-coronavirus-2 (SARS-CoV-2). Clin Chem. 2020;66(7):977-979. https://doi.org/10.1093/clinchem/hvaa099 [ Links ]
6.Chan JF, Yip CC, To KK, et al. Improved molecular diagnosis of COVID-19 by the novel, highly sensitive and specific COVID-19-RdRp/Hel real-time reverse transcription-PCR assay validated in vitro and with clinical specimens. J Clin Microbiol. 2020;58(5):e00310-e00320. https://doi.org/10.1128/JCM.00310-20 [ Links ]
7.Loeffelholz MJ, Tang Y-W. Laboratory diagnosis of emerging human coronavirus infections - The state of the art. Emerg Microb Infect. 2020;9(1):747-756. https://doi.org/10.1080/22221751.2020.1745095 [ Links ]
8.Arevalo-Rodriguez I, Buitrago-Garcia D, Simancas-Racines D, et al. False-negative results of initial RT-PCR assays for COVID-19: A systematic review. medRxiv. 2020:2020.04.16.20066787. https://doi.org/10.1101/2020.04 [ Links ]
9.Younes N, Al-Sadeq DW, Al-Jighefee H, et al. Challenges in laboratory diagnosis of the novel coronavirus SARS-CoV-2. Viruses. 2020;12(6):582. https://doi.org/10.3390/v12060582 [ Links ]
10.Zhong L, Chuan J, Gong B, et al. Detection of serum IgM and IgG for COVID-19 diagnosis. Sci China Life Sci. 2020;63(5):777-780. https://doi.org/10.1007/s11427-020-1688-9 [ Links ]
11.Haveri A, Smura T, Kuivanen S, et al. Serological and molecular findings during SARS-CoV-2 infection: The first case study in Finland, January to February 2020. Euro Surveill. 2020;25(11):2000266. https://doi.org/10.2807/1560-7917.ES.2020.25.11.2000266 [ Links ]
12.Patel R, Babady E, Theel ES, et al. Report from the American Society for Microbiology COVID-19 international summit, 23 March 2020: Value of diagnostic testing for SARS-CoV-2/COVID-19. mBio. 2020;11(2):e00722-20. https://doi.org/10.1128/mBio.00722-20 [ Links ]
13.Arksey H, O'Malley L. Scoping studies: Towards a methodological framework. Int J Soc Res Methodol. 2005;8(1):19-32. https://doi.org/10.1080/1364557032000119616 [ Links ]
14.Adhikari SP, Meng S, Wu YJ, et al. Epidemiology, causes, clinical manifestation and diagnosis, prevention and control of coronavirus disease (COVID-19) during the early outbreak period: A scoping review. Infect Dis Poverty. 2020;9(1):020-00646. https://doi.org/10.1186/s40249-020-00646-x [ Links ]
15.Tahamtan A, Ardebili A. Real-time RT-PCR in COVID-19 detection: Issues affecting the results. Expert Rev Mol Diagn. 2020;20(5):453-454. https://doi.org/10.1080/14737159.2020.1757437 [ Links ]
16.Zhao J, Yuan Q, Wang H, et al. Antibody responses to SARS-CoV-2 in patients of novel coronavirus disease 2019. Clin Infect Dis. 2020;ciaa344. https://doi.org/101093/cid/ciaa344 [ Links ]
17.Okba NMA, Muller MA, Li W, et al. SARS-CoV-2 specific antibody responses in COVID-19 patients. medRxiv. 2020:2020.03.18.20038059. [ Links ]
18.Gorse GJ, Donovan MM, Patel GB. Antibodies to coronaviruses are higher in older compared with younger adults and binding antibodies are more sensitive than neutralizing antibodies in identifying coronavirus-associated illnesses. J Med Virol. 2020;92(5):512-517. https://doi.org/10.1002/jmv.25715 [ Links ]
19.WHO. Advice on the use of point-of-care immunodiagnostic tests for COVID-19 [homepage on the Internet]. Scientific Brief 8 April 2020 [cited 2020 Apr 08]. Available from: WHO/2019-nCoV/Sci_Brief/POC_immunodiagnostics/20201 [ Links ]
20.Cassaniti I, Novazzi F, Giardina F, et al. Performance of VivaDiag COVID-19 IgM/IgG Rapid Test is inadequate for diagnosis of COVID-19 in acute patients referring to emergency room department. J Med Virol. 2020 Mar 30. https://doi.org/10.1002/jmv.25800 [ Links ]
21.WHO. Coronavirus disease (COVID-19) technical guidance: Laboratory testing for 2019-nCoV in humans [homepage on the Internet]. [cited 2020 Apr 08]. Available from: www.who.int; [cited 2020 Apr 06]. [ Links ]
22.Wang Y, Kang H, Liu X, Tong Z. Combination of RT-qPCR testing and clinical features for diagnosis of COVID-19 facilitates management of SARS-CoV-2 outbreak. J Med Virol. 2020;92(6):538-539. [ Links ]
23.Stackelberg O, Esmaeilzadeh M, Olsen B, Lundkvist Å. [Rapid point-of-care serology testing for sars-cov-2]. Lakartidningen, Stockholm. 2020;117. [ Links ]
24.Malaysia MoH. Guidelines on COVID-19 management in Malaysia. 5th ed. The Ministry of Health Malaysia: Putrajaya; 2020. [ Links ]
25.Control. ECfDPa. Novel coronavirus (SARS-CoV-2) discharge criteria for confirmed COVID-19 cases - When is it safe to discharge COVID-19 cases from the hospital or end home isolation? [homepage on the Internet]. [cited 2020 Apr 10]. Available from: https://www.ecdceuropaeu/sites/default/files/documents/COVID-19-Discharge-criteria.pdf [ Links ]
26.Chan PK, Ng KC, Chan RC, et al. Immunofluorescence assay for serologic diagnosis of SARS. Emerg Infect Dis. 2004;10(3):530-532. https://doi.org/10.3201/eid1003.030493 [ Links ]
27.Lee CY, Lin RTP, Renia L, Ng LFP. Serological approaches for COVID-19: Epidemiologic perspective on surveillance and control. Front Immunol. 2020;11:879. https://doi.org/10.3389/fimmu.2020.00879 [ Links ]
28.Guo L, Ren L, Yang S, et al. Profiling early humoral response to diagnose novel coronavirus disease (COVID-19). Clin Infect Dis. 2020;71(15):778-785. https://doi.org/10.1093/cid/ciaa310 [ Links ]
29.Zainol Rashid Z, Othman SN, Abdul Samat MN, Ali UK, Wong KK. Diagnostic performance of COVID-19 serology assays. Malaysian J Pathol. 2020;42(1):13-21. [ Links ]
30.Castro R, Luz PM, Wakimoto MD, Veloso VG, Grinsztejn B, Perazzo H. COVID-19: A meta-analysis of diagnostic test accuracy of commercial assays registered in Brazil. Braz J Infect Dis. 2020;24(2):180-187. https://doi.org/10.1016/j.bjid.2020.04.003 [ Links ]
31.Zhang P, Gao Q, Wang T, et al. Evaluation of recombinant nucleocapsid and spike proteins for serological diagnosis of novel coronavirus disease 2019 (COVID-19). medRxiv. 2020:2020.03.17.20036954. https://doi.org/10.1101/2020.03.17.20036954 [ Links ]
32.Liu Y, Liu Y, Diao B, et al. Diagnostic indexes of a rapid IgG/IgM combined antibody test for SARS-CoV-2. medRxiv. 2020:2020.03.26.20044883. https://doi.org/10.1101/2020.03.26.20044883 [ Links ]
33.Julian P. Covid-19 mass testing facilities could end the epidemic rapidly. BMJ. 2020;368:m1163. https://doi.org/10.1136/bmj.m1163 [ Links ]
34.Bioconcept C. Covid-19 Ag resp-strip [homepage on the Internet]. 2020 [cited 2020 Apr 29]. Available from: https://www.corisbiocom/Products/Human-Field/Covid-19.php [ Links ]
35.(KEMRI) KMRI. Covid-19 results in 15 minutes: KEMRI starts manufacturing rapid test kits, Kenya Medical Research Institute (KEMRI) has started manufacturing Covid-19 rapid test kits to ease the testing burden at the State's facilities [homepage on the Internet]. 2020 [cited 2020 Apr 07]. Available from: www.standardmediacoke/article/2001367222/kemri-starts-manufacturing-covid-19-rapid-test-kits [ Links ]
36.Cassette CC-II. Singapore's Camtech, JN Medsys to increase production of COVID-19 test kits. 2020 [homepage on the Internet]. [cited 2020 Apr 16]. Available from: https://www.mobihealthnewscom/news/asia-pacific/singapore-s-camtech-jn-medsys-increase-production-covid-19-test-kits [ Links ]
37.Biosensor S. Standard Q COVID-19 Ag [homepage on the Internet]. 2020 [cited 2020 Apr 10]. Available from: http://www.sdbiosensorcom/xe/product/7672 [ Links ]
38.EUA BEua. Bodysphere touts 2-minute COVID-19 test [homepage on the Internet]. 2020 [cited 2020 Apr 02] Available from: https://www.massdevicecom/fda-clears-bodysphere-2-minute-covid-19-test/ [ Links ]
39.Diagnostics OC. Ortho clinical diagnostics pick up EUA for COVID-19 total antibody assay [homepage on the Internet]. 2020 [cited 2020 Apr 15]. Available from: www.middionlinecom/ortho-clinical-diagnosics-picks-eva-covid-19-total-antibody-assay [ Links ]
40.Li Z, Yi Y, Luo X, et al. Development and clinical application of a rapid IgM-IgG combined antibody test for SARS-CoV-2 infection diagnosis. J Med Virol. 2020. https://doi.org/10.1002/jmv.25727 [ Links ]
41.Fellmann F. Jetzt beginnt die Suche nach den Genesenen. Tages Anzeiger. Euroimmun Medical Laboratory Diagnostics and Epitope Diagnostics; Germany: Lubeck. 2020. [ Links ]
42.Liu R, Liu X, Han H, et al. The comparative superiority of IgM-IgG antibody test to real-time reverse transcriptase PCR detection for SARS-CoV-2 infection diagnosis. preprints from medRxiv and bioRxiv. 2020. https://doi.org/10.1101/2020.03.28.20045765 [ Links ]
43.Artronlab. One step novel coronavirus (COVID-19) IgM/IgG antibody test kit [homepage on the Internet]. 2020. Available from: http://www.artronlabcom/products/CoVBrochure-ver2.pdf [ Links ]
44.Xiang J, Yan M, Li H, et al. Evaluation of enzyme-linked immunoassay and colloidal gold- immunochromatographic assay kit for detection of novel coronavirus (SARS-Cov-2) causing an outbreak of pneumonia (COVID-19). Pre print medRxiv preprint https://doi.org/101101/202002272002878 [ Links ]
45.Thermogenesis. A rapid covid-19 IgM/IgG serological test for point-of-care [homepage on the Internet]. [cited 2020 Apr 09]. Available from: https://www.thermogenesiscom/rapid-covid-19-point-of-care-diagnostic-test/ [ Links ]
46.Cassette AT-nIIRT. 2019-nCoV IgG/IgM rapid test cassette [homepge on the Internet]. 2020 [cited 2020 Feb 18]. Available from: https://www.assaygeniecom/content/Assay%20Genie%20Rapid%20COVID%20POC%20test.pdf [ Links ]
47.BD BTw. BioMedomics teams with BD to launch rapid COVID-19 test [homepage on the Internet]. [cited 2020 Apr 06]. Available from: https://www.ncbiotechorg/news/biomedomics-teams-bd-launch-rapid-covid-19-test [ Links ]
48.kit TbTC-. NADALR COVID-19 IgG/IgM test instruction manure [homepage on the Internet]. 2020 [cited 2020 Apr 20]. Available from: https://www.dailymailcouk/news/article-8128327/Test-test-Covid-kits-10-minute-finger-prick-tests-mask-diagnose-instantly.html [ Links ]
Correspondence:
Oluyemi Akinloye
oakinloye@unilag.edu.ng
Received: 26 Apr. 2020
Accepted: 07 Aug. 2020
Published: 30 Sept. 2020
OPINION PAPER
COVID-19 pandemic and antimicrobial resistance: Another call to strengthen laboratory diagnostic capacity in Africa
Beverly EgyirI; Noah Obeng-NkrumahII; George B. KyeiIII
IBacteriology Department, Noguchi Memorial Institute for Medical Research, University of Ghana, Accra, Ghana
IIDepartment of Medical Laboratory Sciences, University of Ghana, Accra, Ghana
IIIVirology Department, Noguchi Memorial Institute for Medical Research, University of Ghana, Accra, Ghana
Introduction
The coronavirus disease 2019 (COVID-19) pandemic caused by the severe acute respiratory syndrome coronavirus 2 (SARS-CoV-2) resulted in 7 145 539 confirmed cases and 408 025 deaths by 03 June 2020.1 Understandably, almost all attention has been on COVID-19, which continues to take lives and stretch healthcare systems around the world. A critical issue receiving much less attention during this pandemic is the effect it could have on antimicrobial resistance (AMR). With no proven therapy for COVID-19, prescribers are more likely to use antibiotics indiscriminately for treatment and prevention of presumed bacterial co-infections. In high-income settings, where bacterial cultures can be done on a timely basis, such antibiotic regimens can be stopped within 48 hours. However, in Africa, unneeded empiric antibiotic regimens are likely to be continued for a longer period of time due to lack of bacterial culture and antimicrobial susceptibility testing (AST) capabilities. In addition, the widespread use of hand sanitizers and antimicrobial soaps could exacerbate AMR among healthcare workers and the general population. In this article, we discuss how the COVID-19 pandemic could affect the already precarious AMR situation in Africa and discuss ways to minimise the effects on public health.
Antimicrobial resistance, a global menace
Antimicrobial resistance occurs when microbes change and render antimicrobial agents ineffective. This phenomenon is fuelled by overuse and misuse of antimicrobial agents in humans and animals. Antimicrobial resistance leads to treatment failures, prolongs hospital stays, worsens clinical outcomes and makes surgical procedures and chemotherapy risky and unsafe. With increasing antibiotic resistance and few new antimicrobial agents in the production pipeline, it is imperative to monitor the epidemiology of bacteria species, especially respiratory pathogens to inform treatment decisions2,3 in the era of COVID-19. It has been estimated that AMR could lead to 10 million deaths by 2050 if nothing is done about the menace, and most of the deaths are likely to occur in Asia and Africa.4 Actions such as infection prevention and control, antibiotic stewardships, capacity building (laboratory infrastructure and personnel) and surveillance are necessary to ameliorate the impact of AMR. To support a global action plan on AMR, the World Health Organization has developed the Global Antimicrobial Resistance Surveillance System to provide a standardised approach for collection, analysis and sharing of data related to AMR to inform decision-making at national and international levels; surveillance of AMR bacteria in humans and animals across the globe is key in tackling the problem of AMR.5 Unfortunately, this is hampered by the limited data from Africa due to limited diagnostic microbiology infrastructure on the continent.6
Coronavirus disease 2019, secondary bacterial infection and antimicrobial resistance
Viral respiratory infections can be complicated with secondary bacterial infections, commonly with Streptococcus pneumoniae, Haemophilus influenzae and Staphylococcus aureus, resulting in increased severity and mortality.7 The majority of deaths from the 1918 influenza pandemic resulted from secondary bacterial infections.8 During the 2009 swine influenza pandemic, there was an increase in hospital pneumonia cases as a result of secondary bacterial pneumonia, which resulted in 29% - 55% of deaths.9 In a recent study on the outcome of COVID-19 patients from the Wuhan region of China, half of the non-survivors had secondary infections.10 Of note, the majority (95%) of the patients in the study were given antibiotics.10
Azithromycin, a broad-spectrum macrolide antibiotic (in combination with hydroxychloroquine) has become a common treatment for COVID-19 patients in several parts of the world including Africa11,12 without much evidence to support its use. It is worth noting that the World Health Organization has warned against indiscriminate use of antibiotics during COVID-19 treatment.2
While antibiotics may not affect COVID-19 directly, they are agents administered to prevent or treat secondary bacterial infections in COVID-19 patients. Therefore, the swell in the numbers of COVID-19 patients could lead to the inappropriate use of antibiotics and subsequent selection of AMR bacteria. In previous epidemics, there were indications of an increase in methicillin resistant S. aureus infections in hospitals, which was linked to heavy use of antimicrobial agents.13,14 It is therefore possible that COVID-19 patients could also be battling with AMR bacteria, in addition to the virus, resulting in poor patient outcomes. Urgent studies are needed to define the bacteria aetiologies and AMR bacteria that contribute most to mortality in COVID-19 patients.
Coronavirus disease 2019, the environment and antimicrobial resistance
From the onset of the pandemic, the general public has been constantly directed to regularly wash hands with soap and water, and use hand sanitizers. Although such practices will help improve hygiene standards and reduce the spread of COVID-19, they could have negative effects on AMR. Disinfectants and antimicrobial soaps contain biocides or antimicrobials. An increase in use of these agents may lead to an increase in their concentration in waste water and receiving water bodies; this may have a potentially negative impact, because the elevated concentrations may lead to selection of AMR bacteria, posing a health risk to persons exposed to such environments.15 More research in Africa is needed to determine how the widespread use of antimicrobial sanitizers and soaps affects the microbiome and contributes to AMR.
Antimicrobial resistance in Africa in the era of coronavirus disease 2019
The World Health Organization reports that there is limited data on AMR prevalence from Africa due to limited laboratory capacity and surveillance networks.6,16 A survey indicated that very few countries in Africa have functional national surveillance systems for AMR of common bacterial infections from community and hospitalised patients.17 An external quality assessment report indicated poor performance of AST in several African countries.18 Quality assurance in AST is key for reporting and implementation of the Global Antimicrobial Resistance Surveillance System19; laboratories in Africa have to be supported with the needed investments for better performance.
With the paucity of data on AMR, realistic evidence on how AMR may compromise first-line empirical treatment in common bacterial infections is lacking on the continent.16 In the absence of microbiology and AMR data, prescribers often manage clinical symptoms rather than specific bacteria,16 a situation that may fuel inappropriate use of antimicrobials and emergence of resistant microbes.
In Ghana, like most African countries, the majority of microbiology laboratories do not have the capacity to perform culture and AST tests.20 For the few laboratories that are able to do culture and AST, performing such tests in a standard way is a challenge often due to a lack of reference strains and up-to-date standard interpretation guidelines. In addition, culture of bacteria and AST are often not requested by clinicians, because of cost to patients and the long turn-around time that often render the results useless for patient care. Altogether, data on AMR bacteria to guide treatment decisions at local and national levels are scarce. Newman et al.20 conducted the first nationwide AMR surveillance in Ghana between 2002 and 2003 and found bacteria species resistant to ceftriaxone (6.3%) and ciprofloxacin (11%).21 Opintan et al. (2015), followed up with another nationwide survey between June 2014 and November 2014 and observed that > 50% of the commonly isolated bacteria species were resistant to third-generation cephalosporins and fluoroquinolones. In this study, the majority of the Gram-negative bacteria species recovered were positive for extended spectrum beta lactamase; these organisms are resistant to a wide range of antimicrobial agents.22
In another study, a New Delhi metallo-beta-lactamase-producing Escherichia coli strain resistant to meropenem and belonging to ST410 was detected in a urine sample from a hospitalised patient in the northern part of Ghana. In this first report, the detected plasmid co-carried other resistance genes.23 This is disturbing, mainly because these organisms are resistant to the antimicrobials used as last-line treatment for severe bacterial infections.24
Among female patients who presented with vaginal discharge, dysuria, intermenstrual bleeding or abdominal pain and men who presented with urethral discharge or dysuria, gonococcal isolates recovered from samples collected from five healthcare centres were resistant to tetracycline (100%), benzylpenicillin (91%) and ciprofloxacin (82%). One isolate resistant to cefixime (MIC: 0.75 µg/ml) belonged to ST1407, a pandemic resistant clone.25
A total of 520 methicillin susceptible S. aureus and 30 methicillin resistant S. aureus isolates were recovered from 1219 nasal swabs (community and hospital carriers) and 916 clinical isolates (blood, skin and soft tissues, wounds) in other studies; methicillin resistant S. aureus isolates detected belonged to global epidemic clones, including USA300.26,27,28,29
Our review of more than 20 articles on AMR from Ghana for this write-up revealed that resistance of bacteria species (recovered from human, food and animals) to commonly used antimicrobial agents such as ampicillin, tetracycline, chloramphenicol and trimethoprim sulfamethoxazole was common. The situation is not different from other parts of the continent.16 The majority of AMR data in Ghana are from pockets of studies focusing on particular bacteria species recovered in select hospitals or research institutions. They therefore may not reflect the national AMR situation and could be an underestimation of the actual magnitude of the AMR problem in a country where self-medication is rampant and antimicrobial agents are often available without prescription.30
Ghana is gradually gathering momentum to get to a stage of having a functional national system to monitor AMR. The Antimicrobial Use and Resistance Policy and the national action plan on AMR, which provide strategies and plans to guide AMR data generation for evidence-based interventions at local, national and international levels, were launched by the President of Ghana on 11 April 2018. The national action plan was fashioned along the lines of the objectives of the Global Action Plan on AMR.5 Ghana also has a national AMR working group; the group meets regularly to deliberate on AMR issues in the country. To strengthen knowledge and evidence base through surveillance and research, Ghana received the first Fleming Country Grant, which is currently supporting a government-led system of collecting, analysing and reporting of AMR and antimicrobial use data from humans and animals from 11 sentinel sites. These data will provide a national AMR picture to inform treatment decisions at the national level. Plans are underway to begin a pilot surveillance study.
The prevalence and mortality rate of COVID-19 in Africa is lower compared to that of Europe, America and Asia. However, the rapid spread of the virus is another call to strengthen the laboratory diagnostic capacity in Africa to perform standard antimicrobial susceptibility testing, especially of relevant respiratory pathogens to inform treatment decisions in healthcare facilities. Importantly, AST data need to be collected yearly to support empiric treatment in hospitals. Continuous surveillance is required on the African continent and across the globe to understand the epidemiology of AMR pathogens, provide the needed data to guide and inform treatment decisions and policies and monitor resistance trends and emergence of new clones. In all of these actions, the role of networks and collaborations in enhancing the success of various interventions cannot be overemphasised. Ownership and sustainability plans by governments and local authorities are key to maintaining the successes for continuous AMR surveillance activities with local and international partners. Capacity building (infrastructure and personnel) is a must-have and must be continuously improved to fight AMR in Ghana and Africa.
Going forward
One cannot blame the African prescribers for throwing the 'kitchen sink' of antibiotics at sick and dying COVID-19 or other virally infected patients. Rather, these practices could be reduced significantly, if physicians were empowered to order cultures and obtain results in a timely manner. Doctors faced with negative culture results are more likely to stop antibiotics than if no results are available. With the necessary political will, African governments and academics can do a few things in line with the five strategic objectives of the Global Action Plan on combating AMR during the current pandemic and beyond. Firstly, there is a need to raise awareness of AMR among personnel in human and animal health, and agriculture, as well as among consumers, to ensure a proper understanding of AMR pathogens and the impact of AMR across sectors. There is an urgent need to build laboratory capacity to generate the required microbiology data through surveillance and research to inform treatment decisions, especially in urban centres where resistant organisms are often abundant. Evidence-based prescribing and dispensing should be the way to go to optimise antimicrobial use. More automated systems like the GeneXpert platform used for tuberculosis could be repurposed for organisms like methicillin-resistant S. aureus. In addition to phenotypic methods used in the detection of resistance, genomic tools such as whole genome sequencing can be utilised to generate extensive data to expand our knowledge on the changing epidemiology of AMR bacteria. During the COVID-19 pandemic, urgent studies are needed to document the bacterial organisms responsible for co-infections at the local level to guide empiric therapy. Due to the widespread use of hand sanitizers and antimicrobial soaps, research is needed to study healthcare workers and others for changes in the skin flora that they carry, which could be transmitted to vulnerable patients. Healthcare institutions without antibiotic stewardship programmes must take steps to institute measures for rational antibiotic use. Antibiotic stewardship optimises institutional antibiotic use and reduces the selection and spread of AMR; similarly, infection prevention needs strengthening across the board to limit the spread of resistant bacteria. Finally, the need for increased investment by African governments to drive development of new diagnostic tools, novel antimicrobial agents and vaccines cannot be over-emphasised.
Lessons and conclusion
The AMR menace has been described as a problem that knows no borders; resistant bacteria can be found in humans, animals, food and the environment. The current pandemic shows that we remain susceptible to infections for which we have no therapeutic options. The experience from COVID-19 therefore should be another reminder of the life-threatening consequences of AMR microbes, and the need for rapid capacity building (infrastructure and human resources) for surveillance of resistant bugs on the African continent.
Acknowledgements
The authors of this manuscript are grateful to all other authors whose works were cited.
Competing interests
The authors have declared that no competing interests exist.
Authors' contributions
B.E. conceived the idea and wrote the first draft. N.O.-N. and G.B.K. critically reviewed the content of the manuscript.
Ethical considerations
No ethical clearance was needed for this study.
Sources of support
This research received no specific grant from any funding agency in the public, commercial or not-for-profit sectors.
Data availability statement
Data sharing is not applicable to this article as new data were not created or analysed.
Disclaimer
The views and opinions expressed in this article are those of the authors and do not necessarily reflect the official policy or position of any affiliated agency of the authors.
References
1.World Health Organisation. COVID19 dashboard [homepage on the Internet]. 2020. Available from: https://covid19.who.int/?gclid=CjwKCAjw2a32BRBXEiwAUcugiEyvXpSw1Ku6wc7KQlFeIDlgzFCHlmJyN rxB0mYg3KP3m7tiMTwjeBoCVl8QAvD_BwE Accessed 03 June, 2020. [ Links ]
2.World Health Organisation. WHO [homepage on the Internet]. 2020 [cited 2020 July 06]. Available from: https://www.who.int/news-room/detail/01-06-2020-record-number-of-countries-contribute-data-revealing-disturbing-rates-of-antimicrobial-resistance [ Links ]
3.Moodley A, Patel E. The straw that might break the camel's back [homepage on the Internet]. 2020 [cited 2020 July 06]. Available from: https://www.ilri.org/news/straw-might-break-camel%E2%80%99s-back-exploring-link-between-covid-19-and-antibiotic-resistance-low?fbclid=IwAR3xrWhCNESp4UYFz8JZE1AfOxFkC9g01UVWOVqBhNryj-lHYx627BuACr8 [ Links ]
4.O'Neil J. Review on AMR 2014: Tackling drug resistant infections globally: Final report [homepage on the Internet]. 2014 [cited 2020 July 07]. Available from: https://www.antimicrobialsworkinggroup.org/antimicrobial-resistance/ [ Links ]
5.World Health Organisation. Global action plan on antimicrobial resistance. Geneva: WHO; 2015. [ Links ]
6.World Health Organization. Antimicrobial resistance: Global report on surveillance [homepage on the Internet]. 2014 [cited 2020 July 09]. Available from: https://apps.who.int/iris/bitstream/10665/112642/1/9789241564748_eng.pdf?ua=1 [ Links ]
7.Morris DE, Cleary DW, Clarke SC. Secondary bacterial infections associated with influenza pandemics. Front Microbiol. 2017;8(1):1041. https://doi.org/10.3389/fmicb.2017.01041 [ Links ]
8.Morens DM, Taubenberger JK, Fauci AS. Predominant role of bacterial pneumonia as a cause of death in pandemic influenza: Implications for pandemic influenza preparedness. J Inf Dis. 2008;198(7):962-970. https://doi.org/10.1086/591708 [ Links ]
9.Centers for Disease Control and Prevention. Bacterial co-infection in lung tissue specimens from fatal cases of 2009 pandemic influenza A (H1N1) - United States. Morb Mortal Wkly Rep. 2009;58(38):1071-1074. [ Links ]
10.Zhou F, Yu T, Du R, et al. Clinical course and risk factors for mortality of adult inpatients with COVID-19 in Wuhan, China: A retrospective cohort study. Lancet. 2020;395(10229):1054-1062. https://doi.org/10.1016/S0140-6736(20)30566-3 [ Links ]
11.Reardon S. Antibiotic treatment for COVID-19 complications could fuel resistant bacteria [homepage on the Internet]. 2020 [cited 2020 May 27]. Available from: https://www.sciencemag.org/news/2020/04/antibiotic-treatment-covid-19-complications-could-fuel-resistant-bacteria [ Links ]
12.Africanews [homepage on the Internet]. 2020 [cited 2020 July 06]. Available from: https://www.africanews.com/2020/05/27/covid-19-treatment-algeria-to-continue-using-hydroxychloroquine// [ Links ]
13.Yap FHY, Gomersall CD, Fung KSC, et al. Increase in methicillin-resistant Staphylococcus aureus acquisition rate and change in pathogen pattern associated with an outbreak of severe acute respiratory syndrome. Clin Inf Dis. 2004;39(4):511-516. https://doi.org/10.1086/422641 [ Links ]
14.European Centre for Disease Prevention and Control. ECDC country visit to Italy to discuss antimicrobial resistance issues. Stockholm: ECDC; 2017. [ Links ]
15.Murray AK. The novel coronavirus COVID-19 outbreak: Global implications for antimicrobial resistance. Front Microbiol. 2020;11(1):1020. https://doi.org/10.3389/fmicb.2020.01020 [ Links ]
16.Bernabé KJ, Langendorf C, Ford N, Ronat JB, Murphy RA. Antimicrobial resistance in West Africa: A systematic review and meta-analysis. Int J Antimicrob Agents. 2017;50(5);629-639. https://doi.org/10.1016/j.ijantimicag.2017.07.002 [ Links ]
17.World Health Organisation. Global Database for Antimicrobial Resistance [homepage on the Internet]. 2018/2019. Available from: https://amrcountryprogress.org/ [ Links ]
18.Perovic O, Yahaya AA, Viljoen C, et al. External quality assessment of bacterial identification and antimicrobial susceptibility testing in African National Public Health Laboratories, 2011-2016. Trop Med Infect Dis. 2019;13(4):144. https://doi.org/10.3390/tropicalmed4040144 [ Links ]
19.World Health Organisation. Global antimicrobial resistance surveillance system: Manual for early implementation. Geneva: WHO; 2015. [ Links ]
20.Newman MJ, Frimpong E, Donkor ES, Opintan JA, Asamoah-Adu A. Resistance to antimicrobial drugs in Ghana. Inf Drug Resist. 2011;4(1):215-220. https://doi.org/10.2147/IDR.S21769 [ Links ]
21.Opintan JA, Newman MJ, Arhin RE, et al. Laboratory-based nationwide surveillance of antimicrobial resistance in Ghana. Inf Drug Resist. 2015;(8):379-389. https://doi.org/10.2147/IDR.S88725 [ Links ]
22.Opintan JA, Newman MJ. Prevalence of antimicrobial resistant pathogens from blood cultures: Results from a laboratory based nationwide surveillance in Ghana. Antimicrob Resist Infect Control. 2017;6(1):64. https://doi.org/10.1186/s13756-017-0221-0 [ Links ]
23.Ayibieke A, Sato W, Mahazu S, et al. Molecular characterisation of the NDM-1-encoding plasmid p2189-NDM in an Escherichia coli ST410 clinical isolate from Ghana. PLoS One. 2018;13(12):e0209623. https://doi.org/10.1371/journal.pone.0209623 [ Links ]
24.Morrill HJ, Pogue JM, Kaye KS, LaPlante KL. Treatment options for carbapenem-resistant enterobacteriaceae infections. Open Forum Infect Dis. 2015;2(2):ofv050. https://doi.org/10.1093/ofid/ofv050 [ Links ]
25.Attram N, Agbodzi B, Dela H, et al. Antimicrobial resistance (AMR) and molecular characterization of Neisseria gonorrhoeae in Ghana, 2012-2015. PLoS One. 2019;14(10):e0223598. https://doi.org/10.1371/journal.pone.0223598 [ Links ]
26.Egyir B, Guardabassi L, Moneck S, Newmann MJ, Addo KK, Larsen AR. Short communication: Methicillin resistant Staphylococcus aureus strains from Ghana include USA300. J Glob Antimicrob Resist. 2015;3(1):26-30. https://doi.org/10.1016/j.jgar.2014.11.006 [ Links ]
27.Egyir B, Guardabassi L, Sørum M, et al. Molecular epidemiology and antimicrobial susceptibility of clinical Staphylococcus aureus from healthcare institutions in Ghana. PLoS One. 2014;9(2):e89716. https://doi.org/10.1371/journal.pone.0089716 [ Links ]
28.Egyir B, Guardabassi L, Esson J, et al. Insights into nasal carriage of Staphylococcus aureus in an urban and a rural community in Ghana. PLoS One. 2014;9(4):e96119. https://doi.org/10.1371/journal.pone.0096119 [ Links ]
29.Egyir B, Guardabassi L, Nielsen SS, et al. Prevalence of nasal carriage and diversity of Staphylococcus aureus among inpatients and hospital staff at Korle Bu Teaching Hospital, Ghana. J Glob Antimicrob Resist. 2013;1(4):189-193. https://doi.org/10.1016/j.jgar.2013.05.006 [ Links ]
30.Donkor ES, Tetteh-Quarcoo PB, Nartey P, Agyeman IO. Self-medication practices with antibiotics among tertiary level students in Accra, Ghana: A cross-sectional study. Int J Environ Res Public Health. 2012;9(10):3519-3529. https://doi.org/10.3390/ijerph9103519 [ Links ]
Correspondence:
Beverly Egyir
beverlyegyir@gmail.com
Received: 15 June 2020
Accepted: 07 Aug. 2020
Published: 23 Sept. 2020
OPINION PAPER
How can clinical immunology laboratories contribute to the management of severe COVID-19 cases in limited resource contexts?
Brahim AdmouI; Abdelhamid HachimiII; Mohamed Abdenasser SamkaouiIII
ICenter of Clinical Research, Faculty of Medicine and Pharmacy, Mohamed VI University Hospital, Cadi Ayyad University, Marrakech, Morocco
IIDepartment of Intensive Care, Faculty of Medicine and Pharmacy, Mohamed VI University Hospital, Cadi Ayyad University, Marrakech, Morocco
IIIDepartment of Anesthesiology and Intensive Care, Faculty of Medicine and Pharmacy, Mohamed VI University Hospital, Cadi Ayyad University, Marrakech, Morocco
Introduction
Since its appearance, the coronavirus disease 2019 (COVID-19) that is caused by severe acute respiratory disease coronavirus 2 (SARS-CoV-2), has been responsible for severe respiratory disease similar to diseases commonly associated with the coronaviruses such as severe acute respiratory syndrome and Middle East respiratory syndrome; COVID-19 frequently requires hospitalisation in the intensive care unit and has had a high mortality rate.1 The severity of COVID-19 is generally stratified as asymptomatic, mild (without signs of severe or critical illness), severe (with signs of breathing difficulties) or critical (with signs of respiratory failure, shock and multiple organ failure).2
The contribution of the medical laboratory to the categorisation of COVID-19 clinical forms is not yet well defined.3 After confirmation of infection by real-time polymerase chain reaction, biochemical and haematological analyses provide fundamental biological parameters for determining disease severity. Similarly, the clinical immunology laboratory could play an important role in elucidating diverse immunological abnormalities associated with the disease. In particular, immunological testing could better categorise the severe and critical forms of COVID-19, and subsequently assist treating physicians during the entire course of therapy. The purpose of this opinion article is to highlight the position of the immunology laboratory in the management of severe and critical COVID-19 cases, specifically in countries with limited resources.
COVID-19 and cytokine storm
COVID-19 is marked by an overproduction of pro-inflammatory cytokines and chemokines, mainly interleukin (IL)-6, IL-10, tumor necrosis factor (TNF)-α, IL-1β, IL-2, IL-10, interferon-γ and monocyte chemoattractant protein-1.4 Other biological abnormalities may predict the severity or progression of the disease, such as abnormal coagulation activation, leukopenia, high levels of C-reactive protein, ferritin, D-dimers, aminotransferase, lactate dehydrogenase and creatin kinase.3,5 Elevated levels of pro-inflammatory cytokines have been shown to characterise severe lung infection, which manifests as respiratory distress, multiple organ failure and adverse outcomes in SARS-CoV-2 infection.6,7 In addition, IL-6, IL-10, and TNF-α levels significantly increase during infection and drop during recovery,8 suggesting that the intensity of the cytokine release correlates with disease activity. Interestingly, IL-6 may be a marker for monitoring serious COVID-19 cases.9
Moreover, simultaneous high levels of IL-6 and D-dimers have been shown to be narrowly associated with severe forms of the disease in adult patients. Therefore, measuring them in combination allows for greater specificity and sensitivity for predicting severe cases of COVID-19.3
COVID-19 and T cell impairment
Deregulation of the immune response, particularly T lymphocytes, appears to be strongly linked to the pathology of COVID-1910; direct infection of lymphocytes by SARS-CoV-2 has been proposed as a cause for acute lymphocyte decline.3,11 Lymphocytes express the receptor angiotensin-converting enzyme 2, which has been suggested to be the primary receptor targeted by SARS-CoV-2.12
Moreover, altered T lymphocytes could be an important factor in worsening symptoms in patients, which makes lymphopenia a relevant marker of disease severity, hence the need for intensive care unit admission.11
It has been demonstrated that the severe respiratory syndrome that manifests due to COVID-19 is characterised by cluster of differentiation (CD)4 and CD8 T lymphopenia, correlating with disease severity.4,13 On the other hand, COVID-19 patients who require intensive care unit hospitalisation have significantly higher levels of IL-6, IL-10 and TNF-α, with lower levels of CD4 and CD8 T cell counts,8 with which levels of cytokines and T cells are inversely correlated.6,8 Moreover, because T lymphocytes are generally crucial for amortising exaggerated natural immune reactions against viral infection, T cell defects can lead to worsening inflammatory responses during COVID-19, whereas restoring the number of these lymphocytes can improve them.6
In accordance with this hypothesis, it has been shown that 4-6 days following the onset of infection, T lymphocyte counts drop to their lowest level, whereas cytokine levels reach their maximum. Conversely, the restoration of the number of T lymphocytes is associated with a decrease in serum levels of various cytokines, such as IL-6, IL-10 and TNF-α.6 Owing to the cytokine storm, and other immunological predictors of severity of SARS-CoV2 infection, these may also be helpful in choosing anti-inflammatory drugs, especially corticosteroids for their potential benefit in the reduction of inflammation-induced lung damage in severe COVID-19 patients.1
COVID-19 and immunological investigations
Having shown that the most relevant immunological parameters include inflammatory cytokines and T lymphocyte subpopulations, the clinical immunology laboratory is positioned to be important for assessing COVID-19 patients, especially for categorising, or even predicting severe cases.2,10 Cytokine levels, especially that of IL-6, can be individually measured on immunoassay analysers, whereas other cytokine profiles can be explored using either enzyme-linked immunosorbent assays or other specific biotechnologies like Luminex®, 200™ (or multiplex) (Luminex®, Austin, Texas, United States) and flow cytometry systems, which allow for a large-scale quantitative measurement.14 The assessment of the main T cell subsets, such as CD3+, CD4+ and CD8+, requires only a simple phenotyping procedure conductible on a mini-cytometer, which is largely available worldwide even in limited-resource context laboratories, thanks to HIV management programs. More developed flow cytometry platforms allow for comprehensive phenotyping assays, enabling the investigation of naive, memory and regulatory T cells; in severe COVID-19 patients, early data on T cell subpopulation abnormalities show increased naive helper T cells and decreased memory helper T cells, associated with a lower number of regulatory T cells.10
Using a receiver operating characteristic curve to compare fatal and recovered COVID-19 cases, Xu et al.2 considered 559 cells/µL, 235 cells/µL, and 104 cells/µL of CD3+, CD4+T, and CD8+ T cell subsets as warning values, below which there was a significantly higher risk of in-hospital death.2 Indeed, there is a need for regional data analyses before determining cut-off values of these T cell subsets. However, T cell lymphopenia might be accentuated by possible primary or acquired immune deficiency conditions, potentially revealed by COVID-19, and must then be considered first when interpreting cell phenotyping values and when managing patients as well.15
Conclusion
For SARS-CoV-2 infection, alongside other clinical and biological parameters, the measurement of inflammatory cytokines, mainly IL-6, as well as CD4+ and CD8+ T cell assessment, should be systematically planned during management of the disease. These markers could be useful for identifying severe cases requiring prompt admission to intensive care units, and for monitoring patient disease progression. These investigations are within the reach of almost all clinical immunology laboratories in the world. Close collaboration between immunologists and physicians is essential for effective global efforts against this highly threatening pandemic.
Acknowledgements
We would like to express our sincere gratitude and deepest appreciation to Yacine Berka for his highly valuable contribution in the editing of this manuscript.
Competing interests
The authors have declared that no competing interests exist.
Authors' contributions
All authors contributed equally to this work. B.A. conceptualised and wrote the major parts of the manuscript. A.H. co-wrote the clinical aspects of the manuscript. M.A.S. contributed to the conceptualisation and validated a writing review of the manuscript.
Ethical considerations
Ethical clearance was not required for this study.
Sources of support
This research received no specific grant from any funding agency in the public commercial or not-for-profit sectors.
Data availability statement
Data sharing is not applicable to this article as no new data were created or analysed in this study.
Disclaimer
The views and opinions expressed in this article are those of the authors and do not necessarily reflect the official policy or position of any affiliated agency of the authors.
References
1.Huang C, Wang Y, Li X, et al. Clinical features of patients infected with 2019 novel coronavirus in Wuhan, China. Lancet. 2020;395(10223):497-506. https://doi.org/10.1016/S0140-6736(20)30183-5 [ Links ]
2.Xu B, Fan C-Y, Wang A-L, et al. Miao. Suppressed T cell-mediated immunity in patients with COVID-19: A clinical retrospective study in Wuhan, China. J Infect. 81(1):e51-e60. [ Links ]
3.Gao Y, Li T, Han M, et al. Diagnostic utility of clinical laboratory data determinations for patients with the severe COVID-19. J Med Virol. 2020;92(7):791-796. https://doi.org/10.1002/jmv.25770 [ Links ]
4.Pedersen S-F, Ho Y-C. SARS-CoV-2: A storm is raging. J Clin Invest. 2020;130(5):2202-2205. https://doi.org/10.1172/JCI137647 [ Links ]
5.Henry B-M, De Oliveira M-H-S, Benoit S, et al. Hematologic, biochemical and immune biomarker abnormalities associated with severe illness and mortality in Coronavirus Disease 2019 (COVID-19): A meta-analysis. Clin Chem Lab Med. 2020;58(7):1021-1028. https://doi.org/10.1515/cclm-2020-0369 [ Links ]
6.Liu J, Li S, Liu J, et al. Longitudinal characteristics of lymphocyte responses and cytokine profiles in the peripheral blood of SARS-CoV-2 infected patients. EBio Med. 2020;55:102763. https://doi.org/10.1016/j.ebiom.2020.102763 [ Links ]
7.Zhou J, Chu H., Li C, et al. Active replication of Middle East respiratory syndrome coronavirus and aberrant induction of inflammatory cytokines and chemokines in human macrophages: Implications for pathogenesis. J Infect Dis 2014;209(9):1331-1342. https://doi.org/10.1093/infdis/jit504 [ Links ]
8.Diao B, Wang C, Tan Y, et al. Reduction and functional exhaustion of T cells in patients with coronavirus disease. Front. Immunol. 2020;11:827. https://doi.org/10.3389/fimmu.2020.00827 [ Links ]
9.Zhu Z, Cai T, Fan L, et al. Clinical value of immune-inflammatory parameters to assess the severity of coronavirus disease 2019. Int J Infect Dis. 2020;95:332-339. https://doi.org/10.1016/j.ijid.2020.04.041 [ Links ]
10.Qin C, Zhou L, Hu Z, et al. Dysregulation of immune response in patients with COVID-19 in Wuhan, China. Clin Infect Dis. 2020. https://doi.org/10.1093/cid/ciaa248 [ Links ]
11.Tan L, Wang Q, Zhang D, et al. Lymphopenia predicts disease severity of COVID-19: A descriptive and predictive study. Signal Transduct Target Ther. 2020;5(1):33. https://doi.org/10.1038/s41392-020-0159-1 [ Links ]
12.Xu H, Zhong L, Deng J, et al. High expression of ACE2 receptor of 2019-nCoV on the epithelial cells of oral mucosa. Int J Oral Sci. 2020;12:8. https://doi.org/10.1038/s41368-020-0074-x [ Links ]
13.Chen G, Wu D, Guo W, et al. Clinical and immunologic features in severe and moderate coronavirus disease 2019. J Clin Invest. 2020;130(5):2620-2629. https://doi.org/10.1172/JCI137244 [ Links ]
14.Medeiros NI, Gomes JAS. Cytometric Bead Array [CBA] for measuring cytokine levels in Chagas disease patients. Methods Mol Biol. 2019;1955:309-314. https://doi.org/10.1007/978-1-4939-9148-8_23 [ Links ]
15.Brough H-A, Kalayci O, Sediva A, et al. Managing childhood allergies and immunodeficiencies during respiratory virus epidemics - The 2020 COVID-19 pandemic. Pediatr Allergy Immunol. 2020;31(5):442-448. https://doi.org/10.1111/pai.13262 [ Links ]
Correspondence:
Brahim Admou
br.admou@uca.ac.ma
Received: 27 May 2020
Accepted: 03 Sept. 2020
Published: 02 Nov. 2020
OPINION PAPER
COVID-19 during malaria transmission season in Africa and why we should be prepared: An example from Senegal
Khadim DiongueI, II; Mamadou A. DialloII
IParasitology-Mycology Service, Faculty of Medicine, Pharmacy and Odontology, Cheikh Anta Diop University, Dakar, Senegal
IILaboratory of Parasitology and Mycology, Aristide Le Dantec University Hospital, Dakar, Senegal
Introduction
Coronavirus disease 2019 (COVID-19) is not just a global health crisis; it is also a socio-economic crisis1 with a huge number of associated deaths.2 On 30 June 2020, the World Health Organization reported 10 185 374 cases and 503 862 deaths related to COVID-19 globally, of which 297 290 cases and 6010 deaths were recorded in Africa.1 In Senegal, malaria transmission is seasonal with high vector populations observed during the rainy season - from mid-June to October. The heaviest rainfalls are observed in the months of July, August and September. On 30 March 2020, as effort to combat the spread of COVID-19 in Senegal, a state of emergency was declared banning religious gatherings, closing schools and universities and imposing a curfew between 22:00 and 06:00. As of 30 June 2020, the day the state of emergency was lifted, the authorities had reported 6698 confirmed COVID-19 cases and 108 COVID-19 related deaths1,3,4 thus the country was confronted with managing the expected rainy-season malaria epidemic and the on-going COVID-19 pandemic. Hence, this article aims to draw the attention of authorities to this current situation.
An important epidemiological reminder in this current context
Before and after the ease of lockdown measures on 04 June 2020, Senegal had been experiencing constantly increasing COVID-19 cases, as evidenced by a 22% increase in cases during the month of June 2020. There were 1838 COVID-19 cases on 01 June 2020, which had reached 2249 cases by 30 June 2020. However, the most detrimental event during the COVID-19 pandemic is that of the general population deserting the health facilities that are hosting infected COVID-19 individuals for fear of being tested or infected. Since the decentralisation and proliferation of COVID-19 care centres around the country, COVID-19 hosting centres are being avoided by the populace; worse still, patients have now deserted the isolation centres. Senegalese people avoid going to places where any test that could suggest COVID-19 is done, even a body temperature measurement. However, experience has shown that in an outbreak such as the COVID-19 pandemic, it is essential to not ignore other diseases such as malaria. The recent West Africa Ebola epidemic revealed the deleterious impact of increased health service demand on an already fragile health system, as well as on the control of other diseases. Consequently, the Ebola outbreak led to a substantial increase in morbidity and mortality of other diseases, including malaria.5 The World Health Organization has warned of a twofold devastation by the COVID-19 pandemic: the first is its direct effect on health - COVID-19 morbidity and mortality - and the second is the related increase in morbidity and mortality of other diseases due to lack of or diversion of adequate health response for other diseases.5 For example, during the Ebola epidemic year in Guinea, health facilities recorded a lower malaria patients' visitation than was expected - an estimated deficit of 74 000 visitations. Conversely and sadly, malaria caused 1067 deaths in 2014 - an Ebola year - compared to 108 deaths reported in 2013 - a non-Ebola year.6 More worryingly, in Liberia, Sierra Leone and Guinea, about 7000 other deaths related to malaria were recorded among children under age 5 years, which were attributed to the 2014-2016 Ebola outbreak.6
What we know
Malaria illness presents some similar symptoms to the COVID-19 illness: fever, respiratory distress, fatigue and an acute onset headache.5,7 The major sign between both illnesses is fever. Thus, a malaria case or a COVID-19 case may each be confused for the other, if symptoms alone are used to define a case during this current pandemic. Also, since the beginning of the pandemic in Senegal, fever is the major symptom of infected individuals8; febrile individuals are isolated before samples are taken. The sampling team is deployed after contact with the Senegalese medical emergency assistance service; however, the emergency assistance centre has been overwhelmed (more than 726 000 emergency calls between 02 March 2020 and 29 June 20209), which could be the reason why, unfortunately, sampling teams can sometimes take more than 24 h to intervene. This delays the differential diagnosis of malaria and similar illnesses, as well as increases the risk of development of severe malaria, if malaria diagnosis is correct but delayed. Therefore, clinicians should go back to the good old method of 'any case of fever must be considered as malaria until proven otherwise'. Confirming either malaria or severe acute respiratory syndrome coronavirus 2 (SARS-CoV-2) infection with a diagnostic test does not rule out the possibility of the other in a patient. Indeed, both false-positive and false-negative results have been reported worldwide with rapid diagnostic tests.10 Likewise, approximately 50% of infected cases are likely missed by current screening approaches for COVID-19, even in countries with good healthcare systems and available diagnostic capacities. As COVID-19 can be transmitted even by asymptomatic people, and personal social distancing cannot be effective when performing a malaria test, such as a rapid diagnostic test,11 other infection prevention and control measures must be carefully put in place.7 These measures include but are not limited to: proper donning and doffing of personnel protection equipment, especially face masks; provision and use of soap and water for handwashing; provision and use of alcohol-based hand sanitiser and the practice of good respiratory hygiene (i.e. covering of the mouth and nose with a disposable tissue when sneezing or coughing or sneezing into the crease of the elbow).7 Thus, health providers should also be more careful.
What we should do
In Senegal, according to the last national malaria control programme report published in 2018, malaria caused 395 706 cases with 284 deaths including 95 deaths (33.45%) among children younger than age 5 years.12 However, the malaria burden was more than 50% lower between 2009 and 2015, permitting the country to achieve the objectives of Roll Back Malaria in 2015.3 Therefore, to not lose this positive momentum in the fight against malaria, the Senegalese national malaria control programme should scrupulously follow the recommendations of the World Health Organization, which include tailoring malaria interventions in the COVID-19 response5 with particular regard to the following points: case management, chemoprevention (intermittent preventive treatment in pregnancy and seasonal malaria chemoprevention); extraordinary interventions, including presumptive treatment of fever and mass drug administration, as well as the assurance of continued access to and use of recommended insecticide-treated mosquito nets; and implementation of core vector-control activities to the greatest extent possible (current and planned insecticide-treated nets campaigns should go ahead, if at all possible). Malaria prevention and treatment is even more important during the COVID-19 pandemic than under normal circumstances.
Rapid diagnosis plays an important role in the outcome of both malaria and COVID-19; thus, in addition to these recommendations, quick, easy, reliable and cheap diagnostics requiring minimal invasion must be performed, especially in cases of likely overlap with malaria and COVID-19. This is the time for malaria-endemic countries challenged with the COVID-19 pandemic to apply modern techniques including point-of-care tests such as the Loop-Mediated Isothermal Amplification assay for rapid detection of both Plasmodium and SARS-CoV-2.13,14 Meanwhile, health authorities should also centralise the management of COVID-19 infected individuals so that populations suffering from other diseases (diabetes, high blood pressure, cardiovascular disorders, arthritis, etc.) could return to health facilities without fear of being infected. However, number of tests as well as the test centers for COVID-19 detection should be multiplied in order to attend benefits of early case identification.
Acknowledgements
We are thankful to Dr Mamane Nassirou Garba for his English review and all the staff of the parasitology and mycology laboratory at Le Dantec University of Dakar, especially to Prof. Daouda Ndiaye.
Competing interests
The authors declare that they have no financial or personal relationships that may have inappropriately influenced them in writing this article.
Authors' contributions
K.D. was responsible for the conception and design of the study and drafting the article. M.A.D. reviewed the article. All authors approved the final version to be submitted.
Ethical considerations
The work did not involve the use of human subjects or animal experiments.
Sources of support
This research received no specific grant from any funding agency in the public, commercial or not-for-profit sectors.
Data availability statement
Data sharing is not applicable to this article as no new data were created or analysed in this study.
Disclaimer
The views and opinions expressed in this article are those of the authors and do not necessarily reflect the official policy or position of any affiliated agency of the authors.
References
1.World Health Organization (WHO). Coronavirus disease (COVID-19): Situation report - 162. WHO; 2020 [cited 2020 Jun 30]. Available from: www.who.int/emergencies/diseases/novel-coronavirus-2019/situation-reports [ Links ]
2.Gangneux J-P, Bougnoux M-E, Dannaoui E, Cornet M, Zahar JR. Invasive fungal diseases during COVID-19: We should be prepared. J Mycol Méd. 2020;30(2):100971. https://doi.org/10.1016/j.mycmed.2020.100971 [ Links ]
3.Programme National de Lutte contre le paludisme (PNLP). Sénégal - Plan Stratégique de lutte contre le Paludisme 2016-2020 [homepage on the Internet]. PNLP; 2015 [cited 2020 Jun 30]. http://www.pnlp.sn/wp-content/uploads/2016/08/PNLP_PSN_VFF_03-02-2016.pdf [ Links ]
4.Agence Nationale de la Statistique et de la Démographie/Service Régional de la Statistique et de la Démographie de Dakar (ANSD/SRSD). Situation Économique et Sociale régionale - 2012 [homepage on the Internet]. ANSD/SRSD; 2015 [cited 2020 Jun 30]. Available from: http://www.ansd.sn/ressources/ses/SES_Dakar-2012.pdf [ Links ]
5.World Health Organization (WHO). Tailoring malaria interventions in the COVID-19 response [homepage on the Internet]. WHO; 2020 [cited 2020 Jun 30]. Available from: http://www.who.int/malaria [ Links ]
6.Wang J, Xu C, Wong YK, et al. Preparedness is essential for malaria-endemic regions during the COVID-19 pandemic. Lancet. 2020;395(10230):1094-1096. https://doi.org/10.1016/S0140-6736(20)30561-4 [ Links ]
7.Chanda-Kapata P, Kapata N. COVID-19 and malaria: A symptom screening challenge for malaria endemic countries. Int J Infect Dis. 2020;94:151-153. https://doi.org/10.1016/j.ijid.2020.04.007 [ Links ]
8.Seydi M, Lakhe NA. Profil Épidémiologique, Clinique et Évolution des Cas de COVID-19 au Sénégal. Ministère de la santé et de l'action sociale [homepage on the Internet]. 2020 [cited 2020 Jun 30]. Available from: http://familyplanning2020.org/sites/default/files/resources/COVID/COVID-19%20AFREHealth%20Webinar%20Talk_CMIT_Dakar_Senegal_Pr.%20Seydi_Dr.%20Lakhe_March19_2020 _French%20Version.pdf [ Links ]
9.Ministère de la Santé et de l'Action Sociale (MSAS). Message à la Nation de SEM le Président Sall Levée de l'état d'urgence instauré dans le cadre de la lutte contre la maladie à coronavirus COVID-19 [homepage on the Internet]. MSAS; 2020 [cited 2020 Jun 30]. Available from: http://www.sante.gouv.sn/sites/default/files/DISCOURS%20DU%20PR.pdf [ Links ]
10.Kafai NM, Odom John AR. Malaria in children. Infect Dis Clin N Am. 2018;32(1):189-200. https://doi.org/10.1016/j.idc.2017.10.008 [ Links ]
11.Diallo MA, Diongue K, Ndiaye M, et al. Evaluation of CareStart™ Malaria HRP2/pLDH (Pf/pan) combo test in a malaria low transmission region of Senegal. Malar J. 2017;16:328. https://doi.org/10.1186/s12936-017-1980-z [ Links ]
12.Programme National de Lutte contre le paludisme (PNLP). Bulletin épidémiologique annuel 2017 du paludisme au Sénégal [homepage on the Internet]. PNLP; 2018 [cited 2020 Jun 30]. Available from: https://fr.africacheck.org/wp-content/uploads/2018/04/Senegal-paludisme-bulletin-annuel-2017-PNLP.pdf [ Links ]
13.Lucchi NW, Gaye M, Diallo MA, et al. Evaluation of the Illumigene Malaria LAMP: A robust molecular diagnostic tool for malaria parasites. Sci Rep. 2016;6:36808. https://doi.org/10.1038/srep36808 [ Links ]
14.L'Helgouach N, Champigneux P, Schneider FS, et al. EasyCOV: LAMP based rapid detection of SARS-CoV-2 in saliva [homepage on the Internet]. 2020 [cited 2020 Jun 30]. https://www.skillcell-alcen.com/sites/skillcell-alcen/files/pdf/press/Clinical-assessment-of-EasyCov-v10_1.pdf [ Links ]
Correspondence:
Khadim Diongue
khadimase@gmail.com
Received: 08 July 2020
Accepted: 14 Sept. 2020
Published: 18 Nov. 2020
OPINION PAPER
Will long-read sequencing technologies replace short-read sequencing technologies in the next 10 years?
Boluwatife A. AdewaleI, II, III
IMedicine and Surgery, Faculty of Clinical Sciences, College of Medicine, University of Ibadan, Ibadan, Nigeria
IICollege Research and Innovation Hub (CRIH), University of Ibadan, Ibadan, Nigeria
IIIUniversity College Hospital, Ibadan, Nigeria
The year 1977 is quite remarkable in the history of genomics. It was the first time that the complete genome of an organism (phage φX174) would be sequenced - the advent of the first generation of sequencing technologies. Of the two sequencing methods published that year, Fred Sanger's 'chain-termination' method would become the mainstay of sequencing technology for the next three decades. Because of its better usability compared to the Maxam-Gilbert method, it was widely preferred and became commercialised1 by Applied Biosystems Inc. Thanks to the collaborative efforts of scientists across the world,2 Sanger sequencing eventually produced a reference human genome, courtesy of the US$2.7-billion (United States dollar) Human Genome Project completed in 2003.3
Next-generation sequencing
The launch of pyrosequencing by 454 Life Sciences in 2005 marked the beginning of the second generation of sequencing. Massively parallel or next-generation sequencing (NGS) technologies eliminated the need for multiple personnel working on a genome by automating DNA cleavage, amplification and parallel short-read sequencing on a single instrument, thereby lowering costs and increasing throughput.1,4
Pyrosequencing relies on the release of pyrophosphates when nucleotides are washed over fixed DNA clones in a DNA polymerase-mediated reaction (Figure 1). Pyrophosphate takes part in a cascade of reactions that eventually give off light which is detected and interpreted by a computer program. Ion Torrent employs a similar technique except that it uses pH instead of luminescence to detect nucleotide addition, whereas the Applied Biosystems Inc. SOLiD™ system is a sequencing--by-ligation technique which detects fluorescence that results from the action of DNA ligase on oligonucleotides (Figure 1).5,6
SOLiD™ and Ion Torrent have been in the NGS market since 2007 and 2010, whereas Roche announced the phaseout of 454 Pyrosequencing in 2013 after facing stiff competition in the market. The reversible terminator sequencing currently sold by Illumina is the predominant NGS platform: a sequencing-by-synthesis approach that uses bridge amplification and fluorescent signals from the addition of deoxynucleoside triphosphate (dNTP) to a growing complementary strand (Figure 1). The signal is detected in real time by a coupled charge device camera and interpreted by computer software.1
Next-generation sequencing technologies have made sequencing much easier, faster and cheaper than Sanger sequencing. The August 2019 report from the National Human Genome Research Institute put the cost of sequencing a complete human genome at $942.00 United States dollars (USD). Thanks to NGS, the reduction in cost of genome sequencing has beaten Moore's Law prediction (Figure 2), more evidently since 2008, about the same time that NGS became popular in sequencing centres.7
Illumina, introduced in 2006, is the most robust of all NGS technologies. It quickly gained traction among scientists, because of its high throughput and affordability compared to 454 Pyrosequencing, SOLiD™ and Ion Torrent. In fact, Illumina was the first company to fulfil the '$1000 genome' promise with its HiSeq X Ten sequencer in 2014. Sequencing a genome now costs below $1000.00 USD with ongoing efforts to reach the $100.00 USD target.3
Where short reads come short
All second-generation sequencing technologies have a common limitation - the inability to sequence long stretches of DNA. To sequence a large genome like human DNA using NGS, the DNA has to be fragmented and amplified in clones of between 75 base pairs and 400 base pairs, hence the term 'short-read sequencing' (SRS). Computer programs are then used to assemble the random clones into a contiguous sequence.2 Aside from the fact that polymerase chain reaction - a necessary step in SRS - causes preferential amplification of repetitive DNA, SRS fails to generate sufficient overlap sequence from the DNA fragments. This constitutes a major challenge for de novo sequencing of a highly complex and repetitive genome like the human genome.2 The detection of large sequence changes is another area of difficulty that is encountered using SRS - a major barrier to studying structural variations.8
Long-read sequencing
Third-generation sequencing technologies which are otherwise called long-read sequencing (LRS) technologies address the shortcomings of NGS. Whereas the Sanger and SRS approaches cannot exceed read lengths of 1 kilobase pair, third-generation sequencing technologies read lengths are between 5 kilobase pairs and 30 kilobase pairs. The longest read length ever generated by a third-generation sequencing technology is 2 gigabase pairs.9 Long-read sequencing methods sequence a single molecule - thus abolishing amplification bias - and generate a reasonable length of overlap sequence for better sequence assembly.1
There are two prominent LRS technologies namely, nanopore sequencing and the single-molecule real-time (SMRT) sequencing.10 Single-molecule real-time sequencing was commercially released in 2011 by Pacific Biosciences (PacBio). A SMRT genome sequencer consists of millions of zero-mode waveguides - microscopic wells with DNA polymerase fixed at the bottom. Within each zero-mode waveguide, two hairpin adaptors are ligated to both ends of the molecule to form a circular single-stranded DNA. With the aid of a primer complementary to the adaptors, DNA polymerase is used to sequence a complementary strand. When a fluorescent nucleotide is added to the strand, a fluorescence of wavelength corresponding to the added nucleotide is given off. This signal is captured in real time by a coupled charge device camera and interpreted by a computer program.1
Nanopore sequencing, released by Oxford Nanopore Technologies in 2014, works by a different principle: threading the DNA molecule through a 1.5 nm wide bioengineered channel embedded in a biological membrane. Electrical current across the channel depends on which nucleotide is traversing the channel at the time. This variation is used to determine the base sequence of the nucleic acid.1
Single-molecule real-time and nanopore sequencing check all of the boxes in terms of suitability for de novo sequencing, resolution of repeat sequences (e.g. human leukocyte antigen gene, centromere), detection of structural variations, epigenetics and transcriptome sequencing, among others. However, the accuracy per read and the throughput of LRS is poor compared to SRS.1,10 Moreover, there are challenges in the adaptability of LRS for sequencing different genome lengths, as LRS data processing takes longer for organisms with large genomes than for viral genomes.10
The high error rates of nanopore sequencing are attributed to the poor sensitivity of the nanopore and the inability to control the speed of DNA translocation through the pore. Whereas the errors in nanopore sequencing are systematic, SMRT base-calling errors are random and can be reduced using circular consensus sequencing (CCS), a method that allows the DNA to have multiple passes through the zero-mode waveguides. Increasing the accuracy of SMRT via CCS comes at a higher cost than using NGS.3 Nanopore sequencing has improved over the years, although it is still not as accurate as NGS.
'Nano-promises, giga-prospects'
MinION, a small-sized nanopore sequencing device similar to a universal serial bus flash drive, was used to sequence the Ebola virus during the 2014-2016 outbreak in West Africa in 60 min.3 The MinION sequencer is much more affordable when compared with Illumina and SMRT considering the cost of instruments and consumables.9 Considering its portability, affordability and its ability to generate ultra-long reads, the possibility of using MinION to accurately determine larger genome sequences is of immense value to researchers and clinicians. It holds the answer to affordable genome sequencing in low-resource settings and at the point of care. With improving nanopore technology aimed at decreasing MinION's high error rates, these promises may not be far-fetched.
The Sequel II 8M SMRT cell, which was launched in 2019 by PacBio, has a CCS read accuracy of 99% and above. PromethION, also released in 2019 by Oxford Nanopore Technologies, generates ultra-long reads, although with less accuracy than SMRT. In their efforts to beef up quality, both companies update their products regularly. The latest -double-sensored nanopore cell R10 and linear consensus sequencing (a similar method to SMRT CCS) are expected to improve the accuracy of Oxford Nanopore Technologies products. Interestingly, LRS technologies are approaching SRS in terms of cost and accuracy. Using the Sequel II 8M SMRT cell that was released, CCS reads can now be obtained for about $1500.00 - an eight-fold reduction in costs.3 Less accurate long reads from the PromethION flow cell can be obtained at about the same price.3,5 Error rates for LRS used to be 12% - 15%5 but have now fallen to less than 1% for SMRT and less than 5% for nanopore sequencers10 compared to an error rate of approximately 0.1% in NGS.3,5
Situation report
Notwithstanding SRS market dominance, LRS has broadened its range of applications in recent years as a result of significant improvements in accuracy and throughput. For instance, there has been an increase in the use of MinION in metagenomics studies. LRS technologies are increasingly being used in epigenetics and transcriptomics as well.10
The technical difficulties associated with de novo assembly of short reads for large complex genomes will likely persist for the foreseeable future. The question then becomes whether LRS technologies will improve on their own shortcomings to take over the market.
A paradigm shift in the prevailing technology is likely to occur if there is a major scientific breakthrough, such as the discovery of a DNA polymerase with a longer lifespan for higher throughput and accuracy in SMRT base calling, or a drastic improvement in the sensitivity and DNA translocation speed in nanopore sequencing that matches the accuracy of SRS technologies. However, such improvements are more likely to take place gradually rather than suddenly; I do not see that occurring in the next 10 years.
Lessons from the past
History suggests a difficult transition from short-read to long-read technologies. When 454 pyrosequencing was introduced in 2005, it had a clear advantage over Sanger sequencing in terms of throughput and cost. However, funding agencies and scientists were not immediately receptive to the new technology. Many of the researchers had got used to Sanger sequencing, whereas investors were mindful of their stakes. Thus, it took 3 years before NGS gained wide acceptance in the scientific community.4,7 Even a major scientific breakthrough in sequencing technologies could still take about 2-3 years before finding its footing in the market for wide acceptability.
As of 2014, Illumina controlled about 70% of the market for DNA sequencers and accounted for 90% of global DNA data.3 It is the biggest company on the genomic sequencing market with a worth of $43.6 billion USD. The company's large and increasing customer base makes it difficult to change sides by motivating customers to buy their stocks.11 Currently, no technology compares to Illumina in terms of cost, throughput and accuracy. Even if one were to arise today, it would still have a hard time replacing Illumina, considering the niche that Illumina has carved for itself in the market.
The Illumina-PacBio merger
The potential of LRS, particularly SMRT, is not unnoticed by market giant Illumina, who entered talks in 2018 on a $1.2 billion USD merger with PacBio. Both parties, however, terminated the deal owing to concerns from the United Kingdom Competition and Markets Authority and the United States Federal Trade Commission about an emerging monopoly.12
One is left to imagine why Illumina wanted a merger. Sheer desire for monopoly or the prospect of a robust hybrid technology? Anyway, the synergy of both generations of sequencing technology is worth considering. Hybrid sequencing combines the throughput and accuracy of SRS with the long read length of LRS. It is highly effective for genome polishing10 and can produce reference genomes for most organisms.3
Outlook
While it may be difficult to predict with certainty major breakthroughs capable of altering the narrative in genomic sequencing, it is apparent that LRS holds the key to many unanswered questions in genomics. Long-read sequencing technologies, although constantly improving and gradually closing the gap on NGS in terms of accuracy and costs,3,5 have yet to attain their full potential. In this decade, I expect that LRS technologies will gain more recognition and acceptance as they are adapted for sequencing a variety of organisms. In the absence of an innovation in LRS technology that can significantly increase accuracy and throughput and reduce costs far beyond what SRS technologies offer, I would argue that it is unlikely that LRS technologies completely replace SRS technologies in the next 10 years. Meanwhile, in the middle of these improvements in SRS and LRS technologies, I expect to see increased efforts towards making hybrid sequencing more scalable.
Acknowledgements
I am immensely grateful to my mentors and teachers Dr J.O. Olugbami and Dr O.O. Bello for their invaluable guidance and support. This article was adapted from the winning essay for the Sanger Institute Prize 2020 organised by the Wellcome Sanger Institute, Hinxton, Cambridge, United Kingdom.
Competing interests
The author declares that no competing interests exist.
Author's contributions
The author B.A.A. wrote and edited the manuscript.
Ethical considerations
I confirm that ethical clearance was not needed for this paper.
Sources of support
The author received no financial support for the research, authorship or publication of this article.
Data availability statement
Data sharing is not applicable to this article as no new data were created or analysed in this study.
Disclaimer
The views and opinions expressed in this article are those of the author and do not necessarily reflect the official policy or position of any affiliated agency of the author.
References
1.Heather JM, Chain B. The sequence of sequencers: The history of sequencing DNA. Genomics. 2016;107(1):1-8. https://doi.org/10.1016/j.ygeno.2015.11.003 [ Links ]
2.Mardis ER. DNA sequencing technologies: 2006-2016. Nat Protoc. 2017;12(2):213-218. https://doi.org/10.1038/nprot.2016.182 [ Links ]
3.Giani AM, Gallo GR, Gianfranceschi L, Formenti G. Long walk to genomics: History and current approaches to genome sequencing and assembly. Comput Struct Biotechnol J. 2020;18:9-19. https://doi.org/10.1016/j.csbj.2019.11.002 [ Links ]
4.Schuster SC. Next-generation sequencing transforms today's biology. Nat Methods. 2008;5(1):16-18. https://doi.org/10.1038/nmeth1156 [ Links ]
5.Kchouk M, Gibrat J, Elloumi M. Generations of sequencing technologies: From first to next generation. Biol Med. 2017;9(3):1-8. https://doi.org/10.4172/0974-8369.1000395 [ Links ]
6.Suresh PS, Venkatesh T, Tsutsumi R, Shetty A. Next-generation sequencing for endocrine cancers: Recent advances and challenges. Tumor Biol. 2017;39(5):1-11. [ Links ]
7.Wetterstrand KA. DNA sequencing costs: Data from the NHGRI Genome Sequencing Program (GSP) [homepage on the Internet]. 2019 [cited 2020 Mar 06]. Available from: https://www.genome.gov/about-genomics/fact-sheets/DNA-Sequencing-Costs-Data [ Links ]
8.Ho SS, Urban AE, Mills RE. Structural variation in the sequencing era. Nature Research. 2020;21:171-89. Available from: https://www.nature.com/articles/s41576-019-0180-9 [ Links ]
9.Kraft F, Kurth I. Long-read sequencing in human genetics. Medizinische Genet. 2019;31:198-204. https://doi.org/10.1007/s11825-019-0249-z [ Links ]
10.Amarasinghe SL, Su S, Dong X, Zappia L, Ritchie ME, Gouil Q. Opportunities and challenges in long-read sequencing data analysis. Genome Biol. 2020;21(30):1-16. https://doi.org/10.1186/s13059-020-1935-5 [ Links ]
11.Berman K. Genome sequencing stocks on the rise [homepage on the Internet]. Forbes; 2019 [cited 2020 Mar 06]. Available from: https://www.forbes.com/sites/kenberman/2019/02/21/genome-sequencing-stocks-on-the-rise/#76a851951f51 [ Links ]
12.Illumina, PacBio Scrap $1.2B Merger, Citing 'Continued Uncertainty' [homepage on the Internet]. Genetic Engineering and Biotechnology News; 2020 [cited 2020 Mar 06]. Available from: https://www.genengnews.com/news/illumina-pacbio-scrap-1-2b-merger-citing-continued-uncertainty/ [ Links ]
Correspondence:
Boluwatife Adewale
boluadeleye03@gmail.com
Received: 18 July 2020
Accepted: 07 Sept. 2020
Published: 26 Nov. 2020
BRIEF REPORT
Rapid testing for respiratory syncytial virus in a resource-limited paediatric intensive care setting
Howard NewmanI, II, III; Donald TshabalalaIV, V; Sikhumbuzo MabundaVI, VII; Nokwazi NkosiII, VIII; Candice CarelsonI
INational Health Laboratory Service, Virology, Port Elizabeth, South Africa
IIDepartment of Pathology, Division of Medical Virology, Stellenbosch University, Cape Town, South Africa
IIIFaculty of Health Sciences, Nelson Mandela University, Port Elizabeth, South Africa
IVDepartment of Paediatrics, Nelson Mandela Academic Hospital, Mthatha, South Africa
VDepartment of Paediatrics, Walter Sisulu University, Mthatha, South Africa
VIDepartment of Public Health, Walter Sisulu University, Mthatha, South Africa
VIIMpumalanga Department of Health, Nelspruit, South Africa
VIIINational Health Laboratory Service, Tygerberg Academic Hospital, Cape Town, South Africa
ABSTRACT
We analysed the performance characteristics of the respiratory syncytial virus lateral flow rapid antigen assay in use when compared to a multiplex polymerase chain reaction for detection of respiratory viruses. The study was conducted at a tertiary paediatric hospital in Port Elizabeth, South Africa, from 01 January 2017 to 31 December 2018. We found the clinical sensitivity (36.8%) of the rapid test to be too low for routine diagnostic use. Knowledge of assay performance characteristics of rapid tests are important for appropriate interpretation of rapid test results.
Keywords: respiratory syncytial virus; rapid antigen tests; respiratory viruses; respiratory multiplex polymerase chain reaction; assay performance characteristics.
Introduction
Respiratory syncytial virus (RSV) infection is a common cause of casualty visits and hospital admissions in infants.1,2,3,4 In 2005, a meta-analysis reported that between 66 000 and 160 000 children under age 5 years died of RSV infection worldwide.4
During the South African RSV season, 50% - 60% of all respiratory admissions in children are due to RSV.5 Data from the 2016 pneumonia surveillance programme in South Africa showed that 17% of enrolled patients tested positive for RSV, with a case fatality rate of less than 1%.6
RSV is highly contagious and numerous hospital outbreaks have been reported in multiple age groups,7 thus necessitating appropriate infection prevention and control measures. For timeous initiation of appropriate infection prevention and control measures, rapid laboratory confirmation of RSV is essential.
Options for laboratory testing include virus isolation, rapid antigen tests, direct fluorescent antibody tests and molecular methods such as polymerase chain reaction (PCR).8,9 Rapid assays utilising antigen capture technology, that can be performed in less than 30 min, are available.10 Numerous commercial assays exist, ranging in sensitivity from approximately 50% to 96% in children, while the majority of assays have specificity above 97%.1,11,12,13,14,15,16 The sensitivity of rapid antigen assays for RSV is affected by several factors; decreased sensitivity was noted in patients with a prolonged duration of symptoms at the time of testing, infection with subtype B, and older age.13,14,15,16
Nucleic acid amplification tests have been shown to be superior to classical methods such as virus isolation and direct fluorescent antibody testing.17,18 Not only is PCR more sensitive and specific than conventional methods, but it is also more amenable to 'multiplexing', thus allowing for the simultaneous detection of a panel of common respiratory viruses.19 One limitation of molecular testing is its potentially prohibitive cost. This is of particular concern in resource-limited settings. In addition, the laboratory turn-around time may not be rapid enough to aid clinical decision making, especially when samples have to be referred to distant laboratories.20
The commercial rapid antigen RSV assay used in the virology laboratory of the National Health Laboratory Service in Port Elizabeth, South Africa, is the RSV Respi-Strip by Coris BioConcept (Gembloux, Belgium). It has a reported sensitivity of approximately 80%, with a specificity of greater than 95%.16 When compared to direct fluorescent antibody tests, the RSV Respi-Strip was found to be 92% sensitive and 98% specific.21 If the reported sensitivity of the assay of 80% is accurate, while not ideal, this may still be a clinically useful test in resource-limited settings, since positive cases would be detected 80% of the time, allowing for patient cohorting and isolation, and thereby limiting nosocomial transmission.7
For respiratory multiplex PCR testing, the virology laboratory in Port Elizabeth refers specimens to another National Health Laboratory Service virology laboratory at Tygerberg Hospital in Cape Town, South Africa. This laboratory makes use of the Seeplex® RV16 assay by Seegene (Seoul, South Korea). The sensitivity and specificity for the individual viruses varies. For RSV, the sensitivity and specificity is reported to be above 90% when compared with singleplex or duplex PCR.17
Since patients admitted to our paediatric intensive care unit (ICU) for suspected lower respiratory tract infection are all tested for RSV with a rapid antigen assay, in addition to testing for a panel of common respiratory viruses (including RSV subtypes A and B) by PCR, we compared the two assays to determine the sensitivity and specificity of the RSV Respi-Strip assay. We additionally sought to describe the common respiratory viruses detected in our ICU setting.
Methods
Ethical considerations
This study received ethical clearance from the Human Research Committee of the Faculty of Health Sciences, Walter Sisulu University (reference 043/2018).
Study design
This was a descriptive, retrospective cross-sectional study analysing laboratory reports for RSV rapid antigen and multiplex PCR tests for respiratory viruses. Results from the RSV rapid antigen assay were compared to results from the multiplex PCR assay, thus allowing for the calculation of performance characteristics of the rapid antigen assay. Factors associated with false-negative RSV rapid antigen results were analysed.
Sample selection
The study population comprised all paediatric patients admitted to ICU at Dora Nginza Hospital in Port Elizabeth, Eastern Cape Province, South Africa, who had respiratory samples taken for laboratory investigation of viral infections from 1 January 2017 to 31 December 2018. Rapid testing for RSV is performed locally by the virology laboratory of the National Health Laboratory Service in Port Elizabeth, South Africa, with the nasopharyngeal aspirates being the specimen matrix. In addition, remnant specimen is referred to another virology laboratory (Cape Town, South Africa) within the National Health Laboratory Service, for multiplex PCR. This allowed for retrospective analysis of laboratory data.
Data analysis
All variables were captured and coded in Microsoft Excel 2013 (Microsoft Corporation, Seattle, Washington, United States) and exported to Stata 14.1 for analysis (Stata Corp LP, College Station, Texas, United States). The distribution of age in days (numerical variable) was explored using the Shapiro Wilk test, and age was further converted into a categorical variable in months.
Clinical sensitivity and specificity of the RSV Respi-Strip rapid antigen assay was calculated by comparison against the multiplex PCR (Seeplex® RV16).
Categorical variables are presented using frequency tables, percentages and graphs. Bivariate logistic regression models were used to determine associations of false RSV rapid antigen results with risk factors such as age, sex, HIV co-infection, RSV subtype, and co-infections with other viruses or bacteria. The odds ratio was the relative measure of association used. The 95% confidence interval was used to estimate the precision of estimates. The level of statistical significance was set at 5% (p-value ≤ 0.05).
Results
Test reports from a total of 152 participants were obtained and included in the study. Eighty-one of the participants (53.3%) were female, and 121 were under the age of one year. Table 1 shows all the demographic characteristics considered during this study.

Results from the multiplex PCR assay show that rhinovirus was the most common virus detected (n = 55), followed by adenovirus (n = 30), RSV (n = 19) and enterovirus (n = 17), with the remainder of the viruses occurring less commonly (Figure 1). Respiratory syncytial virus subtype A was detected much more frequently than subtype B.

When comparing the RSV rapid antigen assay to the multiplex PCR assay, the former was found to be 36.8% sensitive (Table 2).

When analysing factors associated with false-negative RSV rapid antigen results, only viral-viral co-infection and infection with RSV subtype A were statistically significant associations (Table 3).

Discussion
To the best of our knowledge, this is the first study comparing a RSV rapid antigen assay to a multiplex PCR assay that includes RSV as a target. In addition, it is also the first study to report on the prevalence of the common respiratory viruses found in our local paediatric ICU. We found the clinical sensitivity of the RSV rapid antigen assay (RSV Respi-Strip by Coris BioConcept) to be 36.84%; rhinovirus was the most commonly detected virus on the respiratory multiplex PCR assay. Although the majority of respiratory admissions worldwide are due to RSV,5 the most common viruses detected in our setting were rhinovirus (n = 55) and adenovirus (n = 30), followed by RSV (n = 19) and enterovirus (n = 17).
The main aim of this study was to determine the performance characteristics of the RSV rapid antigen assay in use (RSV Respi-Strip) by comparison to the respiratory multiplex PCR assay (Seeplex® RV16 assay), which includes RSV as a target. The sensitivity of the RSV rapid antigen assay was found to be 36.84% (confidence interval: 16.29% - 61.64%). Even at the upper end of the confidence interval, this sensitivity is too low for routine diagnostic use. While the specificity of above 90% may be sufficient for a rapid antigen assay, the low sensitivity would have resulted in many cases being undiagnosed, thus defeating the main purpose of using a rapid test, which is to allow for early institution of infection prevention and control measures to mitigate against the well-known nosocomial outbreak risk.7 Potential reasons for the discrepancy in performance of this rapid test in our setting compared to the manufacturer's claims are manifold. Rapid antigen assays are generally less sensitive than PCR. This can be compounded by low viral loads in the clinical samples, as may be the case with upper respiratory tract infections only. It was beyond the scope of this study to differentiate patients based on severity of disease. The relatively small sample size may also account for the discrepancy in clinical sensitivity.
The bivariate logistic regression analysis revealed a statistically significant association between false-negative RSV rapid antigen tests and viral co-infection, and infection with RSV subtype A. In contrast, a previous study showed that infection with RSV subtype B was associated with decreased sensitivity of rapid antigen assays.15
Cytomegalovirus and HIV positivity were more likely to be associated with false RSV rapid antigen results, as well as more likely to be associated with false-negative results specifically. Neither of these associations was statistically significant.
Limitations
The main limitation of this study is the small sample size as a result of resource constraints, resulting in wider-than-ideal confidence intervals in the calculation of clinical sensitivity of the RSV rapid antigen test. However, even at the upper limit of the confidence intervals, the main conclusion that the sensitivity and positive predictive value are not acceptable for routine diagnostic use, still holds.
Conclusion
This study highlights the importance of ongoing monitoring of newly introduced assays, as verification experiments may not always determine whether an assay will perform optimally in real-world conditions. Based on the results of this study, the RSV rapid antigen assay in use (RSV Respi-Strip) was discontinued due to an unacceptably high rate of false results.
In conclusion, we have demonstrated the common respiratory viruses found in our local paediatric ICU setting. In addition, we report on the poor performance of the RSV rapid antigen assay in use and the potential factors associated with false results, with only viral co-infections and infection with RSV subtype A being statistically significant.
Clinicians should have an idea of the sensitivity and specificity of the rapid tests in use to allow for the appropriate interpretation of results.
Acknowledgements
We would like to express our gratitude to all the staff at the Virology Laboratory of the National Health Laboratory Service, Port Elizabeth, South Africa, who assisted in collection of data.
Competing interests
The authors have declared that no competing interests exist.
Authors' contributions
H.N. initiated the study. D.T., S.M., N.N. and C.C. assisted in producing the protocol. D.T. oversaw the ethics application. C.C. and H.N. handled the data collection. S.M. performed the data analysis. H.N., D.T., S.M., N.N. and C.C. wrote and revised the manuscript.
Sources of support
This research received no specific grant from any funding agency in the public, commercial, or not-for-profit sectors.
Data availability statement
Data sharing is not applicable to this article as no new data were created or analysed in this study.
Disclaimer
The views and opinions expressed in this article are those of the authors and do not necessarily reflect the official policy or position of any affiliated agency of the authors.
References
1.Chartrand C, Tremblay N, Renaud C, Papenburg J. Diagnostic accuracy of rapid antigen detection tests for respiratory syncytial virus infection: Systematic review and meta-analysis. J Clin Microbiol. 2015;53(12):3738-3749. https://doi.org/10.1128/JCM.01816-15 [ Links ]
2.Green RJ, Zar HJ, Jeena PM, Madhi SA, Lewis H. South African guideline for the diagnosis, management and prevention of acute viral bronchiolitis in children. S Afr Med J. 2010;100(5):320-325. https://doi.org/10.7196/SAMJ.4016 [ Links ]
3.Madhi SA, Cutland CL, Downs S, et al. Burden of respiratory syncytial virus infection in South African human immunodeficiency virus (HIV)-infected and HIV-uninfected pregnant and postpartum women: A longitudinal cohort study. Clin Infect Dis. 2018;66(11):1658-1665. https://doi.org/10.1093/cid/cix1088 [ Links ]
4.Nair H, Nokes DJ, Gessner BD, et al. Global burden of acute lower respiratory infections due to respiratory syncytial virus in young children: A systematic review and meta-analysis. Lancet. 2010;375(9725):1545-1555. https://doi.org/10.1016/S0140-6736(10)60206-1 [ Links ]
5.Moyes J, Cohen C, Pretorius M, et al. Epidemiology of respiratory syncytial virus-associated acute lower respiratory tract infection hospitalizations among HIV-infected and HIV-uninfected South African children, 2010-2011. J Infect Dis. 2013;208(Suppl. 3):S217-S226. https://doi.org/10.1093/infdis/jit479 [ Links ]
6.Walaza S, Cohen C, Treurnicht F, et al. Epidemiology of respiratory pathogens from influenza-like illness and pneumonia surveillance programmes, South Africa, 2016. Commun Dis Surveill Bull NICD. 2017;15(1):9-25. [ Links ]
7.French CE, McKenzie BC, Coope C, et al. Risk of nosocomial respiratory syncytial virus infection and effectiveness of control measures to prevent transmission events: A systematic review. Influ Other Respir Viruses. 2016;10(4):268-290. https://doi.org/10.1111/irv.12379 [ Links ]
8.Ahluwalia G, Embree J, McNicol P, Law B, Hammond GW. Comparison of nasopharyngeal aspirate and nasopharyngeal swab specimens for respiratory syncytial virus diagnosis by cell culture, indirect immunofluorescence assay, and enzyme-linked immunosorbent assay. J Clin Microbiol. 1987;25(5):763-767. https://doi.org/10.1128/JCM.25.5.763-767.1987 [ Links ]
9.Griffiths C, Drews SJ, Marchant DJ. Respiratory syncytial virus: Infection, detection, and new options for prevention and treatment. Clin Microbiol Rev. 2017;30(1):277-319. https://doi.org/10.1128/CMR.00010-16 [ Links ]
10.Aslanzadeh J, Zheng X, Li H, et al. Prospective evaluation of rapid antigen tests for diagnosis of respiratory syncytial virus and human metapneumovirus infections. J Clin Microbiol. 2008;46(5):1682-1685. https://doi.org/10.1128/JCM.00008-08 [ Links ]
11.Leonardi GP, Wilson AM, Dauz M, Zuretti AR. Evaluation of respiratory syncytial virus (RSV) direct antigen detection assays for use in point-of-care testing. J Virol Methods. 2015;213:131-134. https://doi.org/10.1016/j.jviromet.2014.11.016 [ Links ]
12.Cruz AT, Cazacu AC, Greer JM, Demmler GJ. Performance of a rapid assay (Binax NOW) for detection of respiratory syncytial virus at a children's hospital over a 3-year period. J Clin Microbiol. 2007;45(6):1993-1995. https://doi.org/10.1128/JCM.00279-07 [ Links ]
13.Miernyk K, Bulkow L, DeByle C, et al. Performance of a rapid antigen test (Binax NOW® RSV) for diagnosis of respiratory syncytial virus compared with real-time polymerase chain reaction in a pediatric population. J Clin Virol. 2011;50(3):240-243. https://doi.org/10.1016/j.jcv.2010.11.011 [ Links ]
14.Schauer U, Ihorst G, Rohwedder A, et al. Evaluation of respiratory syncytial virus detection by rapid antigen tests in childhood. Klin Padiatr. 2007;219(4):212-216. https://doi.org/10.1055/s-2006-933530 [ Links ]
15.Papenburg J, Buckeridge DL, De Serres G, Boivin G. Host and viral factors affecting clinical performance of a rapid diagnostic test for respiratory syncytial virus in hospitalized children. J Pediatr. 2013;163(3):911-913. https://doi.org/10.1016/j.jpeds.2013.03.067 [ Links ]
16.Blyth CC, Booy R, Dwyer DE. Point of care testing: Diagnosis outside the virology laboratory. In: Stephenson JR, Warnes A, editors. Diagnostic virology protocols. Methods in molecular biology, Vol. 665. New Jersey: Humana Press, 2011; pp. 415-433. https://doi.org/10.1007/978-1-60761-817-1 [ Links ]
17.Pillet S, Lardeux M, Dina J, et al. Comparative evaluation of six commercialized multiplex PCR kits for the diagnosis of respiratory infections. PLoS One. 2013;8(8):e72174. https://doi.org/10.1371/journal.pone.0072174 [ Links ]
18.Gharabaghi F, Hawan A, Drews SJ, Richardson SE. Evaluation of multiple commercial molecular and conventional diagnostic assays for the detection of respiratory viruses in children. Clin Microbiol Infect. 2011;17(12):1900-1906. https://doi.org/10.1111/j.1469-0691.2011.03529.x [ Links ]
19.Somerville LK, Ratnamohan VM, Dwyer DE, Kok J. Molecular diagnosis of respiratory viruses. Pathology. 2015;47(3):243-249. https://doi.org/10.1097/PAT.0000000000000240 [ Links ]
20.Mills JM, Harper J, Broomfield D, Templeton KE. Rapid testing for respiratory syncytial virus in a paediatric emergency department: Benefits for infection control and bed management. J Hosp Infect. 2011;77(3):248-251. https://doi.org/10.1016/j.jhin.2010.11.019 [ Links ]
21.Gregson D, Lloyd T, Buchan S, Church D. Comparison of the RSV respi-strip with direct fluorescent-antigen detection for diagnosis of respiratory syncytial virus infection in pediatric patients. J Clin Microbiol. 2005;43(11):5782-5783. https://doi.org/10.1128/JCM.43.11.5782-5783.2005 [ Links ]
Correspondence:
Howard Newman
howardnewman@vpath.org
Received: 27 Aug. 2019
Accepted: 12 Aug. 2020
Published: 08 Dec. 2020
EDITORIAL
African laboratory medicine in the time of COVID-19
Iruka N. Okeke
Department of Pharmaceutical Microbiology, Faculty of Pharmacy, University of Ibadan, Ibadan, Nigeria
2020 has been a turbulent year but one that fixed the importance of laboratory medicine in the eye of the global public. Public health experts' worst fears surrounding a hypothetical 'Agent X' that spurred thousands of calls for 'pandemic preparedness' in the last half-decade have become eerily true and the importance of 'testing' is now broadly acknowledged. By the end of the first quarter of 2020, following its emergence in Wuhan, China, Agent X was named severe acute respiratory syndrome coronavirus 2 (SARS-CoV-2); it had caused infections in almost every country, and one of the worst pandemics of all time was underway (Figure 1). Instituting SARS-CoV-2 testing rapidly and reliably was one of the pivotal distinguishers between countries that got a handle on their coronavirus disease 2019 (COVID-19) epidemics and those that did not.

No country in the world was ready by the time COVID-19 overwhelmed each national surveillance and health system. Across Africa, pandemic response planning began early and, as SARS-CoV-2 entered our continent relatively late, most African countries were able to deploy testing before the virus arrived.1,2 To their tremendous credit, African countries leveraged this testing advantage to implement pandemic infection control policies that likely combined with as yet unknown biological features to yield what are still now relatively temperate versions of COVID-19 devastation. African countries have also continued to grow testing capacity so that, while we are not the necessary step ahead of the virus, most countries in Africa are, to some degree, keeping pace with it.
National epidemic responses depend on very local activities. Published this year in the African Journal of Laboratory Medicine (AJLM) is an exemplary local response to a COVID-19 crisis in an African SARS-CoV-2 testing laboratory. The crisis was a laboratory outbreak that not only endangered the medical laboratory scientists, but also disabled the testing service when the need was greatest.3 Among other things, the affected laboratory implemented heightened infection prevention and control measures and increased physical distancing. It also increased automation of sample processing, which reduced contact between staff and infected specimens, and will improve operations in the years to come. As another article from Skosana et al.4 demonstrates, workplace infections are an ever-present risk in laboratories and so lessons learned from this pandemic will have broad application.
At the patient level, a significant proportion of COVID-19 survivors live for months with disabling sequelae in 'long-COVID'; the ultimate prognosis for this new disease remains unclear.5 COVID-19 also has unclear long-haul implications on communities, on countries and on healthcare systems and their laboratories. The pandemic is a frontal challenge to weak systems, but it also offers opportunities to develop them and build resilience, if the response is implemented with this in mind.6 For example, future procurement could be templated on more generally applicable network approaches to procurement and supply chain management outlined by Williams et al. for HIV, forestalling the procurement crises experienced in Africa with COVID-19 testing and personal protective equipment supplies.7,8
SARS-CoV-2 is not the only epidemic pathogen that circulated in Africa in 2020. The Democratic Republic of Congo declared a 21-month Ebola outbreak that ended on 14 May 2020, but on 01 June 2020, a new outbreak began. Nigeria has worked to contain Lassa fever virus epidemics for most of the duration of the COVID-19 pandemic. While these three feared viruses ravage, measles, cholera and other epidemics are also in play.8 One of the things that has become increasingly visible in the course of these epidemics is the central role laboratory medicine must play to contain them. Volume 9, Issue 1 of AJLM goes beyond chronicling a broad range of infectious disease catastrophes to outlining lessons learned that will strengthen health systems.3,9,10,11,12,13,14,15,16,17,18 While most pandemic activity has focused on reverse transcription polymerase chain reaction and other forms of testing to support the identification of cases and transmission chains,10 other domains of laboratory medicine have made important contributions that shed more light on the pathogenesis of the disease, and therefore how best to improve treatment.19,20
As clinical and laboratory health workers and the scientific community engaged in discoveries to combat the pandemic, another equally frenetic behind-the-scenes response took place in editorial offices as we, gratefully helped by volunteer reviewers, struggled under the mound of COVID-19 submissions to bring to the fore discoveries that are most worthy of priority and long-term attention. In mid-May, relatively early in the pandemic, a Science commentary reported that COVID-19 researchers and policymakers were becoming overwhelmed by the literature in this brand new field with a 20-day doubling time on the number of articles indexed by major databases.21 By early November, that curve had flattened somewhat but, still, over 70 000 COVID-19 articles were indexed in PubMed or posted on pre-print servers, awaiting assessment. The flood has spurred the creation of artificial intelligence approaches for curating the literature.21 But the bulk of the work required to review, improve and present these works to the drowning community is done manually by editors and volunteer reviewers. Unsurprisingly, the pandemic has seen highly publicised discourse on research article quality, as well as some very high-profile retractions. The strain on peer review has also led to some misleading information driving COVID-19 policy, prevention and therapeutics, some of which have been amplified by influential non-scientists. Among the many lessons learned on the fly in this pandemic is that health crises bring an influx of emergency-care patients, specimens requiring immediate testing and a flood of literature. Resilience is needed as much in scientific publishing as in health systems. Pandemic preparedness must include plans for rapidly but effectively sifting through the literature flood to retrieve the knowledge most likely to reign in the emergency, which is the only way to stop the overwhelm on both fronts.
As a regional journal addressing laboratory medicine on a continent that has seen multiple epidemics this year, we at AJLM quickly found that our standard workflows would not manage submissions fast and rigorously enough for a helpful pandemic response. At the same time, it was important for us to continue to process manuscripts across the journal's scope. We did manage to ensure that the journal could contribute in valuable ways towards addressing the pandemic while at the same time ensuring that important articles not focused on the pressing problem of COVID-19 were published. Indeed, by responding to COVID-19 but not succumbing to 'COVIDdisation',22 we observed that articles submitted before the pandemic was declared were key to the COVID-19 response. Among these are the Future of Diagnostics special issue article by Preiser and Van Zyl23 on pooled testing, with a focus on HIV, which included critical knowledge for aligning test-and-trace COVID-19 needs with the extreme resource limitations that almost every country has seen associated with polymerase chain reaction testing. Additional articles in that special issue also have direct relevance to strengthening testing capabilities in the pandemic.24,25
To meet the double demands of maintaining peer review and production of regular articles, the submission rate of which continues to rise, and processing pandemic submissions, the pandemic pushed us to alter our operations. AJLM's new normal allows for a regular submission track, and a new fast track for articles containing knowledge that could be applied to the ongoing COVID-19, Lassa fever and Ebola haemorrhagic fever outbreaks. This year, these ran in addition to the call to our special issue (Volume 9, Issue 2) on the future of diagnostics, which was guest edited by Timothy Amukele, Noah Fongwen and Rosanna Peeling.26 Our fast track remains open and will include the many excellent articles we are processing now for Volume 10.
Altogether, AJLM received 47 submissions through its viral epidemic fast track between April 2020 when we opened the track and October of the same year. Only two of these epidemic articles addressed Lassa fever, and none addressed Ebola haemorrhagic fever, pointing to the disproportionately low scientific activity on local African epidemics. So far, just 10 of the COVID-19 fast-tracked articles have been accepted. This acceptance rate compares with that for regular submissions but is unexpectedly low, because we expected predominantly pressing issues worthy of publication to come via the fast track. Similar high submission, low acceptance rates have been reported by editors of other journals.27
Do the low acceptance rates make all the extra hard work done on pandemic submissions by the editorial offices worth it? This question is important to us, because all three epidemics are still in play, our journal's overall submission rate has continued to rise and our fast track is still open. The answer is undoubtedly yes. Firstly, by overseeing the peer review of the manuscripts we received, we did help to shield frontline health workers and policymakers from the even larger deluge of COVID-19 preprints that they would otherwise have had to navigate. This is an important function of peer review in general. Secondly and more pointedly, we are proud to be publishing key articles that influence the course of the pandemic, particularly on the African continent, where the dynamics are different, the response, while variable, is largely commendable and resources are severely limited. Given the sacrifices made in so many areas towards containing this pandemic, this is the least we could do.
Acknowledgements
I thank the authors, reviewers, editorial office and publishers' staff that made African Journal of Laboratory Medicine's necessary capacity surge in this pandemic possible. I am also grateful to frontline medical laboratory science and other health professionals for their selfless service through this pandemic.
Competing interests
The author has declared that no competing interests exist.
Author's contributions
I conceived and wrote the editorial.
Disclaimer
The views and opinions expressed in this article are those of the author and do not necessarily reflect the official policy or position of any affiliated agency of the author.
References
1.Kapata N, Ihekweazu C, Ntoumi F, et al. Is Africa prepared for tackling the COVID-19 (SARS-CoV-2) epidemic. Lessons from past outbreaks, ongoing pan-African public health efforts, and implications for the future. Int J Infect Dis. 2020;93:233-236. https://doi.org/10.1016/j.ijid.2020.02.049 [ Links ]
2.Senghore M, Savi MK, Gnangnon B, Hanage WP, Okeke IN. Leveraging Africa's preparedness towards the next phase of the COVID-19 pandemic. Lancet Glob Health. 2020;8(7):e884-e885. https://doi.org/10.1016/S2214-109X(20)30234-5 [ Links ]
3.Opperman CJ, Marais GJK, Naidoo M, Hsiao M, Samodien N. Response to a cluster of Severe Acute Respiratory Syndrome Coronavirus 2 cases at a diagnostic laboratory. Afr J Lab Med. 2020;9(1):a1307. https://doi.org/10.4102/ajlm.v9i1.1307 [ Links ]
4.Skosana L, Ismail F, Mbelle N, Said M. Brucellosis - Laboratory workers' nightmare come true: A case study. Afr J Lab Med. 2020;9(1):a1114. https://doi.org/10.4102/ajlm.v9i1.1114 [ Links ]
5.Honigsbaum M, Krishnan L. Taking pandemic sequelae seriously: From the Russian influenza to COVID-19 long-haulers. Lancet. 2020;396(10260):1389-1391. https://doi.org/10.1016/S0140-6736(20)32134-6 [ Links ]
6.Umaru FA. Scaling up testing for COVID-19 in Africa: Responding to the pandemic in ways that strengthen health systems. Afr J Lab Med. 2020;9(1):a1244. https://doi.org/10.4102/ajlm.v9i1.1244 [ Links ]
7.Nkengasong JN, Mankoula W. Looming threat of COVID-19 infection in Africa: act collectively, and fast. Lancet. 2020;395(10227):841-842. https://doi.org/10.1016/S0140-6736(20)30464-5 [ Links ]
8.Nkengasong JN, Tessema SK. Africa needs a new public health order to tackle infectious disease threats. Cell. 2020;183(2):296-300. https://doi.org/10.1016/j.cell.2020.09.041 [ Links ]
9.Egyir B, Obeng-Nkrumah N, Kyei GB. COVID-19 pandemic and antimicrobial resistance: Another call to strengthen laboratory diagnostic capacity in Africa. Afr J Lab Med. 2020;9(1):a1302. https://doi.org/10.4102/ajlm.v9i1.1302 [ Links ]
10.Olalekan A, Iwalokun B, Akinloye OM, Popoola O, Samuel TA, Akinloye O. COVID-19 rapid diagnostic test could contain transmission in low- and middle-income countries. Afr J Lab Med. 2020;9(1):a1255. https://doi.org/10.4102/ajlm.v9i1.1255 [ Links ]
11.Mitton B, Rule R, Mbelle N, Van Hougenhouck-Tulleken W, Said M. Post-procedural Bacillus cereus septic arthritis in a patient with systemic lupus erythematosus. Afr J Lab Med. 2020;9(1):a1119. https://doi.org/10.4102/ajlm.v9i1.1119 [ Links ]
12.Govender S, Mbambo L, Nyirenda M, Sebitloane M, Abbai N. Herpes simplex virus-2 infections in pregnant women from South Africa: Evaluation of the ImmunoFLOW rapid test. Afr J Lab Med. 2020;9(1):a854. https://doi.org/10.4102/ajlm.v9i1.854 [ Links ]
13.Haumba SM, Toda M, Jeffries R, et al. Prevalence of cryptococcal antigen (CrAg) among HIV-positive patients in Eswatini, 2014-2015. Afr J Lab Med. 2020;9(1):a933. https://doi.org/10.4102/ajlm.v9i1.933 [ Links ]
14.Madeira CM, Azam KI, Sato DN, Khosa C, Bhatt N, Viegas SO. Evaluation of the Ogawa-Kudoh method for tuberculosis isolation in two health units in Mozambique. Afr J Lab Med. 2020;9(1):a929. https://doi.org/10.4102/ajlm.v9i1.929 [ Links ]
15.Pasipamire M, Broughton E, Mkhontfo M, Maphalala G, Simelane-Vilane B, Haumba S. Detecting tuberculosis in pregnant and postpartum women in Eswatini. Afr J Lab Med. 2020;9(1):a837. https://doi.org/10.4102/ajlm.v9i1.837 [ Links ]
16.Sayed S, Mutasa R, Kaaya E, et al. Establishing the College of Pathologists of East, Central and Southern Africa - The Regional East Central and Southern Africa College of Pathology. Afr J Lab Med. 2020;9(1):a979. https://doi.org/10.4102/ajlm.v9i1.979 [ Links ]
17.Mudenda V, Malyangu E, Sayed S, Fleming K. Addressing the shortage of pathologists in Africa: Creation of a MMed programme in pathology in Zambia. Afr J Lab Med. 2020;9(1):a974. https://doi.org/10.4102/ajlm.v9i1.974 [ Links ]
18.Demba RN, Aradi SM, Mwau M, Mwanda WO. Kaposi's sarcoma-associated herpesvirus protein ORF75 among HIV-1 patients in Kenya. Afr J Lab Med. 2020;9(1), a939. https://doi.org/10.4102/ajlm.v9i1.939 [ Links ]
19.Attoh SA, Hobenu F, Edusei L, et al. Postmortem diagnosis of COVID-19: Antemortem challenges of three cases at the 37 Military Hospital, Accra, Ghana. Afr J Lab Med. 2020;9(1):a1290. https://doi.org/10.4102/ajlm.v9i1.1290 [ Links ]
20.Admou B, Hachimi A, Samkaoui MA. How can clinical immunology laboratories contribute to the management of severe COVID-19 cases in limited resource contexts? Afr J Lab Med. 2020;9(1), a1282. https://doi.org/10.4102/ajlm.v9i1.1282 [ Links ]
21.Brainard J. Scientists are drowning in COVID-19 papers. Can new tools keep them afloat. Science. 2020 (13 May). https://doi.org/10.1126/science.abc7839 [ Links ]
22.Pai M. Covidization of research: What are the risks? Nat Med. 2020;26(8):1159. https://doi.org/10.1038/s41591-020-1015-0 [ Links ]
23.Preiser W, Van Zyl GU. Pooled testing: A tool to increase efficiency of infant HIV diagnosis and virological monitoring. Afr J Lab Med. 2020;9(2):a1035. https://doi.org/10.4102/ajlm.v9i2.1035 [ Links ]
24.Emperador DM, Mazzola LT, Kelly-Cirino C. An open-source molecular diagnostic platform approach for outbreak and epidemic preparedness. Afr J Lab Med. 2020;9(2):a1017. https://doi.org/10.4102/ajlm.v9i2.1017 [ Links ]
25.Naidoo D, Ihekweazu C. Nigeria's efforts to strengthen laboratory diagnostics - Why access to reliable and affordable diagnostics is key to building resilient laboratory systems. Afr J Lab Med. 2020;9(2):a1019. https://doi.org/10.4102/ajlm.v9i2.1019 [ Links ]
26.Fongwen N, Boeras D, Peeling RW, Amukele T. Connected Diagnostics Systems: The Future of Disease Control in Africa. Afr J Lab Med. 2020;9(2):a1365. In press. [ Links ]
27.The Lancet Global Health. Publishing in the time of COVID-19. Lancet Glob Health. 2020;8(7):e860. https://doi.org/10.1016/S2214-109X(20)30260-6 [ Links ]
Correspondence:
Iruka Okeke
iruka.n.okeke@gmail.com
ORIGINAL RESEARCH
Prevalence and antifungal susceptibility of gastrointestinal candidiasis among diabetic patients: A cross-sectional study
Anthony P. OyomI; Emmanuel OkelloI; Victoria AcamI; Christine AramoI; Bashir MwambiI; John C. OkiriaII; Caesar OyetI
IDepartment of Medical Laboratory Sciences, Faculty of Allied Health, Clarke International University (formerly International Health Sciences University), Kampala, Uganda
IIDepartment of Clinical Medicine and Community Health, Faculty of Allied Health, Clarke International University (formerly International Health Sciences University), Kampala, Uganda
ABSTRACT
BACKGROUND: Gastrointestinal candidiasis is the most predominant opportunistic human mycosis, especially in diabetic patients. There is a global increase in antifungal resistance coupled with a rarity of information on antifungal susceptibility profiles in Uganda.
OBJECTIVE: This study aimed to determine the occurrence and antifungal susceptibility of gastrointestinal candidiasis in diabetic patients.
METHODS: Stool and fasting blood specimens were obtained from randomly sampled consenting patients with diabetes mellitus at St. Francis Hospital Nsambya in Kampala, Uganda to determine Candida infection, fasting blood glucose and glycated haemoglobin levels. Susceptibility testing was performed on Muller Hilton agar supplemented with 2% glucose and 0.2 µg of methylene blue, using the E-test diffusion method.
RESULTS: Among the 241 patients included in the analyses, the overall prevalence of gastrointestinal candidiasis was 15.4% (n = 37). Candida albicans (62.16%, n = 23) was the predominant species, followed by Candida glabrata (18.92%, n = 7), Candida tropicalis (8.11%, n = 3), Candida krusei (5.41%, n = 2) and Candida dublinensis (5.41%, n = 2). Resistance was observed with miconazole (48.65%), clotrimazole (18.92%) and fluconazole (8.11%). No resistance to itraconazole and nystatin was observed. Gastrointestinal candidiasis was associated with poor glucose control (p ≤ 0.001), prior use of antibiotics (p ≤ 0.001), antifungals (p ≤ 0.001) and corticosteroids (p ≤ 0.001) and was more common among female patients (p = 0.01).
CONCLUSION: Occurrence of gastrointestinal candidiasis was relatively low among our participants, and infection was associated with poor glucose control, female sex and use of antifungals, antibiotics and corticosteroids
Keywords: candidiasis; diabetes; gastrointestinal; antifungal; susceptibility.
Introduction
Candida species reside in the human gastrointestinal tract as part of the body's microbiota. Due to changes in host environment (such as immunosuppression, metabolic imbalances and dysbiosis), they can proliferate as opportunistic pathogens.1,2 They are the predominant cause of opportunistic human mycoses, and are capable of causing superficial as well as invasive mycoses.3Candida proliferation, especially with heavy growth, within the gut may result in diarrhoea and abdominal discomfort.4,5
Patients with diabetes mellitus (DM) are also susceptible to intestinal candidiasis,6,7 due to the effects of the hyperglycaemic state on the immune system such as dysfunction in the microbicidal activity, chemotaxis and the phagocytosis ability of the neutrophils.8 Additionally, there is increased death of leukocytes and decreased response to moderators of inflammation such as histamine and bradykinin among DM patients,9 resulting in a reduction in the capability of their immune systems to combat gastrointestinal infections.
Any of the Candida species can cause gastrointestinal candidiasis among diabetic patients; however, Candida albicans is the most common.10 Studies reporting prevalence of gastrointestinal candidiasis at the global and continental levels are scarce, and studies in various countries have yielded varying results. In Poland, Kowalewska et al.2 reported a prevalence of gastrointestinal candidiasis to be 75.47% among type 1 DM patients; however, in India, the prevalence varied from 2.45% in North India to 9.7% in Goa.10 A study in Turkey reported prevalence of gastrointestinal candidiasis to be between 25% and 40%.11 A review of studies conducted across the African continent reported a non-uniform prevalence of gastrointestinal candidiasis with a continental prevalence of 12.42% but with a slightly higher prevalence in sub-Saharan Africa at 12.8%.9
The range of antifungal drugs available for treatment of gastrointestinal candidiasis is limited, with azoles, polyenes, allylamines, echinocandins and flucytosine as the available options.3 Both C. albicans and non-albicans Candida species such as Candida tropicalis, Candida glabrata and Cand ida krusei have shown high rates of intrinsic and acquired forms of antifungal resistance.5,12,13,14 There are suggested factors that predispose diabetic patients to gastrointestinal candidiasis and these factors include superimposed immunosuppression, use of steroids, use of antibiotics and poor glycaemic control.15
Despite the increase in the number of patients with DM, a non-communicable disease with the potential to induce conditions that increase the risk of mycosis,3,7 gastrointestinal candidiasis among diabetic patients remains an understudied condition,2,5 with few guidelines on the identification and treatment of such infections.16,17 In Uganda the problem is compounded by a lack of adequate microbiology facilities in most health laboratories, which inhibits the timely diagnosis and treatment of such infections. We aimed to determine antifungal susceptibility of gastrointestinal Candida isolates from DM patients with persistent diarrhoea at St. Francis Hospital Nsambya.
Methods
Ethical considerations
This study was approved by the Institutional Ethics Committee and Institutional Review Board of International Health Sciences University: approval number IHSU-REC/0046. All participants provided written informed consent before the enrolment, and for participants younger than age 18 years, written informed consent was provided by a parent or legal guardian.
Study design
This was a cross-sectional study carried out at the Diabetes Clinic of St. Francis Hospital Nsambya, Kampala, Uganda. Two hundred and eighty DM patients attending the hospital's diabetes treatment clinic were assessed by a medical officer for clinical presentation consistent with diarrhoea.
Inclusion criteria
Patients with diabetes who had signs and symptoms of gastrointestinal infection such as diarrhoea, abdominal pain, bloating and heartburn were consented and enrolled in the study.
Exclusion criteria
Diabetic patients who had other immunosuppressive diseases, chronic diseases and those admitted in wards were not included in the study. Participants were randomly selected and informed consent was obtained as previously described.18,19 Briefly, a list of all the patients attending treatment at the clinic was obtained. Microsoft Excel (Microsoft Corporation, Redmond, Washington, United States) was used to generate numbers ranging between 1 and 500 to three digits. The numbers were typed on cards and the cards were placed in a box. Eligible patients who picked cards with numbers that were multiples of three were enrolled in the study. The cards were reshuffled each time a card was picked and picked cards were not replaced. Where repeated numbers were generated, only one card with such numbers was left in the box.
Data and sample collection
Clinical data were obtained from the consenting participants' medical records for demographic characteristics such as age, sex, type of diabetes and date of diabetes diagnosis plus information on use of antibiotics, corticosteroids, anti-diabetes and antifungal medication. Stool specimens and blood samples were collected from the recruited participants according to the United States Centers for Disease Control and Prevention 2014 guidelines.16 In brief, a sterile, wide-mouthed spoon fitted with a graduated stool container was labelled for each participant and participants were instructed to produce about 10 mL of stool. The specimens were immediately delivered to the laboratory for subsequent analysis. One 4-mL fasting blood specimen was collected from each participant into fluoride/oxalate tubes and the plasma separated from the cells within 30 min after collection.
Sample analyses
Potassium hydroxide wet mounts and smears for Gram staining were prepared from each stool specimen to examine them for Candida blastoconidia and pseudohyphae. Specimens were cultured on Saboraud dextrose agar (Laboratorios Conda, Madrid, Spain) for colony counts and Candida differential agar (Himedia Laboratories, Mumbai, India) for species identification; cultures were incubated at 37 °C for 24-72 h and checked for growth.16 The Germ tube test and growth test at 45 °C were performed to distinguish between C. albicans and C. dublinensis. Colonies on Sabouraud dextrose agar were enumerated and counts above 105 CFU/mL were interpreted as overgrowth indicative of infection, based on reviewed literature.2,16.
Following species identification of isolates, susceptibility testing was performed using the Kirby-Bauer disk diffusion test on a Mueller Hinton agar supplemented with 2% glucose and methylene blue (Himedia Laboratories, Mumbai, India). Inoculum was prepared by picking five distinct colonies of approximately 1 mm from 24-h-old culture grown on Sabouraud dextrose agar. Colonies were suspended in 5 mL of sterile 0.85% saline and turbidity adjusted to 0.5 McFarland standard which corresponds to an approximate yeast density of 1 × 106 to 5 × 106 cells/mL. The surface of the Muller Hilton agar was dried and seeded with the yeast suspension using a sterile cotton swab by streaking the entire agar surface of the plate with the swab three times, turning the plate 60 degrees between each streaking. The inoculum was allowed to dry for 5 min - 15 min with the lid in place, the antifungal discs were placed on the agar surface aseptically and then the plates were incubated at 35 °C ± 2 °C within 15 min after the discs were applied. The plates were examined for susceptibility after 20-24 h of incubation or at 48 h when insufficient growth was observed after 24 h incubation. Inhibitory zone diameters were measured in millimetres at the transitional point where growth abruptly decreased, as determined by a marked reduction in colony sizes.20
Antifungal susceptibility disks were used to test for susceptibility to two triazoles (fluconazole and itraconazole), two imidazoles (clotrimazole and miconazole) and one polyene (nystatin) (Laboratorios Conda, Madrid, Spain). Fasting blood glucose levels were tested using a point-of-care Accu-chek glucose meter (Roche Diabetes Care, Inc., Ängelholm, Sweden) and glycated hemoglobin levels were determined using an automated glycated hemoglobin 501 analyser (HemoCue AB, Ängelholm, Sweden).
Quality control
Growth testing for all culture media was performed using reference Candida strains (Candida albicans ATCC 10231, Candida glabrata ATCC 15126, Candida krusei ATCC 24408, Candida tropicalis ATCC 750) and negative control strains (Escherichia coli ATCC 25922 and Staphylococcus aureus ATCC 25923) as recommended by the manufacturers. Susceptibility testing was performed in adherence to National Committee for Clinical Laboratory Standards guidelines.20 Procedures for Gram staining, serial dilutions and culture techniques were performed according to protocols developed by the American Society for Microbiology.21 Blood glucose and glycated hemoglobin determination were performed on calibrated devices following the manufacturer's manual.
Statistical analysis
Data were entered in an Excel spreadsheet and analysed using STATA special edition, Version 10.0 (StataCorp, College Station, Texas, United States). Data regarding study population characteristics, proportion of patients with gastrointestinal candidiasis, species distribution and susceptibility profiles were analysed using frequency distributions and 95% confidence intervals. Bivariate analysis through the use of chi-square tables, and multivariate logistic regression were used to analyse associations between risk factors and gastrointestinal candidiasis. Statistical significance was assumed to exist if p-values were less than 0.05. The risk factors studied were age of the participants, sex, glycaemic control ('good' control = glycated haemoglobin level < 7.0%; 'poor' control = glycated haemoglobin > 7.0%), history of antibiotic therapy, history of corticosteroid therapy and type of DM. Participants were analysed in four age groups: children (< 18 years), youth (18-40 years), adult (41-65 years) and elderly (> 65 years). Diabetes type was classified based on diagnostic information on the patient's form into type 1 and type 2 DM. The history of therapies was classified as Yes if the patient had treatment for more than 2 weeks but less than 1 month earlier or No if the patient had therapies either for less than 2 weeks or more than 1 month earlier.
Results
Two hundred and forty-one study participants were recruited into the study (Table 1). One hundred and seventeen (48.5) of the participants were female patients; 82 (34.02%) patients had type 1 DM and the rest had type 2 DM. The mean age of the participants was 43 years (95% confidence interval: 41-46); among type 1 DM patients the mean age was 21 years (95% confidence interval: 19-22 years) and in type 2 DM patients this was 55 years (95% CI: 53-57 years). The average fasting blood glucose levels in the study participants was 9.9 mmol/L (standard deviation = 2.3 mmol/L), and average glycated haemoglobin level was 9.3% (standard deviation = 1.6%).

Proportion of diabetes mellitus patients with gastrointestinal candidiasis
Cultures from 37 (15.4%) patients had colony counts consistent with gastrointestinal candidiasis (≥ 1 × 105 colony-forming units/mL of stool). Among infected patients, 11 (29.7%) had type 1 DM, and 26 (70.3%) had type 2 DM (p = 0.706). About one-third of patients with gastrointestinal candidiasis (25, 67.6%) were female, and 12 (32.4%) were male (p = 0.009).
The majority of the isolates were C. albicans (n = 23, 62.2%), followed by C. glabrata (n = 7, 18.9%), C. tropicalis (n = 3, 8.1%), Candida dublinensis (n = 2, 5.4%) and C. krusei (n = 2, 5.4%). Among female patients, only C. albicans and C. dubliniensis were isolated (Figure 1). C. glabrata, C. krusei and C. tropicalis were isolated exclusively from male patients.

Antifungal susceptibility of gastrointestinal Candida isolates
A total of 25 of the 37 isolates (67.6%) were susceptible to fluconazole and 3/37 (8.1%) isolates were resistant to fluconazole. Itraconazole susceptibility was observed in 33 (89.2%) isolates; 15 (40.5%) isolates were susceptible to clotrimazole, while 7 (18.9%) were resistant and 18 (48.6%) isolates were resistant to miconazole, while 8 (21.6%) were sensitive. All isolates were susceptible to nystatin (Table 2).

Patient factors associated with gastrointestinal candidiasis
There were 12 (34.4%) male, culture-positive patients and 25 (67.6%) female, culture-positive patients (p = 0.01). Twenty-five (67.6%) of the culture-positive patients reported prior use of antifungal drugs, whereas the rest had no history of antifungal drug use in the past weeks (p < 0.001); 26 (70.3%) culture-positive patients had used antibiotics and 11 (29.7%) had not used antibiotics in the past weeks; 14 (37.8%) culture-positive patients had used corticosteroids and the rest had not used corticosteroids in the past weeks (p < 0.001) (Table 3). Thirty-five had poor glucose control, and 20 were hyperglycaemic. Based on glycated haemoglobin results, 2 (5.4%) culture-positive patients had good glycaemic control and the remaining 35 (94.6%) culture-positive patients had poor glycaemic control (p < 0.001).
Discussion
The overall prevalence of intestinal candidiasis in this study was 15.4% (37 isolates found among 241 patients). This is considerably lower than other findings such as 21.5% in Cameroon,22 75.47% in Poland in 20152 and 41.1% in Mexico.23 The prevalence in this study was also lower than the overall prevalence in sub-Saharan Africa, which was estimated to be 23.4%.8 Gurleen and Savio24 in India, however, reported a lower prevalence (9.7%). Previous authors have noted a wide variation in the prevalence of candidiasis depending on region, population surveyed and even the research methods used.3 Whereas most studies used similar culture-based methods, the quantification threshold for colony-forming units of the culture colonies have varied. In this study, a threshold range of 105 CFU was considered significant for growth, whereas in the study in Poland,2 a wider range (103 CFU - 106 CFU) was considered. This would have accounted for the significantly higher prevalence in their study.
In the current study, female patients had a higher prevalence rate compared to male patients (21.4% vs 9.7%; p = 0.009). A study conducted in Vienna, Austria, on burn patients found a female predisposition in systemic and related candidiasis.25 The predilection of gastrointestinal candidiasis in female patients is poorly understood and there is no proper explanation for the predisposition.26
Species distribution of Candida isolates
C. albicans accounted for the majority of isolates in the current study. This is consistent with other studies that identified it as the most common isolate from clinical materials,27,28 and could be attributed to the fact that C. albicans is highly adapted to the human mucosal surfaces and possesses virulence factors such as protease production and biofilm formation.3,29 These enhance its chances of survival in the gastrointestinal tract. Omrani et al.9 in their review of African studies also found a predominance of C. albicans. Non-albicans species in general accounted for a larger number of isolates in studies by Banerjee et al.30 in India, as well as in Brazil and Chile.31 No mixed species infections were encountered in this study, unlike the studies in Poland2 and India.30 Among non-albicans species in this study C. glabrata was predominant, accounting for half (7/14) of all non-albicans isolates. This was followed by C. tropicalis (3/14), C. krusei (2/14) and C. dubliniensis (2/14). Species diversity was greater in male patients and type 2 DM patients; however, the latter could simply be a reflection of the fact that the type 2 DM sub-group accounted for the majority of patients. The relationship could perhaps be better established with a cohort study design.
Antifungal susceptibility patterns of Candida isolates
There are relatively fewer options for the treatment of mycoses compared with antibiotics. Fluconazole is a narrow spectrum fungistatic azole with good activity against yeasts; however, from the mid-1990s concerns about resistance have persisted.3 This study found that 87% of C. albicans isolates were fluconazole-susceptible. Similarly, the study in Poland2 and a study conducted in 2013 in India32 also reported fluconazole susceptibility in over 80% of C. albicans isolates. Fluconazole resistance among non-albicans species was found to be 21%. This was considerably lower than observations from the Polish study2 where 56% of non-albicans species were susceptible to fluconazole. This has implications for clinical therapy since the guidelines for the treatment of non-albicans infection in Uganda require fluconazole.
Intrinsic resistance in non-albicans species has been documented in species such as C. krusei, and reduced susceptibility in C. glabrata and C. guilliermondii has been reported.33,34Candida tropicalis has been known to exhibit fluconazole resistance up to 31.3%28; however, this could be due to the use of a panel that mostly comprised high-potency drugs normally reserved for systemic infections, such as amphotericin B and voriconazole. In this study C. krusei, was also the most fluconazole-resistant strain. This strain has been known to exhibit intrinsic fluconazole resistance; Sanguinetti et al.28 reported an estimated global fluconazole resistance of 78% in C. krusei.
Itraconazole has a wider spectrum of activity than fluconazole, and is normally effective against both fluconazole-susceptible and fluconazole-resistant Candida strains.17 Lesser susceptibility, however, was observed in 2 C. glabrata and both C. krusei isolates. The Polish study,2 however, found that only 28% of C. albicans and 11% of non-albicans species were itraconazole susceptible. Higher rates of resistance were observed in the imidazoles; 18.9% of isolates were resistant to clotrimazole and nearly half were resistant to miconazole.
It is worth noting that a number of patients in this study had prior exposure to antifungal medications, especially azoles, which were mostly used to treat dermatomycoses and Candida. Clotrimazole and miconazole are commonly used over-the-counter antifungals, and these could therefore be a driver for the reduced susceptibility and resistance patterns observed in some patient isolates.
All isolates in this study were susceptible to nystatin, which is consistent with reports that document low rates of polyene-class antifungal resistance.3,17,33 Nystatin carries the additional advantage of being a low-cost medicine and is widely available in many formulations including tablets, suspension and topical preparations. In Uganda, the treatment plan for oropharyngeal candidiasis and gastrointestinal candidiasis may require the use of nystatin preparations, which replaces the expensive and less available medicines such as caspofungins.
Patient factors associated with gastrointestinal candidiasis
There was no significant association between the diabetes type and gastrointestinal candidiasis. Gosiewski et al.34 also found no association, despite a higher prevalence among those with type 2 DM patients. This was contrary to Kumar et al.,35 who found a higher prevalence among type 1 DM.
Gastrointestinal candidiasis was more common among female patients than among male patients (p = 0.01) and among patients with poor glycaemic control (p ≤ 0.001) than among those with good glycaemic control. The use of antifungals (p ≤ 0.001), antibiotics (p ≤ 0.001) and corticosteroids (p ≤ 0.001) was a predisposing factor to gastrointestinal candidiasis. Similar findings were reported by Banerjee et al.,30 in India, where a majority of patients were on antibiotic and corticosteroid therapy. Antibiotics, especially the broad-spectrum variety, are known to interfere with the balance of gut microbiota in the human body.27,36,37 In doing so, they create a favourable environment for the proliferation of yeasts, and some studies have reported a possible influence on drug resistance profiles. Ben-Ami et al.,37 found a significant association between the use of antibiotics such as carbapenems, clindamycin and colistin and fluconazole resistance, but in this study the class of antibiotics used by diabetic patients was not reported. Use of antifungal therapy could also select for more resistant strains. This was demonstrated by Lortholary et al.,38 using data from a prospective surveillance programme; the authors observed high rates of isolation of fluconazole-resistant Candida species following the recent use of the drug. In this study, poor antifungal susceptibility at baseline level and inappropriate doses of antifungal drugs could be responsible for the association that was observed.
Increased age is usually associated with decreased effectiveness of the immune response.1,17 The elderly patients and adults accounted for the majority of infections, but there was no significant association between age and gastrointestinal candidiasis. Therefore, this observation could simply be a reflection of the study population, most of which comprised adults and elderly patients. In contrast, Banerjee et al.30 observed a higher isolation rate in children (0-12 years), and attributed it to the weaker immune systems in such populations. Given the adult: paediatric ratio in that study (1:1.9), however, the sampling method may have also had an influence on this result.
Corticosteroid use was also associated with gastrointestinal candidiasis. This has also been observed by Glavey et al.,39 in their cross-sectional study, and Madhumati and Rajendran.40 Kakeya et al.41 and Fardet et al.42 reported an increased risk of susceptibility to opportunistic infections in patients exposed to corticosteroids.
Most patients with gastrointestinal candidiasis in this study had poor glucose control. Studies investigating the association between the two have yielded varying results. Findings from this study are similar to the report by Olczak-Kowalczyk et al.,43 but contrary to studies conducted by Suarez et al.,44 Kowalewska et al.2 and Arslan et al.29 which did not find association between poor glycaemic control and candidiasis.
Recommendations
As a package for the diagnosis and management of gastrointestinal candidiasis, speciation of Candida isolates should be performed, and antifungal susceptibility profiles established to guide patient therapy. The speciation is important, since species within the Candida genus differ widely, both in their ability to cause infection and also in their susceptibility to antifungal agents. Nystatin was shown to have excellent antifungal activity in this study and could be considered for empirical therapy in settings where inadequate resources may inhibit antifungal susceptibility testing.
Limitations
This study enrolled only participants who complained of gastrointestinal symptoms and several asymptomatic patients could have been left out. This might have reduced the prevalence of gastrointestinal candidiasis. Routine culture and sensitivity testing was conducted and very sensitive techniques such as molecular techniques were not performed. This could have reduced the detection of Candida organisms.
Conclusion
Prevalence of gastrointestinal candidiasis was relatively low among the participants of this study. The infection is associated with female sex, poor glycaemic control and previous use of antifungals, antibiotics and corticosteroids. Nystatin can be a drug of choice in the treatment of gastrointestinal candidiasis, if the suspension or tablet formulations can be made available.
Acknowledgements
The authors are highly grateful to the diabetic patients who accepted to participate in the study. The author wishes to sincerely acknowledge the contributions of the administration and staff of St. Francis Hospital Nsambya Diabetes Centre, the staff of the International Health Sciences University Laboratory and teaching staff, especially Mr Taremwa Ivan Mugisha.
Competing interests
The authors have declared that no competing interest exists.
Authors' contributions
C.O. and A.P.O. conceived the topic and collected the data, C.O. analysed the data, B.M. and E.O. drafted the manuscript, and J.C.O., V.A. and C.A. edited the manuscript. All authors read and approved the contents of the manuscript.
Sources of support
This research received no specific grant from any funding agency in the public, commercial or not-for-profit sectors.
Data availability statement
Data sharing is not applicable to this article as no new data were created or analysed in this study.
Disclaimer
The views and opinions expressed in this article are those of the authors and do not necessarily reflect the official policy of any affiliated agency of the authors.
References
1.Mahon RC, Lehman CD, Manuselis G. Textbook of diagnostic microbiology. 5th ed. St Louis. MO: Saunders Elsevier; 2015. [ Links ]
2.Kowalewska B, Kawko M, Zorena K, Myśliwiec M. Yeast-like fungi in the gastrointestinal tract in children and adolescents with Diabetes type 1. Pediatr Endocrinol Diabetes Metab. 2014;20(4):170-177. https://doi.org/10.18544/PEDM-20.04.0017 [ Links ]
3.Anaissie EJ, McGinnis RM, Pfaller AM. Clinical mycology. 2nd ed. St Louis, MO: Elsevier; 2009. [ Links ]
4.Lamps WL. Surgical pathology of the gastrointestinal system: Bacterial, fungal, viral and parasitic infections. 1st ed. New York, NY: Springer; 2009. [ Links ]
5.Wang ZK, Yang YS, Stefka AT, Sun G, Peng LH. Review article: Fungal microbiota and digestive diseases. Aliment Pharmacol Ther. 2014;39(8):751-766. https://doi.org/10.1111/apt.12665 [ Links ]
6.Lamichhane RS, Boaz K, Natarajan S, Shrestha M. Assessment of Candidal carriage in patients with type II diabetes mellitus. J Path Nep. 2015;5(9):733-738. https://doi.org/10.3126/jpn.v5i9.13784 [ Links ]
7.Mandal SM, Mahata D, Migliolo L, et al. Glucose directly promotes antifungal resistance in the fungal pathogen, Candida spp. J Biol Chem. 2014;289(37):25468-25473. https://doi.org/10.1074/jbc.C114.571778 [ Links ]
8.Jafar N, Edriss H, Nugent K. The effect of short-term hyperglycemia on the innate immune system. Am J Med Sci. 2016;351(2):201-211. https://doi.org/10.1016/j.amjms.2015.11.011 [ Links ]
9.Omrani SA, Pecen L, Rajek P, Raghubir N, Zigmond J. Prevalence of invasive and superficial Candida infections in Africa and Middle East; a systematic review and meta-analysis. 114th Meeting of the American Society for Microbiology (ASM), Boston, MA, May; 2014; pp. 17-20, Poster number 1273. [ Links ]
10.Soyucen E, Gulcan A, Aktuglu-Zeybek AC, Onal H, Kiykim E, Aydin A. Differences in the gut microbiota of healthy children and those with type 1 diabetes. Pediatr Int. 2014;56(3):336-343. https://doi.org/10.1111/ped.12243 [ Links ]
11.Alba-Loureiro CT, Munhoz DC, Martins OJ, Cerhiaro AGC, Scavone RC, Sannomiya P. Neutrophil function and metabolism in individuals with diabetes mellitus. Braz J Med Biol Res. 2007;40(8):1037-1044. https://doi.org/10.1590/S0100-879X2006005000143 [ Links ]
12.Deorukhkar CS, Saini S, Mathew S. Non-albicans Candida Infection: An Emerging Threat. Interdiscip Perspect Infect Dis. 2014;2014:615958. https://doi.org/10.1155/2014/615958 [ Links ]
13.Maubon D, Garnaud C, Calandra T, Sanglard D, Cornet M. Resistance of Candida spp. to antifungal drugs in the ICU: Where are we now? J Intensive Care Med. 2014;40(9):1241-1255. https://doi.org/10.1007/s00134-014-3404-7 [ Links ]
14.Doi AM, Pignatari ACC, Edmond MB, et al. Epidemiology and microbiologic characterization of nosocomial candidemia from a Brazilian national surveillance program. PLoS One. 2016;11(1):e0146909. https://doi.org/10.1371/journal.pone.0146909 [ Links ]
15.Geerlings SE, Hoepelman. Immune dysfunctuion in patients with diabetes mellitus (DM). FEMS Immunol Med Micobiol. 1999;26;(3-4):259-265. https://doi.org/10.1111/j.1574-695X.1999.tb01397.x [ Links ]
16.Centres for Disease Control and Prevention. Stool specimens - Specimen collection. DPDx - Laboratory Identification of Parasitic Diseases of Public Health Concern [homepage on the Internet]. 2016 [cited 2017 Feb 04]. Available from: https://www.cdc.gov/dpdx/diagnosticprocedures/stool/specimencoll.html [ Links ]
17.Kauffman AC, Pappas GP, Sobel JD, Dismukes WE. Essentials of clinical mycology. 2nd ed. New York, NY: Springer. [ Links ]
18.Jeehyoung K, Wonshik S. How to do random allocation (randomization). Clin Orthop Surg. 2014;6(1):103-109. https://doi.org/10.4055/cios.2014.6.1.103 [ Links ]
19.Dettori J. The random allocation process: Two things you need to know. Evid Based Spine Care J. 2010;1(3):7-9. https://doi.org/10.1055/s-0030-1267062 [ Links ]
20.National Committee for Clinical Laboratory Standards. Method for antifungal disk diffusion susceptibility testing of yeasts; approved guideline. Wayne, PA: NCCLS; 2009. [ Links ]
21.American Society for Microbiology. Laboratory protocols [homepage on the Internet]. American Society for Microbiology; 2016 [cited 2017 Feb 04]. Available from: http://www.asmscience.org/content/education/protocol/ [ Links ]
22.Bissong M, Azodo CC, Agbor MA, Nkuo-akenji T, Fon P. Oral health status of diabetes mellitus patients in Southwest Cameroon. Odontostomatol Trop. 2015;38(150):49-57. [ Links ]
23.Martinez RFF, Jaimes-Aveldañez A, Hernández-Pérez F, Arenas R, Miguel GFS. Oral Candida spp carriers: Its prevalence in patients with type 2 diabetes mellitus. An Bras Dermatol. 2013;88(2):222-225. https://doi.org/10.1590/S0365-05962013000200006 [ Links ]
24.Gurleen K, Savio R. Prevalence of Candida in Diarrhoeal Stools. J Dent Medi Sci. 2016;15(4):47-49. [ Links ]
25.Rubaihayo J, Tumwessigye NM, Konde-Lule J, Wamani H, Nakku-Joloba E, Makumbi F. Frequency and distribution patterns of opportunistic infections associated with HIV/AIDS in Uganda. BMC Res Notes. 2016;9(1):501. https://doi.org/10.1186/s13104-016-2317-7 [ Links ]
26.Loster JE, Wieczorek A, Loster BW. Correlation between age and Candida species infections of complete denture wearers: A retrospective analysis. Clin Interv Aging. 2016;2016(11):1707-1714. https://doi.org/10.2147/CIA.S116658 [ Links ]
27.Flevari A, Theodorakopoulou M, Velegraki A, Armaganidis A, Dimopoulos G. Treatment of invasive candidiasis in the elderly: A review. Clin Interv Aging. 2013;2013:8:1199. https://doi.org/10.2147/CIA.S39120 [ Links ]
28.Sanguinetti M, Posteraro B, Lass-Flörl C. Antifungal drug resistance among Candida species: Mechanisms and clinical impact. Mycoses. 2015;58(Suppl 2):2-13. https://doi.org/10.1111/myc.12330 [ Links ]
29.Arslan S, Koç AN, Sekerci AE, et al. Genotypes and virulence fac+tors of Candida species isolated from oral cavities of patients with type 2 diabetes mellitus. Turk J Med Sci. 2016;46(1):18-27. https://doi.org/10.3906/sag-1405-73 [ Links ]
30.Banerjee P, Kaur R, Uppal B. Study of fungal isolates in patients with chronic diarrhea at a tertiary care hospital in North India. J Mycol Med. 2013;23(1):21-26. https://doi.org/10.1016/j.mycmed.2012.12.002 [ Links ]
31.Sardi OCJ, Scorzoni L, Bernardi T, Fusco-Almeida MA, Mendes GSJM. Candida species: Current epidemiology, pathogenicity, biofilm formation, natural antifungal products and new therapeutic options. J Med Microbiol. 2013;62(1):10-24. https://doi.org/10.1099/jmm.0.045054-0 [ Links ]
32.Premkumar J, Ramani P, Chandrasekar T, Natesan A, Premkumar P. Detection of species diversity in oral candida colonization and anti-fungal susceptibility among non-oral habit adult diabetic patients. J Nat Sci Biol Med. 2014;5(1):148. https://doi.org/10.4103/0976-9668.127315 [ Links ]
33.Spampinato C, Leonardi D. Candida infections, causes, targets, and resistance mechanisms: Traditional and alternative antifungal agents. BioMed Res Int. 2013;2013:204237. https://doi.org/10.1155/2013/204237 [ Links ]
34.Gosiewski T, Salamon D, Szopa M, Sroka A, Malecki MT, Bulanda M. Quantitative evaluation of fungi of the genus Candida in the feces of adult patients with type 1 and 2 diabetes-a pilot study. Gut Pathog. 2014;6(1):1. https://doi.org/10.1186/s13099-014-0043-z [ Links ]
35.Kumar BV, Padshetty NS, Bai KY, Rao MS. Prevalence of Candida in the oral cavity of diabetic subjects. J Assoc Physicians India. 2005;53:599-602. [ Links ]
36.Vaishnavi C, Kaur S, Prakash S. Speciation of fecal Candida isolates in antibiotic-associated diarrhea in non-HIV patients. Jpn J Infect Dis. 2008;61(1):1-4. [ Links ]
37.Ben-Ami R, Olshtain-Pops K, Krieger M, et al. Antibiotic exposure as a risk factor for fluconazole-resistant Candida bloodstream infection. Antimicrob Agents Chemother. 2012;56(5):2518-2523. https://doi.org/10.1128/AAC.05947-11 [ Links ]
38.Lortholary O, Desnos-Ollivier M, Sitbon K, Fontanet A, Bretagne S, Dromer F. Recent exposure to caspofungin or fluconazole influences the epidemiology of candidemia: A prospective multicenter study involving 2,441 patients. Antimicrob Agents Chemother. 2011;55(2):532-538. https://doi.org/10.1128/AAC.01128-10 [ Links ]
39.Glavey SV, Keane N, Power M, O'Regan AW. Posterior pharyngeal candidiasis in the absence of clinically overt oral involvement: A cross-sectional study. Lung. 2013;191(6):663-668. https://doi.org/10.1007/s00408-013-9503-3 [ Links ]
40.Madhumati B, Rajendran R. Evaluation of chrom agar in speciation of Candida species from various clinical samples in a tertiary care hospital. Int J Curr Microbiol App Sci. 2015;4(9):463-472. [ Links ]
41.Kakeya H, Izumikawa K, Yamada K, et al. Concurrent subcutaneous Candida. 2014. [ Links ]
42.Fardet L, Petersen I, Nazareth I. Common infections in patients prescribed systemic glucocorticoids in primary care: A population-based cohort study. PLoS Med. 2016;13(5):e1002024. https://doi.org/10.1371/journal.pmed.1002024 [ Links ]
43.Olczak-Kowalczyk D, Pyrżak B, Dąbkowska M, et al. Candida spp. and gingivitis in children with nephrotic syndrome or type 1 diabetes. BMC Oral Health. 2015;15(1):57. https://doi.org/10.1186/s12903-015-0042-6 [ Links ]
44.Suárez LB, Alvarez MI, De Bernal M, Collazos A. Candida species and other yeasts in the oral cavities of type 2 diabetic patients. Colombia Méd. 2013;44(1):26-30. https://doi.org/10.25100/cm.v44i1.1040 [ Links ]
Correspondence:
Caesar Oyet
coyet@ihsu.ac.ug
Received: 13 Feb. 2019
Accepted: 12 Aug. 2020
Published: 10 Dec. 2020
ORIGINAL RESEARCH
Evaluation of ceftriaxone-sulbactam-disodium edetate adjuvant combination against multi-drug resistant Gram-negative organisms
Shilpi GuptaI; Mahadevan KumarII; Shelinder P.S. ShergillIII; Kundan TandelIV
IDepartment of Microbiology, Military Hospital, Bhopal, India
IIDepartment of Microbiology, Bharati Vidyapeeth University Medical College, Pune, India
IIIDepartment of Microbiology, Armed Forces Medical College, Pune, India
IVDepartment of Microbiology, Command Hospital (Central Command), Lucknow, India
ABSTRACT
BACKGROUND: Multi-drug resistant (MDR) Gram-negative bacteria are an emerging threat, both in hospital and community settings. As very few antibiotics are effective against such infections, the need of the hour is a new antibiotic or drug combination which can overcome the effect of extended-spectrum β-lactamases (ESBL) and metallo β-lactamases (MBL). A new antibiotic combination of ceftriaxone, sulbactam and disodium edetate (CSE) has recently been proposed to tackle the MDR organisms.
OBJECTIVE: Our study was carried out to assess the susceptibility of ESBL- and MBL-producing Gram-negative organisms to CSE.
METHODS: The study was conducted in a tertiary-care hospital in Delhi, India, from February 2017 to June 2017. A total of 179 MDR (85 ESBL + 94 MBL) Gram-negative isolates from various clinical samples, identified by an automated system (Vitek 2) were tested against CSE using the Kirby-Bauer disc diffusion method. Susceptibility to CSE was recorded based on interpretative zone sizes of ceftriaxone as per 2017 Clinical and Laboratory Standards Institute guidelines.
RESULTS: The most common isolate was Escherichia coli (76/179; 42.4%) followed by Klebsiella pneumoniae (53/179; 29.6%) and Acinetobacter baumanii (27/179; 15.1%). The in vitro susceptibility of ESBL- and MBL-producing Gram-negative isolates to CSE was found to be 58/85 (68.2%) for ESBL and 37/94 (39.4%) for MBL.
CONCLUSION: The in vitro susceptibility results obtained for CSE against ESBL-producing organisms is promising. It has the potential to emerge as a carbapenem-sparing antibiotic, active against ESBL-producing strains. Further clinical studies are required to establish the clinical efficacy of CSE against MDR pathogens.
Keywords: ceftriaxone sulbactam, disodium edetate; multi-drug resistance; carbapenem-sparing.
Introduction
Increased antimicrobial resistance of Gram-negative bacteria (GNB), both hospital- and community-acquired, is of great concern worldwide.1 According to the report of Global Antibiotic Resistance Partnership - India Working Group, the irrational and increased use of antibiotics, especially cephalosporins, in India has resulted in the emergence of multi-drug resistant (MDR) bacteria which were earlier known to be susceptible.2 The menace of the emerging threat has been realised by the Indian Government, hence it has called for effective action to address the increasing antimicrobial resistance. The Indian Ministry of Health and Family Welfare, in collaboration with the World Health Organization, formulated the National Health Policy 2017, which calls for an urgent need for standardisation of antibiotic usage guidelines to minimise the emergence of antimicrobial resistance. Thus, both organisations decided to tackle the issue as a priority collaborative work in 2018-2019.3
Despite increasing antibiotic resistance, the common therapy for treatment of GNB infections includes use of β-lactams with β-lactamase inhibitors, third and fourth generation cephalosporins and carbapenems.4 Production of β-lactamase enzymes is the most widespread mechanism of resistance adopted by GNB to counteract the effect of β-lactam antibiotics.5,6 Extended-spectrum β-lactamases (ESBLs) are usually plasmid-mediated β-lactamases and hydrolyse oxyimino group-containing β-lactam antibiotics.7 Metallo β-lactamases (MBLs) are a class of broad-substrate spectrum enzymes that also hydrolyse most β-lactam antibiotics, except monobactams.8 Other mechanisms that contribute to resistance are drug efflux systems, outer membrane protein changes, antibiotic-modifying enzymes and antibiotic-target modification.9 Carbapenems are used against the ESBL-producing organisms because of their stability against hydrolysis by ESBLs and broad-spectrum activity.10 However, with the emergence of carbapenem-hydrolysing enzymes, overexpression of efflux pumps and changes in outer membrane proteins, increases in carbapenem resistance have been reported among the members of enterobacteriaceae and non-fermenter GNB, such as the Acinetobacter and Pseudomonas group of pathogens.11,12
In India, the prevalence of ESBL and MBL producers among Gram-negative organisms range between 28% - 84% and 7.5% - 71%, respectively.13,14 The increasing resistance towards available antibiotics, as well as the lack of development of new antibiotics against GNB, could soon lead to the world experiencing the tough situations of the pre-antibiotic era with an increase in cases with untreatable infections. A newer approach to improving the efficiency of the existing antimicrobials is the use of antibiotic adjuvants. A novel antibiotic adjuvant entity of ceftriaxone, sulbactam with adjuvant disodium edetate (CSE) is being used in Indian hospitals against MDR infections.15,16 The antibiotic adjuvant entity is a combination of ceftriaxone plus sulbactam with disodium edetate and has undergone Phase III clinical trials under the aegis of the Central Drugs Standard Control Organisation, India.17 This study aimed to study the in vitro susceptibility to CSE of MDR Gram-negative organisms isolated in our centre. Thus, the present study aimed to study the in vitro susceptibility of ESBL- and MBL-producing GNB to CSE and to explore whether it could be utilised as a carbapenem-sparing drug.
Methods
Ethical considerations
Ethical clearance was obtained from the Institutional Ethics Committee, Army Hospital (Research and Referral), New Delhi, India (92/2016).
Study design and setting
This cross-sectional study was conducted in the Department of Microbiology of a 900-bed, tertiary-care, super-speciality Army Hospital (Research and Referral), New Delhi, India from February 2017 to June 2017. Isolates were obtained from various clinical samples from both out- and inpatients received in the laboratory for bacterial culture from different clinical departments. Sample types included: urine, pus, cerebrospinal fluid, sputum, tissue from burn wound sites, endotracheal aspirate, semen, high vaginal swab and drains fluid.
Microbiological processing
Samples were processed using conventional methods. Blood culture bottles were incubated in a fully automated blood culture system, the BacT/Alert 3D (bioMérieux SA, Marcy-l'Étoile, France). After obtaining a pure bacterial growth, isolate identification and antibiotic sensitivity testing were carried out on a Vitek 2 Compact (bioMérieux SA, Marcy-l'Étoile, France).
An MDR isolate was defined as a GNB strain that showed resistance to at least three different categories of antibiotics.18 A total of 85 ESBL- and 94 MBL-producing GNB were identified by phenotypic tests and confirmed by the Vitek 2 system for inclusion in the study. The confirmatory test for ESBL production was carried out using discs containing ceftazidime (30 µg) alone, along with ceftazidime/clavulanic acid (30/10 µg) discs. Similarly, cefotaxime (30 µg) and cefotaxime/clavulanic acid discs (30/10 µg) were also used. An increase in zone diameter of ≥ 5 mm around the clavulanate disk compared to the zone of inhibition for the ceftazidime and cefotaxime disk alone was used to confirm and isolate as positive for ESBL production as per Clinical and Laboratory Standards Institute guidelines.19 The modified Hodge test19 was used for isolates identified as carbapenemase-producing GNB strains. A 10 µg meropenem disc was placed on a Mueller-Hinton agar plate previously inoculated with Escherichia coli American Type Culture Collection 25922 (the indicator organism). Afterwards, the test organisms were streaked out in a straight line, starting from the edge of the meropenem disc, for at least 20 mm - 25 mm length. The enhancement of growth of the indicator organism along the test organism's streak line and zone of inhibition of the disk to form a cloverleaf appearance was considered as a positive indicator for carbapenemase production as per Clinical and Laboratory Standards Institute guidelines.19 For detection of class B carbapenemases (MBL), the double-disc synergy test using imipenem and imipenem plus ethylenediaminetetraacetic acid disc was done. An organism with a zone size difference of 7 mm between imipenem and imipenem plus ethylenediaminetetraacetic acid discs was considered to be an MBL-producing strain.20
All 179 isolates were then further tested for antimicrobial susceptibility against CSE (Venus Medicine Research Centre, Baddi, Himachal Pradesh, India) by the Kirby-Bauer disc diffusion method on a Mueller-Hinton agar kept at 37 °C for 16 h - 18 h (Figure 1). Quality control of CSE antibiotic discs was done using E. coli American Type Culture Collection 25922 and a laboratory-characterised sensitive isolate of Acinetobacter baumanii (Strain no. AHRR1205/2017). Susceptibility of the tested organisms against this combination was reported as sensitive, intermediate or resistant based on the zone of inhibition mentioned for ceftriaxone as per Clinical and Laboratory Standards Institute guideline M100S27: Performance Standards for Antimicrobial Sensitivity Testing, 2017.19 The zone of inhibition around the disc was measured, and the organism was labelled as sensitive if the zone measured > 23 mm for enterobacteriaceae or > 21 mm for Acinetobacter, intermediate if 20 mm - 22 mm (enterobacteriaceae) or 14 mm - 20 mm (Acinetobacter), or resistant if < 19 mm for enterobacteriaceae or < 13 mm for Acinetobacter.19 Non-fermenters such as Pseudomonas aeruginosa and Burkholderia cepacia were not tested against CSE as these are known to be inherently resistant to ceftriaxone and there are no testing standards mentioned in Clinical and Laboratory Standards Institute guidelines.19
Data analysis
Statistical analysis was done using Graph Pad, a free online software offering by founder Dr Harvey Motulsky (GraphPad Software, San Diego, California, United States). Associations between two factors were drawn through univariate logistic regression using the Fischer exact test. P-values of less than 0.05 were considered statistically significant.
Results
A total of 179 clinical isolates from 168 clinical cases (117 male patients and 51 female patients) were included in the study, with a mean patient age of 43.22 years (range: 4-85 years). Most isolates were from urine, followed by pus and blood specimens, and these accounted for 136 (75.9%) of the total isolates (Table 1). Of the included pathogens, 127 (70.9%) were isolated from inpatients, and 29 (16.2%) were isolated from patients in intensive care units (Figure 2).

Among the isolated pathogens, E. coli (n = 76; 42.4%) was the most predominant followed by Klebsiella pneumoniae (n = 53; 29.6%) and A. baumanii (n = 27; 15%) (Table 1). Eighty-five (47.5%) of the tested isolates were ESBL producers and 94 (52.5%) were MBL producers. Fifty-eight (68.23%) of the ESBL producers (Table 2) and 37 (39.36%) MBL producers (Table 3) showed in vitro sensitivity towards CSE.
Among the identified ESBL-producing GNB, 44 (73.3%) E. coli and 7 (53.8%) K. pneumoniae showed sensitivity towards CSE, while 51 (85%) E. coli and 11 (84.6%) K. pneumoniae showed sensitivity towards meropenem. The most common MBL-producing GNBs, K. pneumoniae, A. baumanii and E. coli, showed 27.5% (n = 11), 48% (n = 12) and 31.3% (n = 5) sensitivity, respectively, towards CSE and 2.5% (n = 1), 0% and 6.3% (n = 1) sensitivity, respectively, towards meropenem (data not shown). A statistically significant association was found when susceptibility to meropenem and CSE were compared (p < 0.001) in ESBL-producing E. coli. However, no statistically significant associations were seen when the CSE susceptibility pattern was compared to meropenem susceptibility patterns for other ESBL- and MBL-producing organisms. Twelve (48%) of the MBL-producing A. baumanii isolates which were resistant to meropenem showed susceptibility to CSE (data not shown). Multi-drug resistant E. coli, K. pneumoniae and A. baumanii showed 64.5% (n = 49), 33.9% (n = 18) and 48.1% (n = 13) susceptibility, respectively, towards CSE and 71.1% (n = 54), 20.8% (n = 11) and 7.4% (n = 2), respectively, against meropenem (Figure 3).

Discussion
This study included only those MDR GNB isolates which were proven to be pathogenic, obtained from clinically established cases of infection. The majority of isolates were from urine samples (n = 84; 47%), followed by pus (n = 34; 19%) and blood (n = 18; 10%). The identified pathogens included E. coli, K. pneumoniae and A. baumanii, in decreasing order of prevalence. Similar distributions of isolates with similar specimen distribution have been reported by other studies.21,22 In the present study, E. coli (n = 49; 58.3%) was highly prevalent in urine samples, followed by K. pneumoniae (n = 22; 26.2%), indicating their significant role in urinary tract infections. Similar findings were also reported by Janifer et al. in Chennai, South India23 and Ruchika et al. in Gurgaon, Haryana, North India.24Klebsiella spp. and E. coli are known to be the major causative agents for hospital-acquired infections. According to the National Health Service report of 2017 on Gram-negative bloodstream infections, E. coli, P. aeruginosa and Klebsiella spp. were responsible for 72% of all Gram-negative bloodstream infections, with E.coli accounting for 59% of the total cases.25 However, in the present study, E. coli and K. pneumoniae were implicated in 16 out of 18 (88.8%) Gram-negative bloodstream infection cases, with K. pneumoniae identified in the majority (10/18; 55.5%) of cases as compared to E. coli (6/18; 33.3%), which is in contrast to the National Health Service report.25Acinetobacter baumanii is known to be an important pathogen in causing respiratory infections such as hospital-acquired pneumonia and bacteraemia, especially in intensive care patients, followed by skin and soft tissue infections and urinary tract infections.26,27 The present study has dissimilar findings in terms of isolation of A. baumanii, with maximum isolation from pus, because of skin and soft tissue infection cases (50%); followed by respiratory samples, because of respiratory infections (32.1%); and blood samples, because of bacteraemia (7.1%).
In the present study, 95 out of 179 (53.1%) MDR GNB isolates showed sensitivity to CSE in vitro. In similar studies conducted in the northern and western parts of India, higher susceptibility rates against CSE have been reported by Bhatia et al. (84% - 94%), Kumar et al. (81.9% - 94.74%), Bagga et al. (87.5% - 94.6%) and Sachdeva et al. (74.2% - 80.5%).12,24,28,29 The lower rate in our study compared to other studies could be because the isolates tested in the present study have been identified as ESBL or MBL producers, which was not specifically mentioned by other studies. The susceptibility of ESBL- and MBL-producing isolates to the CSE combination in the present study was from 68% for ESBL producers and 39% for MBL producers. The range is close to a similar study conducted in Mumbai, Maharashtra, India by Sahu et al.30
Because of increased clinical use of carbapenems against MDR GNB, our study also compared the efficacy of CSE against meropenem on Gram-negative isolates to use this new combination as a possible carbapenem-sparing drug. Carbapenems are considered to be the drug of choice for ESBL-producing GNB. The present study showed that 58 (68.2%) of the ESBL isolates were susceptible to CSE, of which E. coli susceptibility to CSE was statistically significant when compared with its susceptibility to meropenem (p < 0.001). The susceptibility profile to CSE of the three most predominant pathogens in our study, E. coli (49/76, 64.5%), K. pneumoniae (18/53, 34%) and A. baumanii (13/27, 48.1%) was comparable for E.coli (54/76, 71.1%) when compared to meropenem and high for K. pneumoniae (11/53, 20.8%) and A. baumanii (2/27, 7.4%). However, several authors from different parts of India (Haryana, western Uttar Pradesh, Gujarat) have reported significantly higher susceptibility to CSE when compared with meropenem.24,28,31 Our study showed comparable sensitivity among ESBL organisms to CSE (58/85, 68.2%) and meropenem (64/85, 75.3%), which implies that if CSE is tested against all ESBL isolates and they are found to be susceptible, CSE could be used as a drug of choice in place of carbapenems. Most of the MBL-producing organisms are resistant to carbapenems and the drug of choice for such isolates is polymixins. In the present study, 39.4% (34) of such isolates were susceptible to CSE; thus, CSE instead of polymixins could be considered as a therapeutic option in these cases.
One major concern is finding effective treatments for infection with Acinetobacter spp., which is now commonly isolated from critical areas in most of the hospitals worldwide.24 Our study found CSE to be effective in 48.1% of MBL-producing A. baumanii infections, which is a fair number, and use of CSE could be beneficial in such infections. A similar study conducted in Pune, India found that CSE was a superior antibiotic compared to other commonly used β-lactam antibiotics, including carbapenems, when tested against MDR GNB.32 A study conducted in Faridabad, Haryana, India, which evaluated the clinical use of CSE on patients, concluded that CSE should be used as a carbapenem-sparing drug and its combination with polymyxins can help to reduce mortality rates by successfully treating complicated MDR cases of intraabdominal, lower respiratory tract and urinary tract infections.12
Limitations
The limitation of our study was the relatively small number of isolates tested. Larger sample size and diverse health facility level (primary to tertiary) studies would be required to rule out any referral bias that is expected in a tertiary-care hospital. Further, this study can be extended with application to clinical situations to have a clinico-microbiological correlation to guide clinicians for the judicious use of CSE against MDR pathogens.
Conclusion
The results of this study show that CSE can potentially be effective among ESBL-producing bacteria, especially E. coli. The susceptibility of multi-drug resistant Gram-negative microorganisms to CSE suggests that CSE could be a good option as a carbapenem-sparing drug and also against some of the MBL-producing organisms.
Acknowledgements
We wish to thank Venus Remedies (India) for providing antibiotic discs of ceftriaxone-sulbactam-disodium edetate for testing.
Competing interests
There are no competing interests, financial interests, relationships and affiliations relevant to the subject matter or materials discussed in the manuscript.
Authors' contributions
All authors contributed intellectually to the work. S.G. was involved in bench work and manuscript writing; M.K. was involved in the study concept and supervision, manuscript writing and final approval; S.P.S.S. was involved in the study concept and supervision; and K.T. was responsible for collection of MDR strains, and contributed to the bench work.
Sources of support
This research received no specific grant from any funding agency in the public, commercial, or not-for-profit sectors.
Data availability statement
Data sharing is not applicable to this article as no new data were created or analysed in this study
Disclaimer
The views and opinions expressed in this article are those of the authors and do not necessarily reflect the official policy or position of any affiliated agency of the authors.
References
1.Kumar D, Singh AK, Ali MR, Chander Y. Antimicrobial susceptibility profile of extended spectrum ß-lactamase (ESBL) producing Escherichia coli from various clinical samples. Infect Dis (Auckl). 2014;7:1-8. https://doi.org/10.4137/IDRT.S13820 [ Links ]
2.Global Antibiotic Resistance Partnership (GARP) - India Working Group. Rationalizing antibiotic use to limit antibiotic resistance in India. Indian J Med Res. 2011;134(3):281-294. [ Links ]
3.National Action Plan on Antimicrobial Resistance (NAP-AMR) 2017-2021. April 2017 | Ministry of Health & Family Welfare-Government of India. [ Links ]
4.Bush K. Bench-to-bedside review: The role of β-lactamases in antibiotic-resistant Gram-negative infections. Bush Crit Care. 2010;14:224. https://doi.org/10.1186/cc8892 [ Links ]
5.Bush K, Jacoby GA, Medeiros AA. A functional classification scheme for β- lactamases and its correlation with molecular structure. Antimicrob Agents Chemother. 1995;39(6):1211-1233. https://doi.org/10.1128/AAC.39.6.1211 [ Links ]
6.Bush K, Jacoby GA. Updated functional classification of beta-lactamases. Antimicrobial Agents Chemother. 2010;54(3):969-976. https://doi.org/10.1128/AAC.01009-09 [ Links ]
7.Bradford PA. Extended-spectrum β-lactamases in the 21st century: Characterization, epidemiology, and detection of this important resistance threat. Clin Microbiol Rev. 2001;14(4):933-951. https://doi.org/10.1128/CMR.14.4.933-951.2001 [ Links ]
8.Drawz SM, Bonomo RA. Three decades of β-lactamase inhibitors. Clin Microbiol Rev. 2010;23(4):160-201. https://doi.org/10.1128/CMR.00037-09 [ Links ]
9.Chopra I, Schofield C, Everett M, et al. Treatment of health-care associated infections caused by Gram-negative bacteria: A consensus statement. Lancet Infect Dis. 2008;8(2):133-139. https://doi.org/10.1016/S1473-3099(08)70018-5 [ Links ]
10.Pravin KN and Michelle SV. Prevalence of carbapenem resistant Enterobacteriaceae from a tertiary care hospital in Mumbai, India. J Microbiol Infect Dis. 2013;3(04):207-210. https://doi.org/10.5799/ahinjs.02.2013.04.0110 [ Links ]
11.Rodrigues C. Carbapenem-resistant enterobacteriaceae: A reality check. Reg Health Forum. 2011;15(1):83-86. [ Links ]
12.Bhatia P. Alternative empiric therapy to carbapenems in management of drug resistant gram negative pathogens: a new way to spare carbapenems. Res J Infect Dis. 2015;3:2. http://doi.org/10.7243/2052-5958-3-2 [ Links ]
13.Basavaraj CM, Jyothi P, Peerapur Basavaraj V. The prevalence of ESBL among Enterobacteriaceae in a tertiary care hospital of North Karnataka, India. J Clin Diagn Res. 2011;5(3):470-475. [ Links ]
14.Chaudhuri BN, Rodrigues C, Balaji V, et al. Incidence of ESBL producers amongst Gram-negative bacilli isolated from intra-abdominal infections across India (Based on SMART Study, 2007 Data). J Assoc Physicians Ind. 2011;59(5):287-292. [ Links ]
15.De AS, Kumar SH, Baveja SM. Prevalence of metallo-β-lactamase producing Pseudomonas aeruginosa and Acinetobacter species in intensive care areas in a tertiary care hospital. Indian J Crit Care Med. 2010;4(1):217-219. https://doi.org/10.4103/0972-5229.76089 [ Links ]
16.Chaudhary M, Payasi A. Clinical, microbial efficacy and tolerability of Elores, a novel antibiotic adjuvant entity in ESBL producing pathogens: Prospective randomized controlled clinical trial. J Pharmacy Res. 2013;7(4):275-280. https://doi.org/10.1016/j.jopr.2013.04.017 [ Links ]
17.Chaudhary M, Payasi A. A randomized, open label prospective, multicenter phase-III clinical trial of Elores in lower respiratory tract and urinary tract infections. J Pharmacy Res. 2013;6(4):409-414. https://doi.org/10.1016/j.jopr.2013.04.011 [ Links ]
18.Magiorakos AP, Srinivasan A, Carey RB, et al. Multidrug-resistant, extensively drug resistant and pandrug-resistant bacteria: An international expert proposal for interim standard definitions for acquired resistance. Clin Microbiol Infect. 2012;18(3):268-281. https://doi.org/10.1111/j.1469-0691.2011.03570.x [ Links ]
19.Clinical Laboratory Standard Institute (CLSI). Performance standards for antimicrobial susceptibility testing (2017) CLSI approved standards CLSI M100-S23. Wayne, PA: CLSI; 2017. [ Links ]
20.Clinical Laboratory Standard Institute. Performance standards for antimicrobial susceptibility testing; Twenty-second Informational Supplement. Wayne, PA: Clinical Laboratory Standard Institute; 2013, p. 32. [ Links ]
21.Pop-Vicas AE, D'Agata EM. The rising influx of multidrug-resistant gram-negative bacilli into a tertiary care hospital. Clin Infect Dis. 2005;40(12):1792-1798. https://doi.org/10.1086/430314 [ Links ]
22.Subhedar V, Jain SK. Gram negative super bugs: A new generation of ICU infections, an emerging challenge for health care settings. Am J Microbiol Res. 2016;4(1):47-50. [ Links ]
23.Janifer J, Geethalaksmi S, Satyavani K, et al. Prevalence of lower urinary tract infection in South Indian type 2 diabetic subjects. Indian J Nephrol. 2009;19(3):107-111. https://doi.org/10.4103/0971-4065.57107 [ Links ]
24.Bagga R. Retrospective analysis of antibiotic susceptibility and resistance patterns against nosocomial Gram negative pathogens in Fortis Memorial Research Institute Gurgaon. Int J Curr Adv Res, 2015;4(9):347-351. [ Links ]
25.NHS_Improvement. Guidance on the definition of healthcare associated Gram-negative bloodstream infections. In: NHS Improvement, editor. Public Health England; 2017. [ Links ]
26.Gaynes R, Edwards JR. Overview of nosocomial infections caused by Gram-negative bacilli. Clin Infect Dis. 2005;41(6):848-854. https://doi.org/10.1086/432803 [ Links ]
27.Paul M, Weinberger M, Siegman-Igra Y, et al. Acinetobacter baumannii: Emergence and spread in Israeli hospitals 1997-2002. J Hosp Infect. 2005;60(3):256-260. https://doi.org/10.1016/j.jhin.2005.01.007 [ Links ]
28.Kumar M, Chaudhary S, Makkar DK, Garg N, Chugh SK. Comparative antimicrobial efficacy evaluation of a new product Elores against Meropenem on Gram-negative isolates. Asian J Pharm Clin Res. 2015;8:251-254. [ Links ]
29.Neelam Sachdeva. Antibiotic sensitivity pattern of bacterial pathogens in Rajeev Gandhi Cancer Hospital, Delhi. Int J Recent Sci Res. 2016;7(1):8480-8485. [ Links ]
30.Sahu M, Sanjith S, Bhalekar P, Keny D. Waging war against extended spectrum beta lactamase and metallobetalactamase producing pathogens - Novel adjuvant antimicrobial agent Cse1034- An Extended Hope. J Clin Diagn Res. 2014;8(6):DC20-DC23. https://doi.org/10.7860/JCDR/2014/8802.4504 [ Links ]
31.Makkar DK, Kumar M, Chaudhary S, Goyal S, Aggarwal P, Garg N. Comparative antimicrobial efficacy evaluation of a new product Elores against meropenem on Gram- negative isolates. Asian J Pharm Clin Res. 2015;8:1-4. [ Links ]
32.Arora S, Munshi N. Comparative assessment of antibiotic susceptibility pattern of Gram negative pathogens isolated from intensive care unit patients in Pune. BMRJ. 2015;10(2):1-9. https://doi.org/10.9734/BMRJ/2015/18199 [ Links ]
Correspondence:
Mahadevan Kumar
dr.mkumar011@gmail.com
Received: 04 Feb. 2019
Accepted: 27 Aug. 2020
Published: 10 Dec. 2020
ORIGINAL RESEARCH
Validation of PHASE for deriving N-acetyltransferase 2 haplotypes in the Western Cape mixed ancestry population
Celeste SwartI, II; Surita MeldauII, III; Chad M. CentnerIV, V; Adrian D. MaraisVI; Fierdoz OmarVI
IFaculty of Health Sciences, University of Cape Town, Cape Town, South Africa
IINational Health Laboratory Service (NHLS), Groote Schuur Hospital, Cape Town, South Africa
IIIDivision of Chemical Pathology, University of Cape Town, Cape Town, South Africa
IVDivision of Medical Microbiology, University of Cape Town, Cape Town, South Africa
VNational Health Laboratory Service (NHLS), Medical Microbiology, Groote Schuur Hospital, Cape Town, South Africa
VIDivision of Chemical Pathology, University of Cape Town, Cape Town, South Africa
ABSTRACT
BACKGROUND: There is a shortage of data on the accuracy of statistical methods for the prediction of N-acetyltransferase 2 (NAT2) haplotypes in the mixed ancestry population of the Western Cape.
OBJECTIVE: This study aimed to identify the NAT2 haplotypes and assess the accuracy of PHASE version 2.1.1 in assigning NAT2 haplotypes to a mixed ancestry population from the Western Cape.
METHODS: This study was conducted between 2013 and 2016. The NAT2 gene was amplified and sequenced from the DNA of 100 self-identified mixed ancestry participants. Haplotyping was performed by molecular and computational techniques. Agreement was assessed between the two techniques.
RESULTS: Haplotypes were assigned to 93 samples, of which 67 (72%) were ambiguous. Haplotype prediction by PHASE demonstrated 94.6% agreement (kappa 0.94, p < 0.001) with those assigned using molecular techniques. Five haplotype combinations (from 10 chromosomes) were incorrectly predicted, four of which were flagged as uncertain by the PHASE software. Only one resulted in the assignment of an incorrect acetylation phenotype (intermediate to slow), although the software flagged this for further analysis. The most common haplotypes were NAT2*4 (28%) followed by NAT2*5B (27.4%), NAT2*6A (21.5%) and NAT2*12A (7.5%). Four rare single nucleotide variants (c.589C>T, c.622T>C, c.809T>C and c.387C>T) were detected
CONCLUSION: PHASE accurately predicted the phenotype in 92 of 93 samples (99%) from genotypic data in our mixed ancestry sample population, and is therefore a suitable alternative to molecular methods to individualise isoniazid therapy in this high burden tuberculosis setting.
Keywords: NAT2; haplotyping; isoniazid; pathology; molecular.
Introduction
Tuberculosis remains a global life-threatening infectious disease.1 Patients in developing countries are particularly vulnerable, as informal settlements and overcrowded environments provide optimal conditions for the spread of tuberculosis. According to the National Strategic Plan, South Africa has the third highest tuberculosis burden worldwide. with an annual incidence of approximately 1%.2 The Western Cape demonstrates nearly the highest global incidence of tuberculosis, with the mixed ancestry population being particularly affected.3
Isoniazid is a key first-line antimicrobial drug in the treatment of tuberculosis. The dosage of isoniazid is usually standard and, in most settings, related to body mass in accordance with World Health Organization treatment guidelines.4 However, elimination of, and thus response to, the drug are affected by the patient-specific expression of metabolising enzymes, in particular arylamine N-acetyltransferase 2 (NAT2), which catalyses N-acetylation of aryl amines and aryl hydrazines.5 These drugs include clinically important antimicrobial agents such as isoniazid and sulphonamides, caffeine, dapsone as well as some toxigenic substances and carcinogenic chemicals derived from the environment and human diet. Expression of NAT2 is limited to the intestine and liver.5
The NAT2 gene is located on chromosome 8p22 and has two exons,6,7,8 one of which is transcribed.9 Since the discovery of NAT2 in 1990,10 extensive studies in various population groups have linked NAT2 genetic variants to enzyme function, classifying individuals as either slow, intermediate or fast acetylators. The different acetylator phenotypes determine individual responses to toxins and prescribed medications, and also influence cancer susceptibility.11 The acetylation phenotype can affect clinical outcome on standard drug doses and may result in an increased risk of therapeutic failure or adverse drug reactions.12
Both lack and excess of NAT2 (slow and fast acetylation) can be associated with isoniazid hepatotoxicity. The major metabolites associated with isoniazid metabolism are thought to be responsible for isoniazid-induced liver injury, while isoniazid itself can also cause immune-mediated hepatotoxicity by binding to liver proteins and serving as a hapten.13 It is thus postulated that fast acetylators may have a poor response to treatment as a result of suboptimal exposure to isoniazid due to reduced isoniazid plasma levels, as well as liver injury due to an increased rate of isoniazid metabolite formation.13 Conversely, slow acetylators achieve higher isoniazid plasma levels, since they cannot efficiently metabolise the drug, leading to hepatic injury.13
Distinct NAT2 haplotypes have been described, consisting of up to four single nucleotide variants (SNVs) in various combinations. Over 100 haplotypes have been classified into 20 groups according to defining mutations, for example, the NAT2*5 group includes 29 different haplotypes and is defined by the c.341T>C SNVs. Each haplotype is associated with an acetylation phenotype. In human populations globally, the seven most prevalent NAT2 haplotypes are: NAT2*4, NAT2*5B, NAT2*6A, NAT2*7B, NAT2*12A, NAT2*13A and NAT2*14.14 These haplotypes include various combinations of NAT2 SNVs.15NAT2*4 is classified as the wild type and is associated with fast (normal) acetylator status, as are the NAT2*12A (c.803A>G) and NAT2*13A (c.282C>T) haplotypes. The other four common haplotypes are associated with either significantly decreased expression or decreased stability of the NAT2 enzyme.16 Heterozygotes for fast and slow alleles demonstrate intermediate acetylating activity.
Genotyping is typically performed using conventional restriction fragment length polymorphism (RFLP) analysis to detect the most common variants only, or Sanger sequencing to detect all SNVs in the NAT2 region. Ambiguous NAT2 genotyping results (the presence of more than one heterozygous SNV in the same patient) commonly arise from sequencing data due to simultaneous analysis of both maternal and paternal alleles. This can cause uncertainty predicting the NAT2 phenotype as it may be unclear if one or both alleles carry variants with functional effects. In these cases, more complex molecular techniques are required in addition to Sanger sequencing for complete and accurate haplotyping.17 These include RFLP or amplification-refractory mutation system (ARMS) amplification.18 These methods are tedious for implementation in a routine diagnostic laboratory, and therefore computational haplotype reconstruction programs have been developed that statistically predict the most likely haplotype present using algorithms that take into account established allele frequencies within the population. The computational algorithms offer a quicker, cheaper and more practical alternative. Several approaches are available, including Clark's algorithm, the Expectation Maximum algorithm and the Bayesian implementation, which estimate the maximum likelihood of haplotype frequencies.19 The software program PHASE (used in this study) is considered to be the reference standard for computational haplotype inference.20,21 It utilises the Bayesian approach for reconstructing haplotypes based on population genotype data. Using prior information (based on beliefs about patterns of haplotypes expected in certain population samples), as well as the information obtained from the observed data, the most likely haplotype is estimated and reconstructed for each allele in each individual.22
The proportions of slow and fast acetylators differ among various populations. In addition, the effect of different acetylation phenotypes on isoniazid-induced hepatic toxicity has been shown to be inconsistent across ethnic groups.23 There is limited NAT2 genotypic data in African populations; the few known demonstrate nucleotide variants that differ from those commonly described in European populations. African populations are genetically diverse,24 and data can therefore not be extrapolated among the various population groups.
The South African mixed ancestry population (8.9% of the South African population) is described as a distinct ethnic group with a complex genetic admixture,25 with over 60% living in the Western Cape and particularly in the Cape Town area. The major ancestral populations contributing to the genetic diversity of this group include Khoisan and non-Khoisan Africans, with smaller contributions from both European and Indian Asian descent populations.26 The genotypic complexity and origin of this population not only influence disease susceptibility,27 but may also have implications when computational haplotype prediction algorithms are employed.
It would be ideal to determine the NAT2 acetylation status of each patient in order to individualise isoniazid therapy. However, the complex manual molecular haplotyping techniques are expensive, time-consuming and tedious,17 and are thus not realistically feasible in a high tuberculosis burden setting such as the Western Cape where this study was performed. While the PHASE computational algorithm is used routinely at many centres, its performance has not been validated in the South African mixed ancestry population.
This study aims to describe the NAT2 haplotypes identified in this population and to assess the accuracy of PHASE version 2.1.1 in assigning NAT2 haplotypes in the mixed ancestry population of the Western Cape.
Methods
Ethical Considerations
The Human Research Ethics Committee (HREC REF: 327/2014), appointed by the Faculty of Health Sciences at the University of Cape Town, approved this study. All the work conducted was performed on pre-extracted, stored DNA from participants who gave informed consent for research conducted in a previous study, as well as for any future molecular testing. The DNA samples were selected at random from participants of self-identified mixed ancestry by allocation of numbers only.
Study site and population
This study was conducted between 2013 and 2016. The blood samples (n = 100) used in this study were sourced with informed consent from randomly selected, self-identified mixed ancestry adult patients attending the Lipid outpatients' clinic at Groote Schuur Hospital in Cape Town, South Africa. DNA was extracted and stored.
Molecular techniques
The NAT2 gene was amplified by polymerase chain reaction (PCR), sequenced (using Sanger sequencing) and haplotyped using molecular and computational techniques as described below.
Polymerase chain reaction
The PCR was performed using primers designed to flank the entire coding region of the NAT2 gene (PCR amplicon size 1003 bp). The reaction consisted of the appropriate forward (5′GTCACACGAGGAAATCAAATGC3′) and reverse (5′AGTTGATAATTAGTGAGTTGGGTGA3′) NAT2 primers (0.5 µM), deoxynucleotide triphosphates (0.2 mM), Supertherm Gold taq DNA polymerase (0.75 U) (JMR Holdings, Kent, United Kingdom), 1 X buffer containing MgCl2 at 1.5 mM final concentration (supplied) and approximately 50 ng to 150 ng DNA. Polymerase chain reaction cycling conditions were as follows: 94 °C for 3 minutes; 35 cycles of: 94 °C for 30 s, 56 °C for 30 s and 72 °C for 40 s, followed by 72 °C for 8 min. Reaction efficacy was assessed by agarose gel electrophoresis (using 2% agarose gel with the addition of ethidium bromide for visualisation) prior to further analysis.
Sequencing of polymerase chain reaction products
Sequencing of the resulting PCR products were outsourced to the Central Analytical Facility (Stellenbosch University, South Africa). Forward and reverse sequencing were performed. The sequencing data were compared to the NAT2 genomic reference sequence obtained from GenBank (NG_012246.1) (https://www.ncbi.nlm.nih.gov/genbank/) to identify all NAT2 gene variants present (Figure 1 and Figure 2).


Restriction fragment length polymorphism
Restriction fragment length polymorphism was used to separate individual alleles in 25 samples with ambiguous haplotypes. The c.481C>T and c.191G>A variations destroy cleavage sites for Kpn1 and Msp1. Kpn1 was therefore used in samples heterozygous for c.481C>T (n = 22), while Msp1 was used in those with heterozygous c.191G>A (n = 3). While the normal allele is recognised and digested into two smaller fragments, the affected allele is not (Figure 3). Reaction products were separated by agarose gel electrophoresis (2%) followed by excision, agarose gel extraction and sequencing of the undigested allele.

Amplification-refractory mutation system polymerase chain reaction
Amplification-refractory mutation system PCR was performed for the remaining cases with ambiguous haplotypes containing heterozygous c.282C>T SNVs (n = 42). An ARMS forward primer (5′CCACAATGTTAGGAGGGTATTTTTAT3′) was designed to recognise and amplify only alleles containing the c.282T variant base. Polymerase chain reactions were performed as before, using the same reverse primer, with the exception of an annealing temperature of 62 °C. After checking the reaction efficacy with agarose gel electrophoresis, the individual alleles were sequenced as before.
Data analysis
Sequence data were aligned to published reference sequences using the ClustalW alignment function in BioEdit version 7.2.528 and analysed. The Court Lab online calculator was used to assess whether the variants were in Hardy-Weinberg equilibrium,29 and haplotypes were assigned by molecular methods.
PHASE computational algorithm
Results obtained from genotyping of both ambiguous (n = 67) and non-ambiguous samples (n = 26) were used as input data for the PHASE computational algorithm.21,22 The following data were inputted: number of variant positions, variant nucleotide positions and the genotypes for each sample at those positions (wild type, heterozygous, homozygous). The following parameters were specified: number of iterations (= 1000), thinning interval (= 1), burn-in (= 100).
Statistical analysis
The information obtained by molecular and computational haplotyping was compared by kappa statistics using Stata 13 (StataCorp LLC, College Station, Texas, United States). The p-values less than 0.05 were considered statistically significant.
Results
Genotypes from all 100 samples were found to be in Hardy-Weinberg equilibrium for each SNV detected in the study population (Table 1). Four samples were heterozygous for both c.590G>A and c.857G>A, while another one was heterozygous for both c.341T>C and c.803A>G. No further work was done on these, although future studies should aim to analyse these with similar ARMS or RFLP techniques and those employed here. An additional two ambiguous samples could not be assigned haplotypes due to degraded DNA and repeatedly failed amplification - a total of seven samples were thus excluded from further analysis.

Of the 93 remaining samples, 26 were non-ambiguous genotypes and therefore did not require haplotyping. These 26 genotypes comprised either only wild type variants (n = 6), or were homozygous for any particular haplotype (n = 20). Separation of the non-ambiguous alleles by RFLP or ARMS PCR was thus not necessary and haplotypes could be assigned directly to these samples. Allele separation and haplotype determination for the remaining 67 samples were obtained using the RFLP and ARMS methods described earlier. The non-ambiguous samples demonstrated a predominance of haplotype NAT2*5B (28%), followed by NAT2*4 (25%), NAT2*6A (17%), NAT2*12A (12%), NAT2*13A and NAT2*5C (both 6%), NAT2*5A (4%) and NAT2*27 (2%).
Apart from the commonly described NAT2 SNVs, four additional variants were detected in our study population. A single sample was heterozygous for the c.622T>C (p.Tyr208His) variant (rs56387565). In this instance, it co-occurred with c.803A>G, resulting in the less common haplotype NAT2*12F. Another was heterozygous for c.809T>C (p.Ile270Thr) (rs868725509). It co-occurred with c.341T>C and c.803A>G; molecular haplotyping could not be performed on this ambiguous sample due to the inability to delineate with available methodology. A single nonsense variant, c.589C>T (p.Arg197*), resulting in a stop codon, was detected in isolation in one patient.30 Two samples were heterozygous for a very rare variant, c.387C>T (p.Ser129=) (rs144828000). In both of our patients, it co-occurred with the c.282C>T and c.590G>A variants (NAT2*6A).
The most common haplotypes in the 67 ambiguous samples, derived by molecular methods, were NAT2*4 (29.1%) followed by NAT2*5B (26.9%), NAT2*6A (23.1%) and NAT2*12A (6%). These frequencies were similarly predicted by PHASE (Table 2). Of 67 ambiguous samples, 15 (22%) required further molecular testing (i.e. RFLP or ARMS PCR) to differentiate between slow and intermediate acetylation phenotypes. In 14 (93%) cases, the ambiguous genotype was resolved to predict a slow acetylation phenotype.

There was a 94.6% agreement between the haplotypes obtained by molecular methods and those predicted by PHASE, with a strong correlation (kappa 0.94, p < 0.001). Five haplotype combinations (from 10 chromosomes) were incorrectly predicted. Of these, only one resulted in a change of acetylation phenotype (intermediate to slow). Furthermore, the program flagged four of these five incorrect haplotype combinations (including the one incorrectly assigned to slow acetylator status) to indicate that uncertainty was present around one of the predicted variant positions.
Discussion
NAT2 genotypes were obtained by molecular methods for 100 samples. Ninety-three genotypes were then used to validate the accuracy of PHASE in predicting haplotypes. Twenty-six of these samples had non-ambiguous genotypes; of the remaining 67 samples, only 15 (22.5%) technically needed further allelic haplotyping, where the ambiguous genotype could lead to ambiguous acetylation phenotype prediction. This is in keeping with possible clinical scenarios, where non-ambiguous samples would not in fact need to be subjected to PHASE analysis to obtain haplotypes.
Four rare SNVs were detected in our study population. The variant at position c.622T>C (rs56387565) results in a non-synonymous change (p.Tyr208His); the functional effect of this variant is not well studied, although it has been linked to slow acetylation according to dbSNP.31 Another variant at c.809T>C (rs868725509) is also non-synonymous (p.Ile270Thr) and has not been characterised. The nonsense variant c.589C>T (p.Arg197*) results in a stop codon with a subsequent presumed lack of functional protein expression.30 These three SNVs each occurred at a frequency of 0.5% in the study population. Lastly, the very rare synonymous variant detected at position c.387C>T (p.Ser129=) (rs144828000) has to date not been described in the context of the NAT2 acetylation status, and occurred in 1% of the study cohort. Further assessment of the protein and enzymatic activity of these SNVs was not within the scope of this study. Future studies, however, may investigate these less commonly detected SNVs, whether 'in silico' or otherwise.
There are limited data available on the most commonly occurring NAT2 haplotypes in the mixed ancestry population of the Western Cape, although numerous studies have been performed in other population groups. Fuselli et al. demonstrated a preponderance of NAT2*4 (37%), NAT2*7B (24%) and NAT2*5B (23%) in 13 American and two Siberian populations.32 Our study showed a similar predominance of NAT2*4 (28%) and NAT2*5B (27.4%), while the frequency of NAT2*7B was much lower (3.8%). While the wild type (NAT2*4) was also the most commonly occurring haplotype in East Asians,33 Loktionov et al. described NAT2*5B to be the most common haplotype in black South Africans,34 followed by NAT2*6A and NAT2*12A (both 16.8%, vs 21.5% and 7.5% in our study population). In contrast to our findings, the wild type NAT2*4 was shown to occur less frequently in black South Africans (13.4%).34 In a cohort of 62 black and 54 mixed ancestry South Africans, where 17% were found to be fast acetylators35, haplotype frequencies did not differ significantly between the two population groups (unpublished). The frequency of NAT2 haplotypes obtained in this study serve as a priori information to strengthen future haplotype predictions by computational algorithms such as PHASE, specifically in this mixed ancestry population.
The good correlation between PHASE and molecular haplotyping methods demonstrated in our mixed ancestry population is similar to previous studies in other populations. A study by Golka et al. in a German population, where the statistical program PHASE version 2.1.1 was used to predict haplotypes from genotypes by analysing seven NAT2 SNVs commonly observed in the Caucasian population, concluded that this program unambiguously derived haplotypes in over 99% of cases.36 Similarly, other studies have shown that these computational algorithms (including PHASE) compare well with molecular haplotyping, and could thus be used as an alternative method for genetic phasing. Sabbagh and Darlu (2005) investigated the performance of several computational approaches in estimating individual haplotype phases in five different population groups (Spanish, United Kindom Caucasians, black South Africans, Koreans and Nicaraguans).17 They compared the results obtained from the computational programs with those obtained through direct molecular haplotyping and found that even the incorrectly predicted haplotypes did not result in phenotypic changes, resulting in a complete correlation of the acetylation phenotypes in all five population groups. The population group in which computational haplotype inference displayed the highest error rate was black South Africans, although error rates were always low (less than 4%). The postulated reasons include the high number of ambiguous genotypes as well as the low rate of linkage disequilibrium between the various SNVs in this sample, compared with the other four population groups.17 The authors suggest studying these data before computational haplotyping is employed, to attempt to predict the accuracy and reliability with which haplotypes will subsequently be inferred in such cases.
The single incorrectly predicted phenotype (intermediate to slow) may be clinically significant. However, the computational program flagged the predicted haplotypes as being uncertain; in the clinical scenario, such a flag could serve as a prompt to confirm the haplotype by molecular methods instead of relying on PHASE.
In our current setting, NAT2 acetylation status is chiefly investigated by special request once the patient has hepatic complications of isoniazid therapy. Apart from the adverse drug reactions that could be avoided by individualising isoniazid dosage according to NAT2 phenotypes, incorrect dosage may contribute to the growing prevalence of multi-drug resistant tuberculosis.37 The unavailability of routine isoniazid genotyping could thus be considered a major limitation of current tuberculosis treatment protocols. N-acetyltransferase 2 genotyping should ideally be performed on all patients before commencing isoniazid therapy. The cost of genetic investigations as well as the limited infrastructure in the South African healthcare setting make it difficult to apply haplotyping without the PHASE computational approach. This approach could be supported by specific investigation of incompletely explored SNVs and the development of a high throughput multiplex assay targeting common SNVs relevant to the population being investigated. Further studies are also recommended to investigate and monitor the isoniazid safety and treatment outcome in patients undergoing treatment for tuberculosis with different NAT2 acetylation phenotypes.
Limitations
Due to budgetary and time constraints, only a small sample size of 100 was used. The ARMS PCR could not be set up for the following variants which may have improved the correlation: c.590G>A, c.857G>A, c.341T>C and c.803A>G.
Conclusion
PHASE accurately predicted the NAT2 acetylation phenotype in 92 of 93 samples (99%) from genotypic data in our mixed ancestry study population, and could be used as an alternative to molecular methods to individualise isoniazid therapy in our high tuberculosis burden setting. Data obtained from this study may also be potentially used to predict haplotypes in future patients from this population group.
Acknowledgements
Competing interests
The authors have declared that no competing interest exists.
Authors' contributions
C.S. was the primary author and performed the majority of the molecular work and subsequent analyses. All co-authors assisted with the reviewing of the manuscript. F.O. was the supervisor and assisted with the project design, and S.M. assisted with molecular bench work and interpretation of results. A.D.M. was responsible for the funding, and provided the source of samples utilised in this study. C.M.C. was responsible for running the PHASE computational haplotype predictions as well as the statistical analysis.
Sources of support
Research conducted in this study was supported by existing internal research funds from the University of Cape Town.
Data availability statement
Data sharing is not applicable to this article as no new data were created or analysed in this study.
Disclaimer
The views and opinions expressed in this article are those of the authors and do not necessarily reflect the official policy or position of any affiliated agency of the authors.
References
1.Mandal A. History of tuberculosis [homepage on the Internet]. 2014 [accessed 2020 Sep 7]. Available from: http://www.news-medical.net/health/History-of-Tuberculosis.aspx [ Links ]
2.South African National Aids Council (SANAC). National strategic plan on HIV, STIs and TB 2012-2016 [homepage on the Internet]. SANAC; 2011 [accessed 2020 Sep 7]. Available from: https://www.hst.org.za/publications/NonHST%20Publications/hiv-nsp.pdf [ Links ]
3.Beyers N, Gie RP, Zietsman HL, et al. The use of a geographical information system (GIS) to evaluate the distribution of tuberculosis in a high-incidence community. S Afr Med J. 1996;86(1):40-44. [ Links ]
4.World Health Organization. Treatment of tuberculosis: Guidelines. WHO/HTM/TB/2009.420. 4th ed. Geneva: World Health Organization; 2009. [ Links ]
5.Weber WW, Hein DW. N-acetylation pharmacogenetics. Pharmacol Rev [serial online]. 1985;37(1):25-79. Available from: https://doi.org/10.2165/00003088-197702030-00003 [ Links ]
6.Matas N, Thygesen P, Stacey M, Risch A, Sim E. Mapping AAC1, AAC2 and AACP, the genes for arylamine N-acetyltransferases, carcinogen metabolising enzymes on human chromosome 8p22, a region frequently deleted in tumours. Cytogenet Cell Genet. 1997;77(3-4):290-295. https://doi.org/10.1159/000134601 [ Links ]
7.Franke S, Klawitz I, Schnakenberg E, et al. Isolation and mapping of a cosmid clone containing the human NAT 2 gene. Biochem Biophys Res Commun. 1994;199(1):52-55. https://doi.org/10.1006/bbrc.1994.1192 [ Links ]
8.Hickman D, Risch A, Buckle V, et al. Chromosomal localization of human genes for arylamine N-acetyltransferase. Biochem J. 1994;297(Pt 3):441-445. https://doi.org/10.1042/bj2970441 [ Links ]
9.Husain A, Zhang X, Doll MA, States JC, Barker DF, Hein DW. Identification of N-acetyltransferase 2 (NAT2) transcription start sites and quantitation of NAT2-specific mRNA in human tissues. Drug Metab Dispos. 2007;35(5):721-727. https://doi.org/10.1124/dmd.106.014621 [ Links ]
10.Blum M, Grant DM, McBride W, Heim M, Meyer UA. Human arylamine N-acetyltransferase genes: Isolation, chromosomal localization, and functional expression. DNA Cell Biol. 1990;9(3):193-203. https://doi.org/10.1089/dna.1990.9.193 [ Links ]
11.Blum M, Demierre A, Grant DM, Heim M, Meyer UA. Molecular mechanism of slow acetylation of drugs and carcinogens in humans. Proc Natl Acad Sci U S A. 1991;88(12):5237-5241. https://doi.org/10.1073/pnas.88.12.523712 [ Links ]
12.Meisel P. Arylamine N-acetyltransferases and drug response. Pharmacogenomics. 2002;3(3):349-366. https://doi.org/10.1517/14622416.3.3.349 [ Links ]
13.Wang P, Pradhan K, Zhong X, Ma X. Isoniazid metabolism and hepatotoxicity. Acta Pharmaceutica Sinica B. 2016;6(5):384-392. https://doi.org/10.1016/j.apsb.2016.07.014 [ Links ]
14.Sabbagh A, Darlu P, Crouau-Roy B, Poloni ES. Arylamine N-acetyltransferase 2 (NAT2) genetic diversity and traditional subsistence: A worldwide population survey. PLoS One. 2011;6(4):e18507. https://doi.org/10.1371/journal.pone.0018507 [ Links ]
15.DUTH. Human NAT2 Alleles (Haplotypes). 2013 [updated 2016; accessed 2020 Sep 7]. Available from: http://nat.mbg.duth.gr/Human%20NAT2%20alleles_2013.htm [ Links ]
16.SNPedia. NAT2. 2020 [accessed 2020 Sep 7]. Available from: http://www.snpedia.com/index.php/NAT2. [ Links ]
17.Sabbagh A, Darlu P. Inferring haplotypes at the NAT2 locus: The computational approach. BMC Genet. 2005;6:a30. https://doi.org/10.1186/1471-2156-6-30 [ Links ]
18.Ahmadian A. Approaches for analysis of mutations and genetic variations. Stockholm: KTH, Superseded Departments, Biotechnology; 2001. [ Links ]
19.Niu T. Algorithms for inferring haplotypes. Genet Epidemiol. 2004;27(4):334-347. https://doi.org/10.1002/gepi.20024 [ Links ]
20.Delaneau O, Zagury JF. Haplotype inference. Methods Mol Biol. 2012;888:177-196. https://doi.org/10.1007/978-1-61779-870-2_11 [ Links ]
21.Stephens M, Donnelly P. A comparison of Bayesian methods for haplotype reconstruction from population genotype data. Am J Hum Genet. 2003;73(5):1162-1169. https://doi.org/10.1086/379378 [ Links ]
22.Stephens M, Smith NJ, Donnelly P. A new statistical method for haplotype reconstruction from population data. Am J Hum Genet. 2001;68(4):978-989. https://doi.org/10.1086/319501 [ Links ]
23.Zhang M, Wang S, Wilffert B, et al. The association between the NAT2 genetic polymorphisms and risk of DILI during anti- TB treatment: A systematic review and meta-analysis. Br J Clin Pharmacol. 2018;84(12):2747-2760. https://doi.org/10.1111/bcp.13722 [ Links ]
24.Podgorná E, Diallo I, Vangenot C, et al. Variation in NAT2 acetylation phenotypes is associated with differences in food-producing subsistence modes and ecoregions in Africa. BMC Evol Biol. 2015;15(1):263. https://doi.org/10.1186/s12862-015-0543-6 [ Links ]
25.Patterson N, Petersen DC, Van der Ross RE, et al. Genetic structure of a unique admixed population: Implications for medical research. Hum Mol Genet. 2010;19(3):411-419. https://doi.org/10.1093/hmg/ddp505 [ Links ]
26.De Wit E, Delport W, Rugamika CE, et al. Genome-wide analysis of the structure of the South African Coloured Population in the Western Cape. Hum Genet. 2010;128(2):145-153. https://doi.org/10.1007/s00439-010-0836-1 [ Links ]
27.Chimusa ER, Zaitlen N, Daya M, et al. Genome-wide association study of ancestry-specific TB risk in the South African coloured population. Hum Mol Genet. 2014;23(3):796-809. https://doi.org/10.1093/hmg/ddt462 [ Links ]
28.Hall T. BioEdit: A user-friendly biological sequence alignment editor and analysis program for Windows 95/98/NT. Nucleic Acids Symp Ser. 1999;41:95-98. [ Links ]
29.Tufts University. Court lab Hardy-Weinberg calculator. n.d. [accessed 2020 Aug 14]. Available from: http://emerald.tufts.edu/~mcourt01/Documents/Courtlab-HWcalculator.xls [ Links ]
30.Matimba A, Del-Favero J, Van Broeckhoven C, Masimirembwa C. Novel variants of major drug-metabolising enzyme genes in diverse African populations and their predicted functional effects. Hum Genomics. 2009;3(2):169-190. https://doi.org/10.1186/1479-7364-3-2-169 [ Links ]
31.National Centre for Biotechnology Information (NCBI). Database of Single Nucleotide Polymorphisms (dbSNP). 2020 [accessed 2020 Sep 7]. Available from: https://www.ncbi.nlm.nih.gov/snp [ Links ]
32.Fuselli S, Gilman RH, Chanock SJ, et al. Analysis of nucleotide diversity of NAT2 coding region reveals homogeneity across Native American populations and high intra-population diversity. Pharmacogenomics J. 2007;7(2):144-152. https://doi.org/10.1038/sj.tpj.6500407 [ Links ]
33.Sabbagh A, Langaney A, Darlu P, Gerard N, Krishnamoorthy R, Poloni ES. Worldwide distribution of NAT2 diversity: Implications for NAT2 evolutionary history. BMC Genet. 2008;9(1):21. https://doi.org/10.1186/1471-2156-9-21 [ Links ]
34.Loktionov A, Moore W, Spencer SP, et al. Differences in N-acetylation genotypes between Caucasians and Black South Africans: Implications for cancer prevention. Cancer Detect Prev. 2002;26(1):15-22. https://doi.org/10.1016/S0361-090X(02)00010-7 [ Links ]
35.Centner CM, Carrara H, Harrison T, Benatar M, Heckmann J. Sensory polyneuropathy in human immunodeficiency virus-infected patients receiving tuberculosis treatment. Int J Tuberc Lung Dis. 2014;18(1):27-33. https://doi.org/10.5588/ijtld.13.0375 [ Links ]
36.Golka K, Blaszkewicz M, Samimi M, Bolt HM, Selinski S. Reconstruction of N-acetyltransferase 2 haplotypes using PHASE. Arch Toxicol. 2008;82(4):265-270. https://doi.org/10.1007/s00204-007-0247-9 [ Links ]
37.Pasipanodya JG, Srivastava S, Gumbo T. Meta-analysis of clinical studies supports the pharmacokinetic variability hypothesis for acquired drug resistance and failure of antituberculosis therapy. Clin Infect Dis. 2012;55(2):169-177. https://doi.org/10.1093/cid/cis353 [ Links ]
Correspondence:
Celeste Swart
celeste.swrt@gmail.com
Received: 28 Jan. 2019
Accepted: 14 Sept. 2020
Published: 17 Dec. 2020
ORIGINAL RESEARCH
Sensitivity and specificity of mean platelet volume as a laboratory marker for irritable bowel syndrome: Can it be added to Rome criteria?
Mostafa Vaghari-TabariI, II; Soheila MoeinIII, IV; Durdi QujeqV, VI; Mehrdad KashifardVII; Haydeh AlaoddoleheiVIII; Karimollah Hajian-TilakiIX
IDepartment of Clinical Biochemistry and Laboratory Medicine, Tabriz University of Medical Sciences, Tabriz, Iran
IILiver and Gastrointestinal Diseases Research Center, Tabriz University of Medical Sciences, Tabriz, Iran
IIIMolecular Medicine Research Center, Hormozgan University of Medical Sciences, Bandar Abbas, Iran
IVDepartment of Biochemistry, Faculty of Medicine, Hormozgan University of Medical Sciences, Bandar Abbas, Iran
VCellular and Molecular Biology Research Center (CMBRC), Health Research Insititute, Babol University of Medical Sciences, Babol, Iran
VIDepartment of Clinical Biochemistry, Babol University of Medical Sciences, Babol, Iran
VIIDepartment of Internal Medicine, Gastroenterology Division, Ayatollah Rouhani Hospital, Babol University of Medical Sciences, Babol, Iran
VIIIDepartment of Hematology and Medical Laboratory Sciences, Para Medical Faculty, Babol University of Medical Sciences, Babol, Iran
IXDepartment of Biostatistics and Epidemiology, Babol University of Medical Sciences, Babol, Iran
ABSTRACT
BACKGROUND: Irritable bowel syndrome (IBS) is a functional gastrointestinal disorder.
OBJECTIVE: This study aimed to evaluate red blood cell distribution width (RDW) and mean platelet volume (MPV) as laboratory markers to discriminate IBS patients from both healthy controls and patients with inflammatory bowel disease (IBD)
METHODS: This case-control study enrolled patients referred to Ayatollah Rouhani Hospital, Endoscopy Department, Babol, Iran, for colonoscopy examination from 2015 to 2017. Fifty IBS patients were selected from among patients who had undergone a normal colonoscopy and showed symptoms matching the Rome III criteria. Fifty healthy participants and 50 IBD patients, matched for sex and age, were also enrolled in this study. Both RDW and MPV were measured and analysed by independent sample t-test and receiver operating characteristic curve analysis. A p-value of less than 0.05 was considered statistically significant.
RESULTS: While RDW was higher and MPV was lower among IBS patients compared to healthy controls (p = 0.047 and p = 0.001), there were no significant differences in RDW or MPV levels between IBS and IBD patients. The area under the curve of RDW in the discrimination between IBS and IBD was 0.620 (p = 0.039), and the area under the curve of MPV in the discrimination between healthy controls and IBS patients was 0.801 (p = 0.001).
CONCLUSION: Mean platelet volume is potentially a useful laboratory marker for distinguishing between IBS patients and healthy individuals. Red blood cell distribution width should be considered as a potential marker to distinguish among IBS and IBD patients.
Keywords: IBS; irritable bowel syndrome; inflammatory bowel disease; red blood cell distribution width; mean platelet volume.
Introduction
Bowel disorders have been categorised into organic and functional diseases. Organic diseases have observable and measurable disease processes. For example, these diseases may be associated with tissue damage. Inflammatory bowel disease (IBD) and colorectal cancer are examples of important organic intestinal diseases. There are no organic pathologies such as masses and ulcers in intestinal functional disorders.1 Irritable bowel syndrome (IBS) is one of the most common functional gastrointestinal disorders associated with abdominal pain and a range of other symptoms like stomach cramps, bloating, diarrhoea, constipation, or alternate periods of diarrhoea and constipation.2 The exact pathogenesis of IBS is not clear but it is believed that impairment in the brain-gut axis causes IBS. It seems that multiple factors, including environmental factors such as diet, stress, and intrinsic factors, such as epigenetics and genetics, are involved in IBS pathogenesis and can affect the brain-gut axis.2 Irritable bowel syndrome symptoms and severity vary from one individual to another. Irritable bowel syndrome is commonly diagnosed by clinical signs and symptoms according to the Rome III criteria.3 Although colonoscopy is not required in the diagnosis of IBS, a colonoscopy can be requested to rule out organic diseases such as IBD in patients with rectal bleeding. Based on the Rome III criteria proposed in 2006, an IBS patient is one who has had recurrent discomfort or abdominal pain 3 days per month in the last 3 months and who has met two or more of the following criteria: decrease in pain or discomfort after defecation, change in stool frequency or change in stool form.4 According to signs and symptoms, IBS is divided into four groups, namely: IBS-D-diarrhoea is the predominant symptom; IBS-C-constipation is the predominant symptom; IBS-M-alternating periods of diarrhoea and constipation is a predominant symptom; IBS-U-no predominant symptom is experinced.5,6 In addition to the Rome III criteria, a simple laboratory test with acceptable sensitivity and specificity will aid the diagnosis of IBS.
The effectiveness of laboratory tests for IBS diagnosis is poorly investigated. However, some studies have shown that red blood cell distribution width (RDW) and mean platelet volume (MPV) may be useful for IBS diagnosis.7,8 Both RDW and MPV are hematologic markers with clinical significance and are routinely included in the complete blood count test. Not only is RDW an indicator of erythrocyte size variation and conventionally used for categorisation of anaemia,9 it is also high in some clinical conditions such as autoimmune disease, liver disorder and sickle cell disease.9,10 Some studies have demonstrated high RDW in IBD.11,12 Meanwhile, MPV has been traditionally used for examination of platelet production status in the bone marrow and has clinical importance in some circumstances13; MPV levels may also be altered in hypertension, diabetes and IBD.14 Irritable bowel syndrome is an organic intestinal disease with two major subtypes: ulcerative colitis and Crohn's disease.15 Its clinical signs and symptoms have been shown to have a significant overlap with IBS.5 Some studies of IBD have demonstrated that MPV can be used for assessment of disease activity.14,16,17 Although IBS is conventionally diagnosed based on clinical symptoms, a further laboratory test can be done to increase the validity of the diagnosis. Additionally, patients may need a colonoscopy, for example colonoscopy can be requested for patients who have a family history of IBD. However, this could be avoided if an available laboratory test that accurately discriminates IBS from an organic disorder like IBD. This would also reduce the incidences of colonoscopy. Thus this study evaluated the utility of RDW and MPV as potential laboratory biomarkers to discriminate between IBS and healthy controls as well as for distinguishing among IBS and IBD patients.
Methods
Ethical considerations
This retrospective study is a part of Master of Science (MSc) thesis project (no. 6793) and has conformed to the standards of the World Medical Association, as embodied in the Declaration of Helsinki and the protocol was approved by the Hormozgan University of Medical Sciences Ethical Committee (IR.HUMS.REC.94.182). All patients signed the written informed consent forms provided by Hormozgan University of Medical Sciences and agreed that their medical information could be used in this study. These forms contained information about the project and how patient information was used. To protect patients' personal information, a special code was assigned to each patient's information.
Study design and sample selection
All participants were over 18 years of age and were referred to a gastroenterologist at the Ayatollah Rouhani Hospital, Babol in northern Iran. The consultation period was from September 2015 to January 2017.
Irritable bowel syndrome case group
These were patients whose clinical symptoms matched the Rome III criteria, who had normal C-reactive protein (CRP) and erythrocyte sedimentation rate without organic disorders, confirmed by colonoscopy examination. Patients' symptoms included abdominal pain, diarrhoea, constipation and other IBS symptoms. Primary reasons for colonoscopy included rectal bleeding, family history of colorectal malignancy and positive stool occult blood test. Colonoscopy examination was done by expert gastroenterologists using an Olympus colonoscopy instrument (Olympus, Tokyo, Japan). Irritable bowel syndrome patients with any of the following criteria were excluded: abnormal haemoglobin level, iron deficiency, abnormal blood smear microscopic analysis, any type of cancer, diverticular disease, history of colorectal surgery, any type of blood disease, diabetes, cardiovascular dysfunction, liver and kidney disease, any type of infectious disease, any type of congenital disease or use of non-steroidal anti-inflammatory drugs (e.g. using aspirin before blood sampling and colonoscopy examination).
A case group of 50 patients, 23 women and 27 men, met the inclusion criteria and were enrolled as IBS patients. Among these IBS patients, 18 patients had IBS-D, 17 patients had IBS-C and 15 patients had IBS-M.
Inflammatory bowel disease case group
These were patients diagnosed with IBD by colonoscopy and approved by histopathologic methods. Inflammatory bowel disease patients who met the following criteria were excluded: previous colorectal surgery, diverticular disease, cardiovascular disease, cancers, infectious disease, liver diseases, kidney diseases, congenital blood disorders, diabetes and taking non-steroidal anti-inflammatory drugs before blood sampling.
Fifty IBD patients (14 of them had Crohn's disease and others had ulcerative colitis) were matched for sex and age. Among these IBD patients, 25 patients had active disease and 25 patients were in clinical remission.
Control group
The control group consisted of 50 healthy volunteers, matched for sex and age, who were referred to the laboratory of Ayatollah Rouhani Hospital, in Babol in northern Iran. The healthy participants were selected after consultation with a gastroenterologist. All did not have a colonoscopy examination, clinical signs and symptoms of IBS or a history of IBD. Healthy individuals were excluded if they had: any systemic condition, any type of anaemia or blood disorder, abnormal haemoglobin, abnormal CRP or erythrocyte sedimentation rate levels, abnormal blood smear, abnormal iron levels or IBS sign or symptoms.
Laboratory measurements
A venous blood sample was taken from each participant's arm into ethylenediaminetetraacetic acid-tubes for complete blood count testing. For a precise selection of patients and controls routine laboratory analysis including complete blood count, erythrocyte sedimentation rate, CRP, iron profile and blood smear microscopic analysis was performed for all participants. Red blood cell distribution width and MPV were determined simultaneously with complete blood count in a Sysmex cell counter instrument (Sysmex, Kobe, Japan). The CRP, serum iron and total iron-binding (TIBC) levels were quantitatively measured in an auto-analyser instrument (Hitachi, Tokyo, Japan). The following assay kits were used: Bionic CRP kit (Bionic, Tehran, Iran), serum iron kit (Darman Faraz Kave, Tehran, Iran) and TIBC kit (Darman Faraz Kave, Tehran, Iran). Serum ferritin level was measured by the enzyme-linked immunosorbent assay method according to the ferritin enzyme-linked immunosorbent assay kit instructions (Pishtaz Teb, Tehran, Iran) and using an RT2100c enzyme-linked immunosorbent assay reader instrument (Raytolife, Hamburg, Germany). Erythrocyte sedimentation rate was measured by the conventional Westergren method. In this method, 2 mL of blood sample collected in a tube containing 0.4 mL of sodium citrate was transferred to a standard Westergren-Katz tube. The tube was set to stand for 1 h, for erythrocytes to settle. The column of separated plasma was measured, along with the rate of settling in millimetres per hour.
Statistical analysis
The data obtained were analysed using an IBM Statistical Package for the Social Sciences (SPSS software version 17, Armonk, New York, United States). The independent sample t-test was used for comparing variable means between groups. The receiver operating characteristic analysis was also used for comparing the utility of MPV and RDW for discrimination between IBS patients and healthy controls as well as for discrimination between IBS and IBD patients. P-values less than 0.05 were considered as statistically significant.
Results
Our data demonstrated that the MPV level was significantly reduced while the RDW level was significantly elevated in IBS patients when compared with those of healthy subjects, but the levels of the same parameters were not significantly different between IBS and IBD patients (Table 1).
Receiver operating characteristic analysis showed that MPV has a larger area under the curve (0. 801, p = 0.001) than RDW (Figure 1, Figure 2, Table 2) in differentiating between the healthy control and IBS patients. Mean platelet volume had a 68% sensitivity and 88% specificity at 9.55 femtoliter.



Receiver operating characteristic analysis showed that RDW compared to MPV had a larger but not significant area under the curve of 0.620 (p = 0.039) for differentiating between IBS and IBD patients (Figure 3, Figure 4, Table 3). The best cut-off point for RDW was a value of 13.05%, with 72% sensitivity and 56% specificity, to help discriminate IBD patients from IBS patients.



Discussion
Our results showed that there was not a significant difference in RDW and MPV between IBS and IBD patients. Although average RDW among IBS patients was lower compared with RDW among IBD patients, the difference was not statistically significant (p = 0.068). However, this difference could become meaningful if the sample size were increased. Our data also showed that, in comparison with healthy controls, the mean MPV was lower while RDW was higher among IBS patients, which could be due to subclinical inflammation in IBS patients. Subclinical inflammation in IBS has been previously reported in some studies,18,19 and it is well known that MPV and RDW can be altered in inflammatory conditions.11,12,14 Our findings augment the hypothesis that subclinical inflammation has a role to play in IBS. However, further studies in this regard are needed. Our findings, in contrast to a study conducted in Turkey, showed that the MPV levels were higher among IBS patients than among healthy controls.7 This inconsistency may be due to the difference in study populations or inclusion criteria. In our study, the results of receiver operating characteristic curve analysis showed that the area under the curve, sensitivity and specificity of MPV for IBS diagnosis are acceptable. The use of receiver operating characteristic curve analysis to evaluate the utility of MPV in IBS diagnosis has not been previously presented by other studies; thus, a direct comparison of our results with other studies, results was not possible. Inflammatory bowel disease is a complex gastrointestinal disease and multiple factors are involved in its pathogenesis.20,21,22 According to our results, RDW has a relatively low specificity for differentiating between IBD and IBS patients. Our results are similar to a study conducted in Hungary that reported 92% specificity and 78% sensitivity for RDW (cut-off: 13.4%) in active Crohn's disease diagnosis. These researchers also reported that in the majority of IBS patients RDW was normal. They however did not evaluate the specificity and sensitivity of RDW in discriminating between IBD and IBS.23
Further studies are needed to evaluate the utility of RDW as a diagnostic marker. There are very few studies investigating laboratory diagnosis of IBS and it is proposed that the MPV may be used as an IBS biomarker. A mean platelet volume test in addition to the clinical parameters of the Rome criteria can improve the diagnosis of IBS.
Limitations
Our study has some limitations. Firstly, a major study limitation is that our sample size was relatively low because the aim of the study was primarily to evaluate the utility of RDW and MPV for laboratory diagnosis of IBS. Budget and time limitations further limited the possible sample size. The second limitation of our study was that we could not assess the other laboratory factors to discriminate between healthy controls and IBS patients. However, we used rigorous inclusion and exclusion criteria for patient selection in an attempt to mitigate the influence of confounding conditions.
Conclusion
Red blood cell distribution width was higher while the MPV level was lower among IBS patients compared to healthy controls, although the same parameters did not differ significantly when compared with IBD patients. Mean platelet volume is a potential marker with adequate sensitivity and specificity to discriminate healthy controls from IBS patients. However, it is not useful for discriminating between IBD and IBS patients. Red blood cell distribution width could be a potential marker for differentiation between IBD and IBS. Further studies with a sufficiently large sample size are needed for a comprehensive evaluation of the utility of these potential biomarkers to discriminate between healthy controls, IBS patients and IBD patients.
Acknowledgements
The authors express their thanks to Hormozgan University of Medical Sciences. The authors also thank the personnel of the Endoscopy Department of Ayatollah Rouhani Hospital and the laboratory personnel. Moreover, the authors wish to express their gratitude to Dr Javad Shokri-Shirvani, Dr Seyed Saeid Mohammadi, Tooba Yousefi, Koroush Rasoulpour, Hamed Ghasem Tabar and Maryam Ghasemnejad for their helpful and professional assistance.
Competing interests
The authors have declared that no competing interests exist.
Authors' contributions
D.Q. designed the experiments. M.V.-T. performed the experiments. K.H.-T. analysed the data and S.M. contributed to the writing and revising of the manuscript. M.K. selected the patients based on colonoscopy examination and H.A. helped in the performance of haematology tests and analysed these tests.
Sources of support
This project was funded by Prof. Soheila Moein. Also, this investigation was partly supported by the grant no. 9437 from the Research Council of Hormozgan University of Medical Sciences.
Data availability statement
Our data are available from the corresponding author upon reasonable request.
Disclaimer
The views and opinions expressed in this article are those of the authors and do not necessarily reflect the official policy or position of any affiliated agency of the authors.
References
1.Drossman DA. Functional GI disorders: What's in a name? Gastroenterology. 2005;128(7):1771-1772. https://doi.org/10.1053/j.gastro.2005.04.020 [ Links ]
2.Gazouli M, Wouters MM, Kapur-Pojskic L, et al. Lessons learned-resolving the enigma of genetic factors in IBS. Nat Rev Gastroenterol Hepatol. 2016;13(2):77-87. https://doi.org/10.1038/nrgastro.2015.206 [ Links ]
3.Saha L. Irritable bowel syndrome: Pathogenesis, diagnosis, treatment, and evidence-based medicine. World J Gastroenterol. 2014;20(22):6759-6773. https://doi.org/10.3748/wjg.v20.i22.6759 [ Links ]
4.Shih DQ, Kwan LY. All roads lead to Rome: Update on Rome III criteria and new treatment options. Gastroenterol Rep. 2007;1(2):56-65. [ Links ]
5.Lacy BE, Mearin F, Chang L, et al. Bowel disorders. Gastroenterology. 2016;150(6):1393-1407. https://doi.org/10.1053/j.gastro.2016.02.031 [ Links ]
6.Enck P, Aziz Q, Barbara G, et al. Irritable bowel syndrome. Nat Rev Dis Prim. 2016;2:16014. https://doi.org/10.1038/nrdp.2016.14 [ Links ]
7.Aktas G, Alcelik A, Tekce BK, Tekelioglu V, Sit M, Savli H. Red cell distribution width and mean platelet volume in patients with irritable bowel syndrome. Prz Gastroenterol. 2014;9(3):160-163. https://doi.org/10.5114/pg.2014.43578 [ Links ]
8.Coskun A, Yavasoglu I, Sargin G, et al. The role of mean platelet volume in patients with non-specific abdominal pain in an emergency department. Prz Gastroenterol. 2015;10(3):156-159. https://doi.org/10.5114/pg.2015.49042 [ Links ]
9.Lippi G, Plebani M. Red blood cell distribution width (RDW) and human pathology. One size fits all. Clin Chem Lab Med. 2014;52(9):1247-1249. https://doi.org/10.1515/cclm-2014-0585 [ Links ]
10.Sahli CA, Bibi A, Ouali F, et al. Red cell indices: Differentiation between β-thalassemia trait and iron deficiency anemia and application to sickle-cell disease and sickle-cell thalassemia. Clin Chem Lab Med. 2013;51(11):2115-2124. https://doi.org/10.1515/cclm-2013-0354 [ Links ]
11.Arhan M, Önal İK, Taş A, et al. The role of red cell distribution width as a marker in inflammatory bowel disease. Turk J Med Sci. 2011;41(2):227-234. [ Links ]
12.Yeşil A, Senateş E, Bayoğlu I, Erdem ED, Demirtunç R, Kurdaş Övünç A. Red cell distribution width: A novel marker of activity in inflammatory bowel disease. Gut Liver. 2011;5(4):460-467. https://doi.org/10.5009/gnl.2011.5.4.460 [ Links ]
13.Bancroft AJ, Abel EW, McLaren M, Belch JJ. Mean platelet volume is a useful parameter: A reproducible routine method using a modified Coulter thrombocytometer. Platelets. 2000;11(7):379-387. https://doi.org/10.1080/09537100020008311 [ Links ]
14.Gasparyan AY, Ayvazyan L, Mikhailidis DP, Kitas GD. Mean platelet volume: A link between thrombosis and inflammation? Curr Pharm Des. 2011;17(1):47-58. https://doi.org/10.2174/138161211795049804 [ Links ]
15.Moein S, Vaghari-Tabari M, Qujeq D, Majidinia M, Nabavi SM, Yousefi B. MiRNAs and inflammatory bowel disease: An interesting new story. J Cell Physiol. 2019;234(4):3277-3293. https://doi.org/10.1002/jcp.27173 [ Links ]
16.Kapsoritakis AN, Koukourakis MI, Sfiridaki A, et al. Mean platelet volume: A useful marker of inflammatory bowel disease activity. Am J Gastroenterol. 2001;96(3):776-781. https://doi.org/10.1111/j.1572-0241.2001.03621.x [ Links ]
17.Yüksel O, Helvacı K, BaŞar Ö, et al. An overlooked indicator of disease activity in ulcerative colitis: Mean platelet volume. Platelets. 2009;20(4):277-281. https://doi.org/10.1080/09537100902856781 [ Links ]
18.De Silva AP, Nandasiri SD, Hewavisenthi J, et al. Subclinical mucosal inflammation in diarrhea-predominant irritable bowel syndrome (IBS) in a tropical setting. Scand J Gastroenterol. 2012;47(6):619-624. https://doi.org/10.3109/00365521.2012.666672 [ Links ]
19.Tornblom H, Lindberg G, Nyberg B, Veress B. Full-thickness biopsy of the jejunum reveals inflammation and enteric neuropathy in irritable bowel syndrome. Gastroenterology. 2002;123(6):1972-1979. https://doi.org/10.1053/gast.2002.37059 [ Links ]
20.Vaghari-Tabari M, Moein S, Qujeq D, Kashifard M, Hajian-Tilaki K. Positive correlation of fecal calprotectin with serum antioxidant enzymes in patients with inflammatory bowel disease: Accidental numerical correlation or a new finding? Am J Med Sci. 2018;355(5):449-455. https://doi.org/10.1016/j.amjms.2017.12.009 [ Links ]
21.Mohammadi E, Qujeq D, Taheri H, Hajian-Tilaki K. Evaluation of serum trace element levels and superoxide dismutase activity in patients with inflammatory bowel disease: Translating basic research into clinical application. Biol Trace Elem Res. 2017;177(2):235-240. https://doi.org/10.1007/s12011-016-0891-0 [ Links ]
22.De Souza HS, Fiocchi C. Immunopathogenesis of IBD: Current state of the art. Nat Rev Gastroenterol Hepatol. 2016;13(1):13-27. https://doi.org/10.1038/nrgastro.2015.186 [ Links ]
23.Farkas K, Papp M, Nyári T, et al. Red blood cell distribution width in combination with serological markers can help in the differentiation between Crohn's disease and ulcerative colitis. Open Gastroenterol J. 2010;4:1-4. https://doi.org/10.2174/1874259901004010001 [ Links ]
Correspondence:
Soheila Moein
soheila_9@yahoo.com
Received: 24 Feb. 2019
Accepted: 14 Sept. 2020
Published: 21 Dec. 2020
ORIGINAL RESEARCH
Serologic evidence of seasonal influenza A and B in HIV patients on combined antiretroviral therapy in Lagos, Nigeria
AbdulAzeez A. Anjorin; Barakat A. Adepoju
Department of Microbiology, Faculty of Science, Lagos State University, Ojo, Nigeria
ABSTRACT
BACKGROUND: Influenza and HIV are endemic in Nigeria but there is no epidemiological data on the co-infection of influenza A and B among HIV patients.
OBJECTIVE: We investigated seasonal influenza A and B, and co-infection among HIV patients on combined antiretroviral therapy (cART) in Lagos, Nigeria.
METHODS: In a prospective cross-sectional study, clear sera collected from 174 HIV-positive patients between August and September 2018 were analysed for immunoglobulin M-specific antibodies to seasonal influenza A subtypes H1N1 and H3N2, and influenza B by enzyme immunoassay.
RESULTS: A total of 39.7% (69/174) of HIV patients were seropositive for influenza A or B viruses with 84.1% (58/69) being positive for influenza A, 13.04% (9/69) seropositive for both influenza A and B, and only 2.9% (2/69) positive for influenza B mono-infection. Median age was 44 (mean 45, mode 40, range 18-74) years. The 41-50 years age group had the highest seroprevalence (39.1%; 27/69). Seropositivity was highest among women (65.2%; 45/69). A total of 88.4% (61/69) of HIV patients seropositive for influenza A or B were on fixed dose cART, while 73.9% (51/69) were virologically suppressed. Furthermore, 27.5% (19/69) were immunocompromised, of which 21.1% (4/19) were severely immunosuppressed (cluster of differentiation 4 < 200 cells/mm>3
CONCLUSION: Influenza A and B was prevalent among HIV patients on cART, which may predispose them to life-threatening complications. We recommend strong advocacy on the need to reduce the risk of exposure to influenza and for the provision of an influenza vaccine in Nigeria.
Keywords: influenza A; influenza B; HIV co-infection; seroprevalence; Lagos.
Introduction
In humans, seasonal influenza viruses cause an annual 3-5 million illnesses and 290 000-650 000 deaths worldwide.1 The majority of the deaths and severe illness occur in low- and middle-income countries2 especially in Africa where there is little or scanty information on epidemiological surveillance. Influenza virus infection can be self-limiting and could vary in severity from asymptomatic to fatal disease arising from medical complications. These complications include pneumonia, meningitis and worsening of underlying medical conditions, mostly in immunocompromised individuals.1
On the other hand, HIV is a retrovirus that spreads through the body rapidly, causing damage to the immune system by attacking host cluster of differentiation 4 (CD4) cells with resultant AIDS.3 In 2017, HIV-related causes killed about 1 million people worldwide, having claimed over 35 million lives in the last three decades.4
According to the World Health Organization,4 as of 2018, 1.8 million newly infected individuals were added to the 36.9 million people living with HIV, with 25.7 million (> 66%) infected people living in the sub-Saharan Africa region.4,5 There are about 197 997 230 people living in Nigeria, equivalent to 2.57% of the total world population (www.worldometers.info), with up to 3.2 million people living with HIV.6 This is the second-largest HIV epidemic after South Africa and represents 9% of the total population living with HIV globally, among whom 1 million people are on antiretroviral therapy (ART).6,7,8 Lagos State with a total population of about 21 million has a HIV prevalence of 2.2%.
Influenza viral infection is a common cause of respiratory illness among HIV-infected persons in whom it can be more severe and prolonged.9 HIV has also been described as the most common underlying risk factor in patients with respiratory infection.10 Influenza virus co-infections in HIV-infected patients cause a 4-8 times higher incidence of hospitalisation and death compared to non-HIV-infected individuals.11 The reduction in the number of CD4 T-cells due to infection with HIV causes immunodeficiency and thus higher susceptibility to complications of influenza in HIV patients.12
In general, the immunogenicity of influenza viral infections in HIV-infected patients is directly proportional to the CD4 cell count and correlates negatively to the viral load.13 Studies have also shown that better immune health (i.e. higher CD4 cell counts and suppressed viral load of HIV patients on combined antiretroviral therapy [cART]) in comparison with immunocompromised patients made them less likely to experience prolonged shedding of influenza virus.9
However, a lack of epidemiological data on seasonal influenza in HIV-positive individuals is a major problem preventing the development of national policies on influenza preventive strategies in sub-Saharan Africa, including Nigeria. In South Africa, 44% of influenza positive patients having acute respiratory infections are HIV-infected.10 No data is available on influenza virus infection in HIV patients from Nigeria and that underscores the importance of this study.
Serological assays usually complement epidemiological and clinical investigations in the detection and identification of influenza viruses. They measure antibodies developed in response to infection with antigenically novel and seasonal influenza viruses.14 The enzyme-linked immunosorbent assay method has been used in different studies for detecting serological evidence of the influenza virus in humans15,16,17 because it is apt, easy, fast, can be automated and is commercially available for large-scale sero survey, targeting specific antibodies against different subtypes of influenza virus. It is also affordable for sero epidemiology in poor and limited resource settings.
This study was therefore designed to investigate seasonal influenza A and B virus infections in HIV patients on cART in Lagos, Nigeria.
Methods
Ethical considerations
Permission was sought from the head of the AIDS prevention initiative in Nigeria (APIN) clinic where the samples were collected after tendering the ethical approval (reference no.: LREC.06/10/1030) obtained from the Health Research and Ethics Committee of the Lagos State University Teaching Hospital (LASUTH).
Study area, population and design
A prospective cross-sectional study was designed. Outpatients attending the AIDS prevention initiative in Nigeria (APIN)-Lagos University Teaching Hospital clinic who were previously laboratory confirmed to be HIV-positive were recruited for this study from August 2018 to September 2018. APIN-Lagos University Teaching Hospital clinic is a large university-based HIV clinic in Lagos, Nigeria, with about 15 000 patients currently enrolled in Lagos. After explaining the concept of the study, a total of 174 HIV patients, including 165 on cART, who were unvaccinated for influenza and gave both oral and written informed consent, were bled by venepuncture. Demographic and clinical data were appropriately collected with a designed questionnaire. Results of further laboratory analyses including CD4 count, RNA viral load and cART regimen were obtained from the patients' clinical records.
Sample collection and treatment
Approximately 5 mL of whole blood samples were collected into sterile plain bottles. They were stored in sample coolers stacked with ice packs before being conveyed to the laboratory. The samples were centrifuged at 704 × g for 15 min to obtain clear sera that were aliquoted into labelled sterile plain cryovial tubes. The sera were then stored away at −30 °C until ready for serological analysis.
Laboratory analysis
Clear sera were analysed for the detection and quantitative determination of immunoglobulin M antibody specific for influenza virus by enzyme-linked immunoassay (Demeditec Diagnostics GmbH, Kiel, Germany) in the Department of Microbiology (Virology Research) Laboratory, Lagos State University, Ojo. Following manufacturer's instructions, sufficient amounts of micro titre wells were prepared for the standards, controls and samples as well as for the substrate blank. The samples were diluted with ready-to-use sample diluent provided with the test kit in the ratio 1:100 (2 µL serum + 200 µL sample diluents). Assay absorbance was read at a wavelength of 450 nanometres with an EMax precision Microplate reader (Molecular Devices, LLC, San Jose, California, United States). Sample results were compared with the included standards and controls and were interpreted based on the assay standard curve as recommended by the manufacturer. It should however be noted that positive immunoglobulin M antibody specific for influenza virus implies a recent immunological reaction to circulating live influenza strains as a result of infection since Nigeria does not currently practise influenza vaccination.
Statistical analysis
Raw data were entered into Microsoft Excel, version 2013 (Microsoft Corporation, Redmond, Washington, United States). Descriptive statistics was performed while inferential statistics was analysed with chi-square at p less than 0.05 for statistical significance using GraphPad Prism version 8.0.1 (GraphPad Software Inc., San Diego, California, United States).
Results
Out of the 174 HIV-positive patients tested, 69/174 (39.7%) were seropositive for influenza A or B viruses, with 58/69 (84.1%) positive for influenza A, 2/69 (2.9%) for influenza B, and 9/69 (13.0%) for both influenza A and B (Table 1). The median age of patients was 44, mean 45, mode 40, and range 18-74 years. Seropositivity was higher in female patients (45/69; 65.2%) compared to male patients (17/69; 24.6%). A total of 51/69 (73.9%) of the patients were virologically suppressed with HIV RNA under 400 copies/mL, and 19/69 (27.5%) were immunocompromised (CD4 < 400 cells/mm3). Out of the immunocompromised patients, 4/19 (21.1%) were severely immunosuppressed (CD4 < 200 cells/mm3). 61/69 (88.4%) of HIV patients seropositive for influenza A or B were on fixed dose cART compared to those that were seronegative: 96/105 (91.4%) (p < 0.001).
The most commonly prescribed cART used as a single-pill combination at the APIN clinic included atazanavir, azidothymidine, efavirenz, lamivudine, lopinavir or ritonavir, nevirapine, and tenofovir (Table 2). The majority of patients received a combined therapy of tenofovir, lamivudine and efavirenz (74/174; 42.5%) or azidothymidine, lamivudine and nevirapine (64/174; 36.8%).
Seroprevalence was highest in patients aged 41-50 years (39.1%; 27/69), with no detections in the age groups 61-70 and 71-80 years (Figure 1).
Discussion
In this study, we described the recent infection of seasonal influenza A and B, and their co-infection, among HIV patients on cART in Lagos, Nigeria, with a high predominance of influenza A virus. While a high proportion of the patients were virologically suppressed, having HIV RNA under 400 copies/mL, 27.5% of them were immunocompromised while 21.1% were severely immunosuppressed (CD4 < 200 cells/mm3). The hospital population-based study revealed an overall seasonal influenza serological prevalence of 39.7% (69/174) that will serve as a baseline for other studies in Nigeria. We defined the seasonal influenza virus as any type or subtype of influenza virus including influenza A or B that are commonly circulating in our environment at any particular point in time as against a pandemic influenza virus. To our knowledge, this is the first study on clinical and sero-epidemiological prevalence of influenza viruses in HIV patients on cART in Nigeria.
The seroprevalence rate is comparable with the 31% serological response recorded in HIV-positive individuals in Miami, United States.18 A significantly lower seroprevalence rate of 14.7% was recorded in Taiwan.19 A higher prevalence rate of 71.6% for influenza-specific antibody responses in HIV patients was recorded in Rome, Italy.20 In Africa, lower prevalence rates of 11% and 24.5% were also recorded in Malawi and Kenya.21,22 The disparity observed in the prevalence rates could be attributed to differences in many factors including sample size and the assay type used.
Our investigation further revealed that 84.1% (58/69) were immunoglobulin M seropositive for influenza A, indicating an epidemiological predominance of the influenza A over the influenza B virus during the study period in Lagos, Nigeria. In a study conducted in Malawi,21 it was also reported that in low-resource settings with high HIV prevalence, there is a high prevalence of influenza illness and greater risk of hospitalisation among HIV-infected persons which supports the high prevalence rate of influenza A detected in this study.
Interestingly, 13.04% (9/69) of the HIV patients were seropositive for both influenza A and B viruses. Co-infection of influenza A and B viruses in HIV patients may exacerbate the immunocompromised status by further impairing T-cell responses with resultant fatal consequences in such individuals. This position agrees with previous studies that influenza in HIV-infected persons leads to increased and prolonged hospitalisation, and an elevated risk of in-hospital death.9,11 Furthermore, it is evident from previous reports that even mono-infection due to influenza A (H1N1) pandemic09 (now seasonal influenza virus) caused severe pneumonia leading to acute respiratory distress syndrome and multiple organ dysfunction associated with deaths.23,24 Hence, simultaneous detection of influenza A and B in patients calls for serious public health intervention to ameliorate the menace of influenza co-infection especially in people living with HIV.
Our study demonstrated the highest 39.1% seroprevalence of influenza among HIV patients in the age group 41-50 years which disagrees with the United States Centers for Disease Control and Prevention report that persons older than 65 years are more likely to be at risk of the influenza virus.25 Our observation is however supported by earlier findings in South Africa in 2009 to 201111 and the United States in 201326 which reported that on account of hospitalisation and mortality rates, older adults do not have the highest rate of infection and do not represent the main contributors to local outbreaks.
Based on gender, a higher 65.2% seroprevalence was detected among women compared to 24.6% among men in our study, which is consistent with findings from Malawi27 that reported higher seroprevalence among women. In contrast, a United States study recorded a higher seroprevalence in men than in women.9 A suggested reason for the higher seroprevalence among women could be the overwhelming burden of HIV that affects more women in sub-Saharan Africa making them more susceptible to influenza infection.
Of the 19/69 (27.5%) immunocompromised patients seropositive for the influenza virus, 4/19 (21.1%) were severely immunosuppressed (CD4 < 200 cells/mm3). However, the role of CD4 and its impact on influenza in HIV-positive patients is poorly understood, partly due to their heterogeneity and lack of epitope-specific systems.28
Contrary to studies in South Africa from 2009 to 201111 and 2012-2016,29 the prevalence of influenza in the current study was higher among individuals with a CD4 count over 400 compared to those with a lower CD4 count. However, it should be noted that the South African study11 reported influenza based on detection of virus nucleic acids in symptomatic patients whereas the current study detected with serology a fraction of patients who had asymptomatic influenza infections. Similar to this study, a study in the United States from 2010 to 20119 recorded a higher prevalence of influenza in patients with a CD4 count over 200 cells/mm3 than those with less than 200 cells/mm3. One possible explanation for these observations is the traditionally accepted role of influenza-specific CD4 T-cells in providing help to B-cells for the production of high-quality antibodies.30 Hence, depletion of CD4 T-cells prior to influenza virus infection may be responsible for the low prevalence observed.
People with a viral load under 400 copies/mL (73.9%) had the highest seroprevalence of influenza virus. This agrees with a study in the United States between 2010 and 20119 that detected influenza virus in 85% of virologically suppressed (HIV RNA < 400 copies/mL) patients. This indicates that reduced viraemia of HIV does not reduce the susceptibility of HIV patients to the influenza virus.
Among the 165 HIV patients on a fixed dose combination of some regularly prescribed cART including tenofovir, emtricitabine, azidothymidine, atazanavir, efavirenz, nevirapine, and lopinavir or ritonavir, 61 (37%) were seropositive for influenza A and B viruses. The direct relationship of cART on patients and their seropositivity to influenza is not well understood. Nonetheless, our study demonstrated that HIV patients on cART were susceptible to recent infection with influenza viruses. In support of this finding, a systematic review done on co-infections and comorbidities of influenza in Africa from 1900 to 20132 estimated an increased risk of influenza-associated mortality among HIV-positive individuals even after the widespread introduction of cART. Also, a study in the United States from 2011 to 201218 concluded that regardless of influenza vaccination and control of viral load with cART, HIV-infected patients are at an elevated risk of acquiring seasonal influenza infection. However, in Malawi, the introduction of highly active antiretroviral therapy has led to the reduction of influenza-related complications among HIV-infected patients.31
Limitations
One of the limitations of this study is that positive samples for the influenza virus by enzyme linked immunoassay could not be further tested by polymerase chain reaction due to the cost implication. Also, serological evidence from different HIV treatment centres are necessary for representative data in Nigeria. Another limitation is that an HIV-uninfected control group was not included in the study for possible comparison of the prevalence rates of influenza. Finally, it should be noted that the study was conducted over one influenza season and therefore the impact of seasonal changes in influenza strains was not studied. Rather our study has provided sero-epidemiological data on the commonly circulating seasonal influenza virus in HIV patients.
Conclusion
This study demonstrated using serology that HIV patients on cART are susceptible to both influenza A and B viruses. It however revealed low seroprevalence of influenza B mono-infection, and influenza A and B co-infections among HIV patients. Viral co-infections may further impair the already compromised immune system of HIV patients. Strong advocacy on the need to reduce risk of exposure to influenza, and for provision of an influenza vaccine in Nigeria, is recommended to prevent or reduce the complications of viral co-infection.
Acknowledgements
We sincerely acknowledge all the patients who volunteered to be part of this study. We acknowledge the Lagos State University Teaching Hospital (LASUTH) Directorate of Clinical Services and Training and the Hospital Research Ethics Committee for the approval of the study research proposal. We are grateful to the Management and Staff of APIN-Lagos University Teaching Hospital for the approval for sample collection. Special thanks to all the laboratory technologists who supported the student's research work. Many thanks to all the senior faculty members who criticised and reviewed the initial manuscript. The abstract for this study was presented at the 52nd Miami Winter Symposium 2019: Evolving Concepts in HIV & Emerging Viral Infections, organised by Elsevier, University of Miami Miller School of Medicine, International Union of Biochemistry and Molecular Biology in Florida, United States (27-30 January 2019).
Competing interests
The authors have declared that no competing interest exists.
Authors' contributions
A.A.A. was responsible for experimental design and research supervision, data analysis, laboratory investigation and manuscript writing. B.A.A. was responsible for sample collection, laboratory investigation, data analysis and manuscript writing.
Sources of support
This research received no specific grant from any funding agency in the public, commercial or not-for-profit sectors.
Data availability statement
Data sharing is not applicable to this article as no new data were created or analysed in this study.
Disclaimer
The views and opinions expressed in this article are those of the authors and do not necessarily reflect the official policy or position of any affiliated agency of the authors.
References
1.WHO. Influenza (seasonal) signs and symptoms [homepage on the Internet]. Geneva: WHO; 2019 [cited 2019 Feb 06]. Available from: https://www.who.int/news-room/fact-sheets/detail/influenza-(seasonal) [ Links ]
2.Cohen AL, McMorrow M, Walaza S, et al. Potential impact of co-infections and co-morbidities prevalent in Africa on influenza severity and frequency: A systematic review. PLoS One. 2015;10(6):e0128580. https://doi.org/10.1371/journal.pone.0128580 [ Links ]
3.CDC. HIV basics [homepage on the Internet]. Atlanta, GA: CDC; 2018 [cited 2019 Feb 06]. Available from: https://www.cdc.gov/hiv/basics/index.html [ Links ]
4.WHO. HIV/AIDS key facts [homepage on the Internet]. Geneva: WHO; 2018 [cited 2019 Feb 05]. Available from: https://www.who.int/en/news-room/fact-sheets/detail/hiv-aids [ Links ]
5.UNAIDS. Joint United Nations Programme on HIV and AIDS, 2015. Factsheet 2015: World AIDS day 2015. Geneva: UNAIDS; 2015. [ Links ]
6.Awofala AA, Ogundele OE. HIV epidemiology in Nigeria. Saudi J Biol Sci. 2018;25(4):697-703. https://doi.org/10.1016/j.sjbs.2016.03.006 [ Links ]
7.UNAIDS. Country factsheets Nigeria 2017: HIV and AIDS estimates [homepage on the Internet]. UNAIDS; 2017 [cited 2019 Feb 06]. Available from: http://www.unaids.org/en/regionscountries/countries/nigeria [ Links ]
8.UNAIDS. UNAIDS data 2018: World's response to HIV [homepage on the Internet]. Geneva: UNAIDS; 2018 [cited 2019 Feb 06]. Available from: http://www.unaids.org/sites/default/files/media_asset/unaids-data-2018_en.pdf [ Links ]
9.Patel P, Bush T, Kojic EM, et al. Duration of influenza virus shedding among HIV-infected adults in the cART era, 2010-2011. AIDS Res Hum Retrovir. 2016;32(12):1180-1186. https://doi.org/10.1089/aid.2015.0349 [ Links ]
10.Abadom TR, Smith AD, Tempia S, Madhi SA, Cohen C, Cohen AL. Risk factors associated with hospitalization for influenza-associated severe acute respiratory illness in South Africa: A case-population study. Vaccine. 2016;34(46):5649-5455. https://doi.org/10.1016/j.vaccine.2016.09.011 [ Links ]
11.Cohen C, Moyes J, Tempia S, et al. Severe influenza-associated respiratory infection in high HIV prevalence setting, South Africa, 2009-2011. Emerg Infect Dis. 2013;19(11):1766. https://doi.org/10.3201/eid1911.130546 [ Links ]
12.Castrucci MR. Factors affecting immune responses to the influenza vaccine. Hum Vaccin Immunother. 2018;14(3):637-646. https://doi.org/10.1080/21645515.2017.1338547 [ Links ]
13.Ceravolo A, Orsi A, Parodi V, Rosselli R, Ansaldi F. Influenza vaccination in HIV-positive subjects: Latest evidence and future perspective. J Prevent Med Hyg. 2013;54(1):1. [ Links ]
14.Laurie KL, Huston P, Riley S, et al. Influenza serological studies to inform public health action: Best practices to optimise timing, quality and reporting. Influenza Other Respir Viruses. 2013;7(2):211-224. https://doi.org/10.1111/j.1750-2659.2012.0370a.x [ Links ]
15.Alsuwaidi AR, Al-Mekaini LA, Kamal SM, Narchi H, Souid A-K. Seroprevalence of influenza A and B viruses among unvaccinated children in the United Arab Emirates: A cross-sectional study. BMC Res Notes. 2017;10(1):379. https://doi.org/10.1186/s13104-017-2720-8 [ Links ]
16.Anjorin A, Oyefolu A, Omilabu S. Seasonal influenza virus infection among unvaccinated pregnant women in Lagos, Nigeria. Int J Infect Dis. 2018;73(Suppl.):368. https://doi.org/10.1016/j.ijid.2018.04.4248 [ Links ]
17.Sauerbrei A, Langenhan T, Brandstädt A, et al. Prevalence of antibodies against influenza A and B viruses in children in Germany, 2008 to 2010. Eurosurveillance. 2014;19(5):20687. https://doi.org/10.2807/1560-7917.ES2014.19.5.20687 [ Links ]
18.Parmigiani A, Alcaide ML, Freguja R, et al. Impaired antibody response to influenza vaccine in HIV-infected and uninfected aging women is associated with immune activation and inflammation. PLoS One. 2013;8(11):e79816. https://doi.org/10.1371/journal.pone.0079816 [ Links ]
19.Hung C-C, Zhao T-L, Sun H-Y, et al. Seroepidemiology of novel influenza A (H1N1) infection among HIV-infected patients in the era of highly active antiretroviral therapy. J Microbiol Immunol Infect. 2013;46(3):151-157. https://doi.org/10.1016/j.jmii.2012.03.002 [ Links ]
20.Agrati C, Gioia C, Castilletti C, et al. Cellular and humoral immune responses to pandemic influenza vaccine in healthy and in highly active antiretroviral therapy-treated HIV patients. AIDS Res Hum Retrovir. 2012;28(12):1606-1616. https://doi.org/10.1089/aid.2011.0371 [ Links ]
21.Ho A, Aston SJ, Jary H, et al. Impact of human immunodeficiency virus on the burden and severity of influenza illness in Malawian adults: A prospective cohort and parallel case-control study. Clin Infect Dis. 2017;66(6):865-876. https://doi.org/10.1093/cid/cix903 [ Links ]
22.Ope MO, Katz MA, Aura B, et al. Risk factors for hospitalized seasonal influenza in rural western Kenya. PLoS One. 2011;6(5):e20111. https://doi.org/10.1371/journal.pone.0020111 [ Links ]
23.Domínguez-Cherit G, Lapinsky SE, Macias AE, et al. Critically ill patients with 2009 influenza A (H1N1) in Mexico. JAMA. 2009;302(17):1880-1887. https://doi.org/10.1001/jama.2009.1536 [ Links ]
24.Perez-Padilla R, De la Rosa-Zamboni D, Ponce de Leon S, et al. Pneumonia and respiratory failure from swine-origin influenza A (H1N1) in Mexico. N Engl J Med. 2009;361(7):680-689. https://doi.org/10.1056/NEJMoa0904252 [ Links ]
25.CDC. Influenza: People 65 years and older & influenza [homepage on the Internet]. Atlanta, GA: Centers for Disease Control and Prevention, National Center for Immunization and Respiratory Diseases (NCIRD); 2018 [cited 2019 Feb 07]. Available from: https://www.cdc.gov/flu/about/disease/65over.htm [ Links ]
26.Lambert ND, Ovsyannikova IG, Pankratz VS, Jacobson RM, Poland GA. Understanding the immune response to seasonal influenza vaccination in older adults: A systems biology approach. Exp Rev Vaccin. 2012;11(8):985-994. https://doi.org/10.1586/erv.12.61 [ Links ]
27.Ho A, Mallewa J, Peterson I, et al. Epidemiology of severe acute respiratory illness and risk factors for influenza infection and clinical severity among adults in Malawi, 2011-2013. Am J Trop Med Hyg. 2018;99(3):772-779. https://doi.org/10.4269/ajtmh.17-0905 [ Links ]
28.Sant AJ, McMichael A. Revealing the role of CD4(+) T cells in viral immunity. J Exp Med. 2012;209(8):1391-1395. https://doi.org/10.1084/jem.20121517 [ Links ]
29.Tempia S, Walaza S, Moyes J, et al. Attributable fraction of influenza virus detection to mild and severe respiratory illnesses in HIV-infected and HIV-uninfected patients, South Africa, 2012-2016. Emerg Infect Dis. 2017;23(7):1124. https://doi.org/10.3201/eid2307.161959 [ Links ]
30.Crotty S. Follicular helper CD4 T cells (TFH). Ann Rev Immunol. 2011;29:621-663. https://doi.org/10.1146/annurev-immunol-031210-101400 [ Links ]
31.Jambo KC, Sepako E, Glennie SJ, et al. Naturally-acquired influenza-specific CD4+ T-cell proliferative responses are impaired in HIV-infected African adults. PLoS One. 2012;7(6):e38628. https://doi.org/10.1371/journal.pone.0038628 [ Links ]
Correspondence:
AbdulAzeez Anjorin
abdul-azeez.anjorin@lasu.edu.ng
Received: 22 May 2019
Accepted: 01 Oct. 2020
Published: 21 Dec. 2020
ORIGINAL RESEARCH
Haematological indices of sickle cell patients with chronic leg ulcers on compression therapy
Oluwatoyin A. BabalolaI; Ayodele OgunkeyedeII; Abayomi B. OdetundeI; Foluke FasolaIII; Anthony A. OniIV, †; Chinedum P. BabalolaI, V; Adeyinka G. FalusiI, V
IInstitute for Advanced Medical Research and Training, College of Medicine, University of Ibadan, Ibadan, Nigeria
IIDepartment of Surgery, University of Ilorin Teaching Hospital, Ilorin, Kwara State, Nigeria
IIIDepartment of Haematology, College of Medicine, University of Ibadan, Ibadan, Nigeria
IVDepartment of Medical Microbiology, College of Medicine, University of Ibadan, Ibadan, Nigeria
VSickle Cell Hope Alive Foundation (SCHAF), Nigeria
ABSTRACT
BACKGROUND: Recurrent chronic leg ulcers and its are morbidities associated with sickle cell anaemia (SCA). Compression therapy increases the rate of healing of these ulcers and also decreases the rate of recurrence.
OBJECTIVE: This study evaluated the haematological parameters of patients with SCA and chronic leg ulcers placed on high compression bandaging to provide data for improved ulcer management and prevention.
METHODS: Eighteen patients with SCA and chronic leg ulcers were recruited for treatment by compression therapy in Ibadan, Nigeria, from March to June 2015. Eighteen SCA patients with no history of chronic leg ulcers were age and sex matched and recruited as controls. Blood samples, wound biopsies and swabs were collected at different time points for full blood count, microbiology, culture and antimicrobial susceptibility tests. Haemoglobin variants were quantified by high performance liquid chromatography. Fasting blood sugar was tested for leg ulcer patients to determine diabetic status.
RESULTS: Ulcers ranged from 0.5 cm2 to 416 cm2 (median: 38.4 cm2). Post-intervention ulcer size ranged from 0.0 cm2 to 272 cm2 (median: 18.6 cm2, p < 0.001); four ulcers completely healed. Compared to the control group, haematological indices at commencement of treatment were more severe in leg ulcer patients (p = 0.02). No patients with chronic leg ulcer was diabetic. Microorganisms isolated from the leg ulcers include Pseudomonas aeruginosa, Staphylococcus aureus, Proteus sp., Escherichia coli and Klebsiella oxytoca
CONCLUSION: Measures to improve haematological parameters during leg ulcer treatment in SCA patients should be taken to aid wound healing.
Keywords: chronic leg ulcer; sickle cell anaemia; wound healing; haematological parameters; compression therapy.
Introduction
Chronic leg ulcer is one of the morbidities associated with sickle cell anaemia (SCA). Chronic leg ulcer is a wound on the skin that occurs between the knee and the foot, showing no signs of healing after 3 months of proper treatment.1 In SCA patients, the polymerisation of haemoglobin S (HbS) leads to the formation of sickled red blood cells (RBCs) which become trapped in the microcirculatory system. This leads to microvascular vaso-occlusion causing tissue ischaemia and associated pain. Occlusion of the veins in the legs leads to venous hypertension, which may cause varicose eczema, deposition of scar tissue and iron pigments in the skin, and oedema in the lower leg. This may result in the breakdown of the skin or delay healing in the case of a leg injury, leading to chronicity.2 Any leg ulcer in the presence of a venous disorder is described as a venous ulcer. Other considerations for venous ulcer diagnosis are an ankle brachial pressure index greater than 0.8 with absence of features of rheumatoid vasculitis, malignancies and diabetic mellitus. The gold standard in the management of chronic venous leg ulcers is the four-layered compression therapy bandaging system.
Sickle cell associated ulcers (SCUs) can be precipitated by many factors such as trauma, infection, severe anaemia and usually occur with venous stasis disease, which requires compression therapy.2 The microorganisms invading the tissues of the skin contribute to the delayed healing observed in chronic leg ulcers.3 Bacteria produce and also stimulate the production of substances (from activated neutrophils) that are detrimental to the body's wound healing processes.4,5 These substances include proteases such as metalloproteases, elastases and collagenases that destroy the building blocks needed for normal wound healing. In this proteolytic environment, bacteria can continue to multiply and use up local resources such as oxygen and nutrients that are also needed for the wound healing.4 Diabetes mellitus increases the risk for the development of infection and impaired wound healing in individuals due to a decreased cell and growth factor response.6 The effect of diabetes mellitus in SCUs is yet to be assessed.
Ulcer incidence in sickle cell disease (SCD) patients in the United States ranges from 2.5% to 25% and 75% in Jamaica.7,8 In Nigeria and Ghana, it is about 10%,9,10 and the rate of recurrence of ulcers is high (> 70%).9,11,12 Chronic leg ulcer thus contributes to recurrent and prolonged misery in these patients. Compression therapy increases the rate of healing of SCUs and also reduces the rate of recurrence.7,8,9 There is inadequate education on the prevention and management of leg ulcers among people living with SCD and their caregivers. The therapeutic strategy for SCUs is complex and multidisciplinary efforts to offer holistic care is poor. This study is therefore designed to address the paucity of information about the laboratory markers of SCUs among people living with SCD and also serves as a basis for health promotion interventions for the prevention of SCUs and improvement in clinical interventions in Nigeria and other African countries.
Methods
Ethical considerations
This study was approved by the University of Ibadan/University College Hospital Joint Ethics Review Committee, College of Medicine, University of Ibadan; protocol identification number UI/EC/15/0133. Sickle cell disease patients in need of leg ulcer treatment at the haematological clinics of the University College Hospital and Ring Road State Hospital, Ibadan, voluntarily participated in this study. Oral informed consent was obtained from each of the participants using a format explaining the details of the procedure, possible complications that may arise using the compression therapy technique for wound care and the importance of the biopsies and periodic blood sample collection. A code number was assigned to each patient and their samples to protect participants' privacy.
Study design
In a pilot hospital-based study, 18 SCA patients with chronic leg ulcers were recruited from haematology clinics at University College Hospital and Ring Road State Hospital, Ibadan, for treatment by compression therapy (first use case in Nigeria) for a period of 3 months (13 weeks) between March 2015 and June 2015. There were 6 men and 12 women with ages ranging from 19 to 44 years. Eighteen age and sex matched SCA patients with no history of chronic leg ulcers were recruited as controls. Sickle cell anaemia patients below 18 years as well as adult SCA patients attending the named facilities who did not give informed consent were excluded from this study. Those with chronic leg ulcers with an ankle brachial pressure index less than 0.8 were also excluded. A pre-tested semi-structured questionnaire was administered to each of the patients for a history of leg ulcer, family history and socio-demographic details.
A four-layer high compression bandaging system described previously.13 was used in this study. Dressing was done once a week for 13 weeks.
Sample collection and processing
Blood samples were collected before commencement of treatment (T0) from both groups. For the leg ulcer group, blood samples, wound swabs and tissue biopsies (in normal saline and in peptone) were also collected on the 5th week (T1) and 10th week (T2) of treatment. Microscopy, culture and sensitivity tests were carried out on the wound biopsies and swabs. Full blood count was carried out using a Swelab Haematology Analyser (Boule Diagnostics, Stockholm, Sweden) and the level of haemoglobin variants was determined by high performance liquid chromatography using the BioRad Variant II Hemoglobin Testing System (Clinical Diagnostics, Hercules, California, United States). The patients were prescribed antibiotics based on the result of antibiotic sensitivity tests. A fasting blood sugar test was performed for the leg ulcer patients to determine their diabetic status.
Statistical analysis
Statistical analyses were done using IBM Statistical Package for Social Sciences version 23 (IBM Corporation, Armonk, New York, United States). The differences in haematological parameters between the control and test groups were determined by the student's t-test. The paired t-test was used to evaluate changes in haematological parameters within chronic leg ulcer patients during the therapy. Spearman's rank correlation was used to determine relationships between different haematological parameters and between haematological indices and size of ulcers at T0. The level of statistical significance was set at p < 0.05.
Results
Description of patients, ulcers and healing rate
Eighteen patients with leg-ulcers and a similar number of ulcer-free controls were included in the study. There were 25 uclers in all as seven patients had bilateral ulcers. The ulcers ranged from 0.5 cm2 to 416 cm2 with a median ulcer size of 38.4 cm2. The ages of the ulcers were 1-22 years (with recurrence). Within the 3 months of compression therapy, four of the patients had complete close-up of the ulcer wound, 16 of them had more than a 50% healing rate (the percentage of the size of wound closure to the initial wound size) and the remaining five had a healing rate of 35% - 50%. The post-intervention median ulcer size ranged from 0.0 cm2 to 272 cm2 with a median of 18.6 cm2 (p < 0.001). The full details of patients, ulcers and healing rates have been described elsewhere.12
Full blood count analysis
Haematocrit (HCT) at commencement of treatment was lower in the leg ulcer patients compared to the control group (19.11% vs 26.17%, p < 0.001). Mean corpuscular volume (95.33 femtolitre vs 87.73 femtolitre, p = 0.02), mean corpuscular haemoglobin (MCH) (30.82 picogram vs 28.46 picogram, p = 0.05), red cell distribution width (27.78% vs 22.68%, p = 0.004), white blood cell count (WBC) (13.90 vs 8.70, p < 0.001) and platelet count (PLT) (487.42 vs 299.08, p < 0.001) were higher in the leg ulcer patients (Table 1). In the sickle cell patients, HCT at T2 was significantly higher than at T0 (p = 0.04). There was an improvement in most of the haematological indices from T0 to T2, but that between T0 and T1 was more profound than T1 to T2 (Table 1). Elevated WBC was more prevalent in leg ulcer patients (66.7%) at T0 compared to the control group (11.1%) p < 0.001.
There was a positive correlation between wound size and WBC (0.538, p = 0.01, Figure 1a) and also between wound size and PLT (0.418, p = 0.04, Figure 1b). There was a poor correlation between wound size and haemoglobin (HGB) (0.024, p = 0.46, Figure 1c). The leg ulcer patient with the highest HGB (8.2 g/dL) in this study test group had the biggest ulcer (416 cm2). On exclusion of this patient, the positive correlation between wound size and WBC became r = 0.473, p = 0.03 (Figure 1d) and that between wound size and PLT became more significant at r = 0.618, p = 0.004 (Figure 1e). However, that between wound size and HGB became r = -0.216, p = 0.20 (Figure 1f).
In the patients with chronic leg ulcers, there was a positive correlation between WBC and PLT and negative correlations between WBC and HGB as well as between HGB and PLT with and without exclusion of the patient with the biggest ulcer at T0. There was no correlation between any of these three parameters in the patients who had not experienced a chronic leg ulcer in their lifetime (i.e. the control group) (Table 2).

High performance liquid chromatography analysis
The concentration of HbS was higher in the leg ulcer group (86.25% vs 82.87%, p = 0.03). The difference in the mean foetal haemoglobin (HbF) level between the leg ulcer group (6.01% ± 3.10%) and control group (7.49% ± 5.89%) was not statistically significant (p = 0.19) but four of the control patients and only one of the leg ulcer patients had a HbF level greater than 10%.
Microbial culture test
Bacteria isolated from the wound swabs and biopsies include Pseudomonas aeruginosa, Staphylococcus aureus, Proteus mirabilis, Escherichia coli and Klebsiella oxytoca, with Pseudomonas aeruginosa being the most prevalent (55% - 70%) across the different culture tests.
Fasting blood sugar test
None of the leg ulcer patients was diabetic. Results of the fasting blood sugar test for all the participants in the test group ranged from 64 mg/dL to 82 mg/dL.
Discussion
This study was carried out to evaluate the haematological parameters in patients with SCA and chronic leg ulcers, and also to assess the haematological changes during healing of these ulcers while being managed with high compression bandaging, an as yet unemployed method of chronic leg ulcer treatment in Nigeria. There were marked differences in some haematological parameters between SCA patients with and without chronic leg ulcers and haematological parameters improved with healing of the ulcers. Monitoring of haematological parameters for improvement during treatment of chronic leg ulcers and after wound closure in SCA patients will aid healing and might also reduce the rate of recurrence.
The mean HGB and HCT of the case patients (those with chronic leg ulcers) at T0 were significantly lower than those of the control patients (those who have never had a chronic leg ulcer). A high rate of haemolysis is one of the major causes of a reduced steady state haemoglobin in sickle cell patients. Sickle cell anaemia patients with a lower steady state haemoglobin concentration are at a higher risk of developing chronic leg ulcer.14,15 According to Ladizinski et al.,16 the inability of a wound to heal could be a result of an inadequate supply of blood or a very low haemoglobin level (< 8 g/dL). One of the causes of SCUs is lack of oxygen which may be attributable to overall anaemia and reduced oxygen-carrying capacity of sickled haemoglobin.8 The addition of recombinant human erythropoietin (a glycoprotein hormone that stimulates red blood cell production) subcutaneously at weekly intervals resulted in a rapid and complete healing of a chronic leg ulcer.17 Hence, treatment of chronic leg ulcers should aim at anaemia correction. However, this should be done with caution and within a threshold that will be beneficial to the patient as a much higher HCT may also lead to hyperviscosity and increase the risk of vaso-occlusion.
A wider red cell distribution width as compared to the control group, with a mean corpuscular volume within normal haematological range, in the test patients alludes to anaemia caused by bleeding from regular treatments, folate deficiency or vitamin B12 deficiency. There was a slight improvement in the HCT level from T0 to T2 mainly due to constant education of the patients on the need to improve the quality of their diet and better compliance with routine haematinics.
Nolan et al.14 and Hassan et al.18 found that patients with leg ulcers had higher WBCs as is the case in this study. The majority of the patients with leg ulcers had elevated WBC counts at the beginning of the study. Elevated WBC, which is due to recurrent inflammation and vasculopathy, is one of the hallmarks of disease severity.19,20,21 Patients with elevated WBC may be more susceptible to developing chronic leg ulcer because leukocytes stick to other blood cells and the endothelium due to an upregulation of adhesion molecules, thereby promoting vaso-occlusion.22 Vaso-occlusion of the veins in the leg may cause tissue ischaemia with a resultant breakdown of the skin or delayed healing of wounds, leading to chronicity.2 Higher WBC may also be due to microbial colonisation or infection of the ulcers. A lower WBC count was observed at T2 and this may be due in part to the use of antibiotics prescribed (based on the result of an antibiotic sensitivity test) a week before T1 sampling. Infections that are not resolved may lead to the non-healing of wounds.16 There is a the need to control infections to promote wound closure and healing. In this study, wound size was positively correlated with WBC. Therefore, efforts to reduce elevated WBC in leg ulcer treatment may aid wound closure.
There was a significantly higher number of platelets in the leg ulcer patients than in the control group of this study. In Jamaica, Cumming et al.23 found that leg ulceration was associated with higher PLT. Hypercoagulability can trigger leg ulcer formation as it may cause ischaemia to the skin, resulting in friability and ulceration.24 SCUs are characterised partly by an increase in clotting ability as a result of increased PLT, hypercoagulability and a measured increase in clotting factors at the wound itself.7 In this study, PLT was also positively correlated with wound size. Wirth et al.25 asserted that an efficient decrease in PLT may lead to healing of skin ulcers.
There was a negative correlation between HGB and WBC as well as between HGB and PLT. This means a higher rate of haemolysis may result in elevated WBC and PLT counts. The observation that these three parameters were not significantly correlated in patients without chronic leg ulcers lends credence to the notion that lower steady state HGB and elevated WBC and PLT counts may predispose sickle cell patients to chronic leg ulcers.
Koshy et al.15 noted that there was a lower incidence of leg ulcers in SCD patients with a HbF concentration higher than 10%. In Jamaica, Cumming et al.23 also found that ulceration was negatively associated with foetal haemoglobin levels. In this study however, the difference in HbF levels between the two study groups was not statistically significant, probably due to the small sample size. The presence of HbF may help to reduce the rate of haemolysis by reducing sickling potential. Having HbF within the cell reduces its ability to polymerise due to the formation, in HbS and HbF mixtures, of asymmetrical hybrid tetramers of the type α2βSγ. The contact sites of Hb βS for polymerisation is abolished, and hence prevents sickling26 and this may also reduce subsequent inflammatory reactions. However, elevated HbF levels may not always be protective as the pancellular distribution, rather than the concentration of HbF in the haemolysate is more effective in inhibiting polymerisation.27
The level of HbS was lower in the control patients. A lower HbS level is usually due to higher HbF levels or the presence of alpha or beta thalassemia which was not assayed in this study. Reduced HbS concentration leads to a lower rate of sickling and, consequently, a reduced rate of haemolysis. Haemolysis of sickled RBCs leads to the release of activated molecules (plasma haemoglobin) which react with nitric oxide to form inert nitrate. Nitric oxide maintains vascular function and normal blood flow28,29 and has also been shown to be vital to cutaneous wound healing.30,31 Nitric oxide suppresses aggregation of platelets, secretion of procoagulant proteins and the expression of cell adhesion molecules on endothelial cells, thereby promoting blood flow.28 Hence, improvement in leg ulcer management may be achieved by the introduction of agents that have the capacity to reduce sickle erythrocyte density as well as those that can make nitric oxide more available in tissues.
None of the chronic leg ulcer patients in this study was diabetic. Diabetes is quite rare in sickle cell patients6,32,33 and does not have anything to do with the non-healing ulcers of patients in this study. Venous incompetence leads to reduced blood flow, and may cause increased blood vessel permeability with the attendant leaking of fluid and proteins into tissue spaces, a condition known as oedema.34 Localised oedema traps leukocytes in the tissues, and oxygen-free radicals and harmful substances released by the leukocytes are capable of causing tissue damage, which may eventually lead to the development of ulceration. Blood clotting factors are also triggered in reduced blood flow.35,36 According to Clare et al.,37 'hypoxia-induced sickling, the rheological effects of white cell counts, and activation of components of the coagulation system may all contribute' to venous incompetence. This explains why reduced HCT, elevated PLT and WBC may increase the risk of leg ulceration in individuals with SCD.
Compression therapy aids healing of leg ulcers by increasing venous blood flow,38 thereby making more readily available the supply of adequate nutrients and other factors necessary for wound healing. On the other hand, the risk of blood clot formation and oedema is reduced, thereby promoting healing. However, there may be a recurrence of ulcers if haematological conditions are not monitored and addressed. This was the case for 3 of the previously healed participants in this study. Management and prevention of chronic leg ulcer in SCD patients should address underlying haematological indices as no one method of dressing may totally prevent recurrence.39,40 The wearing of compression stockings after wound healing may help to maintain normal venous pressure and prevent recurrence due to skin tissue breakdown.41,42
Recommendations
Chronic leg ulcer is multifactorial and hence, in order to make the correct diagnosis and give the most effective treatment, health practitioners should adopt a multidisciplinary approach to a systematic patient evaluation to determine the ulcer pathogenesis.34 Laboratory investigations to monitor haematological indices and to reveal any underlying infection should be incorporated in the treatment and management modalities of chronic leg ulcer in Nigeria. Agents that will reduce the rate of sickle red blood cell destruction and cell adherence to endothelial venules should be explored by health practitioners in the prevention of the formation and recurrence of ulcers and also in its management. Several chemical agents have been suggested and some are under clinical trials.43 Some investigators44,45 have also shown that ascorbic acid favours nitric oxide production in endothelial cells by stabilising nitric oxide synthase cofactor tetrahydrobiopterin. It is therefore suggested that the inclusion of vitamin C at recommended doses be explored in the daily routine drugs for individuals living with SCD for the prevention and management of chronic leg ulcers and other haemolysis-related sickle cell phenotypes.
Limitations
One limitation of this study is the small sample size. The high cost of compression therapy was the major determinant of the sample size. Laboratory markers such as elevated serum lactose dehydrogenase, reticulocyte count, bilirubin level and some genetic factors which were not assayed in this study have also been associated with a risk of chronic leg ulcers in patients with SCD,7,14 Assaying for all these factors in a larger cohort of patients may help to identify other laboratory markers of chronic leg ulcer susceptibility.
Conclusion
Sickle cell patients with a lower level of HGB and elevated WBC and PLT counts at steady state may be at a higher risk of non-healing leg ulcers. Most of the haematological indices improved with healing of the leg ulcers placed on high compression bandaging. An interdisciplinary approach to provide a favourable microenvironment for healing of ulcers, and the monitoring of haematological parameters for the prevention of recurrence, is recommended.
Acknowledgements
Sickle Cell Hope Alive Foundation (SCHAF) - or the recruitment of patients and provision of funds for this study. The members of staff of Haematology Department, Ring Road State Hospital, Ibadan, who cooperated and contributed their time to make this study possible. The patients who cooperated and endured the pain of biopsies and treatment. Medical Education Partnership Initiative in Nigeria (National Institute of Health) - For providing guidance in the data analysis and write-up of this work.
Competing interests
The authors have declared that no competing interests exist.
Authors' contributions
O.A.B. was involved in the design, planning, investigation and data analysis of the study and the manuscript write-up. A.O. was involved in the design, planning and investigation. A.B.O. and C.P.B. assisted with the planning and implementation of the study. F.F. revised the manuscript. A.A.O. assisted with the microbiology investigation. A.G.F. was involved in the study design and planning, and assisted with secondary level facility access, project coordination and manuscript revision.
Sources of support
Funding was provided by the Sickle Cell Hope Alive Foundation (SCHAF).
Data availability statement
Data sharing is not applicable to this article as no new data were created or analysed in this study.
Disclaimer
The views and opinions expressed in this article are those of the authors and do not necessarily reflect the official policy or position of any affiliated agency of the authors.
References
1.Kahle B, Hermanns HJ, Gallenkemper G. Evidence-based treatment of chronic leg ulcers. Deutsches Ärzteblatt Int. 2011;108(14):231-237. https://doi.org/10.3238/arztebl.2011.0231 [ Links ]
2.Nelson EA, Bell-Syer SEM, Cullum NA, Webster J. Compression for preventing recurrence of venous ulcers. Cochrane Database Syst Rev. 2000;(4):CD002303. https://doi.org/10.1002/14651858.CD002303 [ Links ]
3.Davies CE, Wilson MJ, Hill KE, et al. Use of molecular techniques to study microbial diversity in the skin: Chronic wounds re-evaluated. Wound Repair Regen. 2001;9(5):332-340. https://doi.org/10.1046/j.1524-475x.2001.00332.x [ Links ]
4.Attinger CE, Janis JE, Steinberg J, Schwartz J, Al-Attar A, Couch K. Clinical approach to wounds: Debridement and wound bed preparation including the use of dressings and wound-healing adjuvants. Plast Reconstr Surg. 2006;117(7):72S-109S. https://doi.org/10.1097/01.prs.0000225470.42514.8f [ Links ]
5.McCarty SM, Percival SL. Proteases and delayed wound healing. Adv Wound Care (New Rochelle). 2013;2(8):438-447. https://doi.org/10.1089/wound.2012.0370 [ Links ]
6.Reid HL, Photiades DP, Oli JM, Kaine W. Concurrent sickle cell disease and diabetes mellitus. Trop Geogr Med. 1988;40(3):201-204. [ Links ]
7.Minniti CP, Eckman J, Sebastiani P, Steinberg MH, Ballas SK. Leg ulcers in sickle cell disease. Am J Hematol. 2010;85(10):831-833. https://doi.org/10.1002/ajh.21838 [ Links ]
8.Penne JR, Goodman BM, Chen IA. Sickle cell disease & wound care: Lower extremity ulcers in 'crisis'. Today's Wound Clinic 2015;9(3):25-27. [ Links ]
9.Ankra-Badu GA. Sickle cell leg ulcers in Ghana. East Afr Med J. 1992;69(7):366-369. [ Links ]
10.Bazuaye GN, Nwannadi AI, Olayemi EE. Leg ulcers in adult sickle cell disease patients in Benin city Nigeria. Gomal J Med Sci. 2010;8(2):190-194. [ Links ]
11.Akinyanju O, Akinsete I. Leg ulceration in sickle cell disease in Nigeria. Trop Geogr Med. 1979;31(1):87-91. [ Links ]
12.Olayemi EE, Bazuaye GN. Lupus anticoagulant and leg ulcers in sickle cell anaemia. Indian J Dermatol. 2009;54(3):251-254. https://doi.org/10.4103/0019-5154.55635 [ Links ]
13.Ogunkeyede AO, Babalola OA, Ilesanmi OS, et al. Chronic leg ulcers in patients with sickle cell anemia: Compression therapy experience in Nigeria. Nigerian J Plast Surg. 2017;13(2):50-55. https://doi.org/10.4103/njps.njps_16_17 [ Links ]
14.Nolan VG, Adewoye A, Baldwin C, et al. Sickle cell leg ulcers: Associations with haemolysis and SNPs in Klotho, TEK and genes of the TGF-β/BMP pathway. Br J Haematol. 2006;133(5):570-578. https://doi.org/10.1111/j.1365-2141.2006.06074.x [ Links ]
15.Koshy M, Entsuah R, Koranda A, et al. Leg ulcers in patients with sickle cell disease. Blood. 1989;74(4):1403-1408. https://doi.org/10.1182/blood.V74.4.1403.1403 [ Links ]
16.Ladizinski B, Bazakas A, Mistry N, Alavi A, Sibbald GR, Salcido R. Sickle cell disease and leg ulcers. Adv Skin Wound Care. 2012;25(9):422. https://doi.org/10.1097/01.ASW.0000419408.37323.0c [ Links ]
17.Abdul-Kareem A, Al-Momen M. Recombinant human erythropoietin induced rapid healing of a chronic leg ulcer in a patient with sickle cell disease. Acta Haematol. 1991;86(1):46-48. https://doi.org/10.1159/000204799 [ Links ]
18.Hassan A, Gayus DL, Abdulrasheed I, Umar MA, Ismail DL, Babadoko AA. Chronic leg ulcers in sickle cell disease patients in Zaria, Nigeria. Arch Int Surg. 2014;4(3):141-145. https://doi.org/10.4103/2278-9596.146405 [ Links ]
19.Curtis SA, Danda N, Etzion Z, Cohen HW, Billett HH. Elevated steady state WBC and platelet counts are associated with frequent emergency room use in adults with sickle cell anemia. PLoS One. 2015;10(8):e0133116. https://doi.org/10.1371/journal.pone.0133116 [ Links ]
20.Damanhouri GA, Jarullah J, Marouf S, Hindawi SI, Mushtaq G, Kamal MA. Clinical biomarkers in sickle cell disease. Saudi J Bio Sci. 2015;22(1):24-31. https://doi.org/10.1016/j.sjbs.2014.09.005 [ Links ]
21.Okpala I. The intriguing contribution of white blood cells to sickle cell disease - A red cell disorder. Blood Rev. 2004;18(1):65-73. https://doi.org/10.1016/S0268-960X(03)00037-7 [ Links ]
22.Okpala I. Leukocyte adhesion and the pathophysiology of sickle cell disease. Curr Opin Hematol. 2006;13(1):40-44. https://doi.org/10.1097/01.moh.0000190108.62414.06 [ Links ]
23.Cumming V, King L, Fraser R, Serjeant G, Reid M. Venous incompetence, poverty and lactate dehydrogenase in Jamaica are important predictors of leg ulceration in sickle cell anaemia. Br J Haematol. 2008;142(1):119-125. https://doi.org/10.1111/j.1365-2141.2008.07115.x [ Links ]
24.Levin C, Koren A. Healing of refractory leg ulcer in a patient with thalassemia intermedia and hypercoagulability after 14 years of unresponsive therapy. Isr Med Assoc J. 2011;13(5):316-318. [ Links ]
25.Wirth K, Schoepf E, Mertelsmann R, Lindemann A. Leg ulceration with associated thrombocytosis: Healing of ulceration associated with treatment of the raised platelet count. Br J Dermatol. 1998;138(3):533-535. https://doi.org/10.1046/j.1365-2133.1998.02141.x [ Links ]
26.Nagel RL, Bookchin RM, Johnson J, et al. Structural bases of the inhibitory effects of hemoglobin F and hemoglobin A on the polymerization of Hemoglobin S. Proc Natl Acad Sci. 1979;76(2):670-672. https://doi.org/10.1073/pnas.76.2.670 [ Links ]
27.Conran. High foetal haemoglobin in sickle cell disease: Not so protective? EBiomedicine. 2015;2(2):102-103. https://doi.org/10.1016/j.ebiom.2015.01.005 [ Links ]
28.Mack AK, Kato GJ. Sickle cell disease and nitric oxide: A paradigm shift? Int J Biochem Cell Biol. 2006;38(8):1237-1243. https://doi.org/10.1016/j.biocel.2006.01.010 [ Links ]
29.Akinsheye I, Klings ES. Sickle cell anemia and vascular dysfunction: The nitric oxide connection. J Cell Physiol. 2010;224(3):620-625. https://doi.org/10.1002/jcp.22195 [ Links ]
30.Luo JD, Wang YY, Fu WL, Wu J, Chen AF. Gene therapy of endothelial nitric oxide synthase and manganese superoxide dismutase restores delayed wound healing in type 1 diabetic mice. Circulation. 2004;110(16):2484-2493. https://doi.org/10.1161/01.CIR.0000137969.87365.05 [ Links ]
31.Weller. Nitric oxide: A key mediator in cutaneous physiology. Clin Exp Dermatol. 2003;28(5):511-514. https://doi.org/10.1046/j.1365-2230.2003.01365.x [ Links ]
32.Morrison JC, Schneider JM, Kraaus AP, Kitabchi AE. The prevalence of diabetes mellitus in sickle haemoglobinopathies. J Clin Endocrinol Metab. 1979;48(2):192-195. https://doi.org/10.1210/jcem-48-2-192 [ Links ]
33.Jarrett OO, Olorundare EI. Type 1 diabetes mellitus in a known sickle cell anaemia patient: A rare combination in Nigeria. Afr J Med Sci. 2014;43(2):177-181. [ Links ]
34.Partsch H. Understanding the pathophysiological effects of compression. In: S Calne (ed). EWMA position document; Understanding compression therapy. London: MEP Ltd; 2003. p. 2. [ Links ]
35.Agale SV. Chronic leg ulcers: Epidemiology, aetiopathogenesis, and management. Ulcers. 2013;2013:413604. https://doi.org/10.1155/2013/413604 [ Links ]
36.Shami SK, Shields DA, Scurr JH, Coleridge Smith PD. Leg ulceration in venous disease. Postgrad Med J. 1992;68(804):779-785. https://doi.org/10.1136/pgmj.68.804.779 [ Links ]
37.Clare A, FitzHenley M, Harris J, Serjeant GR. Chronic leg ulceration in homozygous sickle cell disease: The role of venous incompetence. Br J Haematol. 2002;119(2):567-571. https://doi.org/10.1046/j.1365-2141.2002.03833.x [ Links ]
38.Cullum NA, Nelson EA, Fletcher A, Sheldon T. Compression for venous leg ulcers. Cochraine Database Syst Rev. 2001;(2):CD000265. https://doi.org/10.1002/14651858.CD000265 [ Links ]
39.El Khatib AM, Hayek SN. Leg ulcers in sickle cell patients: Management challenges. Chronic Wound Care Manage Res. 2016;(3):157-161. https://doi.org/10.2147/CWCMR.S85455 [ Links ]
40.O'Donnell TF, Passman MA, Marston WA, et al. Management of venous leg ulcers: Clinical practice guidelines of the Society for Vascular Surgery and the American Venous Forum. J Vasc Surg. 2014;60(2):3S-59S. https://doi.org/10.1016/j.jvs.2014.04.049 [ Links ]
41.Nelson EA, Bell-Syer SEM. Compression for preventing recurrence of venous ulcers. Cochrane Database Syst Rev. 2014;(9):CD002303. https://doi.org/10.1002/14651858.CD002303.pub3 [ Links ]
42.Anderson I. Compression hosiery to reduce leg ulcer recurrence. Nurs Times. 2013;109(6):18-20. [ Links ]
43.Kapoor S, Little JA, Pecker LH. Advances in the treatment of sickle cell disease. Mayo Clin Proc. 2018;93(12):1810-1824. https://doi.org/10.1016/j.mayocp.2018.08.001 [ Links ]
44.Mortensen A, Lykkesfeldt J. Does vitamin C enhance nitric oxide bioavailability in a tetrahydrobiopterin-dependent manner? In vitro, in vivo and clinical studies. Nitric Oxide. 2014;36:51-57. https://doi.org/10.1016/j.niox.2013.12.001 [ Links ]
45.Parker WM, Qu Z, May JM. Intracellular ascorbate prevents endothelial barrier permeabilization by thrombin. J Biol Chem. 2015;290(35):21486-21497. https://doi.org/10.1074/jbc.M115.662098 [ Links ]
Correspondence:
Oluwatoyin Babalola
praisebab2@gmail.com
Received: 23 Apr. 2019
Accepted: 23 Sept. 2020
Published: 21 Dec. 2020
† Note: 1955-2015.
^rND^sKahle^nB^rND^sHermanns^nHJ^rND^sGallenkemper^nG^rND^sNelson^nEA^rND^sBell-Syer^nSEM^rND^sCullum^nNA^rND^sWebster^nJ^rND^sDavies^nCE^rND^sWilson^nMJ^rND^sHill^nKE^rND^sAttinger^nCE^rND^sJanis^nJE^rND^sSteinberg^nJ^rND^sSchwartz^nJ^rND^sAl-Attar^nA^rND^sCouch^nK^rND^sMcCarty^nSM^rND^sPercival^nSL^rND^sReid^nHL^rND^sPhotiades^nDP^rND^sOli^nJM^rND^sKaine^nW^rND^sMinniti^nCP^rND^sEckman^nJ^rND^sSebastiani^nP^rND^sSteinberg^nMH^rND^sBallas^nSK^rND^sPenne^nJR^rND^sGoodman^nBM^rND^sChen^nIA^rND^sAnkra-Badu^nGA^rND^sBazuaye^nGN^rND^sNwannadi^nAI^rND^sOlayemi^nEE^rND^sAkinyanju^nO^rND^sAkinsete^nI^rND^sOlayemi^nEE^rND^sBazuaye^nGN^rND^sOgunkeyede^nAO^rND^sBabalola^nOA^rND^sIlesanmi^nOS^rND^sNolan^nVG^rND^sAdewoye^nA^rND^sBaldwin^nC^rND^sKoshy^nM^rND^sEntsuah^nR^rND^sKoranda^nA^rND^sLadizinski^nB^rND^sBazakas^nA^rND^sMistry^nN^rND^sAlavi^nA^rND^sSibbald^nGR^rND^sSalcido^nR^rND^sAbdul-Kareem^nA^rND^sAl-Momen^nM^rND^sHassan^nA^rND^sGayus^nDL^rND^sAbdulrasheed^nI^rND^sUmar^nMA^rND^sIsmail^nDL^rND^sBabadoko^nAA^rND^sCurtis^nSA^rND^sDanda^nN^rND^sEtzion^nZ^rND^sCohen^nHW^rND^sBillett^nHH^rND^sDamanhouri^nGA^rND^sJarullah^nJ^rND^sMarouf^nS^rND^sHindawi^nSI^rND^sMushtaq^nG^rND^sKamal^nMA^rND^sOkpala^nI^rND^sOkpala^nI^rND^sCumming^nV^rND^sKing^nL^rND^sFraser^nR^rND^sSerjeant^nG^rND^sReid^nM^rND^sLevin^nC^rND^sKoren^nA^rND^sWirth^nK^rND^sSchoepf^nE^rND^sMertelsmann^nR^rND^sLindemann^nA^rND^sNagel^nRL^rND^sBookchin^nRM^rND^sJohnson^nJ^rND^sMack^nAK^rND^sKato^nGJ^rND^sAkinsheye^nI^rND^sKlings^nES^rND^sLuo^nJD^rND^sWang^nYY^rND^sFu^nWL^rND^sWu^nJ^rND^sChen^nAF^rND^sMorrison^nJC^rND^sSchneider^nJM^rND^sKraaus^nAP^rND^sKitabchi^nAE^rND^sJarrett^nOO^rND^sOlorundare^nEI^rND^sPartsch^nH^rND^sAgale^nSV^rND^sShami^nSK^rND^sShields^nDA^rND^sScurr^nJH^rND^sColeridge Smith^nPD^rND^sClare^nA^rND^sFitzHenley^nM^rND^sHarris^nJ^rND^sSerjeant^nGR^rND^sCullum^nNA^rND^sNelson^nEA^rND^sFletcher^nA^rND^sSheldon^nT^rND^sEl Khatib^nAM^rND^sHayek^nSN^rND^sO'Donnell^nTF^rND^sPassman^nMA^rND^sMarston^nWA^rND^sNelson^nEA^rND^sBell-Syer^nSEM^rND^sAnderson^nI^rND^sKapoor^nS^rND^sLittle^nJA^rND^sPecker^nLH^rND^sMortensen^nA^rND^sLykkesfeldt^nJ^rND^sParker^nWM^rND^sQu^nZ^rND^sMay^nJM^rND^1A01 A02^nNaseem^sCassim^rND^nLindi M.^sCoetzee^rND^1A01 A02^nDeborah K.^sGlencross^rND^1A01 A02^nNaseem^sCassim^rND^nLindi M.^sCoetzee^rND^1A01 A02^nDeborah K.^sGlencross^rND^1A01 A02^nNaseem^sCassim^rND^nLindi M^sCoetzee^rND^1A01 A02^nDeborah K^sGlencrossORIGINAL RESEARCH
Categorising specimen referral delays for CD4 testing: How inter-laboratory distances and travel times impact turn-around time across a national laboratory service in South Africa
Naseem CassimI; Lindi M. CoetzeeI, II; Deborah K. GlencrossI, II
INational Health Laboratory Service, Johannesburg, South Africa
IIDepartment of Molecular Medicine and Haematology, Faculty of Health Sciences, University of the Witwatersrand, Johannesburg, South Africa
ABSTRACT
BACKGROUND: The South African National Health Laboratory Service provides laboratory services for public sector health facilities, utilising a tiered laboratory model to refer samples for CD4 testing from 255 source laboratories into 43 testing laboratories.
OBJECTIVE: The aim of this study was to determine the impact of distance on inter-laboratory referral time for public sector testing in South Africa in 2018.
METHODS: A retrospective cross-sectional study design analysed CD4 testing inter-laboratory turn-around time (TAT) data for 2018, that is laboratory-to-laboratory TAT from registration at the source to referral receipt at the testing laboratory. Google Maps was used to calculate inter-laboratory distances and travel times. Distances were categorised into four buckets, with the median and 75th percentile reported. Wilcoxon scores were used to assess significant differences in laboratory-to-laboratory TAT across the four distance categories
RESULTS: CD4 referrals from off-site source laboratories comprised 49% (n = 1 390 510) of national reporting. A positively skewed distribution of laboratory-to-laboratory TAT was noted, with a median travel time of 11 h (interquartile range: 7-17), within the stipulated 12 h target. Inter-laboratory distance categories of less than 100 km, 101-200 km, 201-300 km and more than 300 km (p < 0.0001) had 75th percentiles of 8 h, 17 h, 14 h and 27 h.
CONCLUSION: Variability in inter-laboratory TAT was noted for all inter-laboratory distances, especially those exceeding 300 km. The correlation between distance and laboratory-to-laboratory TAT suggests that interventions are required for distant laboratories.
Keywords: HIV; cluster of differentiation 4; CD4; immune status; inter-laboratory referral; distance; travel time.
Introduction
Laboratory services in South Africa are provided within the public sector by the National Health Laboratory Service (NHLS).1 This mandate is delivered through a national network of 255 laboratories ranging from large high-throughput laboratories located in metropolitan areas to smaller laboratories placed in rural district hospitals.1 Testing is typically offered using a tiered laboratory service approach.2 In the lower tiers, a basket of eight standard pathology tests are performed locally to provide emergency services and include full blood count, urea and electrolytes, cardiac enzymes, glucose, liver enzymes, among others. Specialised assays and tests supporting local HIV/AIDS and tuberculosis testing regarded as high-volume workloads are transferred through the laboratory referral network to appropriate specialist and dedicated testing laboratories, depending on the nature of the test. Tertiary centres and academic laboratories have high workloads that are facilitated by using more sophisticated, high-throughput analysers.2 CD4 testing, for example, is centralised into 43 laboratories located strategically across the country to ensure widespread full-service coverage.2,3 In South Africa, samples are collected daily from health facilities through a network of couriers and transported to the local source laboratory. These laboratories perform a basic repertoire of tests. More specialised tests are referred to the nearest testing laboratory with an expanded test repertoire.
A CD4 count is used to assess the patient's immune status (level of immune suppression) at presentation and during therapy.2 Additionally, it assesses the risk of opportunistic disease, including co-infections such as cryptococcal meningitis in patients with CD4 counts lower than 100 cells/µL.4,5 Global estimates of advanced HIV disease have remained largely unchanged over the last 5 years despite increased antiretroviral therapy (ART) coverage in low-and middle-income countries.6 Between 30% and 50% of HIV-positive individuals in low- and middle-income countries are estimated to have CD4 counts under 200 cells/µL.6 In South Africa, Coetzee et al. reported that the percentage of samples with a CD4 count under 100 cells/µL ranged between 7.8% and 11.5% for the 2014/2015 financial period across South Africa's nine provinces,7 while the burden of advanced disease (CD4 count ≤ 200 cells/µL), reported by Carmona et al., approaches nearly 40% among those entering care for the first time in 2016.8 Approximately 3.5 million CD4 tests are typically processed per annum throughout the NHLS. The burden of advanced disease thus weighs heavily on this laboratory service. Patients with advanced HIV disease are expedited into care and ART initiation, usually within 7 days of diagnosis.6 To meet the requirements of 'fast-tracking' patients into care and onto ART, CD4 results need to be delivered timeously to referring health facilities. This, in turn, requires that samples be delivered in good time to the testing laboratories, within a 12-h window (as per internal guideline), to allow laboratory testing to commence and be completed within the organisational stipulated testing inter-laboratory turn-around time (TAT) of 40 h. Within the NHLS, there are 255 source laboratories that refer CD4 samples to the 43 testing laboratories (5.9:1). The organisational TAT cut-off for the inter-laboratory referral of CD4 samples (or 'lab-to-lab' time) is set at 12 h.
Previous work revealed that the placement of CD4 testing equipment and testing capacity, within an area identified with longer TAT attributable to pre-analytical causes, led to a marked shortening of the associated pre-analytical TAT and noticeably shorter overall TAT.9 Glencross et al. reported using a service radius around existing CD4 testing laboratories to determine healthcare facilities and clinics that lay outside of existing service precincts.2 This study facilitated the identification of additional testing sites required to improve local TAT.2
To achieve prompt sample referral within the CD4 network to address pre-analytic TAT, the NHLS employs a 'hub and spoke' approach whereby each testing CD4 laboratory receives referred samples from multiple source laboratories where the samples are first accepted into the laboratory network (but where there are no facilities to perform the testing).10 At the referring (source) laboratory, the CD4 sample is registered (as a referral) onto the laboratory information system (LIS). Thereafter, samples are transported to the centralised testing site; the inter-laboratory timeframe is completed when the samples are received and receipted on the LIS at the testing site. The LIS automatically generates the relevant dates and times of sample dispatch and receipt that are used to determine the inter-laboratory TAT in hours.10 For the purpose of this study, this inter-laboratory time period (component), from registration at the source laboratory to referral receipt at the testing laboratory, is termed the 'lab-to-lab' TAT.
It is anticipated that the distance and travel time for inter-laboratory referral could potentially impact lab-to-lab TAT performance. Laboratories located more than 300 km from a testing laboratory are expected to have longer lab-to-lab TAT. Conversely, laboratories within a 100 km radius are expected to have shorter travel times and lab-to-lab TAT. With a decentralised laboratory service model, it would be assumed that an inter-laboratory referral distance would not exceed 250 km. The 250 km radius is based on the study by Cassim et al. that used the integrated tiered service delivery model (ITSDM) coverage precinct approach to address ART-related testing service coverage gaps.2,10 The Cassim et al. study assumed that a 250 km buffer around each laboratory would adequately address ART-related test coverage.10 The relationship between travel time, distance and lab-to-lab TAT performance would identify gaps in the current service model, where additional decentralisation would deliver better inter-laboratory TAT performance.
The objective of this study was to determine the impact of distance on inter-laboratory referral time in 2018 for public sector testing in South Africa.
Methodology
Ethical considerations
Ethical clearance was obtained from the University of the Witwatersrand (M1706108). This study was a retrospective analysis of NHLS laboratory data, did not use any patient identifiers and did not involve any direct patient contact.
Study design and data analysis
This study used a cross-sectional study design. Microsoft Access and Excel (Microsoft Corp., Redmond, California, United States) were used to prepare data11 and analysis was performed using SAS 9.4 (SAS, Cary, North Carolina, United States).12 Laboratory data for all CD4 samples referred for centralised testing were extracted from the corporate data warehouse for the 2018 calendar year across South Africa. The corporate data warehouse is an entity of the NHLS and houses all LIS data generated by its laboratories. A referral CD4 outcome was assigned where both the source (referring) laboratory and testing laboratories fields were populated in the LIS data. Google Maps (Alphabet, Inc., Mountain View, California, United States) was used to calculate both inter-laboratory distances and travel times using confirmed coordinates of laboratories (latitude and longitude).13 Data were summarised in a worksheet for later analysis. The LIS date and time stamps were used to calculate the lab-to-lab (inter-laboratory referral) time in hours (time from registration at the source laboratory to the time of referral receipt at the testing laboratory). Due to the limited data points, the following delays could not be determined and are accounted for in the lab-to-lab TAT: (1) between registration at the source laboratory to pick up by the courier, (2) transport to the testing laboratory and (3) delivery at the testing laboratory for referral receipt.
Skewness can be quantified as a representation of the extent to which a given distribution varies from a normal distribution.14 A normal distribution reports a skewness of zero compared to a positively skewed distribution with a value of greater than zero.14 For a normal distribution, descriptive statistics such as the mean and standard deviation can be reported. However, for a skewed distribution, the median and interquartile range are reported. Hence, skewness dictates what descriptive statistics may be reported.
For each CD4 sample, the requesting health facility is captured to facilitate the delivery of patient reports. In the LIS, each health facility has a designated location code. This code is captured in the LIS based on health facility details provided on the laboratory request form. Unfortunately, very few health facilities had latitude and longitude data making it difficult to calculate the distance to the local source laboratory.
CD4 samples that were not referred (i.e. that were received directly at testing laboratories) were excluded for the purpose of this study. Data were reported as descriptive statistics, and visualised using histograms. A scatter plot was used to demonstrate the relationship between referral times (hours) and distances (km), with descriptive statistics reported. The inter-laboratory distances between source and testing sites were categorised into four buckets; (1) ≤ 100 km, (2) 101-200 km (3) 201-300 km and (4) > 300 km. The aim of the analysis was to determine whether lab-to-lab TAT was influenced by distance. The analysis could also reveal whether decentralisation within a 200 km radius would decrease lab-to-lab TAT. The number of health facilities associated with local source laboratories in each of the four inter-laboratory distance buckets was reported. The lab-to-lab TAT component and descriptive statistics (median and 75th percentile) were reported, using the non-parametric Wilcoxon scores (rank sum) test to determine differences in TAT reported among the distance categories. In addition, inter-laboratory referral routes longer than 300 km that referred 1000 or more samples in 2018 are reported as a separate table reporting: (1) source laboratory, (2) testing laboratory, (3) distance, (4) travel time (hours), (5) percentage within 12-h cut-off and (6) 75th percentile, using source and testing laboratory aliases. The projected daily referral volumes were calculated based on the assumption of 21.73 working days per month.
Results
There were 2 844 242 CD4 samples performed in 2018, of which 1 390 510 (49%) were referred for centralised testing within the NHLS laboratory network.
Distribution of inter-laboratory referral times and distances
A linear relationship exists between referral times and distances. lab-to-lab data reported a positively skewed distribution (skewness = 2.83). A lab-to-lab median of 11 h with an interquartile range of 7-17 h was reported. The mode was 8 h, with a range of 96 h (Figure 1).
The inter-laboratory CD4 testing referral distance data also reported a positively skewed distribution (skewness = 1.66) (Figure 2). The median distance travelled by referred samples was 67.1 km (interquartile range = 20.1-123.0 km; mode = 14.4 km; range = 559 km). The distribution of inter-laboratory referral travel times was also positively skewed (skewness = 1.33). The median was 0.9 h, with an interquartile range of 0.4-1.63 h, a mode of 0.35 h, and a range of 6.15 h.

Inter-laboratory CD4 testing referral performance by distance category
Overall, 67% of samples were referred to testing laboratories within a 100 km inter-laboratory referral distance, increasing to approximately 93% of samples within a 200 km radial precinct. Approximately 7% of samples were transported 201 km or more from their source laboratory to their sister centralised testing laboratory. Overall, for referral distances under 300 km, all inter-laboratory precincts (both the mode and median lab-to-lab TAT) met the organisational inter-laboratory TAT cut-off of 12 h.
Longer lab-to-lab TATs were noted from referral or source laboratories further than 300 km from testing laboratories. Analysis of the 75th percentile lab-to-lab TAT, unlike the mode and median parameters, revealed that only inter-laboratory referral distances of under 100 km met the 12-h cut-off (Table 1). The Wilcoxon scores (rank sum) test indicated a significant difference in lab-to-lab TAT across the four distance categories.

Laboratories serviced the majority of health facilities (80%) with an inter-laboratory referral distance within 200 km. There were 12% and 7.5% of health facilities that were serviced by laboratories with an inter-laboratory referral distance of 201 km - 300 km and more than 300 km.
Distant inter-laboratory routes performance analysis
For five source laboratories, distance to the nearest testing facility exceeded 300 km (Table 2). Distances ranged from 304 km to 560 km (mean distance of 387 km). The percentage of samples transferred to the centralised testing site within the cut-off TAT of 12 h was 36%, 37% 6%, 83% and 8% for source laboratories S1, S2, S3, S4 and S5. The median lab-to-lab TAT across each of the five sites exceeded the stipulated TAT cut-off for all five sites. The 75th percentile lab-to-lab TAT revealed further variation of pre-analytical inter-laboratory TAT efficiency, that is, 10 h - 29 h for individual laboratories. Daily CD4 referral volumes from these laboratories ranged from 6 to 24 samples.

Discussion
In this study, the impact of distance and travel time on lab-to-lab TAT as a pre-analytical component of total TAT was assessed to categorise laboratory service efficiency and, in national service, understand where bottlenecks of logistics may occur. We observed moderate correlation between distance travelled and the overall recorded inter-laboratory lab-to-lab TAT. However, across all service precincts, especially those exceeding a radius of 300 km, variable inter-laboratory TAT was recorded. Generally, median lab-to-lab TAT of referrals within a 200 km radius of a testing facility (n = 210 laboratories; 93% of total referrals) was 11 h and fell within the organisational stipulated inter-laboratory TAT cut-off of 12 h. This finding confirms that previous implementation of decentralised CD4 testing facilities into lower service tiers has positively impacted the efficiency of local service delivery.2,9 Earlier work identified that well-planned decentralisation in remote areas has been successfully implemented in the Northern Cape (De Aar, Upington and Tshwaragano laboratories).2
Despite previous decentralisation drives and a national median inter-laboratory TAT of 11 h for at least 93% of referred samples, there are still outliers noted. For example, where distances travelled to a centralised testing facility was between 100 km and 200 km, a 75th percentile inter-laboratory TAT of 17 h was noted. Therefore, although most of the referring times reported here were within the inter-laboratory transfer cut-off of 12 h, service gaps are evident (where referral laboratories failed to deliver their samples to the testing laboratory within the stipulated time frame).
Glencross et al. developed the ITSDM that consists of five tiers to facilitate sustainable 'full-service coverage' across South Africa.2 This model could be used to extend CD4 services into rural and remote areas with tier 3 (community) or tier 2 (point-of-care and hub) services that complement more centralised testing offered by tiers 1 and 2.2 The tier 3 sites would be installed in existing laboratories with existing infrastructure.2 Candidate laboratories are identified using the ITSDM,2 to service health facilities outside the current service precinct.2,9 The implementation of new tier 3 community laboratories in this context has a proven role in reducing pre-analytical TAT, particularly where samples are required to travel distances in excess of 300 km.9 Coetzee et al. have previously reported the successful impact of the placement of an ITSDM-identified community CD4 laboratory in an area experiencing long overall TAT; a dramatically reduced TAT was realised in this rural district.9 This was achieved by adding CD4 testing capacity to the existing test repertoire in the local laboratory (De Aar) which substantially reduced the pre-analytical component of total TAT of testing in the area. In the current study, based on the number of samples referred and the proportion of samples within cut-off TAT, sites 1 and 2 should be eligible for local capacity placement. In some cases (i.e. sites 3, 4 and 5), review of local logistics could improve the pre-analytical component, especially as it was revealed that one of the five sites, which was 304 km from its sister testing site, achieved a remarkable 75th percentile lab-to-lab TAT of around 10 h. This suggests that distance alone is not the primary determining factor influencing lab-to-lab TAT.
This study demonstrated a median lab-to-lab TAT of 15 h, with a right skewed distribution and a 75th percentile of 27 h for referrals outside a 300 km service precinct to the nearest testing laboratory. This finding, again, reiterates the need to apply the ITSDM approach described above to assist with identifying sites for capacity development and alleviation of the longer inter-laboratory TATs identified in this work. At least four sites with low test volumes and exceeding 300 km to the nearest testing facility warrant the introduction of a local service that could be accomplished with lower throughput platforms (daily capacity of 40 samples).15,16,17 Testing systems such as the Beckman Coulter Aquios cytometer or Becton Dickinson FACSPresto are easy to use and suitable for existing smaller laboratories requiring minimal refurbishment. Costing assessments done by Cassim et al. have demonstrated that the incremental cost for decentralising CD4 testing to community laboratories is a mere $2.05.18 This low incremental cost is due to the placement agreement model where the cost of the analysers for new sites is included in the reagent costs. Whether this is a high or low volume site requiring different platforms, the cost to offer one test remains the same. Furthermore, the proposed assays have been validated locally and have World Health Organization pre-qualification,19 reporting acceptable precision to predicate methods for both venous or capillary blood sampling.15 The challenges for the decentralisation model include the availability of adequately trained staff, the need to increase resupply points of reagents and consumables at lower-level facilities, and the ease of access to suppliers for maintenance and repairs. Irrespective of costs, the impact on patient care is invaluable.20
With only about 50% of tested CD4 samples referred between laboratories, the NHLS strives to have adequate testing facilities for maximum coverage especially in high-burden and remote areas,2 and, as mentioned above, has set a maximum target time of 12 h for samples to be transported from source laboratories to the centralised testing facilities. It would make sense for inter-laboratory TAT (referral time) to be directly proportional to distance. This assumption is based on the provision of adequate and reliable delivery vehicles and appropriately maintained roads. The road conditions and how the collection and transportation routes are designed would also affect TAT performance. The operating times of referral sites may also impact delays in TAT as not all offer a 24-h service. Human resource factors can also lead to delays and longer TAT, including the work hours, work ethos and diligence of both drivers and receiving office staff at the centralised facility.21
A limitation of this analysis is that it focuses on the inter-laboratory referral after samples are received within the laboratory network. The laboratory pre-analytical phase of TAT is measured from the first registration in an NHLS laboratory to receipt in the testing facility; it does not include the time from venepuncture to first registration on the LIS system. However, as the latter time periods are poorly recorded, it is difficult to determine if a longer lab-to-lab TAT is due to a delay in time from sample collection to registration at the source laboratory. Challenges in the pre-analytical and analytical arms would have to be addressed separately due to differences in the nature of challenges and the involvement of different personnel. Therefore, separate corrective action interventions need to be set in motion. This may include redesigning the specimen referral network which could include additional routes or potentially identifying some sites for point-to-point routing instead of a multi-stop route, or vice versa.2
To adequately address all delays of inter-laboratory referral TAT, all aspects of this phase should be addressed. Not all of the processes undertaken during the transfer of samples are documented and traceable, that is, not all steps generate a time and date stamp on the LIS or are date-stamped at the point of venesection. The introduction of electronic monitoring of all total TAT would facilitate a more complete view of possible points of delay across the entire sample journey and identify aspects for corrective action. Vertical audits can be used to identify sources of delay on different days of the week to calculate average (delay) times for each process.22 In addition, workflow analyses could assist in mapping out (and eliminating) processes or steps that do not add value.22 Through this process, a standard operating procedure for all pre-analytical processes could be introduced across facilities.
Limitations
The study used predominantly laboratory data to assess the performance of CD4 test referrals across the NHLS. This study did not report data for other tests as the inter-laboratory referral network is integrated. All the concepts reported in this study for CD4 testing apply to other referred tests as well. No information was available to review time from sample collection to registration onto the laboratory network, as well as time after sample registration at the source laboratory to collection by the courier.
Conclusion
This study demonstrates that most referrals for CD4 testing reach their testing facilities within the expected 12-h window, with some outliers identified. Here, differences in inter-laboratory referral distances and lab-to-lab TAT performance suggest that there are inconsistent systems and practices in use to transfer samples between centres. Further investigation to understand the root causes would assist in aligning efficient delivery of all samples between facilities. There is a need for additional data collection for the inter-laboratory referral process to better understand where service bottlenecks exist. This study identified the need for electronic data recording at multiple stages of sample inter-laboratory referral such that bottlenecks can easily be identified and resolved to optimise timely referrals. For distances exceeding 300 km, the establishment of additional community CD4 laboratories is recommended.
Acknowledgements
The authors would like to thank the corporate data warehouse, and staff at the National Priority Programme unit for their assistance.
Competing interests
The authors have declared that no competing interests exist.
Authors' contributions
D.K.G. supervised the study by providing leadership and oversight and was also the project leader. N.C. and L.M.C. designed the study, developed the methodology, conducted the research, conducted the data analysis and prepared the maps. D.K.G. provided editorial comments and technical input. All authors contributed to the manuscript development.
Sources of support
This research received no specific grant from any funding agency in the public, commercial or not-for-profit sectors.
Data availability statement
Data sharing is not applicable to this article as no new data were created or analysed in this study.
Disclaimer
The views and opinions expressed in this article are those of the authors and do not necessarily reflect the official policy or position of any affiliated agency of the authors.
References
1.National Health Laboratory Service (NHLS). Annual report 2017/18 [homepage on the Internet]. Johannesburg: National Health Laboratory Service (NHLS); 2018 [cited 2018 Jul 25]. Available from: http://www.nhls.ac.za/assets/files/an_report/NHLS_AR_2018.pdf [ Links ]
2.Glencross DK, Coetzee LM, Cassim N. An integrated tiered service delivery model (ITSDM) based on local CD4 testing demands can improve turn-around times and save costs whilst ensuring accessible and scalable CD4 services across a national programme. PLoS One. 2014;9(12):e114727. https://doi.org/10.1371/journal.pone.0114727 [ Links ]
3.Glencross DK, Janossy G, Coetzee LM, et al. Large-scale affordable PanLeucogated CD4+ testing with proactive internal and external quality assessment: In support of the South African national comprehensive care, treatment and management programme for HIV and AIDS. Cytometry B Clin Cytom. 2008;74(Suppl 1):S40-S451. https://doi.org/10.1002/cyto.b.20384 [ Links ]
4.Govender NP, Glencross DK. National coverage of reflex cryptococcal antigen screening: A milestone achievement in the care of persons with advanced HIV disease. S Afr Med J. 2018;108(7):534-535. https://doi.org/10.7196/SAMJ.2018.v108i7.13094 [ Links ]
5.Coetzee LM, Cassim N, Sriruttan C, Mhlanga M, Govender NP, Glencross DK. Cryptococcal antigen positivity combined with the percentage of HIV-seropositive samples with CD4 counts <100 cells/mul identifies districts in South Africa with advanced burden of disease. PLoS One. 2018;13(6):e0198993. https://doi.org/10.1371/journal.pone.0198993 [ Links ]
6.World Health organisation (WHO). Prevent HIV, test and treat all - WHO support for country impact: Progress report [homepage on the Internet]. Geneva: World Health organisation (WHO); 2016 [cited 2019 Jul 25]. Available from: http://apps.who.int/iris/bitstream/10665/251713/1/WHO-HIV-2016.24-eng.pdf?ua=1 [ Links ]
7.Coetzee LM, Cassim N, Glencross DK. Analysis of HIV disease burden by calculating the percentages of patients with CD4 counts <100 cells/microL across 52 districts reveals hot spots for intensified commitment to programmatic support. S Afr Med J. 2017;107(6):507-513. https://doi.org/10.7196/samj.2017.v107i6.11311 [ Links ]
8.Carmona S, Bor J, Nattey C, et al. Persistent high burden of advanced HIV disease among patients seeking care in South Africa's National HIV Program: Data from a nationwide laboratory cohort. Clin Infect Dis. 2018;66(Suppl_2):S111-S117. https://doi.org/10.1093/cid/ciy045 [ Links ]
9.Coetzee LM, Cassim N, Glencross DK. Implementation of a new 'community' laboratory CD4 service in a rural health district in South Africa extends laboratory services and substantially improves local reporting turnaround time. S Afr Med J. 2015;106(1):82-87. https://doi.org/10.7196/SAMJ.2016.v106i1.10081 [ Links ]
10.Cassim N, Coetzee LM, Stevens WS, Glencross DK. Addressing antiretroviral therapy-related diagnostic coverage gaps across South Africa using a programmatic approach. Afr J Lab Med. 2018;7(1):681. https://doi.org/10.4102/ajlm.v7i1.681 [ Links ]
11.Microsoft Corporation. Microsoft Office 2013 Albuquerque [homepage on the Internet]. New Mexico: Microsoft Corporation; 2019 [cited 2019 Jul 01]. Available from: https://products.office.com/en/home [ Links ]
12.SAS Institute. SAS 9.3 [homepage on the Internet]. Cary, NC: SAS Institute; 2019 [cited 2019 Jul 01]. Available from: https://www.sas.com/en_us/software/sas9.html [ Links ]
13.Google. Google maps: Distance and travel time beween two laboratories Mountain View [homepage on the Internet]. CA: Google; 2019 [cited 2019 Aug 12]. Available from: https://www.google.com/maps [ Links ]
14.Investopedia. Skewness [homepage on the Internet]. New York, NY: Investopedia; 2019 [cited 2020 Jun 12]. Available from: https://www.investopedia.com/terms/s/skewness.asp [ Links ]
15.Coetzee LM, Glencross DK. Performance verification of the new fully automated Aquios flow cytometer PanLeucogate (PLG) platform for CD4-T-lymphocyte enumeration in South Africa. PLoS One. 2017;12(11):e0187456. https://doi.org/10.1371/journal.pone.0187456 [ Links ]
16.Coetzee LM, Lawrie D, Stevens W, Venter F, Osih R, Glencross DK, editors. Performance evaluation of PIMATM CD4 Point-of-Care (POC) analyzers in a controlled laboratory setting, Johannesburg, South Africa. XVIII International AIDS Conference; 2010 Jul 18-23; Vienna. [ Links ]
17.Coetzee LM, Moodley K, Glencross DK. Performance evaluation of the Becton Dickinson FACSPresto near-patient CD4 instrument in a laboratory and typical field clinic setting in South Africa. PLoS One. 2016;11(5):e0156266. https://doi.org/10.1371/journal.pone.0156266 [ Links ]
18.Cassim N, Coetzee LM, Schnippel K, Glencross DK. Estimating implementation and operational costs of an integrated tiered CD4 service including laboratory and point of care testing in a remote health district in South Africa. PLoS One. 2014;9(12):e115420. https://doi.org/10.1371/journal.pone.0115420 [ Links ]
19.World Health organisation (WHO). WHO prequalification of diagnostics programme: Product: BD FACSPresto™ Near-Patient CD4 Counter System [homepage on the Internet]. Geneva: World Health Organisation; 2014 [cited 2019 Jul 26]. Available from: https://www.who.int/diagnostics_laboratory/evaluations/140918_public_report_bdfacspresto_cd4.pdf [ Links ]
20.Faal M, Naidoo N, Glencross DK, Venter WD, Osih R. Providing immediate CD4 count results at HIV testing improves ART initiation. J Acquir Immune Defic Syndr. 2011;58(3):e54-e59. https://doi.org/10.1097/QAI.0b013e3182303921 [ Links ]
21.Coetzee LM, Cassim N, Glencross DK. Using laboratory data to categorise CD4 laboratory turn-around-time performance across a national programme. Afr J Lab Med. 2018;7(1):665. https://doi.org/10.4102/ajlm.v7i1.665 [ Links ]
22.Inal TC, Goruroglu Ozturk O, Kibar F, et al. Lean six sigma methodologies improve clinical laboratory efficiency and reduce turnaround times. J Clin Lab Anal. 2018;32(1):e22180. https://doi.org/10.1002/jcla.22180 [ Links ]
Correspondence:
Naseem Cassim
naseem.cassim@wits.ac.za
Received: 06 Nov. 2019
Accepted: 16 Sept. 2020
Published: 21 Dec. 2020
ORIGINAL RESEARCH
Weekly laboratory turn-around time identifies poor performance masked by aggregated reporting
Lindi-Marie CoetzeeI, II; Naseem CassimI, II; Deborah K. GlencrossI, II
INational Health Laboratory Service (NHLS), Johannesburg, South Africa
IIDepartment of Molecular Medicine and Haematology, University of the Witwatersrand, Johannesburg, South Africa
ABSTRACT
BACKGROUND: High-level monthly, quarterly and annual turn-around time (TAT) reports are used to assess laboratory performance across the National Health Laboratory Service in South Africa. Individual laboratory performances are masked by aggregate TAT reporting across network of testing facilities.
OBJECTIVE: This study investigated weekly TAT reporting to identify laboratory inefficiencies for intervention.
METHODS: CD4 TAT data were extracted for 46 laboratories from the corporate data warehouse for the 2016/2017 financial period. The total TAT median, 75th percentile and percentage of samples meeting organisational TAT cut-off (90% within 40 hours) were calculated. Total TAT was reported at national, provincial and laboratory levels. Provincial TAT performance was classified as markedly or moderately poor, satisfactory and good based on the percentage of samples that met the cut-off. The pre-analytical, testing and result review TAT component times were calculated.
RESULTS: Median annual TAT was 18.8 h, 75th percentile was 25 h and percentage within cut-off was 92% (n = 3 332 599). Corresponding 75th percentiles of component TAT were 10 h (pre-analytical), 22 h testing and 1.6 h review. Provincial 75th percentile TAT varied from 17.6 h to 34.1 h, with three good (n = 13 laboratories), four satisfactory (n = 24 laboratories) and two poor performers (n = 9 laboratories) provinces. Weekly TAT analysis showed 12/46 laboratories (28.6%) without outlier weeks, 31/46 (73.8%) with 1-10 outlier weeks and 3/46 (6.5%) with more than 10 (highest of 20/52 weeks) outlier weeks.
CONCLUSION: Masked TAT under-performances were revealed by weekly TAT analyses, identifying poorly performing laboratories needing immediate intervention; TAT component analyses identified specific areas for improvement.
Keywords: CD4; turnaround time; laboratory performance; outliers; weekly reporting.
Introduction
In South Africa, public health facilities across 52 districts provide patient care through primary healthcare (PHC) services, district, regional and tertiary hospitals. A wide spectrum of tests can be requested and submitted to the nearest pathology laboratory of the National Health Laboratory Service (NHLS). The NHLS is the choice laboratory service provider of the South Africa National Department of Health (NDoH). A network of more than 266 laboratories are strategically placed around the country to optimally accommodate the needs of local communities (urban and rural).1,2 Routine laboratory tests have a predetermined total turn-around time (TAT) cut-off that ensures that tests are processed within the required timeframe to effect the appropriate clinical intervention. Total TAT is defined as the time from first registration of a sample on the laboratory information system (LIS) to the time a result is reviewed and released to the requesting physician. TAT is in part determined by (1) the window of testing from venepuncture as prescribed by the test manufacturers, (2) time validity of sample integrity (e.g. how many hours or days before erythrocytes in blood samples die and cannot bind to antibodies effectively) and (3) the clinician timeline (emergency or quick-resulted laboratory testing vs routine laboratory testing).3,4,5 Laboratory TAT reflects the time taken for processing a sample and is a direct indicator of laboratory performance and an integral measure of efficiency where delays can impact patient management.3,4,5,6,7
HIV-associated tests like HIV viral load (VL) and CD4 counts, like all NHLS laboratory tests, have strict predetermined organisational TAT cut-offs, set to reflect treatment guidelines requirements and standards of care for HIV management by local authorities and the World Health Organization (WHO)8,9. These guidelines call for the availability of a CD4 result within 7-14 days.9 To meet this standard, the NHLS has set a within-organisation standard of 40 h for 90% of all CD4 testing to be completed and results released.
The accurate reporting of TAT depends on the quality of data collected through the LIS, that is, the inclusion of automated system date and timestamps at various time points in the journey from patient venesection to result review.10 For samples sent to NHLS laboratories, four major date and timestamps are electronically collected and used to calculate TAT components2,10: (1) pre-analytical time (lab-to-lab), that is, the time from first registration at any NHLS source laboratory to referral receipt at the designated testing laboratory, (2) analytical time (reg-to-test), time from registration at the testing laboratory to result transmission to the LIS, and (3) post-analytical time (test-to-review), time from test transmission onto the LIS to result review and verification by a senior laboratory staff member (i.e. results become available for the requesting physician or nurse to access). Total TAT is the summation of all three TAT components. The limitation of current TAT reporting is that it commences when a sample is registered at a source laboratory (nearest to testing site), that is, the time lapse from patient venesection to sample arrival at the laboratory is not included in the pre-analytical TAT.10 The majority of CD4 samples tested in NHLS laboratories originate from public health clinics of the NDoH, with no electronic system linked to LIS. For true clinical TAT assessment and impact on patient care, the time from sample collection to result receipt should be tracked, but this remains a challenge.11
Laboratory test TAT in the NHLS is monitored at national, provincial and laboratory level, with annual,12 quarterly and monthly reports generated routinely.10 Traditionally, the mean TAT is reported, but retrospective data analysis confirmed a non-Gaussian TAT distribution.4 Taking this into account, CD4 TAT reporting was upgraded to include the median, 75th percentile and percentage within cut-off to better reflect performance. The concept of classifying laboratory performance was also developed: laboratories are reported as good, satisfactory or poor, based on the 75th percentile and percentage within TAT cut-off value quadrants as described in a recent publication.10 The current monthly reports are effective at giving management a snapshot of the CD4 programme and overall (global) laboratory performance10 but cannot be used for timely interventions. Underlying problems with TAT are not detected in real time, thus corrective actions are taken retrospectively, days or weeks after they occurred.10 More frequent reporting was thus recommended in addition to traditional TAT reporting to enable more meaningful and timely interventions to improve laboratory performance. Using these described TAT parameters and classification, a weekly TAT dashboard was developed and rolled out nationally in 2018 for monitoring the TAT of some tests (the most requested HIV, tuberculosis and non-communicable diseases tests). Turn-around time data will inform corrective action such as additional test operator training.13,14 Although the cut-off values for CD4 testing changed from 85% within 48 h to 90% within 40 h in the 2016/2017 financial year, the concept and wording of laboratory performance classification were retained as managers were well acquainted with these terms.
The aim of this article is to describe how weekly review of CD4 TAT analysis can enable the identification of non-compliant laboratories to facilitate effective and timely corrective action and ensure continuous quality management for improved service delivery. Data analysed represents performance prior to the national implementation of the weekly TAT dashboard.
Methods
Ethical considerations
Ethics clearance was obtained from the University of the Witwatersrand (M1706108). No patient identifiers were used for this study and laboratories and provinces were anonymised.
CD4 turn-around time data
CD4 TAT data were extracted from the corporate data warehouse for the financial period April 2016 to March 2017 (2016/2017 financial year) for 46 CD4 testing laboratories. Total TAT was calculated for each sample tested and reported for 52 weeks, together with the TAT component data.
Data analysis included the calculation of the median, 75th percentile and the percentage of samples with a TAT within the stipulated organisation cut-off per week. This was reported per laboratory and per province (aggregated data of laboratories within each of the nine provinces). Performance classification was introduced at provincial level and based on the percentage samples within TAT cut-off as follows: (A) ≥ 95%: good performance, (B) 90.0% - 94.9%: satisfactory performance; (C) 85.0% - 89.9%: moderate to poor performance and (D) 80.0% - 84.99%: poor performance. Performance thus refers to the degree of compliance with NHLS TAT cut-off. The number of weeks that provinces and laboratories did not achieve the 40 h cut-off was reported. Outlier weeks were defined as weeks where the total TAT of all samples tested did not achieve 90% with a TAT under 40 h. Additional data analysis was done on the weekly laboratory data to describe the TAT component contribution to total TAT per laboratory per week and included: (1) lab-to-lab TAT, (2) reg-to-test TAT and (3) test-to-review TAT. The target times set for each TAT component are (1) 14 h, (2) 24 h and (3) 2 h. Although TAT component analysis by laboratory is distributed weekly, for this study, only specific laboratories were selected to represent different levels of compliance and performance categories to demonstrate how individual TAT components affects total TAT. Outlying laboratory TAT components (> 24 h and < 2 h) were correlated with Beckman Coulter engineer logs to verify the impact of instrument downtime on prolonged TAT (data not shown).
Laboratory site visits were conducted to assess root cause analysis for below standard TAT (< 90% processed for > 40 h) performance identified.
Statistical analysis
Data were prepared and analysed using SAS version 9.4 (Cary, North Carolina, United States) and GraphPad software (San Diego, California, United States). The nine provinces were numbered 1-9, with individual laboratories within a province assigned a number and labelled accordingly (i.e. 1.5 represents province 1 and laboratory 5). Box and whisker plots were created for individual laboratory data over 52 weeks. National total test volumes and TAT was plotted against the 50th and 75th percentiles in a bar graph. Provincial total TAT was plotted as 75th percentile per performance category per week. Individual laboratory distribution of 75th percentiles per performance category was plotted, indicating high (> 350 samples per day), medium (150-350 samples per day) and low volume facilities (< 150 samples per day). Component TAT was plotted as stacked bar graphs, showing the 75th percentile for pre-analytical, testing, and review TAT for selected laboratories representing the four performance categories.
Results
Global annual CD4 total turn-around time overview
In this study 3 332 599 CD4 test TAT were analysed. For the 2016/2017 financial year, the national median TAT for all CD4 tests was 18 h with a 75th percentile of 23 h (Table 1). Overall, 91% of all samples met the stipulated cut-off of 40 h, indicating good overall laboratory performance for meeting organisational criteria for CD4 testing. The matched organisational component median (and TAT 75th percentiles) for lab-to-lab TAT was 6.3 (10 h), reg-to-test TAT was 17.3 (22 h) and test-to-review TAT was 1.3 (2.1 h).

National weekly total turn-around time
The weekly distribution of the 50th percentile (median) and 75th percentile showed good consistency despite fluctuations in test volumes across the network of testing laboratories (n = 52) (Figure 1). The median ranged from 14 h to 18 h, while the 75th percentile ranged from 21 h to 26 h (Figure 1). Test volumes fluctuated between 23 681 to 80 821 per week (mean of 64 088 tests weekly).
Provincial total turn-around time distribution (75th percentile) per testing week
Annual global TAT distribution did not identify any poor performance over 52 weeks. To identify poor performances, national TAT were analysed per province. The number of CD4 tests ranged from 65 395 (lowest) to 1 066 137 (highest) (Table 2). The percentage of samples tested within the 40-h TAT cut-off ranged from 82% to 98%. Provincial performance classification was made based on the latter percentage per province, as A to D (as described above). A minimum of three laboratories represented each province.
Three provinces (3, 7 and 9) were classified as category A (good performance). These laboratories were able to maintain all CD4 reporting within organisation-stipulated TAT at greater than 95% and 75th percentile TAT of 21.7 h (province 3), 17.6 h (province 7) and 2.08 h (province 9). Four provinces (1, 2, 4 and 8) were categorised B (satisfactory performance) having 90% - 94.9% of samples meeting the TAT cut-off; 75th percentile values for these provinces were 23 h, 25.1 h, 23.4 h and 18.9 h, respectively. Two provinces failed to meet the TAT cut-off and were classified as categories C (moderate poor performance; province 6) and D (markedly poor performance province 5), indicating that less than 90% of samples met the CD4 TAT. Within the latter provincial performance clusters (C and D), the 75th percentile reported was 28.8 h and 34.2 h.
No weekly outliers (weeks where total TAT did not meet 90% < 40 h) were noted in the three good performance provinces (3, 7, and 9; comprising n = 13 individual laboratories; Figure 2a). The 75th percentile total TAT for these provinces never exceeded 30 h during the test period. Figure 2b describes the four provinces with satisfactory performance (1, 2, 4 and 8, representing 24 individual laboratories; Table 2). Among this group, province 2 and 4 showed better consistency, easily meeting the TAT cut-off throughout the test period. Province 1 had a week with 75th percentile value of 37 h while Province 8 had two weeks with 75th percentile values of 38 h and 40h. Figure 2c represents Province 6 comprising five laboratories, categorised as a moderate or poor performer, due to inconsistency, especially during weeks 24-34 of 2016, with two weeks having a 75th percentile TAT of over 40 h. After week 35 of 2016, performance stabilised and 75th percentile values corrected to within cut-off values. One province (four individual laboratories; Figure 2d) was classified as a markedly poor performer and characterised by inconsistency and repeated failure to meet the cut-off with less than 85% of reported tests meeting stipulated organisational TAT cut-off (10 weeks exceeding 40 h).
Individual laboratory total turn-around time by week and performance category
The different performance levels identified at provincial level still masked the performance and contribution of individual laboratories to provincial performance. Scatter plots were constructed to visualise the performance of individual laboratories over 52 weeks per provincial performance category. Results showed that irrespective of the provincial performance classification (Figures 3a-d), individual laboratory performance included good, satisfactory and poor performance laboratories.
The 75th percentile across 52 weeks for the good performance provinces (3 provinces and 13 laboratories) showed good overall compliance (tight clumping of weekly 75th percentile values) where the overall 75th percentile for the whole period ranged from 5.9 h (laboratory 7.1) to 24.8 h (laboratory 9.2) (Figure 3a). Similarly, the satisfactory performance provinces (n = 24 laboratories) (Figure 3b) had a 75th percentile ranging from 10 h (laboratory 4.3) to 34.2 h (laboratory 4.4). The provinces having moderately poor performance had variable TAT between 9 h (laboratory 6.4) to 35.7 h (laboratory 6.2) (Figure 3c) while markedly poor performance provinces had TAT 75th percentile values ranging from 17.2 h (laboratory 5.4) to 39.7 h (laboratory 5.5) (Figure 3d). Overall, four laboratories recorded a 52-week median TAT of more than 30 h.
The number of weeks that laboratories did not meet the cut-off criteria of 90% with TAT under 40 h varied among categories and laboratories (0-22 weeks), where 12 of 46 laboratories (irrespective of performance category) had zero outlying weeks (26%), 25/46 (54%) more than 5 outlying weeks and 6 (13%) between 6 and 10 outlying weeks. Only three laboratories showed outliers for more than 10 weeks where cut-off was not met (6.5%).
Case examples of individual laboratory component turn-around time analysis
Figure 4a shows a good performer high-volume laboratory, doing more than 350 samples per day with no outlying weeks (exceeding 40 h cut-off). Over the 52 weeks, 86 559 tests were performed by this laboratory. A lab-to-lab 75th percentile of 9.5 h was reported (ranging from 3 h to 16 h), with a reg-to-test of 8.8 h (range from 6 h to 17 h) and a test-to-review of 1.3 h (range from 0 h to 4 h). More than 98% of all samples tested had a total TAT of under 40 h.
Figure 4b represents a satisfactory performance laboratory, doing 63 998 samples for the period. It reported nine non-consecutive weeks of outliers (exceeding 40 h). Of these outlier weeks, eight were due to prolonged reg-to-test (testing delay), where this component contributed between 27 h and 87 h to the total TAT reported for these weeks. One week (week 51 of 2016) had an extended lab-to-lab value of 65 h, due to confirmed challenges with logistics. Test-to-review ranged from 0 h to 6 h and, as such, had no contribution to the outlying weeks. Extended reg-to-test (within laboratory TAT) seen in weeks 6-11 of 2017 correlated with instrument downtime based on data provided by Beckman Coulter call centre log on engineers dispatched.
The laboratory represented in Figure 4c (moderate to poor performance) tested 77 640 samples during the 52 weeks and had an overall lab-to-lab 75th percentile of 17.7 h (ranging from 10 h to 78 h per week), with 11 weeks exceeding the target total TAT (highest recorded total TAT of 129 h). The lab-to-lab component (orange bars) contributed to total TAT outlying weeks during weeks 21, 30-32, and 48 of 2016 and weeks 11 and 18 of 2017. Reg-to-test (within laboratory TAT) was the leading cause of outliers noticed during weeks 30-32, 47-48 of 2016 and weeks 11, 15 and 18 of 2016. The combined extended TAT in two components (i.e. pre-analytical or lab-to-lab and analytical or reg-to-test) for weeks 30-32 of 2016 and weeks 15 and 18 of 2017 contributed to the total TAT for this laboratory to fall into a category of 85% - 90% of samples within the TAT target of 40 h.
The laboratory contributing the most outlying weeks to group D (Figure 3d) was analysed for component TAT. This laboratory had 18 weeks of exceeding the target total TAT. This was for the most part due to prolonged within laboratory TAT (blue bars, Figure 4d). From week 31 to 45 of 2016 the reg-to-test component contributed as much as 81 h (week 40 of 2016) to the weekly TAT. During this period, some weeks also experienced prolonged test-to-review times of up to 25 h (week 1 of 2017).
Discussion
TAT remains a key performance indicator of laboratory service efficiency.4,14 The parameters reported (mean vs median) and time intervals of reporting impacts the utilisation of TAT as a means to identify and address non-compliance to organisational cut-offs. Definitions of TAT may vary and depend on the test (routine or emergency), priority of reporting (immediate or delayed clinical intervention), the population served and activities or components measured.4 The clinical outcome, needs and responsibilities of management determine how TAT information is used to ensure that there are no unnecessary delays in result reporting. Across the NHLS, TAT information typically remains the jurisdiction of the testing laboratory where the laboratory manager uses this data to identify problems and initiate corrective action; the individual laboratory has sole and direct access to its own daily or weekly TAT data.3,4,5 TAT monitoring is however critical for priority programmes, such as HIV and tuberculosis,2,12 where individual laboratories monitor their respective test TAT, while the organisation is responsible for reporting performance of the network of laboratories. Relevant updated information on the efficiency of service delivery is vital in this context for risk assessment and timely intervention to ensure the continued excellence of service delivery10 and meeting dire local HIV and tuberculosis programme needs.9
Ideally, sample-by-sample real-time reporting of TAT would be the preferred way to monitor and assist laboratories in the identification of specific service delivery and related TAT challenges. Hierarchical global overview (usually annual) TAT reporting is however the simplest and most widely used, but masks poor performance, as confirmed by data from this study. Interrogating the weekly data by drilling down to laboratory level at weekly intervals, enables the identification of outliers and poor performers. This study showed that lower hierarchical levels, as well as shorter time periods, can unveil problematic and inefficient testing laboratories (Figure 2 and Figure 3). Adding weekly TAT component analysis at laboratory level further identifies problematic testing weeks and possible causes of prolonged TAT (Figure 4 and Box 1).

The most common issues that impacted on prolonged lab-to-lab (pre-analytical) TAT were delays in transport or sample collection from clinics to testing laboratories and changes in courier routes and pick up times. Reg-to-test times (laboratory TAT) were prolonged due to instrument downtime, lack of trained staff to operate testing instruments, delayed sample registration in the testing facility, challenges with reagent availability and timely delivery, and staff strikes.15 Delays in the test-to-review phase, were mostly due to lack of result auto-authorisation in high-volume laboratories, nonavailability of result authorising staff when samples are analysed during night shifts or where problems with connectivity of the TrackCare LIS were reported. Several references focus on the main causes of TAT delays.5,16,17,18,19,20,21,22 The main objective of this study, however, was not to describe causes of delayed TAT, but to emphasise the importance of TAT monitoring with shorter time intervals as a means of more proactive interventions for sustained good performance across network of laboratories.
Data reported here demonstrate the need for more frequent TAT reporting in effective performance management.10,13,15,23,24 An interactive weekly TAT dashboard was introduced nationally in 2018 for the most requested tests across the NHLS. Frequent performance reporting can be effective in identifying challenges with meeting target TAT cut-offs allowing for timely interventions.13 Weekly assessment of TAT and TAT components not only identifies problematic testing laboratories or days with TAT challenges, but also enables the identification of individual outlier samples that can be investigated (root cause analysis) to assess causes of TAT delays.
Based on the data presented in this study, further refinement of the current reporting platforms is recommended to include daily reporting for rapid proactive intervention. A further recommendation is to integrate daily quality control tests, external quality assessment testing and equipment downtime supplier call-out data into the reporting to assist with focused troubleshooting and interventions.
Turn-around time monitoring and reporting are however guided by the requirements of the end user and will continue to be available at various time intervals for laboratory network management to assess overall trends, with weekly or daily reports to laboratory and programme managers enabling timely proactive intervention to ensure optimal laboratory performance and timely patient result reporting.
Limitations
The monitoring of TAT in the NHLS is currently limited as end-to-end sample tracking system is absent. The TAT reported in this article thus only represents the time from first registration on the LIS to review of the result.
Conclusion
National and provincial analysis of TAT mask individual laboratory performance; therefore, TAT analysis by week and by laboratory is recommended to highlight laboratory TAT inefficiencies. Root-cause analyses were able to identify pre-analytical, analytical or post-analytical factors contributing to performance. TAT data was used to categorise performance at the provincial and laboratory level.
This study used the concept of zooming in to lower levels and shorter times of TAT reporting to identify possible non-compliant laboratories. In conclusion: (1) outlying weeks are not prescribed by provincial or laboratory classification of performance, (2) performance did not correlate to the size of the laboratory (i.e. test volumes of high, medium and low), (3) there were laboratories that had no outlier weeks during the analysed period that can serve as model laboratories for setting performance standards and good reproducibility of week-on-week performance across a network of testing laboratories.
Acknowledgements
This article was in part presented as a poster at the African Society for Laboratory Medicine meeting in 2018, Abuja, Nigeria (ID:PS-2-3b-070), 10-13 December 2018. The authors thank area, business and laboratory managers in the NHLS for their feedback on the use of the weekly TAT dashboard. Thank you to the Central Data Warehouse for the availability of data.
Competing interests
The authors have declared that no competing interests exist.
Authors' contributions
D.K.G. supervised the study by providing leadership and oversight as the project leader. L.-M.C. and N.C. designed the study, developed the methodology and conducted the research, data analysis, initial write-up and review. D.K.G. reviewed the data, provided editorial comments and technical input. All authors contributed to the manuscript development.
Sources of support
This research received no specific grant from any funding agency in the public, commercial or not-for-profit sectors.
Data availability statement
Data is available as online Supplementary Document 1.
Disclaimer
The views and opinions expressed in this article are those of the authors and do not necessarily reflect the official policy or position of any affiliated agency of the authors.
References
1.National Health Laboratory Service (NHLS). NHLS annual report 2014/15 Sandringham [homepage on the Internet]. Johannesburg: National Health Laboratory Service; 2015 [cited 2017 Jul 26]. Available from: http://intranet.nhls.ac.za/assets/files/policy/NHLS_Annual_Report_2015.pdf [ Links ]
2.Glencross DK, Coetzee L, Cassim N. An integrated tiered service delivery model (ITSDM) based on local CD4 testing demands can improve turn-around times and save costs whilst ensuring accessible and scalable CD4 services across a national programme. PLoS One. 2014;9(12):e114727. https://doi.org/10.1371/journal.pone.0114727 [ Links ]
3.Goswami B, Singh B, Chawla R, Gupta VK, Mallika V. Turn around time (TAT) as a benchmark of laboratory performance. Indian J Clin Biochem. 2010;25(4):376-379. https://doi.org/10.1007/s12291-010-0056-4 [ Links ]
4.Hawkins RC. Laboratory turnaround time. Clin Biochem Rev. 2007;28(4):179-194. [ Links ]
5.Pati HP, Singh G. Turnaround time (TAT): Difference in concept for laboratory and clinician. Indian J Hematol Blood Transfus. 2014;30(2):81-84. https://doi.org/10.1007/s12288-012-0214-3 [ Links ]
6.Valenstein P. Laboratory turnaround time. Am J Clin Pathol. 1996;105(6):676-688. https://doi.org/10.1093/ajcp/105.6.676 [ Links ]
7.Valenstein PN, Emancipator K. Sensitivity, specificity, and reproducibility of four measures of laboratory turnaround time. Am J Clin Pathol. 1989;91(4):452-457. https://doi.org/10.1093/ajcp/91.4.452 [ Links ]
8.World Health Organisation. Guidelines for managing advanced HIV disease and rapid initiation of antiretroviral therapy [homepage on the Internet]. Policy Brief. Geneva: WHO; 2017 [cited 2019 Jul 16]. Available from: https://www.who.int/hiv/pub/toolkits/advanced-HIV-disease-policy/en/ [ Links ]
9.National Department of Health (NDOH). National consolidated guidelines for the prevention of mother-to-child transmission of HIV (PMTCT) and the management of HIV in children, adolescents and adults [homepage on the Internet]. Pretoria; 2015 [cited 2019 Jul 16]. Available from: https://sahivsoc.org/Files/ART%20Guidelines%2015052015.pdf [ Links ]
10.Coetzee L, Cassim N, Glencross DK. Using laboratory data to categorise CD4 laboratory turn-around-time performance across a national programme. Afr J Lab Med. 2018;7(1):a665. https://doi.org/10.4102/ajlm.v7i1.665 [ Links ]
11.Stotler BA, Kratz A. Determination of turnaround time in the clinical laboratory: "Accessioning-to-result" time does not always accurately reflect laboratory performance. Am J Clin Pathol. 2012;138(5):724-729. https://doi.org/10.1309/AJCPYHBT9OQRM8DX [ Links ]
12.National Health Laboratory Service (NHLS). Annual report 2017/18 [homepage on the Internet]. Johannesburg: National Health Laboratory Service (NHLS); 2018 [cited 2018 Dec 10]. Available from: http://www.nhls.ac.za/assets/files/an_report/NHLS_AR_2018.pdf [ Links ]
13.Cassim N, Coetzee LM, Tepper MEE, Perelson L, Glencross DK. Timely delivery of laboratory efficiency information, Part II: Assessing the impact of a turn-around time dashboard at a high-volume laboratory. Afr J Lab Med. 2020;9(2):a948. https://doi.org/10.4102/ajlm.v9i2.948 [ Links ]
14.Cassim N, Coetzee L-M, Tepper M, Motlonye B, Glencross DK, editors. TAT as a risk model for operational services. Johannesburg: PathRed. 2017. [ Links ]
15.Coetzee L, Cassim N, Tepper M, Glencross DK. The importance of reporting individual weekly laboratory turn-around-time (TAT) to identify outliers and underperformance masked during global annual TAT review. ASLM Conference; 2018 Dec 10-13; Abuja; p. Poster: ID PS-2.3b-070. [ Links ]
16.Cakirca G. The evaluation of error types and turnaround time of preanalytical phase in biochemistry and hematology laboratories. Iran J Pathol. 2018;13(2):173-178. https://doi.org/10.30699/ijp.13.2.173 [ Links ]
17.Chauhan KP, Trivedi AP, Patel D, Gami B, Haridas N. Monitoring and root cause analysis of clinical biochemistry turn around time at an academic hospital. Indian J Clin Biochem. 2014;29(4):505-509. https://doi.org/10.1007/s12291-013-0397-x [ Links ]
18.Jalili M, Shalileh K, Mojtahed A, Mojtahed M, Moradi-Lakeh M. Identifying causes of laboratory turnaround time delay in the emergency department. Arch Iran Med. 2012;15(12):759-763. https://doi.org/0121512/AIM.008 [ Links ]
19.Khalifa M, Khalid P. Improving laboratory results turnaround time by reducing pre analytical phase. Stud Health Technol Inform. 2014;202:71-74. https://doi.org/10.3233/978-1-61499-423-7-71 [ Links ]
20.Lou AH, Elnenaei MO, Sadek I, Thompson S, Crocker BD, Nassar BA. Multiple pre- and post-analytical lean approaches to the improvement of the laboratory turnaround time in a large core laboratory. Clin Biochem. 2017;50(15):864-869. https://doi.org/10.1016/j.clinbiochem.2017.04.019 [ Links ]
21.Minchella PA, Chipungu G, Kim AA, et al. Specimen origin, type and testing laboratory are linked to longer turnaround times for HIV viral load testing in Malawi. PLoS One. 2017;12(2):e0173009. https://doi.org/10.1371/journal.pone.0173009 [ Links ]
22.Saathoff AM, MacDonald R, Krenzischek E. Effectiveness of specimen collection technology in the reduction of collection turnaround time and mislabeled specimens in emergency, medical-surgical, critical care, and maternal child health departments. Comput Inform Nurs. 2018;36(3):133-139. https://doi.org/10.1097/CIN.0000000000000402 [ Links ]
23.Cassim N, Tepper ME, Coetzee LM, Glencross DK. Timely delivery of laboratory efficiency information, Part I: Developing an interactive turnaround time dashboard at a high-volume laboratory. Afr J Lab Med. 2020;9(2):a947. https://doi.org/10.4102/ajlm.v9i2.947 [ Links ]
24.Coetzee L, Cassim N, Tepper M, Glencross DK. Standardizing individual laboratory turnaround time (TAT) performance amongst laboratories in a CD4 testing network. PathCape 2018: 56th International FSASP Congress; 2018 Aug 16-18; Stellenbosch. [ Links ]
Correspondence:
Lindi-Marie Coetzee
lindi.coetzee@nhls.ac.za
Received: 18 Sept. 2019
Accepted: 14 Sept. 2020
Published: 21 Dec. 2020
Note: Additional supporting information may be found in the online version of this article as Supplementary Document 1.
^rND^sGlencross^nDK^rND^sCoetzee^nL^rND^sCassim^nN^rND^sGoswami^nB^rND^sSingh^nB^rND^sChawla^nR^rND^sGupta^nVK^rND^sMallika^nV^rND^sHawkins^nRC^rND^sPati^nHP^rND^sSingh^nG^rND^sValenstein^nP^rND^sValenstein^nPN^rND^sEmancipator^nK^rND^sCoetzee^nL^rND^sCassim^nN^rND^sGlencross^nDK^rND^sStotler^nBA^rND^sKratz^nA^rND^sCassim^nN^rND^sCoetzee^nLM^rND^sTepper^nMEE^rND^sPerelson^nL^rND^sGlencross^nDK^rND^sCoetzee^nL^rND^sCassim^nN^rND^sTepper^nM^rND^sGlencross^nDK^rND^sCakirca^nG^rND^sChauhan^nKP^rND^sTrivedi^nAP^rND^sPatel^nD^rND^sGami^nB^rND^sHaridas^nN^rND^sJalili^nM^rND^sShalileh^nK^rND^sMojtahed^nA^rND^sMojtahed^nM^rND^sMoradi-Lakeh^nM^rND^sKhalifa^nM^rND^sKhalid^nP^rND^sLou^nAH^rND^sElnenaei^nMO^rND^sSadek^nI^rND^sThompson^nS^rND^sCrocker^nBD^rND^sNassar^nBA^rND^sMinchella^nPA^rND^sChipungu^nG^rND^sKim^nAA^rND^sSaathoff^nAM^rND^sMacDonald^nR^rND^sKrenzischek^nE^rND^sCassim^nN^rND^sTepper^nME^rND^sCoetzee^nLM^rND^sGlencross^nDK^rND^sCoetzee^nL^rND^sCassim^nN^rND^sTepper^nM^rND^sGlencross^nDK^rND^1A01 A02 A03^nVictor N.^sFondoh^rND^1A04^nRichard M.^sFondoh^rND^1A05^nCharles N.^sAwasom^rND^1A06^nPefoule L.^sEdith^rND^1A07^nWinlove A.^sNtungwen^rND^1A08^nBong^sRoland^rND^1A09^nRebeca^sEnow-Tanjong^rND^1A10^nPatrick^sNjukeng^rND^1A11^nJudith^sShang^rND^1A12^nEgbe P.^sEgbengu^rND^1A13^nTalkmore^sMaruta^rND^1A14^nAkazong^sEtheline^rND^1A15^nRobert^sLeke^rND^1A16^nAyuk^sLeo^rND^1A17^nDenis^sNsame^rND^1A01 A02 A03^nVictor N.^sFondoh^rND^1A04^nRichard M.^sFondoh^rND^1A05^nCharles N.^sAwasom^rND^1A06^nPefoule L.^sEdith^rND^1A07^nWinlove A.^sNtungwen^rND^1A08^nBong^sRoland^rND^1A09^nRebeca^sEnow-Tanjong^rND^1A10^nPatrick^sNjukeng^rND^1A11^nJudith^sShang^rND^1A12^nEgbe P.^sEgbengu^rND^1A13^nTalkmore^sMaruta^rND^1A14^nAkazong^sEtheline^rND^1A15^nRobert^sLeke^rND^1A16^nAyuk^sLeo^rND^1A17^nDenis^sNsame^rND^1A01 A02 A03^nVictor N^sFondoh^rND^1A04^nRichard M^sFondoh^rND^1A05^nCharles N^sAwasom^rND^1A06^nPefoule L^sEdith^rND^1A07^nWinlove A^sNtungwen^rND^1A08^nBong^sRoland^rND^1A09^nRebeca^sEnow-Tanjong^rND^1A10^nPatrick^sNjukeng^rND^1A11^nJudith^sShang^rND^1A12^nEgbe P^sEgbengu^rND^1A13^nTalkmore^sMaruta^rND^1A14^nAkazong^sEtheline^rND^1A15^nRobert^sLeke^rND^1A16^nAyuk^sLeo^rND^1A17^nDenis^sNsameORIGINAL RESEARCH
Haematological reference intervals for healthy adults in Bamenda, Cameroon
Victor N. FondohI, II, III; Richard M. FondohIV; Charles N. AwasomV; Pefoule L. EdithVI; Winlove A. NtungwenVII; Bong RolandVIII; Rebeca Enow-TanjongIX; Patrick NjukengX; Judith ShangXI; Egbe P. EgbenguXII; Talkmore MarutaXIII; Akazong EthelineXIV; Robert LekeXV; Ayuk LeoXVI; Denis NsameXVII
IAdministration/Quality Management, Bamenda Regional Hospital Laboratory, Regional Hospital Bamenda, Bamenda, Cameroon
IIDepartment of Medical Laboratory Sciences, School of Health and Medical Sciences, Catholic University of Cameroon, Bamenda, Cameroon
IIIDepartment of Health Economics Policy and Management, Faculty of Business Management, University of Cameroon, Bamenda, Cameroon
IVAdministration/ Pharmaceutical Management, North-West Regional Fund for Health Promotion, Bamenda, Cameroon
VDepartment of Anatomy, School of Health and Medical Sciences, Catholic University of Cameroon, Bamenda, Cameroon
VIBamenda Regional Hospital Laboratory, Regional Hospital Bamenda, Cameroon
VIIPatient First Laboratory, Columbia, Maryland, United States
VIIIProduct Safety/Quality Control Mangement, Geochim Sarl, Cameroon
IXDepartment of Medical Laboratory Science, School of Health and Medical Sciences , Catholic University of Cameroon, Bamenda, Cameroon
XGlobal Health Systems Solutions, Limbe, Cameroon
XILaboratory Service, Center for Disease Control and Prevention, Yaoundé, Cameroon
XIIDepartment of Medicine and Surgery, School of Health and Medical Sciences, Catholic University of Cameroon, Bamenda, Cameroon
XIIIEast Central and Southern Africa Health Community, Arusha, United Republic of Tanzania
XIVDepartment of Biochemistry, University of Dschang, Dschang, Cameroon
XVDepartment of Medicine and Surgery, School of Health and Medical Sciences, Catholic University of Cameroon, Bamenda, Cameroon
XVITB-Department, Regional Hospital Bamenda, Bamenda, Cameroon
XVIIAdministration/Management, Regional Hospital Bemenda, Bamenda, Cameroon
ABSTRACT
BACKGROUND: In the era of evidence-based medicine, haematological reference intervals are essential for the interpretation of data for clinical decision-making, monitoring of treatment and research. It is not uncommon that reference intervals used in most African countries have been obtained from published scientific literature, textbooks, reagent/instrument manuals.
OBJECTIVE: The aim of this study was to determine haematological reference intervals of healthy adults in Bamenda, Cameroon.
METHODS: This was a cross-sectional study conducted between June and November 2015. Participants were voluntary blood donors at the Blood Bank Service of the Regional Hospital Bamenda aged between 18 and 65 years. The mean, median and standard deviation of the mean were calculated for each haematological parameter. The 95th percentile reference intervals were determined using the 2.5th and 97.5th percentile. The differences between gender for all the parameters were evaluated using the Kruskal-Wallis test. Significance was determined at the 95% confidence level.
RESULTS: Out of a total of 340 participants, 202 (59.4%) were men and 138 (40.6%) were women. The median red blood cell, haemoglobin, haematocrit and mean cell haemoglobin concentration were significantly higher in men than women (p < 0.001). The median white blood cell, absolute lymphocytes count, absolute granulocytes and platelet counts for men were significantly lower than those for women (p < 0.011).
CONCLUSION: We propose that the present established haematological reference intervals in this study should be used for clinical management of patients and interpretation of laboratory data for research in Bamenda.
Keywords: haematological reference intervals; African population; pathogenic infections; haematological abnormalities; Cameroon; Clinical and Laboratory Standard Institute; local reference values; Bamenda.
Introduction
Haematological reference intervals are essential for the interpretation of data for diagnosis, clinical decision-making and research in this era of evidence-based medicine. It is not uncommon that reference intervals used in most African countries have been obtained from published scientific literature, textbooks,1,2 the world wide web, reagent package inserts or instrument manuals.3 More often than not, these values have been established from 'Caucasian' populations in Europe or the United States and may not apply to local settings.4,5 There is published literature to confirm that haematological reference intervals established in African populations6,7,8,9,10,11,12,13 differ significantly from those obtained from Caucasian populations.5,14,15 Several factors, including inter- and intra-population variation among populations of the same race, age, sex, geographical origin, altitude, genetics, dietary patterns and ethnicity,7,16,17,18,19,20 account for the differences in these reference intervals. Moreover, pathogenic infections such as HIV, Hepatitis B Virus (HBV), Hepatitis C Virus (HCV), syphilis and some haematological abnormalities generally influence the haematological intervals.9,21,22 Besides, the Clinical and Laboratory Standard Institute recommends that clinical laboratories establish and/or verify their local reference values.21,23
Cameroon is one of the countries that has been burdened by the malaria and HIV epidemics and that has received multilevel interventions, including access to drugs, and capacity building to manage prevention, treatment and clinical trials. There is little published literature on haematological reference intervals established for the population of Yaoundé in Cameroon.6 These intervals cannot be used nationwide since Yaoundé is not representative of the average topography or ecological niche of Cameroon, in general, and Bamenda, in particular. Besides the fact that Bamenda is at a lower altitude than Yaoundé City and differs from other settlements and ethnic groups, there is a need for clinical laboratories to establish and harmonise standard intervals in all localities23 for effective clinical decision-making, monitoring of treatment and management of interventions.24,25,26,27 The objective of this study was to determine the haematological reference intervals of healthy adults between April and September 2015 in Bamenda, Cameroon.
Methods
Ethical considerations
Ethical clearance to carry out this research was obtained from the Institutional Review Board of Regional Hospital Bamenda, Cameroon (Number: 029/APP/RDPH/RHB/IRB). Participants consented to participate in the study by signing the consent form. Participants could withdraw from the study even after signing the consent form.
Study area
The study was conducted at the Regional Hospital Bamenda situated in Bamenda, capital of the North-West region of Cameroon, which lies at an altitude between 1100 m and 1430 m above sea level.28,29 Because of its high socio-economic activity, Bamenda is a cosmopolitan city with settlements of people from diverse ethic backgrounds,30 including Mankon, Nkwen, Bamendakwe, Nsongwa, Mbatu, Chomba and Bandza.31 As it is situated in the grass fields, most of their diet includes varieties of vegetables.32
Regional Hospital Bamenda has standard clinical laboratory and Blood Bank services. The laboratory has been implementing laboratory quality management systems since 2010 and obtained ISO 15189 accreditation by the South African National Accreditation Services in 2017 for Biochemistry, Serology and Haematology services.33 Currently, the Blood Bank service is in the process of certification with the Safe Blood for Africa Foundation.
Research design
This was a cross-sectional descriptive study conducted between April 2015 and September 2015. The participants were voluntary blood donors who presented during the Regional Hospital Bamenda's voluntary blood donation programme. Blood samples were collected from the Mankon, Nkwen and Bamendakwe settlements. A stratified and clustered sampling method was used. The population was divided into two groups (men and women) and at least 50 samples were collected from participants at each site and from each sex. The blood donors were subjected to several physical and medical screening protocols, as required by the national blood transfusion programme of the Ministry of Health, Cameroon,34 in addition to the Clinical and Laboratory Standards Institute guidelines for the establishment of reference intervals21 using a questionnaire.
The questionnaire was used to profile eligible donor. Criteria include: the donor should be free from any non-communicable disease, should not have donated blood or had any sexually-transmitted diseases in the previous three months, should not have been sick or been vaccinated during the previous four months and should not have been on any medication for at least a week before sample collection. Also, the donor should not have smoked on the day of donation or should not have drunk alcohol for at least 24 hours before donation. Female donors should not be pregnant, breastfeeding, or on or expecting their menses within one week of the donation. Furthermore, the donor should be between the ages of 18 and 60 years (women) and 18 and 65 years (men), with blood pressure of 100 mmHg - 140 mmHg/60 mmHg - 100 mmHg, weight greater than 50 kg, and temperature between 36.0 °C - 37.5 °C. Blood specimens were collected from donors who were physically fit and who consented to be part of the study. We anticipated enrolling at least 150 participants from each sex to meet the minimum target of at least 120 or more participants after exclusions, as recommended by the Clinical and Laboratory Standards Institute.21
Inclusion and exclusion criteria
Participants that met the inclusion criteria for voluntary blood donation were excluded if they were positive for HIV, HBV, HCV or syphilis. Participants who were sickle cell disease carriers (had the AS genotype) or who had sickle cell disease (had the SS genotype) were also excluded. Participants who did not meet the inclusion criteria, who did not consent, or who withdrew their consent after consenting, were excluded.
Sample collection
Blood was collected by trained and competent personnel into two 5 mL vacutainer tubes containing dipotassium ethylene diamine tetraacetic acid (K2EDTA). Samples were stored and transported to the Blood Bank service of the Regional Hospital Bamenda in a cold chain between 2 °C and 8 °C within 2 h of collection. One tube was used for screening HIV, HBV, HCV, syphilis and haemoglobin electrophoresis, and the other for complete blood count analysis. The plasma was separated from the red blood cells in separate tubes within 1 h of the samples' arrival at the Blood Bank. Both tubes were stored at 4 °C - 8 °C for testing the following day.
HIV, hepatitis B virus, hepatitis C virus, syphilis and haemoglobin electrophoresis testing
Plasma samples were screened at the Blood Bank department of the Regional Hospital Bamenda. The national algorithm of a rapid test for HIV screening in Cameroon was used.35 Samples were screened for HIV using the HIV-1/2 Ag/Ab Combo Determine (Alere Medical Co., Ltd, Matsuhidai, Matsudo-Shi, Chiba-ken, Japan) as the first-line test and OraQuick (OraSure Technologies, Inc., Bethlehem, Pennsylvania, United States) as the second-line test. All participants who were HIV-negative with the first-line test were confirmed as negative with the second-line test. Participants who were positive for HIV with the first-line test only were declared positive and excluded. Syphilis was screened using the Rapid Plasma Reagin carbon slide agglutination assay (Cypress Diagnostics, Langdorp, Belgium) and the Treponema pallidum haemagglutination test for the serodiagnosis of syphilis - IMMUTREP® TPHA (Omega Diagnostics LTD, Alva, Scotland, United Kingdom). Hepatitis B virus was screened for using the HBsAg DiaSpot rapid diagnostic test (DIASpot Diagnostics, Jawa Barat, Indonesia) while Hepatitis C virus antigen was detected using the HCV Ag DiaSpot rapid diagnostic test (DIASpot Diagnostics, Jawa Barat, Indonesia). Haemoglobin electrophoresis was done using the Hospitex Diagnostics (Hospitex Diagnostics Srl, Sesto Fiorentino, Italy) electrophoresis machine.
The haematological analysis was done within 6 h of sample collection, using the Urit 3300 auto-analyser (Urit Medical Electronic [Group] Co., Ltd, Guilin, China). The instrument was calibrated using Eurocell Diagnostics internal controls (Eurocell Diagnostics, Rennes Cedex, France), following the protocol provided by the manufacturer. The analyser automatically counted and gave a print-out of results for: red blood cells (RBC); haemoglobin (g/dL); haematocrit (%); mean cell volume; mean cell haemoglobin; mean cell haemoglobin concentration); coefficient of variation for the standard deviation of red cell distribution (%); standard deviation of red cell distribution; white blood cells (WBC); proportion of lymphocytes (%), monocytes (%) and granulocytes (%); absolute count of lymphocytes (×109/L), monocytes (×109/L) and granulocytes (×109/L); platelets; mean platelet volume; platelet distribution width and plateletcrit.
Quality control
The Urit 3300 auto-analyser used for the analysis of the specimens went through a vigorous formal verification process following the Clinical Laboratory Standards Institute guidelines21 and the policies of the quality management system of the Bamenda Regional Hospital Laboratory. Precision was monitored daily using commercial internal controls (Eurocell Diagnostics, Rennes Cedex, France) and reviewed using a Levey-Jennings control chart. Randox International Quality Assurance Scheme RIQAS (Randox Laboratories Limited, Crumlin, County Antrim, United Kingdom) external quality controls were done bi-monthly to monitor accuracy. The analysis was suspended if the daily commercial internal control failed. The analysis was done by a trained and competent technician.
Data collection
Data were collected by three trained personnel using a structured data collection format. Data for age, sex and haematological parameters for the participants who were negative for HIV, HBV, HCV and syphilis, with no haemoglobin abnormalities, were collected from the print-out of the Urit 3300 auto-analyser. Data were entered into Excel 2007 software (Microsoft Corp., Redmond, Washington, United States) and double-checked for data entry errors by a second person.
Statistical analysis
The analysis was done using Microsoft Excel 2007 spreadsheet (Microsoft Corporation, Redmond, Washington, United States) and SPSS version 16 software (IBM Corp., Chicago, Illinois, United States). Outliers were eliminated using the box plot function. The median, mean and standard deviation were calculated for each haematological parameter. The 95th percentile reference intervals were determined using the 2.5th and 97.5th percentile. The differences between sexes for all the parameters were evaluated using the Kruskal-Wallis test. Significance was determined at the 95% confidence level.
Results
Of the 487 individuals who presented for the blood donation campaigns, 147 were excluded as per the exclusion criteria (Table 1). Of the 340 participants included in the study, 202 were male (59.4%) and 138 were female (40.6%) within the age range of 18-60 years (95% confidence interval: 31.5 ± 10.9; median age = 29 years). One hundred and thirty-nine participants (40.9%) were aged 18-25 years, 97 (28.5%) were aged 26-35 years, 62 (18.2%) were aged 36-45 years, 35 (10.3%) were aged 46-55 years, and 7 (2.1%) were aged 56-65 years (Figure 1).


The median RBC, haemoglobin, haematocrit and mean cell haemoglobin concentration were significantly higher in men than in women (RBC: 5.31 × 1012/L vs. 4.60 × 1012/L, p < 0.001; haemoglobin: 14.6 g/dL vs. 12.6 g/dL, p < 0.001; haematocrit: 43.9% vs. 38.3%, p < 0.001; and mean cell haemoglobin concentration: 33.1 g/dL vs. 32.8 g/dL, p = 0.005). Although the median mean cell volume and mean cell haemoglobin were higher in men than women (mean cell volume 27.6 fL vs. 27.3 fL, p = 1.000; and mean cell haemoglobin 27.6 pg vs. 27.3 pg, p = 0.147), the differences were not statistically significant (Table 2).
The median total WBC, absolute lymphocyte count and absolute granulocyte count were significantly lower in men than in women (WBC: 5.0 × 109/L vs. 5.5 × 109/L, p = 0.002; absolute lymphocyte count: 2.1 × 109/L vs. 2.2 × 109/L, p = 0.011; and absolute granulocyte count: 2.4 × 109/L vs. 2.8 × 109/L, p = 0.002). Although the absolute median monocyte count for men was relatively higher than that of women, the difference was not statistically significant (Table 3).
Also, the median platelet count was significantly lower in men (231 × 109/L) than in women (253 × 109/L; p = 0.009). There was no statistically significant difference between the median mean platelet volume, platelet distribution width and plateletcrit for men as compared to women (Table 4).

Discussion
The reference interval for haematological parameters, which may serve as a standard for decision-making on clinical laboratory results, treatments and research, were established from 340 participants from Bamenda City, Cameroon. The participants included 202 (59.4%) men and 138 (40.6%) women aged between 18 and 60 years.
According to our findings, the median RBC, haemoglobin and haematocrit for men were significantly higher than for women. These variations may be attributed to the influence of the hormone androgen on erythropoiesis as well as menstrual blood loss in women.36 Our findings are consistent with previous reports in Africa, including Oloume et al. in Cameroon,6 Awad et al. in Sudan,38 Addai-Mensah et al. in Ghana,7 Bakrim et al. in Morocco,8 Mulu et al. in Ethiopia13 and Yalew et al. in Ethiopia,12 Miri-Dashe et al. in Nigeria,36 Dosoo et al. in Ghana10 and Kueviakoe et al. in Togo,9 Karita et al. in Eastern and Southern South Africa21 and Menard et al. in Central Africa.20 Similar findings have also been reported in the United States.5 According to Oloume et al. in the Yaounde study in Cameroon, RBC, haemoglobin, haematocrit and mean cell haemoglobin concentration were lower compared to those obtained in this study.6 In their study, however, haemoglobin abnormalities were not excluded from their sample collection, considering the 2% prevalence of sickle cell disease in Cameroon37 and may thus account for the low values reported. Besides, Bamenda is at a higher altitude than Yaoundé29,39,40 and is situated in the grassland; also, its inhabitants are used to the consumption of vegetables32 which have a high iron content that may increase the erythrocyte parameters. At higher altitude, there are physiological changes to humans that compensate for the lower partial pressure of oxygen at higher altitudes.41,42 The same reason may account for the relatively lower intervals of RBC, haemoglobin and haematocrit in other countries at lower altitudes compared to those in this study,7,10,12,17,36 in contrast to higher intervals observed in a study conducted in Ethiopia at higher altitudes.13,43 On the other hand, we observed relatively lower intervals of haemoglobin and haematocrit in this study compared to those reported in the United States (Table 5).5 This may be attributed to lower ferritin and transferrin saturation among Black participants.44 Besides, our study showed a significantly higher mean cell haemoglobin concentration in men than in women, which had also been reported in previous work in Ethiopia.12
The median total WBC for men was lower than that for women, and the difference was statistically significant. This may be attributed to the significant difference in the immune system of men and women, associated with the presence of sex hormone receptors on the immune cells. These make women generally more prone to autoimmunity, resulting in lower rates of infection and chronic inflammatory disease.45,46 Our findings are in concordance with those reported by Oloune et al. in Yaoundé, Cameroon,6 Bakrim et al. in Morocco,8 Tekkeşin et al. in Turkey14 and Mine et al. in Botswana.47
The significantly higher median platelet count in women compared to men is suggestive of variations in hormone type and concentrations in the different genders as well as the effect of erythropoietin released in response to menstrual blood loss and cross-stimulation of megakaryopoiesis.10,36 Our findings are consistent with other studies in Africa: Addai-Mensah et al. in Ghana,7 Bakrim et al. in Morocco,8 Mulu et al. in Ethiopia,13 Miri-Dashe et al. in Nigeria,36 Dosoo et al. in Ghana10 and Kibaya et al. in Kenya.17 However, platelet counts in this study were relatively higher than those of other African countries in contrast to higher counts reported in the United States (Table 5).5 This could be attributed to genetic factors, compounded by the increased consumption of platelets by Plasmodium spp. in malaria-endemic areas.48,49
Limitations
A limitation for this study was that we could not screen for malaria, helminthes or all types of abnormal haemoglobin (except for the AS and SS sickle cell genotypes), and our complete blood analyser could not differentiate the granulocytes into neutrophils, basophils and eosinophils. Also, subclinical conditions which could affect blood parameters were not discernable during sample collection. Furthermore, ethnic and cultural differences that may influence diet and nutritional practices could have affected the outcome of our haematological intervals. We could not control for potential selection bias for some people who visited Bamenda and donated blood.
Recommendations
We recommend that locally generated haematological values should be used as reference intervals in our locality and that each region in Cameroon should determine their haematological reference intervals as recommended by the Clinical Laboratory Standards Institute.21
Conclusion
The haematological reference intervals established in this study are comparable to those obtained in Yaoundé, Cameroon and other studies within and outside of Africa. Any differences in values may be due to differences in latitudes of the localities, race and diet. We propose that the present established haematological reference intervals in this study should be used for clinical management of patients and interpretation of laboratory data for research in Bamenda.
Acknowledgements
We acknowledge all the participants of this study for voluntarily giving their blood for the establishment of haematological reference intervals for the Bamenda community. Thanks to the Centre for Disease Control and Prevention (CDC), Cameroon, and the Global Health System Solutions, Limbe, for their technical support, the management of the Department of Health Economics, Policy and Management, and the faculty of Health and Medical Science of the Catholic University of Cameroon-Bamenda for academic support during this study. Lastly, we appreciate the staff and management of the Bamenda Regional Hospital Laboratory and the Blood Bank for their wonderful support during the study.
Competing interests
The authors have declared that no competing interests exist.
Authors' contributions
V.N.F. (study leader) was responsible for the conceptualisation of the study, study design, supervision (of the experiments, specimen collection, testing, data collection), statistical analysis and final writing. C.N.A. and R.M.F. were responsible for the conceptualisation of the study and statistical analysis. V.N.F., P.L.E. and W.A.N. were responsible for performing the experiments, specimen collection, specimen testing and data collection. B.R. was responsible for providing technical equipment maintenance services. T.M., R.M.F., C.N.A., R.E-T., P.N., B.R., J.S., E.P.E., A.E., R.L, A.L. and D.N. were responsible to help shape the research, adding literature search and critical review of the manuscript.
Sources of support
This research received no specific grant from any funding agency in the public, commercial, or not-for-profit sectors.
Data availability statement
Data sharing does not apply to this article as no new data were created or analysed in this study.
Disclaimer
The views and opinions expressed in this article are those of the authors and do not necessarily reflect the official policy or position of any affiliated agency of the authors.
References
1.Jameson JL, Weetman AP, Fausi A, et al. Harrison's principles of internal medicine. New York: McGraw-Hill Education, 2005. [ Links ]
2.Lewis SM, Bain BJ, Bates I, et al. Dacie and Lewis practical haematology. E-book. Elsevier Health Sciences; 2006. [ Links ]
3.Koram K, Addae M, Ocran J, et al. Population based reference intervals for common blood haematological and biochemical parameters in the Akuapem north district. Ghana Med J. 2007;41(4): 160-166. https://doi.org/10.4314/gmj.v41i4.55284 [ Links ]
4.Giorno R, Clifford JH, Beverly S, et al. Hematology reference values analysis by different statistical technics and variations with age and sex. Am J Clin Pathol. 1980;74(6):765-770. https://doi.org/10.1093/ajcp/74.6.765 [ Links ]
5.Kratz A, Ferraro M, Sluss PM, et al. Normal reference laboratory values. N Engl J Med. 2004;351(15):1548-1563. https://doi.org/10.1056/NEJMcpc049016 [ Links ]
6.Oloume ME, Mouliom A, Melingui BF, et al. Haematological values in a healthy adult population in Yaoundé, Cameroon. Afr J Lab Med. 2019;8(1):a852. https://doi.org/10.4102/ajlm.v8i1.852 [ Links ]
7.Addai-Mensah O, Gyamfi D, Duneeh RV, et al. Determination of haematological reference ranges in healthy adults in three regions in Ghana. BioMed Res Int. 2019;2019:1-6. https://doi.org/10.1155/2019/7467512 [ Links ]
8.Bakrim S, Motiaa Y, Benajiba M, et al. Establishment of the hematology reference intervals in a healthy population of adults in the Northwest of Morocco (Tangier-Tetouan region). Pan Afr Med J. 2018;29(1):1-18. https://doi.org/10.11604/pamj.2018.29.169.13042 [ Links ]
9.Kueviakoe IM, Segbena AY, Jouault H, et al. Hematological reference values for healthy adults in Togo. ISRN Hematol. 2010;2011:1-5. https://doi.org/10.5402/2011/736062 [ Links ]
10.Dosoo DK, Kayan K, Adu-Gyasi D, et al. Haematological and biochemical reference values for healthy adults in the middle belt of Ghana. PLoS One. 2012;7(4):1-9. https://doi.org/10.1371/journal.pone.0036308 [ Links ]
11.Ramezani A, Shams M, Zarinfar N, et al. Hematological reference values for healthy males in the central part of Iran. Iran J Pathol. 2014;9(1):50-55. [ Links ]
12.Yalew A, Terefe B, Alem M, et al. Hematological reference intervals determination in adults at Gondar university hospital, Northwest Ethiopia. BMC Res Notes. 2016;9(1):483. https://doi.org/10.1186/s13104-016-2288-8 [ Links ]
13.Mulu W, Abera B, Mekonnen Z, et al. Haematological and CD4+ T cells reference ranges in healthy adult populations in Gojjam zones in Amhara region, Ethiopia. PLoS One. 2017;12(7):1-13. [ Links ]
14.Tekkeşin N, Bekoz H, Tukenmez F. The largest reference range study for hematological parameters from Turkey: A case control study. J Clin Exp Investig. 2014;5(4):548-552. [ Links ]
15.Troussard X, Vol S, Cornet E, et al. Étude des valeurs normales de l'hémogramme chez l'adulte: Un besoin pour une meilleure interprétation et pour l'accréditation du laboratoire. Ann Biol Clin. 2014;72(5):61-81. [ Links ]
16.Buchanan AM, Muro FJ, Gratz J, et al. Establishment of haematological and immunological reference values for healthy Tanzanian children in Kilimanjaro Region. Trop Med Int Health. 2010;15(9):1011-1021. https://doi.org/10.1111/j.1365-3156.2010.02585.x [ Links ]
17.Kibaya RS, Bautista CT, Sawe FK, et al. Reference ranges for the clinical laboratory derived from a rural population in Kericho, Kenya. PLoS One. 2008;3(10):1-7. [ Links ]
18.Lawrie D, Coetzee LM, Becker P, et al. Local reference ranges for full blood count and CD4 lymphocyte count testing. S Afr Med J. 2009;99(4): 243-248. [ Links ]
19.Otahbachi M, Simoni J, Simoni G, et al. Gender differences in platelet aggregation in healthy individuals. J Thromb Thrombolysis. 2010;30(2):184-191. https://doi.org/10.1007/s11239-009-0436-x [ Links ]
20.Menard D, Mandeng MJ, Tothy MB, et al. Immunohematological reference ranges for adults from the Central African Republic. Clin Diagn Lab Immunol. 2003;10(3):443-445. [ Links ]
21.Karita E, Ketter N, Price MA, et al. CLSI-derived hematology and biochemistry reference intervals for healthy adults in eastern and southern Africa. PLoS One. 2009;4(2):1-14. [ Links ]
22.Segbena AY, Prehu C, Wajcman H, et al. Hemoglobins in Togolese newborns: Hb S, Hb C, Hb Bart's, and α-Globin gene status. Am J Hematol. 1998;59(3):208-213. https://doi.org/10.1002/(SICI)1096-8652(199811)59:3<208::AID-AJH5>3.0.CO;2-R [ Links ]
23.Appold K. Determining laboratory reference intervals: CLSI guideline makes the task manageable. Lab Med. 2009;40(2):75-76. [ Links ]
24.Alemnji G, Mbuagbaw J, Folefac E, et al. Reference physiological ranges for serum biochemical parameters among healthy Cameroonians to support HIV vaccine and related clinical trials. Afr J Health Sci. 2010;17(3&4):75-82. [ Links ]
25.Ngo-Matip M-E, Pieme CA, Azabji-Kenfack M, et al. Impact of daily supplementation of Spirulina platensis on the immune system of naïve HIV-1 patients in Cameroon: A 12-months single blind, randomized, multicenter trial. Nutr J. 2015;14(1):70. https://doi.org/10.1186/s12937-015-0058-4 [ Links ]
26.Sumbele IUN, Kimbi HK, Ndamukong-Nyanga JL, et al. Malarial anaemia and anaemia severity in apparently healthy primary school children in urban and rural settings in the Mount Cameroon area: Cross sectional survey. PLoS One. 2015;10(4):1-17. [ Links ]
27.Nkuo Akenji T, Ntonifor N, Ching J, et al. Evaluating a malaria intervention strategy using knowledge, practices and coverage surveys in rural Bolifamba, southwest Cameroon. Trans R Soc Trop Med Hyg. 2005;99(5):325-332. [ Links ]
28.Kometa SS, Akoh NR. The Hydro-geomorphological implications of urbanisation in Bamenda, Cameroon. J Sustain Dev. 2012;5(6):64-73. https://doi.org/10.5539/jsd.v5n6p64 [ Links ]
29.Chi A. Human interference and environmental instability: Addresing the environmental consequences of rapid urban growth in Bamenda, Cameroon. Environ Urban. 1998;10(2):161-173. https://doi.org/10.1630/095624798101284527 [ Links ]
30.Review WP. Cameroon population 2020. c2019 [cited 2020 Mar 13]. Available from: https://worldpopulationreview.com/countries/cameroon-population/ [ Links ]
31.Immanuel J. Lack of basic services in the tourism industry: A study of stakeholders' perspectives in Bamenda, Cameroons. c2019 [cited 2020 August 10]. Available from: https://www.diva-portal.org/smash/get/diva2:1337743/FULLTEXT01.pdf [ Links ]
32.Asongwe GA, Yerima BP, Tening AS. Vegetable production and the livelihood of farmers in Bamenda Municipality, Cameroon. Int J Curr Microbiol App Sci. 2014;3(12):682-700. [ Links ]
33.SANAS. 2017 [cited 2020 Mar 13]. Available from: https://www.sanas.co.za/Pages/index.aspx [ Links ]
34.Nchinda E, Tagny C, Mbanya D. Blood donor haemovigilance in Yaoundé, Cameroon. Transfus Med. 2012;22(4):257-261. https://doi.org/10.1111/j.1365-3148.2012.01161.x [ Links ]
35.NACC. National guildeline on the prevention and mangement of HIV in Cameroom [homepage on the Internet]. c2015 [cited 2020 Mar 13]. Available from: https://aidsfree.usaid.gov/sites/default/files/cameroon_art_2015.pdf [ Links ]
36.Miri-Dashe T, Osawe S, Tokdung M, et al. Comprehensive reference ranges for hematology and clinical chemistry laboratory parameters derived from normal Nigerian adults. PLoS One. 2014;9(5):1-10. https://doi.org/10.1371/journal.pone.0093919 [ Links ]
37.Bros B, Leblanc T, Barbier-Bouvet B, et al. Lecture critique de l'hémogramme: valeurs seuils à reconnaître comme probablement pathologiques et principales variations non pathologiques. National Agency of Accreditation and Evaluation of Health (ANAES). September 1997. [ Links ]
38.Awad KM, Bashir AA, Osman AA, et al. Reference values for hemoglobin and red blood cells indices in Sudanese in Khartoum State. International Journal of Health Sciences and Research. 2019;9(1):210-214. [ Links ]
39.Tchamba A, Nzeukou A, Tené R, et al. Building potentials of stabilized earth blocks in Yaounde and Douala (Cameroon). Int J Civil Eng Res. 2012;3(1):1-14. [ Links ]
40.Ngon GN, Yongue-Fouateu R, Bitom D, et al. A geological study of clayey laterite and clayey hydromorphic material of the region of Yaoundé (Cameroon): A prerequisite for local material promotion. J Afr Earth Sci. 2009;55(1-2):69-78. https://doi.org/10.1016/j.jafrearsci.2008.12.008 [ Links ]
41.Windsor JS, Rodway GW. Heights and haematology: The story of haemoglobin at altitude. Postgraduate Med J. 2007;83(977):148-151. [ Links ]
42.Whitacre CC. Sex differences in autoimmune disease. Nat Immunol. 2001;2(9):777-780. https://doi.org/10.1038/ni0901-777 [ Links ]
43.Scheinfeldt LB, Soi S, Thompson S, Ranciaro A, et al. Genetic adaptation to high altitude in the Ethiopian highlands. Genome Biol. 2012;13(1):R1. [ Links ]
44.El-Hazmi MA, Warsy AS. Normal reference values for hematological parameters, red cell indices, HB A2 and HB F from early childhood through adolescence in Saudis. Ann Saudi Med. 2001;21(3-4):165-169. [ Links ]
45.Bupp MRG. Sex, the aging immune system, and chronic disease. Cell Immunol. 2015;294(2):102-110. https://doi.org/10.1016/j.cellimm.2015.02.002 [ Links ]
46.Bhatia A, Sekhon HK, Kaur G. Sex hormones and immune dimorphism. Sci World J. 2014;2014:1-9. [ Links ]
47.Mine M, Moyo S, Penny Stevens KM, et al. Immunohaematological reference values for HIV-negative healthy adults in Botswana. Afr J Lab Med. 2012;1(1):1-7. https://doi.org/10.4102/ajlm.v1i1.5 [ Links ]
48.Asare-Ntow K, Kuma G, Adjei R. Analysis of Malaria diagnosis and treatment data amongst pregnant women after the implementation of Test-Treat-Track policy, Brong Ahafo Region-2017. Int J Infect Dis. 2018;73:171-172. https://doi.org/10.1016/j.ijid.2018.04.3803 [ Links ]
49.Hoffbrand A, Moss P, Pettit J. Essential haematology, 2006. Volume 5. Malden MA: Blackwell Publishing, 2006; p. 249. [ Links ]
Correspondence:
Victor Fondoh
fondohv@yahoo.com
Received: 07 Apr. 2020
Accepted: 01 July 2020
Published: 21 Dec. 2020
ORIGINAL RESEARCH
Biochemical changes in whole blood stored for transfusion at Bungoma County Referral Hospital, Kenya
Phidelis M. MarabiI, II; Stanslaus MusyokiII; Angela AmayoIII
IDepartment of Health, Bungoma County Referral Hospital, Bungoma, Kenya
IISchool of Health Sciences, Kisii University, Kisii, Kenya
IIIDepartment of Human Pathology, Faculty of Health Sciences, University of Nairobi, Nairobi, Kenya
ABSTRACT
BACKGROUND: During storage, transfusion blood may undergo a series of biochemical changes that could pose risks to patients when used. It is important therefore to monitor biochemical changes that may reduce survival or function of stored blood cells.
OBJECTIVE: This study assessed biochemical changes in whole blood stored for transfusion at Bungoma County Referral Hospital in the western region of Kenya between February 2019 and August 2019.
METHODS: A prospective study design involving 20 randomly selected donor blood units in citrate phosphate dextrose adenine anticoagulant was employed. Biochemical changes were evaluated for 35 days. Potassium and sodium levels were tested using the HumaLyte Plus5 analyser. Blood pH level was estimated using the Hanna pH meter.
RESULTS: At the end of the 35 days of storage under blood bank conditions, the mean potassium level significantly increased from 7.31 mmol/L at baseline to 20.14 mmol/L at week 5 (p < 0.0001), and the mean sodium level significantly decreased from 150.72 mmol/L at baseline to 121.56 mmol/L at week 5 (p < 0.0001). The pH level decreased insignificantly from 7.48 at baseline to 7.38 at the end of week 1 (p = 0.0757) but decreased significantly to 6.15 at the end of week 5 (p < 0.0001).
CONCLUSION: Potassium increased and sodium concentrations decreased significantly from the first week of blood storage. The pH decreased significantly from the second week of storage. Therefore, aged blood should be avoided to circumvent potential adverse outcomes from biochemical changes and stored blood should be tested before use.
Keywords: blood; transfusion; biochemical changes; storage; Kenya.
Introduction
Biochemical variations take place during transfusion blood reservations, affecting their function.1 For many years, researchers have investigated the biochemical variations that take place in blood reserved before transfusions. More recently, clinical investigations have proposed that blood units reserved for extended periods (frequently detailed as 14-21 days) might be detrimental to the recipients, causing morbidity and mortality.2 Potassium is the prominent intracellular cation with sodium being the prominent extracellular cation. Maintenance of the circulation of potassium and sodium between the intracellular and the extracellular environments depends on a handful of homeostatic mechanisms. Literature discloses that potassium efflux, a renowned effect of prolonged red blood cell reservation, causes vesicle creation and may have a significant effect on the transfusion outcome.3 Studies have also shown a steady decrease in pH throughout the blood storage period which renders the cell membrane too rigid and predisposes the cells to lysis.4
Blood reservation improves access to blood for transfusions. However, questions arise regarding the toxicity and value of such blood reserved for extended periods. In various medical retrospective investigations, authors propose that transfusion of reserved blood may cause harm, particularly in severely ill patients such as patients with severe myocardial infarction conditions.2 They detected an elevated incidence of death, morbidity, infections, renal and lung breakdown, swelling, and thrombosis in patients who received extensively reserved blood compared to those who received fresh blood5; however, the causes of these remain unknown. These adverse effects may be attributed to the inability of red blood cells in reserved blood to transport oxygen as a result of the reduced concentration of adenosine triphosphate and 2, 3-diphosphoglycerate.4 Also, cytokines, enzymes, and ions such as potassium and calcium from white blood cells in stored blood may modify red blood cells and adversely affect transfused recipients. These modifications affect an assortment of membrane molecules involved with adhesion, oxygen delivery and complement modulation.6 The storage of blood for extended periods can potentially result in the manipulation of the membrane exterior of red blood cells, and consequently their biological functions.6
According to records of Bungoma County Referral Hospital in Bungoma, Kenya, the transfusion rate averages 300 transfusions monthly and there has been an increase in blood reactions in the patients that receive a blood transfusion. A monthly average of 2% - 3% of patients react to transfused blood, especially aged blood, which is blood that has been stored for over 20 days. Despite the high levels of post-reaction after transfusions in Bungoma County Referral Hospital and the risk of toxicity to patients due to leakage of blood chemicals, the biochemical changes in blood stored for transfusions have not been studied and remain unknown. Therefore, this study aimed to assess the biochemical changes in whole blood stored for transfusions at Bungoma County Referral Hospital.
Materials and methods
Ethical considerations
The study was cleared by the Ethical Committee of Jaramogi Oginga Teaching and Referral Hospital (#ERC.IB/VOL.1/454) and authority to carry out the research was issued by the National Commission for Science, Technology and Innovation (#NACOSTI/P/19/32125/27143). Written informed consent was obtained from each donor after a brief explanation of what the study is about. Participation in the study was voluntary. Donor details were kept confidential by the exclusion of all forms of identification on the data collection tool, and filled data tools were stored physically under lock and digitally with restricted password access on a computer. The donors were informed that their blood units, if selected for the study, were not transfused to patients.
Study area
The study was carried out between February 2019 and August 2019 at Bungoma County Referral Hospital, which is located in the western region of Kenya. This was a good study area because adverse reactions among the patients who receive a blood transfusion was common. The hospital also has an accredited laboratory that is well equipped with biochemistry equipment required for the study. The hospital has a blood donation centre which collects on average 600 blood units monthly.
Study design
This was a prospective study involving the collection of blood from healthy volunteers into blood bags containing citrate phosphate dextrose adenine anticoagulant. All donated blood samples were reserved at temperatures between 2 °C and 6 °C and analysed at baseline and then at the ends of week one, two, three, four and five. The whole units of blood were used in the study to ensure that all storage conditions for blood meant for transfusions were met.
Study population
The sample size for the research was determined by Yamane Taro's formulae for a finite population.7 A sample size of 20 blood units was adopted for the study. A simple random sampling technique was used in this study where every 10th sample was selected for the study in order to eliminate bias.
Data collection
Sample collection and analysis
All blood units were collected according to blood transfusion donor guidelines as described by the World Health Organization.8 At baseline, samples were immediately separated from blood units collected from the volunteer donors to test for potassium, podium and pH levels. Blood units were then stored at blood bank conditions of 2 °C - 6 °C for 35 days with intermittent sampling at 7-day intervals to test for potassium and sodium levels. Potassium and sodium levels were tested using a HumaLyte Plus5 analyser (Human Diagnostics Worldwide, Wiesbaden, Germany) while pH was estimated using a Hanna pH meter (Scientific Instrumentation, Woonsocket, Rhode Island, United States). Briefly, the plasma supernatant was aseptically transferred from blood units to plain test tubes and brought to the right temperature as per the manufacturer's instructions before being fed into the machine for automated analysis of potassium and sodium. The instrument measures the electrode potentials, and the data are processed by the microprocessor to obtain the concentration of a given ion. The normal range for potassium concentration is between 3.5 mmol/L and 5.5 mmol/L and between 145 mmol/L and 155 mmol/L for sodium concentration. Aliquots of the whole blood units were taken for pH determination at the study points using the automated Hanna pH meter, with results displayed on the screen. The normal range for blood pH is 7.35-7.45. All laboratory results were recorded on a standard data collection form developed for this study.
Quality assurance of the data
To ensure the quality of data collected, pre-donation requirements (such as ensuring that donors had a haemoglobin level of 12.5 g/dL and above, weighed 50 kg and above, had no transfusion in the past 12 months, had not donated blood in the past 3 months, had no history and signs of malignancy, had no signs and symptoms of sickle cell disease, had no signs and symptoms of polycythaemia Rubra Vera and had no history of haemophilia and other coagulation disorders) were followed and only blood units that met these criteria were used. A qualified phlebotomist collected the blood samples, ensuring that the right quantity of between 450 mL and 500 mL was collected. The pints were transported and stored as per blood transfusion guidelines at 2 °C - 6 °C. Sample aliquots at the various study points were brought to optimum temperature as per the manufacturer's instructions before testing. Samples were analysed in duplicate for each sample and an average computed to ensure accuracy. Both external and internal quality controls for pH, sodium and potassium tests were verified and ensured during the study. Recorded results were verified by a second analyst to ensure accuracy.
The laboratory is enrolled in the Human Quality Assessment Services External Quality Assurance Scheme for chemistry scope including pH, sodium and potassium. The chemistry scope is also accredited by the Kenya Accreditation Services which further assured the quality of data collected.
Data management and analysis
The data were stored in Microsoft Excel (Microsoft Corporation, Redmond, Washington, United States). Data analysis was done using the Statistical Package for the Social Sciences (SPSS V.23) (IBM Corporation, Chicago, Illinois, United States). Descriptive statistics (frequencies, mean and standard deviation) were used to describe the data. The trends of the biochemical changes were shown using line plots. Analysis of variance was used to establish if there were significant biochemical changes in transfusion blood at baseline and each study point compared to normal reference intervals for 35 days of storage. Findings were considered significant at a p-value less than 0.05. Tukey's honest significant difference test was used to collate all feasible pairs of means.
Results
Potassium (K+) levels increased progressively from 7.31 mmol/L to 20.14 mmol/L, while sodium (Na+) levels and pH respectively demonstrated corresponding decrease from 150.72 mmol/L to 121.56 mmol/L and from 7.48 to 6.15 as storage period progressed (Figure 1).

This study observed significant variance in potassium levels at baseline compared to the normal reference interval median of 4.5 mmol/L. Potassium levels also increased significantly throughout the blood storage period compared to the baseline mean of 7.31 mmol/L (Table 1). There was no significant variance in sodium concentrations at the baseline compared to the normal reference interval median of 150 mmol/L; however, a significant decrease in sodium concentration was observed throughout the blood storage period compared to the baseline. pH levels demonstrated no significant variance at baseline compared to the normal reference interval median of 7.4 and no significant variance at the end of week 1 (Day 7) compared to baseline. pH levels at weeks 2, 3, 4 and 5 however decreased significantly from 7.31 at baseline (Table 1).
Discussion
The current study sought to evaluate the biochemical changes in whole blood for transfusion stored at blood bank conditions. At the end of the 35 days of blood storage at blood bank conditions, the potassium levels significantly increased while sodium levels significantly decreased over time. On the other hand, the pH levels significantly decreased over time; however, the change was insignificant at week 2 of storage. Potassium levels had a significant variation from normal reference at the baseline while sodium concentrations and pH had insignificant variance from normal reference intervals. Regardless of the advantages of blood transfusion in clinical care (such as to treat anaemia, prepare patients for a surgical process, and limit manifestations of blood depletion), the procedure may cause harm to patients.9 There are various deleterious after-effects of blood transfusion that could occur despite cautious laboratory methods in handling and cross-matching the donors and the recipient. The undesired effects may be attributed to changes in the usual micro-environment or biochemistry of the blood cells in the course of blood storage.
The present study has found that there are biochemical variations in blood during the 35 days storage period. Potassium ions increased significantly after one week and further increased significantly through to 35 days of storage. This result compares with previous studies in Portugal,10 Uganda,9 India11 and Nigeria12 which demonstrated that potassium significantly increased throughout the storage period.
The current study observed an increase of plasma potassium level to 10.59 mmol/L within the first week. The increase continued to 20.14 mmol/L at the end of the fifth week which was equivalent to an average of 12.83 mmol/L rise after 35 days of storage. This indicates that blood transfusion after the first week of storage may not be safe for patients due to the potassium levels. In the course of blood reservations, there is a steady but continuous efflux of potassium ions from cells into the encircling plasma.12 During critical kidney disorder, even minute amounts of potassium ion variations are potentially threatening, and relatively fresh or washed red cells are recommended. Potassium ions efflux is recognised as a secondary metabolic change that occurs due to cooling.12 The rapid effusion of potassium ions from cells into encircling plasma possibly accounts for the radical elevation in potassium ion concentration in this study. Based on the findings of the present study, monitoring of potassium ion concentration during storage of blood for transfusion is recommended to improve blood safety.
The current study observed that a decrease in sodium levels was significant after 2 weeks (14 days) and further decreased significantly through to 35 days of storage. This result compares with previous studies in India, Portugal and Ghana which demonstrated that sodium levels decreased throughout the storage period.10,11,13 Our results, however, contrast a study done in India which demonstrated that sodium did not show any significant changes due to storage time14 as well as another study done in Nigeria in which reservation period was not established to influence sodium concentration.12
The reference range for plasma sodium level is 145 mmol/L - 155 mmol/L. The findings of this study indicate that within the first week of storage, sodium levels in blood could fall below the normal range. Blood stored at blood bank conditions slows down cellular metabolism and energy demand which permits blood to be reserved for 35-42 days. This makes the sodium-potassium pump defective and, as a result, permits potassium ions to depart the cell and sodium ions to move into the cells through the semipermeable membrane.10 Therefore, these significant changes may affect patients that may be affected by low levels of sodium such as an increased chance of such a recipient being prone to oedema especially in patients with low sodium intake or those experiencing diarrhoea.15 In light of the findings from the present study, monitoring of sodium ion concentration during storage of blood for transfusion with the goal to improve blood safety is recommended.
This study reported a significant pH decrease after 14 days of storage which further decreased significantly through to 35 days of storage. This result compares with previous studies in Uganda, India and Ghana which demonstrated that the pH of reserved blood lessened during the storage period.9,10 The reference range for blood pH is 7.35-7.45; this study reported a decrease in blood pH from 7.48 to 6.15 which was equivalent to an average drop of 1.33 after 35 days of storage. This indicates that the pH decreased far below the normal range by the end of 35 days. According to Oyet et al.,9 the increase in protons due to accumulation of lactate after 14 days of storage causes the pH level to decrease and subsequently changes glycolytic metabolism. The elevated lactate level with the reciprocal descent in pH exerts ravaging consequences on blood receivers, principally those who may be given several units of blood in a short period. This diminishes blood potency and predisposes blood receivers to undesired transfusion-associated morbidity and mortality.9 The depletion of diphosphoglycerate and diminished glycolytic action are also linked to lessening pH.12 This study recommends that transfusion of blood reserved for more than 1 week should be exercised with caution. Taking into account the findings from the present study, pH level monitoring during blood storage especially after the first week of storage with the focus on improving blood safety is recommended.
Overall, together with other parameters, biochemical changes in stored blood for blood transfusion should be properly monitored especially in consideration of the patient to be transfused. Because of the increase in potassium level with storage, caution is required to ascertain the storage duration of blood to be transfused, volume to be transfused at a time, and rate of transfusion to decrease hyperkalaemia-linked blood transfusion problems. Transfusing hyperkalaemic blood, however, may have little effect if the recipient's kidneys are working normally and the sodium-potassium adenosine triphosphate pump is also working efficiently. However, this is a significant concern in recipients with renal failure.
Recommendations
The study recommends the monitoring of biochemical changes and the use of fresh blood to avoid the negative effect of changes in stored blood especially to patients who suffer from renal failure and myocardial infarction.
Limitations
In the current study, other biochemical parameters such as iron, lactate, calcium, and so on, which could have an impact on the viability of blood were not assessed.
Conclusion
This study showed that variations in biochemical parameters occur during the storage of blood despite the use of adequate storage conditions, and may cause risks to patients during transfusion.
Acknowledgements
Mr Thomas Khisa Wekesa contributed by assisting in the donors' recruitment and blood donation. Ms Joan Wasike, Ms Beatrice Lungai, Mr Antony Sangolo and Ms Julia Wasike contributed by assisting in the running of the samples and the data collection.
Competing interests
The authors have declared that no competing interests exist.
Authors' contributions
All authors contributed equally to this work.
Sources of support
This research received no specific grant from any funding agency in the public, commercial or not-for-profit sectors.
Data availability statement
Data sharing is not applicable to this article as no new data were created or analysed in this study.
Disclaimer
The views and opinions expressed in this article are those of the authors and do not necessarily reflect the official policy or position of any affiliated agency of the authors.
References
1.Yalcin O, Ortiz D, Tsai AG, Johnson PC, Cabrales P. Microhemodynamic aberrations created by transfusion of stored blood. Transfusion. 2014;54(4):1015-1027. https://doi.org/10.1111/trf.12361 [ Links ]
2.Roback JD. Vascular effects of the red blood cell storage lesion. Hematology Am Soc Hematol Educ Program. 2011;2011:475-479. https://doi.org/10.1182/asheducation-2011.1.475 [ Links ]
3.Burger P, Kostova E, Bloem E, et al. Potassium leakage primes stored erythrocytes for phosphatidylserine exposure and shedding of pro-coagulant vesicles. Br J Haematol. 2013;160(3):377-386. https://doi.org/10.1111/bjh.12133 [ Links ]
4.D'Alessandro A, Gevi FZL. Red blood cell metabolism under prolonged anaerobic storage. Mol Biosyst. 2013;9(6):1196-1209. https://doi.org/10.1039/c3mb25575a [ Links ]
5.Hod EA, Spitalnik SL. Harmful effects of transfusion of older stored red blood cells: Iron and inflammation. Transfusion. 2011;51(4):881-885. https://doi.org/10.1111/j.1537-2995.2011.03096.x [ Links ]
6.Adams F, Bellairs G, Bird AR, Oguntibeju OO. Biochemical storage lesions occurring in nonirradiated and irradiated red blood cells. Biomed Res Int. 2015; 102015:968302. https://doi.org/10.1155/2015/968302 [ Links ]
7.Israel GD. Determining sample size. Fact Sheet PEOD-6. Orlando, FL: Florida Coop Extension Service; 1992. [ Links ]
8.World Health Organization. Blood donor selection: Guidelines on assessing donor suitability for blood donation. Geneva: WHO;2012. Available from https://apps.who.int/iris/handle/10665/76724 [ Links ]
9.Oyet C, Okongo B, Onyuthi RA, Muwanguzi E. Biochemical changes in stored donor units: Implications on the efficacy of blood transfusion. J Blood Med. 2018; 9:111-115. https://doi.org/10.2147/JBM.S163651 [ Links ]
10.Nogueira D, Rocha S, Abreu E, Costa E S-SA. Biochemical and cellular changes in leukocyte-depleted red blood cells stored for transfusion. Transfus Med Hemother. 2015;42(1):46-51. https://doi.org/10.1159/000370140 [ Links ]
11.Verma M, Dahiya K, Malik D, et al. Effect of blood storage on complete biochemistry. J Blood Disord Transfus. 2015;6:6. https://doi.org/10.4172/2155-9864.1000329 [ Links ]
12.Adias TC, Moore-Igwe B, Jermeiah ZA. Storage related haematological and biochemical changes of CPDA-1 whole blood in a resource limited setting. J Blood Disord Transfus. 2012;3(3):124. [ Links ]
13.Opoku-Okrah C, Acquah BK, Dogbe EE. Changes in potassium and sodium concentrations in stored blood. Pan Afr Med J. 2015;20:236. https://doi.org/10.11604/pamj.2015.20.236.5851 [ Links ]
14.Upadya UB, Seema H, Motakapalli K. Effect of blood storage on biochemical parameters assessed at periodic intervals in CPDA1 blood bags. J Clin diagnostic Res. 2018;12(10):EC05-EC07. https://doi.org/10.7860/JCDR/2018/37223.12139 [ Links ]
15.Metheny NM. Fluid and electrolyte balance: nursing considerations. 5th edn. Sudbury, MA: Jones & Bartlett Learning; 2012. [ Links ]
Correspondence:
Phidelis Marabi
phidelismaruti@yahoo.com
Received: 27 Jan. 2020
Accepted: 14 Oct. 2020
Published: 21 Dec. 2020
LESSONS FROM THE FIELD
Laboratory organisation and management of SARS-CoV-2 infection in Niger, West Africa
Abdourahamane YacoubaI, II; Adamou LagaréII, III; Daouada Alhousseini MaigaI, II; Halimatou Moumouni SamboII, IV; Sani OusmaneII, III; Zelika Hamidou HarounaII, V; Boubacar MarouI; Maman K. SanoussiII; Balki AoulaII; Ali AmadouII, VI; Hassane BoureimaII, VII; Saidou AmatagasII, VIII; Abdoulaye OusmaneIX; Eric AdehossiI, X; Saidou MamadouI, X
IFaculté des Sciences de la Santé, Université Abdou Moumouni, Niamey, Niger
IILaboratory Team COVID-19, Niamey, Niger
IIICentre de Recherche Médicale et Sanitaire, Niamey, Niger
IVDirection des Laboratoires de Santé, Ministère de la Santé Publique, Niamey, Niger
VHôpital National Amirou Boubacar Diallo, Niamey, Niger
VIHôpital de l'Amitié Niger-Turquie, Niamey, Niger
VIIHôpital Général de Référence de Maradi, Maradi, Niger
VIIIHôpital National de Zinder, Zinder, Niger
IXFaculté des Sciences de la Santé, Université Dan Dicko Dankoulodo de Maradi, Maradi, Niger
XCOVID-19 Experts Group, Niamey, Niger
ABSTRACT
BACKGROUND: As the coronavirus disease 2019 (COVID-19) pandemic unfolds, laboratory services have been identified as key to its containment. This article outlines the laboratory organisation and management and control interventions in Niger.
INTERVENTION: The capitol city of Niger, Niamey, adopted a 'National COVID-19 Emergency Preparedness and Response Plan' to strengthen the preparedness of the country for the detection of severe acute respiratory syndrome coronavirus-2. Laboratory training and diagnostic capacity building were supported by existing active clinical and research laboratories for more rapid and practicable responses. The National Reference Laboratory for Respiratory Viruses located at the Centre de Recherche Médicale et Sanitaire was designated as the reference centre for COVID-19 testing. The national plan for COVID-19 testing is being gradually adopted in other regions of the country in response to the rapidly evolving COVID-19 emergency and to ensure a more rapid turn-around time.
LESSONS LEARNT: After the decentralisation of COVID-19 testing to other regions of the country, turn-around times were reduced from 48-72 h to 12-24 h. Reducing turn-around times allowed Niger to reduce the length of patients' stays in hospitals and isolation facilities. Shortages in testing capacity must be anticipated and addressed. In an effort to reduce risk of shortages and increase availability of reagents and consumables, Niamey diversified real-time reverse transcriptase-polymerase chain reaction kits for severe acute respiratory syndrome coronavirus-2 detection.
RECOMMENDATIONS: Continued investment in training programmes and laboratory strategy is needed in order to strengthen Niger's laboratory capacity against the outbreak.
Keywords: severe acute respiratory syndrome coronavirus-2; SARS-CoV-2; coronavirus disease 2019; COVID-19; laboratory diagnosis; West Africa; Niger.
Background
In December 2019, a new viral respiratory infection emerged. The infection was first detected and reported in the Chinese province of Hubei and has since spread globally, affecting people and socio-economic development in both developing and developed countries. The disease, later named the coronavirus disease 2019 (COVID-19) and declared a global pandemic by the World Health Organization, is caused by a species of coronavirus known as severe acute respiratory syndrome coronavirus-2 (SARS-CoV-2), which belongs to the family Coronaviridae and the genus Betacoronavirus.1,2,3 Worldwide, real-time reverse transcriptase-polymerase chain reaction (rRT-PCR) is the gold standard method used to detect the presence of SARS-CoV-2 RNA in clinical specimens.
As of 15 June 2020, 175 503 laboratory-confirmed COVID-19 cases were reported in Africa, with 4111 deaths.4 These figures make Africa the continent least affected by this pandemic, with the most significantly affected countries in the region being South Africa (70 038 cases), Nigeria (16 085 cases), Ghana (11 422 cases), and Algeria (10 919 cases).4
The index case in the Republic of Niger was detected on 19 March 2020. This was an imported case involving a 36-year old man who arrived by road from Burkina Faso. Since the official declaration of the index case, a total of 980 cases have been confirmed as of 15 June 2020.5
As this pandemic unfolds, laboratory services have been identified as key to containment efforts. This article outlines the laboratory organisation and management and control interventions in Niger.
Description of the intervention
Ethical consideration
This article followed all ethical standards for research without direct contact with human or animal subjects.
Organisational response
Severe acute respiratory syndrome coronavirus-2 is an emerging respiratory pathogen spreading rapidly through the general population. Niamey, the capitol city of Niger, adopted the 'National COVID-19 Emergency Preparedness and Response Plan' (available from https://tinyurl.com/y2x3vpmt) to strengthen Niger's preparedness for the detection of SARS-CoV-2. This plan details the procedures for containment, contact tracing and screening based on the risk of spread. The plan is structured around five major strategic axes including reinforcement of coordination, strengthening of epidemiological surveillance, strengthening of health services capacities, reinforcement of risk communication and community engagement, and, lastly, the creation of isolation facilities.
Eight committees have been set up to implement the National COVID-19 Emergency Preparedness and Response Plan, one of which is the Laboratory and Research Team. The National COVID-19 Emergency Preparedness and Response Plan provides $16 484 884.48 (United States dollars) to enable expedited building and implementation of SARS-CoV-2 testing capacity in the eight regions of the country in tune with the expansion of the pandemic. The Laboratory and Research Team, which is charged with the responsibility of improving laboratory capacity and capability, is structured into three groups comprising a pre-analytical group (sample collection, inactivation, identification numbers), an analytical group (rRT-PCR testing) and a post-analytical group (validation and reporting test results).
For more rapid and practicable responses, laboratory diagnostic capacity building is being supported by existing active clinical and research laboratories. The National Reference Laboratory for Respiratory Viruses located at the Centre de Recherche Médicale et Sanitaire (CERMES) was designated as the reference centre for COVID-19 testing. The Veterinary Research Laboratory 'Laboratoire Central de l'Elevage', the National Reference Laboratory for HIV and Tuberculosis, the National Hospital of Niamey and the Research Institute for Sustainable Development supported the laboratory response by providing equipment for PCR techniques. Moreover, seven laboratory technicians from these centres, who have had extensive training on PCR techniques, were mobilised by the Ministry of Health, in addition to the CERMES technicians, to support the response by performing the rRT-PCR testing at CERMES, which received and analysed samples collected from across the country. As part of COVID-19 response, Niamey and its partners provided logistical air support for sample transport from remote regions such as Diffa, Zinder, Maradi, Tahoua and Agadez.
Gradually, the national plan on COVID-19 testing is being adopted in other regions of the country in response to the rapidly evolving COVID-19 emergency and to ensure a more rapid turn-around time (TAT). This adoption involves gradual decentralisation of the SARS-CoV-2 RNA rRT-PCR assays to three regions, Tahoua, Maradi and Zinder, located 550, 662 and 891 kilometres from Niamey (Figure 1). The choice of these regions was based on several factors, including the distance from the capital city, the number of close contacts in these regions, the number of confirmed cases at the time of the decentralisation and the capacity of the laboratory facilities on site.
The Tahoua laboratory analysed samples collected from the Tahoua and Agadez regions. Samples collected from the Zinder and Diffa regions were analysed in Zinder, whereas the Maradi laboratory analysed samples collected in the Maradi region. Samples collected from the Niamey, Dosso and Tillabery regions were analysed at CERMES. Logistics and testing capacity are handled by CERMES, which reported the availability of the reagents and materials needed to sample patients and to perform the rRT-PCR on a weekly basis to the Ministry of Health.
Laboratory diagnosis
Severe acute respiratory syndrome coronavirus-2 is classified as a Risk Group 3 human pathogen, similar to Middle East respiratory syndrome coronavirus and severe acute respiratory syndrome coronavirus.6 The interim guidance from the World Health Organization suggests that non-propagative processing and handling of specimens containing SARS-CoV-2 must be performed in standard biosafety level-2 laboratories.7,8 Consequently, Niamey leveraged the safe practices and techniques, safety equipment and appropriate facility design of CERMES to reduce or eliminate exposure of laboratory workers to SARS-CoV-2-containing materials according to the World Health Organization requirements.7 Before the decentralisation of SARS-CoV-2 RNA rRT-PCR assays to other regions, samples collected from across the country were sent to CERMES. Samples from remote regions such as Diffa, Zinder and Agadez were transported using flights in accordance with category B transportation regulations.9 In an effort to help close contact management, sample collection was performed during home visits.
Ribonucleic acid extraction from samples was performed manually using QIAamp® Viral RNA Mini Kit (250) (QIAGEN GmbH, Hilden, Germany) or Nucleic Acid Isolation or Purification Reagent (DaAn Gene Co., Ltd, Guangzhou, China) according to the manufacturer's instructions. Two teams of four laboratory technicians were dedicated to RNA extraction at CERMES. These teams were often overworked due to the large volume of samples handled.
Qualitative rRT-PCR assays were performed using the nucleic acid testing kit (DaAn Gene Co., Ltd, Guangzhou, China).10 Two target genes, the open reading frame1ab (ORF1ab) and nucleocapsid protein (N), were simultaneously amplified. A cycle threshold value lower than 40 was defined as a positive test result, and a cycle threshold value of 40 or more was defined as a negative outcome according to the manufacturer's protocol. Alternatively, rRT-PCR targeting the RdRp gene of the SARS-CoV-2 or SARS-like coronavirus was performed using the LightMix® Modular SARS-CoV-2 RdRp (TIB Molbiol, Berlin, Germany). Positive samples for RdRp gene were confirmed by performance of rRT-PCR for the detection of the E gene using LightMix® SarbecoV E gene plus equine arteritis virus control (TIB Molbiol, Berlin, Germany). Given the extraordinary demand for reagents and consumables, risk of supply shortages became the main issue. Niamey experienced a shortage of RNA extraction kits and this led to the prioritisation of the testing of vulnerable people, health professionals and patients requiring hospitalisation.
As of 15 June 2020, a total of 5386 samples had been tested for SARS-CoV-2 in Niger. Of these, 980 (18.2%) were confirmed positive (Figure 2). All test results, positive or negative, were immediately reported to the national committee, which is responsible for communication on the pandemic. The highest number of new daily confirmed cases (68 cases) was detected on 11 April 2020.
In March and April 2020, before the decentralisation of SARS-CoV-2 RNA rRT-PCR assays to other regions, the number of samples received exceeded the capacity of the single centralised laboratory earmarked for the testing. Consequently, TATs were between 48 h and 72 h. This TAT length often created a disconnect between clinicians and laboratory staff. Indeed, according to the clinicians, the TAT of 48-72 h delayed treatment and increased patients' length of stay, particularly in isolation facilities where patients are often asymptomatic. After decentralisation, on 15 June, 2020, the TAT had decreased significantly to 12 h at Maradi and between 12 h and 24 h at Tahoua, Zinder and CERMES, Niamey.
Lessons learnt
Experience gained in the management of previous outbreaks (Rift Valley Fever and meningitis) helped Niamey to build a quick response to the COVID-19 pandemic. However, additional control efforts are needed to improve the laboratory strategy and response against COVID-19 in the country. Firstly, a well-coordinated laboratory strategy and operational plan is needed in order to address the shortcomings of the existing plan. Moreover, considering the importance of improved SARS-CoV-2 laboratory capacity, the country should provide extensive training to laboratory technicians in preparation for rapid expansion of laboratory diagnostic capacity. Secondly, laboratory TAT is critical in determining the success of both the laboratory response programme and the management of patients. Reducing the TAT allowed reductions in patients' length of stay in hospitals and isolation facilities. Thirdly, communication between clinical and laboratory staff needs to be improved in order to ensure that laboratory results are understandable to clinicians.
Fourthly, the shortages in testing capacity need to be anticipated and addressed. If capacity is exceeded, priority should be given to the testing of vulnerable patients, health professionals and patients requiring hospitalisation. Niamey diversified rRT-PCR kits for SARS-CoV-2 detection to reduce the risk of shortages and increase the availability of reagents. It has been demonstrated that RNA extraction kits from different manufacturers are interchangeable.11
However, diversifying the type of rRT-PCR kits for SARS-CoV-2 detection can lead to some variation in the detection rate between kits.12 It has been well documented that the limit of detection of different rRT-PCR kits can differ substantially.13,14 Therefore, care must be taken in the interpretation of the results when using different kits for the monitoring of patients. Fifthly, the overwhelming number of specimens to test highlighted the need for fast methods to extract viral RNA. Ribonucleic acid extraction from samples was performed manually in Niger. In addition to the high risk of contamination, manual extraction of viral RNA is time consuming and requires a large number of laboratory professionals.
Lastly, amplification of multiple target genes (e.g. N, E, RpRd genes) could be used to avoid invalid results and increase sensitivity for detection of new genomic variants.15,16
Recommendations
Despite TAT improvement in the laboratory management of COVID-19 testing, several additional control efforts are needed to improve the laboratory response against COVID-19 in Niger. Considering the importance of improved SARS-CoV-2 laboratory capacity, continued investment in training programmes and laboratory strategy is needed to systematically guide the laboratory response against the outbreak.
Acknowledgements
Authors would like to acknowledge the contributions of the National COVID-19 Emergency Preparedness and Response Committee for the technical, resource and logistical contributions, the government of Niger, the Ministry of Health and all its partners for the good support that formed the basis of a favourable working environment for the response against COVID-19 pandemic in Niger. We would also like to thank Dr Ahmed Olowo-Okere of Usmanu Danfodiyo University, Sokoto-Nigeria, for language editing.
Competing interests
The authors have declared that no competing interests exist.
Authors' contributions
A.Y. and S.M. conceived and designed the study. Data acquisition was done by A.L. The draft manuscript was written by A.Y., while B.M., D.A.M., H.M.S., H.B., S.O., E.A., S.M., M.K.S, Z.H.H., H.B., S.A., A.O., A.A. and B.A. critically reviewed the manuscript. All authors have read and agreed to the final version of this manuscript.
Sources of support
This research received no specific grant from any funding agency in the public, commercial or not-for-profit sectors.
Data availability statement
The data are available from the corresponding author upon reasonable request.
Disclaimer
The views and opinions expressed in this article are those of the authors and do not necessarily reflect the official policy or position of any affiliated agency of the authors.
References
1.BBC News. Coronavirus disease named Covid-19 [homepage on the Internet]. [cited 2020 May 31]. Available from: https://www.bbc.com/news/world-asia-china-51466362 [ Links ]
2.WHO Director-General's opening remarks at the media briefing on COVID-19 - 25 May 2020 [homepage on the Internet]. [cited 2020 May 31]. Available from: https://www.who.int/dg/speeches/detail/who-director-general-s-opening-remarks-at-the-media-briefing-on-covid-19---25-may-2020 [ Links ]
3.Gorbalenya AE, Baker SC, Baric RS, et al. The species severe acute respiratory syndrome-related coronavirus: Classifying 2019-nCoV and naming it SARS-CoV-2. Nat Microbiol. 2020;5(5):536-544. https://doi.org/10.1038/s41564-020-0695-z [ Links ]
4.World Health Organisation. Coronavirus disease (COVID-19) situation reports [homepage on the Internet]. [cited 2020 Jun 16]. Available from: https://www.who.int/emergencies/diseases/novel-coronavirus-2019/situation-reports [ Links ]
5.Coronavirus: Le Niger enregistre son premier cas. sikafinance.com [homepage on the Internet]. [cited 2020 Aug 09]. Available from: https://www.sikafinance.com/marches/coronavirus-le-niger-enregistre-son-premier-cas_21336 [ Links ]
6.Iwen PC, Stiles KL, Pentella MA. Safety considerations in the laboratory testing of specimens suspected or known to contain the Severe Acute Respiratory Syndrome Coronavirus 2 (SARS-CoV-2). Am J Clin Pathol. 2020 Apr 15;153(5):567-570. https://doi.org/10.1093/ajcp/aqaa047 [ Links ]
7.World Health Organisation. Laboratory testing for coronavirus disease 2019 (COVID-19) in suspected human cases: Interim guidance, 2 March 2020 [homepage on the Internet]. World Health Organization; 2020. [cited 2020 Sep 05]. Available from: https://www.WHO/COVID-19/laboratory/2020.4 [ Links ]
8.World Health Organisation. Laboratory biosafety guidance related to the novel coronavirus (2019-nCoV) [homepage on the Internet]. World Health Organization; 2020 [cited 2020 Sep 18]. Available from: https://www.who.int/docs/default-source/coronaviruse/laboratory-biosafety-novel-coronavirus-version-1-1.pdf?sfvrsn=912a9847_2.%20Accessed%20March%207,%202020 [ Links ]
9.World Health Organisation. Guidance on regulations for the transport of infectious substances [homepage on the Internet]. [cited 2020 Sep 05]. Available from: https://www.who.int/csr/resources/publications/biosafety/WHO_CDS_CSR_LYO_2005_22r%20.pdf?ua=1 [ Links ]
10.World Health Organisation. WHO emergency use listing for in vitro diagnostics (IVDs) detecting SARS-CoV-2 nucleic acid [homepage on the Internet]. [cited 2020 Sep 18]. Available from: https://www.who.int/diagnostics_laboratory/200710_eul_sars_cov2_product_list.pdf?ua=1 [ Links ]
11.Lim KL, Johari NA, Wong ST, et al. A novel strategy for community screening of SARS-CoV-2 (COVID-19): Sample pooling method. PLoS One. 2020;15(8):e0238417. https://doi.org/10.1371/journal.pone.0238417 [ Links ]
12.Van Kasteren PB, Van der Veer B, Van den Brink S, et al. Comparison of seven commercial RT-PCR diagnostic kits for COVID-19. J Clin Virol. 2020 May 8;128:104412. https://doi.org/10.1016/j.jcv.2020.104412 [ Links ]
13.Hogan CA, Sahoo MK, Huang C, et al. Comparison of the panther fusion and a laboratory-developed test targeting the envelope gene for detection of SARS-CoV-2. J Clin Virol. 2020 Jun 1;127:104383. https://doi.org/10.1016/j.jcv.2020.104383 [ Links ]
14.Wang X, Yao H, Xu X, et al. Limits of detection of 6 approved RT-PCR kits for the novel SARS-coronavirus-2 (SARS-CoV-2). Clin Chem. 2020 Jul 1;66(7):977-979. https://doi.org/10.1093/clinchem/hvaa099 [ Links ]
15.Tahamtan A, Ardebili A. Real-time RT-PCR in COVID-19 detection: Issues affecting the results. Expert Rev Mol Diagn. 2020 May 3;20(5):453-454. https://doi.org/10.1080/14737159.2020.1757437 [ Links ]
16.Penarrubia AL, Ruiz M, Porco R, et al. Multiple assays in a real-time RT-PCR SARS-CoV-2 panel can mitigate the risk of loss of sensitivity by new genomic variants during the COVID-19 outbreak. Int J Infect Dis. 2020;97:225-229. https://doi.org/10.1016/j.ijid.2020.06.027 [ Links ]
Correspondence:
Abdourahamane Yacouba
abdourahamaneyacouba@yahoo.fr
Received: 20 June 2020
Accepted: 01 Oct. 2020
Published: 21 Dec. 2020
SCIENTIFIC LETTER
Inflammatory markers as predictors of mortality in COVID-19 infection
Awadia A. AhmeidiI; Ashraf MusaII; Hend S. AhmedIII; Adel A. ElahmarIV; Ryhana B. GootaV; Ibtihal A. AhmedVI; Abdelhakam H. AliVII; Mushal AllamVIII; Mozan O. HassanIII
IDepartment Hematology, Faculty of Medical Laboratory Science, University of Science and Technology, Khartoum, Sudan
IIAbeer Hospital, Muscat, Oman
IIIDepartment Hematology and Blood Transfusion, Faculty of Medical Laboratory Science, Omdurman Ahlia University, Khartoum, Sudan
IVCommunicable Disease Center, Harmad Medical Corporation, Doha, Qatar
VMinistry of Health, Khartoum, Sudan
VIFaculty of Medical Laboratory Science, Ibn Sina University, Khartoum, Sudan
VIIDepartment Microbiology, Faculty of Medical Laboratory Science, University of Al Butana, Rufaa, Sudan
VIIINational Institute for Communicable Diseases, National Health Laboratory Service, Johannesburg, South Africa
Since the origination of the severe acute respiratory syndrome coronavirus-2 (SARS-CoV-2) in China in December 2019 and its subsequent global spread, it became critical to understand the inflammatory process associated with this virus and the coronavirus disease 2019 (COVID-19) and to understand the changes associated with the different inflammatory parameters. The clinical presentation of COVID-19 cases varies greatly from mild symptoms among the majority of patients, to severe disease leading to death in some patients.
Many COVID-19 cases had increased levels of inflammatory cytokines and other infection-related biomarkers.1 The inflammatory markers, including interleukin-6, D-dimer, neutrophil-to-lymphocyte ratio and high-sensitivity C-reactive protein (hs-CRP) levels, were found to be indicative of severe COVID-19 in reports that emerged from China.2 However, their association with mortality among COVID-19 patients has not been reviewed. In this article, we identify inflammatory markers (interleukin-6, D-dimer, neutrophil-to-lymphocyte ratio and hs-CRP) as predictors of COVID-19 mortality. Laboratory tests for these markers are simple, cheap and available and can be performed in outbreak areas with limited resources.
According to Zhou et al., D-dimer levels exceeding 1.0 µg/mL at hospital admission correlated significantly with death among hospitalised COVID-19 patients in China, with a p-value of less than 0.001.3 Another study in Wuhan, China, which included 343 in-patients with confirmed COVID-19, showed that elevated D-dimer levels over 2 µg/mL at an early stage of hospitalisation correlated significantly with a high risk of death.4 Also, according to another study from China that included 1099 confirmed COVID-19 patients, results revealed that median D-dimer and C-reactive protein levels were higher among severe cases compared to non-severe cases, demonstrating that high D-dimer and C-reactive protein levels were significantly associated with COVID-19 severity.5 Additionally, in Wuhan Jinyintan Hospital, China, a study showed that high levels of interleukin-6 were significantly associated with a high mortality rate.6 This finding was corroborated by Silberstein in this study.7 Liu Y et al. in Zhongnan Hospital of Wuhan University identified an elevation in the neutrophil-to-lymphocyte ratio as an independent and significant predictor of mortality among 245 hospitalised COVID-19 patients, with an 8% increase in mortality with each unit increase in neutrophil-to-lymphocyte ratio.8
Many studies reported a correlation between high levels of hs-CRP and mortality rate in COVID-19 patients. A study done among 375 patients with confirmed SARS-CoV-2 infection revealed that elevated hs-CRP levels were significantly associated with a high mortality risk.9 In another study conducted to evaluate fatal outcomes among COVID-19 patients, 187 patients from China were included among whom 43 died, and results revealed that high levels of hs-CRP was significantly associated with mortality.10
We conclude that elevation in levels of these four inflammatory markers may be indicative of COVID-19 infection severity and mortality. We suggest that these parameters may be helpful predictors of COVID-19 severity and could be used as early predictors for case management before deterioration. On the other hand, these parameters cannot be used independently for initial diagnosis and physicians need to monitor the presence of other infections that may interfere with the elevation of these markers. Finally, we recommend that similar studies on inflammatory markers should be conducted in African populations to demonstrate the levels of these markers among African COVID-19 patients and their association with COVID-19 severity and mortality.
Acknowledgements
Competing interests
The authors have declared that no competing interests exist.
Authors' contributions
A.A.A., A.M., A.A.E. and I.A.A. developed the concepts and performed the literature search. M.O.H. and M.A. helped to supervise the project. A.H.A and R.B.G. edited the manuscript. A.A.A., A.H.A. and A.A.E. prepared and reviewed the manuscript. H.S.A. helped in writing the literature review. M.A. and M.O.H. were responsible for final approval of the version to be published.
Ethical considerations
This article followed all ethical standards for research without direct contact with human or animal subjects.
Sources of support
This research received no specific grant from any funding agency in the public, commercial or not-for-profit sectors.
Data availability statement
Data sharing is not applicable to this article as no new data were created or analysed in this study.
Disclaimer
The views and opinions expressed in this article are those of the authors and do not necessarily reflect the official policy or position of any affiliated agency of the authors.
References
1.Qin C, Zhou L, Hu Z, et al. Dysregulation of immune response in patients with COVID-19 in Wuhan, China. Clin Infect Dis. 2020;71(15):762-768. https://doi.org/10.1093/cid/ciaa248 [ Links ]
2.Chen N, Zhou M, Dong X, et al. Epidemiological and clinical characteristics of 99 cases of 2019 novel coronavirus pneumonia in Wuhan, China: A descriptive study. Lancet. 2020 Feb 15;395(10223):507-513. https://doi.org/10.1016/S0140-6736(20)30211-7 [ Links ]
3.Zhou F, Yu T, Du R, et al. Clinical course and risk factors for mortality of adult inpatients with COVID-19 in Wuhan, China: A retrospective cohort study. Lancet. 2020;395(10229):1054-1062. https://doi.org/10.1016/S0140-6736(20)30566-3 [ Links ]
4.Zhang L, Yan X, Fan Q, et al. D-dimer levels on admission to predict in hospital mortality in patients with Covid-19. J Thromb Haemost. 2020 Jun;18(6):1324-1329. https://doi.org/10.1111/jth.14859 [ Links ]
5.Guan WJ, Ni ZY, Hu Y, et al. Clinical characteristics of coronavirus disease 2019 in China. N Engl J Med. 2020 Apr 30;382(18):1708-1720. [ Links ]
6.Wu C, Chen X, Cai Y, et al. Risk factors associated with acute respiratory distress syndrome and death in patients with coronavirus disease 2019 pneumonia in Wuhan, China. JAMA Intern Med. 2020;180(7):934-943. https://doi.org/10.1001/jamainternmed.2020.0994 [ Links ]
7.Silberstein M. Correlation between premorbid IL-6 levels and COVID-19 mortality: Potential role for Vitamin D. Int Immunopharmacol. 2020 Nov;88:106995. https://doi.org/10.1016/j.intimp.2020.106995 [ Links ]
8.Liu Y, Du X, Chen J, et al. Neutrophil-to-lymphocyte ratio as an independent risk factor for mortality in hospitalized patients with COVID-19. J Infect. 2020;81(1):e6-e12. https://doi.org/10.1016/j.jinf.2020.04.002 [ Links ]
9.Yan L, Zhang HT, Goncalves J, et al. An interpretable mortality prediction model for COVID-19 patients. Nat Mach Intell. 2020;2(5):283-288. https://doi.org/10.1038/s42256-020-0180-7 [ Links ]
10.Guo T, Fan Y, Chen M, et al. Cardiovascular implications of fatal outcomes of patients with coronavirus disease 2019 (COVID-19). JAMA Cardiol. 2020;5(7):811-818. https://doi.org/10.1001/jamacardio.2020.1017 [ Links ]
Correspondence:
Mozan Hassan
oh.mozan@gmail.com
Received: 12 June 2020
Accepted: 07 Oct. 2020
Published: 21 Dec. 2020
BRIEF REPORT
Critical success factors for Vietnamese laboratories striving to implement quality management systems
Cathy RobinsonI; James JohnsonII; Katy YaoIII; Hien BuiIV
IInternational Consulting Services, Louisiana State University Alexandria, Alexandria, Louisiana, United States
IISchool of Health Sciences, Central Michigan University, Mount Pleasant, Michigan, United States
IIIDivision of Global HIV and TB Program, Centers for Disease Control and Prevention, Atlanta, Georgia, United States
IVCenters for Disease Control and Prevention, Hanoi, Vietnam
ABSTRACT
Accurate laboratory reporting is crucial to patient diagnosis and treatment. This study identified critical success factors (CSF) for implementing a laboratory quality management system (QMS). This descriptive research used qualitative and quantitative methods to collect and analyze data from laboratory managers and staff employed in Vietnamese hospital laboratories implementing a QMS. The top five CSFs identified were: (1) staff QMS knowledge, (2) manager leadership, (3) staff commitment, (4) mentorship, and (5) hospital administration support. Identifying CSFs is critical to successful planning and implementation of QMS.
Keywords: critical success factors; medical laboratories implementing QMSs; laboratories earning ISO 15189 accreditation; quality management system helps laboratories improve quality; accuracy; reliability of patient results.
Introduction
Medical laboratories provide critical services which are used by physicians to accurately diagnose, treat and monitor patient health. Grycotis, The Infectious Advisor, emphasises the value of laboratory test results to clinicians in making an accurate diagnosis and monitor treatment regimes.1 Equally important is the detrimental effect inaccurate results have including wrong diagnosis, wrong treatment, and patient death. Likewise, Nkengasong et al., emphasise that quality laboratory systems are needed to achieve the Millennial Development Goals for health and meet universal access for treatment of HIV/AIDS, tuberculosis and malaria.2
Similarly, the International Standardization Organization (ISO) 15189 accreditation is recognised as the gold standard for measuring laboratory quality globally.3 One pathway to attaining this accreditation is by implementing a quality management system (QMS). In addition to a QMS training programme, the World Health Organization developed a checklist entitled Stepwise Laboratory Quality Improvement Process Towards Accreditation to measure quality improvement within laboratories and provide continued recognition and motivation of staff to continue and sustain improvements.4 An international effort was fielded in developing countries to educate and train laboratory management and staff on improving the accuracy and reliability of laboratory results. QMS training is designed to teach participants how to identify deficiencies in their laboratories, design improvement projects to fill those gaps, and enact standard practices and processes into daily laboratory practices. Following the training, managers and staff return to their respective laboratories to begin improvement. Intermittent self-assessments serve to monitor the improvement process, show improvements and motivate to continue improvement. Several previous studies5,6,7 have evaluated the outcome of these training programmes on laboratory quality by comparing laboratory assessments before and after QMS implementation. While this is a good first step, quantitative statistics do not identify 'why' a particular standard was or was not met. Adding a qualitative component allows for the identification of 'why' QMS implementation assessment scores often showed wide variability.
In 1979, Rockart worked with executives in manufacturing organisations to develop a set of factors aimed to guide goal development which proved to significantly contribute to project success. Rockart referred to these factors as critical success factors (CSFs).8 The primary benefit CSFs offer any organisation is the ability to focus organisation efforts for project success. However, there is a noticeable lack of published literature identifying CSFs for success in implementing QMS projects in medical laboratories. This study aimed to identify CSFs for medical laboratories implementing a QMS project and 'why' a laboratory's score may or may not improve over time.
Methods
Ethical considerations
This research received approval from the Institutional Review Board at Central Michigan University. This activity was reviewed per the Centers for Disease Control and Prevention (CDC) human research protection procedures and determined to be a non-research, public health programme activity. The Vietnam Administration of Medical Services agreed to this study and wrote letter no. 1506/KCB-QLCL to each hospital granting data collection permission to the researcher. Written informed consent was obtained from all participants. Results were reported in aggregate form only.
Study participants
The Vietnam Administration for Medical Services assisted in selecting four laboratories (three city level and one district level, coded as H1-H4) based on their managers' and staffs' willingness to share their experiences while implementing a QMS project. Each laboratory reported their various stages of implementation at the time of the study (Table 1). Shi's9 convenience sampling process was utilised to randomly select participants from each of the laboratories. Participants included laboratory managers and staff; participation was voluntary. Eleven participants from each lab (N = 44) completed the demographic survey and interview questions.

Study design
The study was descriptive and employed a mixed design utilising qualitative and quantitative methods. Qualitative data were collected from staff employed in the study's laboratories currently implementing a QMS project. Qualitative data collected from responses to the semi-structured interview provided participant insight to answer 'why' their laboratory scores did or did not improve over time. During the interview, participants were asked to list the top five factors they felt were most important in meeting QMS project goals and improving scores. For added clarity, each was asked to define the factors they listed.
A quantitative demographic survey was used to gather participant data such as age, gender and education levels.
With no previous CSF studies found related to QMS projects and medical laboratories, QMS experts from three countries outside of Vietnam served as benchmark panellists.
Benchmark panel of laboratory quality management system experts
To validate this study's findings, a panel of three experts from Kenya, Tanzania and Ukraine agreed to serve as benchmark experts and review the Vietnam study findings. Each was a practising medical laboratory scientist experienced in the subject matter, that is, laboratory quality in resource-limited countries, QMS, training and Stepwise Laboratory Quality Improvement Process Towards Accreditation checklist. The expert panellists endorsed the QMS implementation methods used in the Vietnamese study as those similarly used in their respective countries.
Statistical analysis
The researchers used content analysis10 to review and sort all responses (220 listed factors) into exhaustive and mutually exclusive categories. Ten categories were identified. After identifying the content categories, the researcher and assistants sorted each of the factors into one of the content categories. Cohen's Kappa statistic was used to measure inter-coder reliability between the researchers. This statistic provides a quantitative measure of reliability for two or more raters coding or sorting the same thing, corrected for how often the raters may agree by chance.
Applying frequency percentages, the top five categories were identified (Table 2). Though not the aim of the study, barriers were also identified using the same frequency percentage calculations. To look for bias between participants' interview responses and demographic survey results, the chi-square test was applied. The same statistical analyses were applied to the data collected from the three expert panellists.

Results and discussion
Applying Cohen's Kappa statistic, reliability values were greater than 0.85, indicating excellent reliability between the researchers in coding and sorting the CSFs.11 Likewise, the chi-square test found no relevant bias between the demographic responses and the factors listed by the participants.
Five top CSFs were identified from the Vietnamese participants' responses via content analysis by the researchers.12 The strength of this study lies in the close alignment of the identified top five CSFs by the researchers and the expert panel after the analysis of participants' responses. The top five success factors identified from the Vietnamese study and the expert panellists were identical although the individual rankings varied between the top five positions (Table 3).
The number one CSF identified was staff knowledge of QMS. Specifically, all groups felt strongly that continuing education was crucial to ensuring current and new staff received QMS training and skills. Staff participants reported they wanted to improve the quality of their laboratories, but felt they lacked QMS knowledge to engage in the improvement processes. QMS knowledge included specific steps to follow when implementing a new task, why the specific task was important to test result accuracy and the importance of quality control monitoring. Although QMS was defined in the training, staff felt frequent reminders explaining the QMS concept, how and why QMS would improve their laboratory's quality, and the benefit to patients would be beneficial and motivational. Without continuing education, participants reported staff turnover often left the laboratory without knowledgeable staff to continue the implementation process. Laboratory manager leadership was ranked as CSF number two by the study participants, whereas the expert panel ranked laboratory manager leadership as CSF number four. Staff commitment to the change process was the third CSF by the study participants; however, with the experts its ranking varied with expert #3 ranking it as third, and expert #1 and expert #2 ranking it as second.
Mentorship, as a CSF, was in varying positions between all groups. The variation in ranking may be due to many types of mentorship options. Expert #1 specifically listed embedded mentorship, whereas the others simply listed 'mentorship'. Often, due to time constraints with both the laboratory staff and mentor, email communication emerged as a valuable part of the mentorship package. Discussing the mentorship experience at their laboratories, study participants agreed on the value of the mentorship without regard to whether the mentor visited the laboratory weekly or monthly. Several participants commented that their mentors provided motivation and quick responses to their questions on QMS implementation, often keeping them moving forward in implementation.
Without a mentor, resource staff indicated improvement projects stalled and were often discontinued. Previous articles suggest that embedded and longer mentorships result in better outcomes for the laboratories, although this was not the finding in this study.5,6,7
Hospital administration support received a wide range of scores. Hospital support was defined as either financial support for QMS resources or hospital-wide recognition for staff efforts. Even without financial support, staff reported recognition from administrators and other hospital staff to be motivational. Based on comments from the study participants, all agreed hospital support was critical but often lacking. This may account for the fifth-place ranking of hospital administration support.
The panel of experts endorsed the implementation methods employed by the Vietnamese laboratories. Methods and processes included QMS training, baseline assessments, development of a strategic plan and improvement projects to meet the strategic plan objectives (gaps).
Previous data reported quantitative outcome information based on individual laboratory assessments (Stepwise Laboratory Quality Improvement Process Towards Accreditation scores in each of 12 sections and a total score). Current and active involvement throughout the QMS implementation process made these participants uniquely qualified to share their experiences as well as identify those factors considered critical to QMS implementation success. Combining qualitative data from this study with previous quantitative findings offers valuable information to laboratory managers explaining 'why' implementation or improvements often stalled and failed to move forward.
One of the factors mentioned by both participants and experts is a perceived, or real, lack of knowledge by both laboratory managers and laboratory staff on QMS. The expert panellists confirmed a similar knowledge deficit of QMS principles and skills in staff attempting to implement unfamiliar processes in their laboratories.
Managers reported that they had received some management training but felt they would benefit from additional training related to staff orientation, conflict management, and quality control. Study participants at all laboratories said the formation of teams greatly improved both morale and motivation.
One interview question asked participants to list gaps identified during their project implementation as well as training they felt would strengthen their ability to successfully implement QMS and continue moving towards ISO 15189 accreditation (Table 4). With significant changes in daily laboratory functions due to QMS implementation, repetitive short training sessions for new and current staff seem reasonable to provide support and motivation until the changes become a normal daily routine.
Limitations
This study focused on a small number of laboratories located in Vietnam. A larger study would offer more insight into CSFs that affect medical laboratory QMS success.
Asking study participants to make a forced ranking by only listing one CSF for each position is another limitation. Participants were unable to give equal rank to two CSFs.
Conclusion
This study is the first to identify CSFs for the global medical laboratory sector. Equipped with QMS training, and now CSFs, managers can more precisely focus their time, resources and implementation strategy to address staff needs and move their implementation plan forward.
Utilising CSFs, implementation success should exhibit less variability between laboratories, and QMS projects should begin to move forward. Data from this study may strengthen QMS success throughout Vietnam and serve as a guide for managers in over 1000 laboratories in low-income and middle-income countries implementing QMS.4,13 Laboratory managers and staff considering implementation of a QMS as a pathway to improving quality aspects of their laboratory would benefit from the results of this study.
Acknowledgements
Competing interests
The authors declare that they have no financial or personal relationships that may have inappropriately influenced them in writing this article.
Authors' contributions
C.R. conducted research and wrote the article and manuscript for dissertation. J.J. was the dissertation chair and mentor and assisted with the manuscript. H.B. and K.Y. were the subject matter experts and assisted with the manuscript.
Sources of support
The Strengthening Laboratory Management Towards Accreditation (SLMTA) programme was supported by the President's Emergency Plan for AIDS Relief through the Centers for Disease Control and Prevention (CDC).
Data availability statement
Data sharing is not applicable to this article as no new data were created or analysed in this study.
Disclaimer
The findings and conclusions in this report are those of the authors and do not necessarily represent the official position of the funding agencies.
References
1.Grygotis L. Study reveals variation in accuracy of laboratory blood testing results. Infect Dis Adv. 2016 May 12. Available from: https://www.infectiousdiseaseadvisor.com/home/topics/practice-management/study-reveals-variation-in-accuracy-of-laboratory-blood-testing-results/ [ Links ]
2.Nkengasong JN, Nsubuga P, Nwanyanwu O, et al. Laboratory systems and services are critical in global health. Am J Clin Pathol. 2010;134(3):368-373. https://doi.org/10.1309/AJCPPMSINO9BRMU6 [ Links ]
3.Boucher N. ISO 15189: 2012 What changes for African laboratories? Afr J Lab Med. 2015;4(1):1-4. https://doi.org/10.4102/ajlm.v4i1.181 [ Links ]
4.What is SLMTA? [homepage on the Internet]. 2018. Available from: www.slmta.org [ Links ]
5.Luman ET, Yao K, Nkengasong JN. A comprehensive review of the SLMTA literature part 1: Content analysis and future priorities. Afr J Lab Med. 2014;3(2):265-302. Available from: https://doi.org/10.4102/ajlm.v3i2.265 [ Links ]
6.Maina RN, Mengo DM, Mohamud AD, et al. Progressing beyond SLMTA: Are internal audits and corrective action the key drivers of quality improvement? Afr J Lab Med. 2014;3(2):a222. https://doi.org/10.4102/ajlm.v3i2.222 [ Links ]
7.Duong CN, Bond KB, Carvalho H, Bui H, Nguyen T, Rush T. Rapid ascent from zero quality to international organization for standardization accreditation: A case study of Hai Duong Preventative Medicine Center in Vietnam, 2012-2013. Am J Clin Pathol. 2017;147(4):427-431. https://doi.org/10.1093/ajcp/aqx017 [ Links ]
8.Rockart J, Bullen C. A primer on critical success factors. 1981; Boston, MA: Center for Information Systems Research, Massachusetts Institute of Technology. [ Links ]
9.Shi L. Health services research methods. Albany, NY: Delmar Publishers; 1997. [ Links ]
10.Neuendorf K. The Content Analysis Guidebook Online-Cleveland State [homepage on the Internet]. 2002. Available from: http://academic.csuhio.edu/kneuendorf/content [ Links ]
11.Landis J, Koch G. March. Biometrics [serial online]. 1977;3:169. Available from: https://www.jstor.org/stable/25293106 [ Links ]
12.Robinson CD. A multi case analysis of critical success factor in Vietnam laboratories implementing quality management systems to earn international accreditation [dissertation]. Mount Pleasant, MI: Central Michigan University; 2018. [ Links ]
13.ISO 15189:2012. Retrieved from: http://www.iso.org/obp/ui/#iso:15189:ed-3-v2:en [ Links ]
Correspondence:
Cathy Robinson
c3trrobinson@gmail.com
Received: 05 Dec. 2020
Accepted: 27 Aug. 2020
Published: 18 Dec. 2020
ORIGINAL RESEARCH
Endometrial sampling at an academic hospital in South Africa: Histological findings, lessons learnt and interesting surprises
Reena D. MohanlalI, II
IDepartment of Anatomical Pathology, Faculty of Health Sciences, University of the Witwatersrand, Johannesburg, South Africa
IINational Health Laboratory Services, Chris Hani Baragwanath Laboratory, Johannesburg, South Africa
ABSTRACT
BACKGROUND: Outpatient sampling is used to investigate endometrial pathology. Little is known about practice habits and local failure rates at Chris Hani Baragwanath Academic Hospital in Johannesburg, South Africa.
OBJECTIVE: This study assessed the frequency of samples that showed no or limited histological representation of endometrium, and described demographic and pathological features.
METHODS: All endometrial sample histology reports from the National Health Laboratory Services at the hospital from 01 July 2013 to 31 May 2017 were retrieved by searching the laboratory's information system. Clinical variables (age, menopausal state, indication for biopsy, endometrial thickness on ultrasound) and pathological findings (macroscopic amount of tissue, histological diagnosis, microscopic presence of endometrial tissue) were extracted and statistically analysed.
RESULTS: A total of 1926 samples were included, 91% of which were submitted for abnormal or postmenopausal bleeding. No endometrium was observed in 25% of samples and 13% showed limited endometrium. Benign diagnoses (86%) were most common, with proliferative or secretory changes, endometrial polyps and endometritis accounting for most of these. Associations between the amount of sample received and the presence of endometrial tissue (p ≤ 0.001) and benign versus malignant diagnoses (p ≤ 0.001) were noted. The greater the endometrial thickness, the greater the likelihood of obtaining more sample (bulky vs scant p < 0.001) and making a malignant versus benign diagnosis (p = 0.005).
CONCLUSION: These findings are in keeping with literature outside Africa. Histology reports should be explicit when terms such as 'inadequate' or 'insufficient' are used, in order to facilitate clinical decision-making.
Keywords: Endometrial sampling; inadequate endometrial biopsy; postmenopausal bleeding; pathology; histopathology; gynaecology.
Introduction
Outpatient blind endometrial sampling using a disposable, flexible aspiration device such as a Z-sampler or pipelle is well tolerated by patients and is a quick and easy procedure to perform.1 In resource-limited settings, this modality for investigating suspected endometrial disease becomes especially relevant, as it eliminates the cost of a hospital stay, anaesthetic administration and post-operative complications inherent with in-theatre diagnostic dilation and curettage. Most of the literature pertaining to endometrial sampling is from non-African countries. Outpatient sampling compares well to other modalities and studies have shown a concordance rate of 95% between pipelle and diagnostic dilation and curettage for atypia and hyperplasia,1 agreement between office sampling and final diagnosis of 0.73, and no significant difference between hysteroscopic and office sampling.2 Outpatient sampling has also been shown to avoid hysteroscopy, particularly in patients with postmenopausal bleeding and an endometrial thickness of more than 4 mm.3 There were no significant differences in the agreement rates for tumour type or grading among endometrial biopsy, curettage or hysteroscopy methods.4 However, outpatient sampling performs less well when there are focal endometrial lesions.1 The biopsy procedure may fail when insufficient tissue is obtained or there is an inability to access the endometrial cavity.5 Failure rates of up to 53% have been cited in a meta-analysis.5 Furthermore, the reporting of these biopsies is not standardised. There is poor agreement on what constitutes an 'insufficient' or 'inadequate' biopsy6,7 among both general and gynaecologic pathologists, as there are no standardised criteria for determining adequacy as shown in a study from the United Kingdom.7 Such ambiguous sign-outs or reporting may result in misinterpretation by the clinician and subsequent overtreatment of the patient.6 This study was undertaken to determine the frequency of biopsies of outpatient endometrial aspiration that showed no or limited amounts of endometrium and to describe demographic and pathological findings in a retrospective cohort of cases at a tertiary hospital in Johannesburg, South Africa.
Methods
Ethical considerations
Ethics approval for this study was obtained from the Medical Ethics Committee of the University of the Witwatersrand (M170697).
Study design
This retrospective, descriptive cross-sectional study was conducted at the Department of Anatomical Pathology, Chris Hani Baragwanath Hospital National Health Laboratory Services, located on the hospital premises in Soweto, South Africa. Endometrial biopsies are submitted to the laboratory from the gynaecology department at the hospital. A retrospective search of all endometrial biopsies reported from 01 July 2013 to 31 May 2017 was conducted using the search word 'endometrium' on the laboratory's information system. A review of all histology reports identified using this search was then undertaken.
All endometrial biopsy samples obtained with an aspiration device such as a Z-sampler were included; while those biopsy samples obtained during hysteroscopy, dilatation and curettage and suction curettage were excluded. Clinical and pathological variables were obtained from the histology reports only. No clinical records or patients' files were accessed. Age, menopausal status, endometrial thickness (in millimetres), clinical examination findings, the presence of risk factors for carcinoma (body mass index ≥ 25 kg/m2, hypertension, diabetes, tamoxifen use, nulliparity) and indications for biopsy were obtained from the clinical history section of the histopathology reports. The clinical history section on the histology report comprises information provided by the submitting clinician on the requisition slip that accompanies a specimen. Pertinent laboratory findings including diagnosis, diagnostic category (benign, atypical, malignant), quantity of tissue at macroscopic assessment (scanty, moderate or bulky) and the presence or absence of endometrial tissue on microscopic examination were also recorded from the histology report.
Cases with superficial strips of endometrium or stroma recorded on histological examination were classified as limited (Figure 1). Diagnoses recorded as malignant were carcinomas and lymphomas; those recorded as atypical were hyperplasia with atypia and squamous intraepithelial lesions. All remaining cases, for example polyps, endometritis, and proliferative or secretory phase endometrium, were categorised as benign. As per laboratory standard operating procedures, the categories of tissue assigned at grossing, or macroscopic examination, were: bulky tissue (fills more than one tissue cassette), moderate (fills up to one tissue cassette) and scanty (minimal or small fragments of tissue submitted). Slides of selected cases were retrieved for photography.

Data analysis
All data were recorded on a datasheet and entered into an Excel (Microsoft, Redmond, Washington, United States) spreadsheet for statistical analysis. Where data were missing, no value was entered. There was no patient follow-up or clinical record review. StatisticaTM version 13.0 (Dell, Round Rock, Texas, United States) and STATA version 15 (Statacorp, College Station, Texas, United States) were used in the statistical analysis. Categorical data (macroscopic tissue quantity, diagnostic category, diagnosis) were reported as frequencies. Numerical data (age and endometrial thickness) were reported as medians with interquartile ranges, as these data were non-normally distributed. Only endometrial thicknesses reported in postmenopausal patients were used. The chi-square and Fisher's exact tests were used to assess associations between the amount of tissue at grossing and diagnostic category, and the presence of endometrial tissue on histological examination. The Kruskall-Wallis test was used to assess differences in endometrial thicknesses recorded for macroscopic quantity of tissue and diagnostic category. Pairwise comparison (Dunn's test) was used to assess associations between median endometrial thickness and diagnostic category, and macroscopic tissue quantity in the postmenopausal group. Statistical significance was set at p < 0.05.
Results
Entire cohort
A total of 1926 outpatient endometrial aspiration biopsies were received and reported in the laboratory from 01 July 2013 to 31 May 2017. The median age of the patients was 53 (interquartile range 48-62) years (Table 1). Most biopsies (n = 1625, 90.58%) were submitted for abnormal or postmenopausal bleeding. In 196 (10.18%) cases, the presence of risk factors for endometrial carcinoma was indicated (data not shown in table). Scanty and moderate samples comprised the majority of samples received, with only 135 (6.82%) bulky specimens noted. For the entire group, 485 (25.18%) cases had no endometrium and 245 (12.72%) cases had limited amounts in the form of superficial strips of mucosa or stroma (Figure 1). The majority of diagnoses were benign (n = 1725, 86.42%). Of the 110 malignancies diagnosed, there were 32 cases of serous carcinoma of the endometrium, 24 endometrioid carcinomas and 13 malignant mixed Müllerian tumours. Cervical pathology was noted in 107 (5.56%) of the total biopsies, 70 cases of which were diagnosed with cervical squamous intraepithelial lesions, eight with squamous cell carcinoma and three with cervical adenocarcinoma.

The distribution of samples with histologically determined endometrium present, absent or limited in amount and the diagnostic categories across macroscopic quantities was assessed. Associations between the macroscopic quantity of tissue received and the presence of endometrial tissue (p ≤ 0.001) and diagnostic category (p ≤ 0.001) are shown in Table 2.
Cases of interest
Two cases of interest were noted. An endometrial sample from a 39-year-old woman with abnormal uterine bleeding revealed cytomegalovirus endometritis (Figure 2). No clinical follow-up was available for this patient. A B-cell non-Hodgkin lymphoma (Figure 3) was noted in a 22-year-old woman with bilateral ovarian masses, hepatosplenomegaly and lymphadenopathy. In addition to endometrial involvement, previous histology also showed nodal and marrow infiltration by lymphoma.


Actinomyces
Six biopsies from five patients, ranging in age from 54 to 78 years, showed infection with Actinomyces bacteria (Figure 4). All patients with Actinomyces infection presented with abnormal bleeding, with one patient additionally complaining of per vaginal discharge. An intrauterine contraceptive device in situ was noted in only one patient and none of patients with Actinomyces infection had microbiological confirmation.

Tamoxifen use
Of the total biopsies studied, 11 were from patients on tamoxifen. Three presented with postmenopausal bleeding, and the endometrial thickness reported in three women ranged from 4 mm to 18 mm (data not shown). Two biopsies from patients on tamoxifen showed endometrial polyps (both patients presented with bleeding), two showed endometritis and one, atypical squamous cells (data not shown).
Postmenopausal subgroup
A total of 994 patients (see Table 1) of the entire cohort were postmenopausal, as indicated in the clinical history sections of the laboratory records. The median age in the postmenopausal group was 60 years (interquartile range 54-68). The majority of biopsies (n = 964, 98.27%), where an indication for biopsy was provided, were for postmenopausal bleeding. Risk factors for malignancy were noted in 126 (12.7%) patients (data not shown). In the postmenopausal group, 267 (26.86%) had no endometrium and 152 (15.29%) had limited amounts (data not shown). Malignant diagnoses accounted for 82 (8.27%) of postmenopausal cases (data not shown). Other significant pathological findings included hyperplasia (n = 16), hyperplasia with atypia (n = 15), endometrial polyps (n = 115), inactive endometrium (n = 125) and endometritis (n = 71) (data not shown). Endometrial thicknesses were specified in only 94 of postmenopausal patients, with an overall median of thickness of 11.0 mm (interquartile range 7-17) (data not shown).
Significant differences were noted in the median endometrial thicknesses recorded among the diagnostic categories and macroscopic quantities of tissue for postmenopausal women (Table 3). On subsequent analysis, it was shown that the greater the endometrial thickness, the greater the likelihood of obtaining more tissue (bulky vs moderate p = 0.021 and bulky vs scanty p < 0.001) (data not shown). In addition, the thicker the endometrium measured on ultrasound, the more likely a diagnosis of malignant versus atypical (p = 0.048) and malignant versus benign (p = 0.005) (data not shown) was made.

Discussion
Outpatient endometrial samples are regularly encountered in general pathology practice. One-quarter of samples in this study contained no endometrial tissue on histological examination. Furthermore, in the postmenopausal group, endometrial thickness on ultrasound correlated with the amount of tissue obtained at sampling and the histologically confirmed diagnostic category.
As per other studies from Canada and Turkey, abnormal bleeding was the most common presenting feature in our study.8,9 The importance of adhering to guidelines or indications for biopsy has been stressed, as endometrial sampling is not without risk. A tendency to over-investigate patients younger than 40 with abnormal bleeding has been shown.10 Furthermore, sampling of the endometrium without a clear indication may contribute to higher failure rates.
Although larger samples show better agreement rates with final excisional diagnoses,4,11 bulky specimens formed the minority of samples submitted in our cohort. Failure rates reported in the literature include cases where insufficient tissue was noted on histological examination or where the endometrium could not be accessed due to technical or patient-related factors.5 Higher failure rates have been noted in postmenopausal, obese patients, those with advanced age or previous failed pipelle and when sampling was performed by a non-physician.9 The failure rate for this cohort is higher than some reported failure rates (6.33% - 18.4%)8,9,12 and lower than the overall failure rate of 42% reported in a meta-analysis where 11% of cases failed due to technical reasons and 31% had insufficient tissue.5 These figures need to be interpreted with caution, as the criteria for labelling biopsies as 'insufficient' may vary across institutions. In one study, complete agreement on classification as insufficient or diagnostic was shown in only 57% of cases.7 The terms 'insufficient' or 'inadequate' were proposed for cases with no endometrial tissue present and 'unassessable' if there was too little tissue.6 Recently published Canadian guidelines may facilitate standardising reporting. Categories of 'non diagnostic sample, no endometrial tissue present' and 'scant fragments of inactive endometrial surface epithelium and/or stroma (suboptimal for histopathological assessment)' have been suggested.13 An endometrial surface area of at least 35 mm,2,11 or a minimum of 10 endometrial strips14 have also been proposed as cut-offs for a conclusive sample. Limited endometrial tissue was noted in 245 (12.72%) of our biopsies. The histological finding of limited endometrial tissue should be correlated clinically with the endometrial thickness as this microscopic finding could be compatible with atrophy, requiring no further clinical intervention. Adequacy is related to endometrial thickness. One study showed that 27% of samples were adequate among postmenopausal patients with an endometrial thickness of less than 5 mm, leading to the suggestion that sampling should not be done in this group.3 This study corroborates the findings of others in that the thicker the endometrium in postmenopausal women, the greater the likelihood of obtaining more sample and a malignant diagnosis.3,8 Specificity of endometrial sampling is high, but its sensitivity is low.5 One study has shown that, following an inadequate or scant biopsy, 10% of patients had hyperplasia, 5% had malignancy on repeat sampling and 15% had malignancy on hysterectomy.7 Worrisome histological findings such as atypia or necrosis on initial biopsy should be communicated as 43% of such patients in one study had malignancy on follow-up biopsy.15
The frequency of histological diagnoses noted in the entire cohort is similar to findings by Inal et al.,8 with the exception that hyperplasia was diagnosed in fewer patients (2.02% vs their 9.7%). Cervical pathology was noted in some of this cohort's endometrial biopsies. Histopathologists should be alert to the presence of, and pathological changes in, cervical tissue present in an endometrial sample, as this may direct clinicians to re-examine and rebiopsy the cervix. In the current study, hyperplasia or malignancy were diagnosed in 113 (11.37%) of postmenopausal women, which is in keeping with other studies.10,16
Cytomegalovirus endometritis and endometrial involvement by non-Hodgkin lymphoma were two interesting cases encountered. Isolated case reports of cytomegalovirus endometritis from the 1990s have been noted, but the most recent report was in a postpartum uterus specimen.17 Polymerase chain reaction for cytomegalovirus was negative and the diagnosis was based on immunohistochemistry.17 A caveat to bear in mind is that biotin present in postpartum endometrial epithelium interacts with the avidin-biotin-complex, resulting in false-positive staining on immunohistochemistry.18 In women, non-Hodgkin lymphoma most commonly affects the ovaries, as it is postulated that the ovarian microenvironment is conducive to the growth of tumour cells. It is important to categorise lymphomas as either primary genital tract disease or secondary involvement, as this may have treatment implications.19 The prevalence of actinomycotic endometritis was 0.31% in this study, which is higher than the 0.0002% previously recorded.20 The association with prolonged use of an intrauterine contraceptive device is well known, but this history is not always forthcoming. Although forming only a very small subset in this study, patients on tamoxifen with postmenopausal bleeding and with adequate endometrial tissue most commonly had endometrial polyps on biopsy, which is similar to another study.21
Limitations
This study included a review of laboratory-record histology reports from a large number of endometrial biopsies. Clinical information submitted in some instances was minimal, with no information about the menopausal status or endometrial thickness. The postmenopausal group was determined using clinical history only and all cases with no comment on menopausal state were excluded from this subgroup. A large number of cases could therefore have been left out, but assumptions about the menopausal state based purely on age could not be justified. Furthermore, there was no clinical record review to assess outcomes and final diagnosis for cases where there was no endometrium or limited endometrium. As this hospital is a tertiary public hospital in a metropolitan area, the cases are biased and therefore may not be a true reflection of the South African community. Further areas of study could include a follow-up of cases with no or limited endometrium and to assess local reasons for the failure rates in this study.
Conclusion
This study provides information about the indications, diagnoses and representation of endometrium in endometrial samples seen at a large tertiary hospital in Soweto. There should be an awareness among pathologists and clinicians regarding terms such as 'insufficient', 'inadequate', 'scant' and 'unassessable' in an endometrial sample pathology report. If these terms are used, they should be accompanied by a clear description of the type and amount of tissue that is present as there is no consensus among pathologists regarding adequacy criteria.6,7 In the appropriate setting, repeat biopsy can be suggested by the pathologist when no or little endometrial tissue is present as there is a possibility of finding hyperplasia or malignancy on subsequent biopsy.7 Ultimately, management following an 'insufficient' tissue biopsy will depend on clinical factors such as the persistence of bleeding and ultrasound findings.7,12,13 Endometrial sampling is a useful investigation if done under the appropriate clinical circumstances, submitted with adequate history and reported mindfully by the histopathologist.
Acknowledgements
The author wishes to thank Dr Innocent Maposa (Faculty of Health Sciences Research Office) for biostatistical support, Mr Eric Liebenberg for assistance with photography, Mr Deon Mahlathi for slide retrieval, and colleagues and staff at Chris Hani Baragwanath Academic Hospital Histopathology Laboratory.
Competing interests
The author declares that she has no financial or personal relationships that may have inappropriately influenced her in writing this article.
Author's contributions
I declare that I am the sole author of this research article.
Sources of support
This research did not receive any specific grant from funding agencies in the public, commercial or not-for-profit sectors.
Data availability statement
Data is available upon request from the author.
Disclaimer
The views expressed in the submitted article are the author's own and not an official position of the institution or funder.
References
1.Demirkiran F, Yavuz E, Erenel H, Bese T, Arvas M, Sanioglu C. Which is the best technique for endometrial sampling? Aspiration (pipelle) versus dilatation and curettage (D&C). Arch Gynecol Obstet. 2012;286(5):1277-1282. https://doi.org/10.1007/s00404-012-2438-8 [ Links ]
2.Visser N, Reijnen C, Massuger L, Nagtegaal I, Bulten J, Pijnenborg J. Accuracy of endometrial sampling in endometrial carcinoma: A systemic review and meta-analysis. Obstet Gynecol. 2017;130(4):803-813. https://doi.org/10.1097/AOG.0000000000002261 [ Links ]
3.Elsandabesee D, Greenwood P. The performance of pipelle endometrial sampling in a dedicated postmenopausal bleeding clinic. J Obstet Gynaecol. 2005;25(1):32-34. https://doi.org/10.1080/01443610400025390 [ Links ]
4.Garcia T, Appel M, Rivero R, Kliemann L, Wender M. Agreement between preoperative endometrial sampling and surgical specimen findings in endometrial carcinoma. Int J Gynecol Cancer. 2017;27(3):473-478. https://doi.org/10.1097/IGC.0000000000000922 [ Links ]
5.Van Hanegem N, Prinns M, Bongers M, et al. The accuracy of endometrial sampling in women with postmenopausal bleeding: A systematic review and meta-analysis. Eur J Obstet Gynecol Reprod Biol. 2016;197:147-155. https://doi.org/10.1016/j.ejogrb.2015.12.008 [ Links ]
6.Phillips V, McCluggage W. Results of a questionnaire regarding criteria for adequacy of endometrial biopsies. J Clin Pathol. 2005;58(4):417-419. https://doi.org/10.1136/jcp.2004.023564 [ Links ]
7.Goebel E, McLachlin M, Ettler H, Weir M. Insufficient and scant endometrial samples: Determining outcomes and consistency in reporting. Int J Gynecol Pathol. 2019;38(3):216-223. https://doi.org/10.1097/PGP.0000000000000514 [ Links ]
8.Inal Z, Inal H, Kuckukosmanoglu I, Kucukkendirci H. Assessment of endometrial sampling and histopathological results: Analysis of 4247 cases. Eurasian J Med. 2017;49(1):44-47. https://doi.org/10.5152/eurasianjmed.2017.16269 [ Links ]
9.Nicholls-Dempsey L, Kamga-Ngande C, Belisle S, et al. Endometrial biopsy in an outpatient gynaecological setting: Overinvestigation. J Obstet Gynaecol Can. 2018;40(10):1309-1314. https://doi.org/10.1016/j.jogc.2018.01.020 [ Links ]
10.Reijnen C, Visser N, Bulten J, Massuger L, Van der Putten L, Pijnenborg J. Diagnostic accuracy of endometrial biopsy in relation to the amount of tissue. J Clin Pathol. 2017;70(11):941-946. https://doi.org/10.1136/jclinpath-2017-204338 [ Links ]
11.Adambekov S, Goughnour S, Mansuria S, et al. Patient and provider factors associated with endometrial pipelle sampling failure. Gynecol Oncol. 2017;144(2):324-328. https://doi.org/10.1016/j.ygyno.2016.11.041 [ Links ]
12.Clark T, Mann C, Shah N, Khan K, Song F, Gupta J. Accuracy of outpatient endometrial biopsy in the diagnosis of endometrial cancer: A systematic quantitative review. BJOG. 2002;109(3):313-321. https://doi.org/10.1111/j.1471-0528.2002.01088.x [ Links ]
13.Parra-Herran C, Cesari M, Djordjevic B, et al. Canadian consensus-based and evidence-based guidelines for benign endometrial pathology reporting in biopsy material. Int J Gynecol Pathol. 2019;38(2):119-127. https://doi.org/10.1097/PGP.0000000000000481 [ Links ]
14.Sakhdari A, Moghaddam P, Liu Y. Endometrial samples from postmenopausal women: A proposal for adequacy criteria. Int J Gynecol Pathol. 2016;35(6):525-530. https://doi.org/10.1097/PGP.0000000000000279 [ Links ]
15.Kandil D, Yang X, Stockl T, Liu Y. Clinical outcomes of patients with insufficient sample from endometrial biopsy or curettage. Int J Gynecol Pathol. 2014;33(5):500-506. https://doi.org/10.1097/PGP.0000000000000085 [ Links ]
16.Patel V, Wilkinson E, Chamala S, Lu X, Castagno J, Rush D. Endometrial thickness as measured by transvaginal ultrasound and the corresponding histopathologic diagnosis in women with postmenopasual bleeding. Int J Gynecol Pathol. 2016;36(4):348-355. https://doi.org/10.1097/PGP.0000000000000344 [ Links ]
17.Giraldo-Isaza M, Jaspan D, Cohen A. Postpartum endometritis caused by herpes and cytomegaloviruses. Obstet Gynecol. 2011;117(2):466-467. https://doi.org/10.1097/AOG.0b013e3181f73805 [ Links ]
18.Bakkar R, Moore G, Martin A, Alatassi H. Biotin-rich intranuclear inclusions: Have you checked your immunohistochemical controls?. Int J Surg Path. 2008;16(4):424-425. https://doi.org/10.1177/1066896908319674 [ Links ]
19.Lagoo A, Robboy S. Lymphoma of the female genital tract: Current status. Int J Gynecol Pathol. 2005;25(1):1-21. https://doi.org/10.1097/01.pgp.0000183049.30212.f9 [ Links ]
20.Chiesa-Vottero A. Actinomycotic endometritis. Int J Gynecol Pathol. 2019;38(2):138-142. https://doi.org/10.1097/PGP.0000000000000476 [ Links ]
21.Jung H, Jung J, Kim S, Cho E, Um M. Comparative study on hysteroscopic and histologic examinations of the endometrium in postmenopausal women taking tamoxifen. J Menopausal Med. 2018;24(2):81-86. https://doi.org/10.6118/jmm.2018.24.2.81 [ Links ]
Correspondence:
Reena Mohanlal
reena.mohanlal@nhls.ac.za
Received: 26 Apr. 2019
Accepted: 15 May 2020
Published: 29 Sept. 2020












